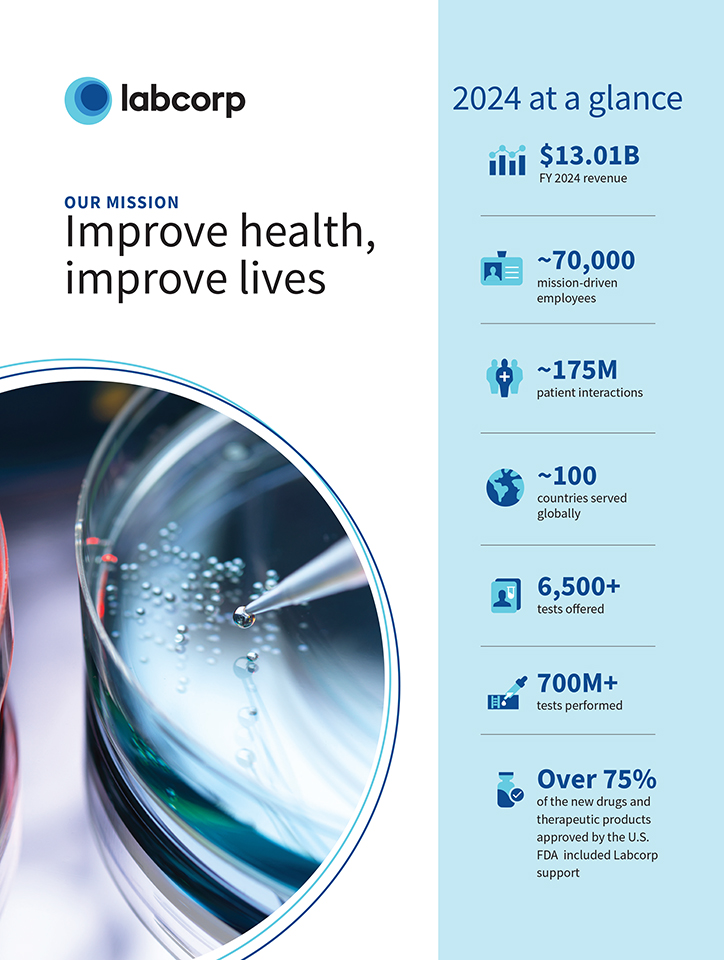
LOGO

labcorp 2025 proxy statement and annual meeting of shareholders
☐ |
Preliminary Proxy Statement | |
☐ |
Confidential, for Use of the Commission Only (as permitted by Rule 14a-6(e)(2)) | |
☒ |
Definitive Proxy Statement | |
☐ |
Definitive Additional Materials | |
☐ |
Soliciting Material Under Rule 240.14a-12 | |
☒ |
No fee required. | |||
☐ |
Fee paid previously with preliminary materials. | |||
☐ |
Fee computed on table in exhibit required by Item 25(b) per Exchange Act Rules 14a-6(i)(1) and 0-11. | |||

labcorp 2025 proxy statement and annual meeting of shareholders
LETTER TO SHAREHOLDERS
Letter from our Chairman, President, and Chief Executive Officer

|
“We have strong momentum heading into 2025. Our core business segments, Diagnostics Laboratories and Biopharma Laboratory Services, which includes Central Laboratory Services and Early Development Research Laboratories, are well-positioned to continue to drive advancements in science and technology solutions that better serve the needs of our customers.”
ADAM H. SCHECHTER |
Dear Shareholder,
On behalf of management and the board of directors, I invite you to join us for the 2025 Annual Shareholder Meeting of Labcorp, to be held on Thursday, May 15, 2025, at 9:00 a.m. Eastern Time. The meeting will be webcast live at www.virtualshareholdermeeting.com/LH2025, at which time you can vote your shares electronically and submit questions.
In 2024, Labcorp delivered exceptional results, while our market-leading diagnostics and biopharma laboratory services businesses made meaningful advances in our strategy through organic growth and transformative acquisitions.
We have strong momentum heading into 2025. Our core business segments, Diagnostics Laboratories and Biopharma Laboratory Services, which includes Central Laboratory Services and Early Development Research Laboratories, are well-positioned to continue to drive advancements in science and technology solutions that better serve the needs of our customers.
Continued Focus on Our Primary Specialty Testing Areas
We are able to bring new testing capabilities, particularly specialty testing, to patients and physicians globally. Our focus is on four key areas of specialty testing: oncology, women’s health, autoimmunology, and neurology. In 2024, we introduced groundbreaking new tests to meet significant unmet medical needs. Among these are a first trimester preeclampsia screening test—the only test of its kind available in the U.S.—that can detect preeclampsia risk even before symptoms present, and a pTau217 blood biomarker test to accelerate the path to diagnosis of Alzheimer’s disease. We anticipate that these key clinical areas will continue to outpace the growth of other specialties. Our advancements within specialty testing and companion diagnostics make us an attractive choice for health systems and biopharmaceutical companies. We have
demonstrated our ability to provide comprehensive portfolios in these four areas, which comprise more than half of clinical trials conducted in our Central Laboratory Services business.
Transformative Transactions
Last year, Labcorp closed or signed 10 agreements across hospital and health systems, as well as regional/local laboratories. Additionally, we delivered on our growth roadmap through the strategic purchase of select assets of Invitae, a leading medical genetics company. Invitae’s cutting-edge science and industry-leading experience are expanding Labcorp’s leadership in and client access to cutting-edge genetic testing solutions. These solutions guide diagnosis, care, and personalized treatment recommendations for oncology and rare disease patients.
Our Business Strength
In 2024, we generated $13.0 billion in revenue, $1.6 billion in operating cash flow, $1.1 billion in free cash flow from operations (operating cash flow less capital expenditures), diluted earnings per share of $8.84, and adjusted earnings per share of $14.57. This performance positions us well for continued success in 2025.
We expect our Diagnostics business to benefit from increased demand for routine and esoteric testing, advancements in science and technology, and expansion of our collaborations with health systems and hospitals. Biopharma Laboratory Services should also continue to benefit from our customer relationships, extensive scientific expertise, and global scale.
Near-term and Long-term Significant Growth opportunities
We continue to make progress on our near-term and long-term areas of focus that we believe will drive Labcorp’s future growth.
2025 PROXY STATEMENT
LETTER TO SHAREHOLDERS
In the near term, we continue to solidify our position as a trusted partner to hospitals and health systems and regional/local laboratories. Labcorp brings the scientific expertise, innovation, and robust data and analytics capabilities needed to serve patients efficiently and with high-quality, enabling hospitals to be at the forefront of science, technology, and innovation in testing. We expect to have a strong pipeline of opportunities and look forward to expanding access to Labcorp’s world-class diagnostics solutions. In addition, as discussed above, we continue to lead in the development, licensing, and scaling of specialty testing in oncology, women’s health, autoimmunology, and neurology.
Longer term, we see tremendous opportunity for increased development of cell and gene therapies. Currently, cell and gene therapies represent approximately 20% of the new drug pipeline at pharmaceutical companies, with more than 2,000 trials in progress. We expect this market to grow at a substantially higher rate than other therapies over the next five years, with Labcorp supporting development and commercialization to make these advanced, personalized therapies available to more patients.
We have approximately 175 million patient encounters per year, and we continue to invest in additional capabilities to digitize and improve the patient journey. We are expanding our consumer-centric capabilities to enhance the patient service center experience and help patients manage their wellness through Labcorp OnDemand. Moving forward, we aim to better serve this market with even more convenient and innovative offerings. More generally, our efforts to bring innovation to the work we do and the clients and patients we serve are being driven in part by our use of AI and machine learning tools, which we have been using to supplement our existing data analysis projects and support greater efficiency in our operations. We continue to evaluate and test additional applications of AI and machine learning tools to further advance our goals for digital enablement in clinical development services, especially in oncology.
Finally, as the world’s largest laboratory service provider, we are leveraging our network to expand our business globally. We believe that our scale, portfolio breadth, and geographic presence are differentiators that uniquely position us to expand specialty testing capabilities into new markets. As companion diagnostics continues to become more important for serving customers across the enterprise, we have unique capabilities to be a strategic partner to biopharmaceutical clients and will continue to expand these capabilities to fuel further targeted growth internationally.
Prioritizing Corporate Governance
We believe that Labcorp’s commitment to maintaining strong corporate governance plays an important role in creating long-term value for shareholders. Our board prioritizes developing a culture that is committed to fostering an environment for engagement across the enterprise.
We also value the input that we receive from shareholders through our regular interactions. We share the insights gained from these
meetings with the full board on a regular basis so that our directors have an understanding of shareholders’ perspectives.
Additionally, the Labcorp board believes the structure of our compensation program successfully creates alignment of executives’ pay with the Company’s performance. The compensation program is designed to achieve this objective by using performance-based and variable compensation, and we will continue to refine the program to reflect our strategic execution and the best interests of shareholders. I encourage you to review the discussion of our compensation program that begins on page 50.
Your Vote Is Important
At the 2025 Annual Meeting, we will ask you to (1) elect ten director nominees, (2) approve, on a non-binding advisory basis, the compensation of our named executive officers, (3) approve the Company’s 2025 Omnibus Incentive Plan, (4) approve the Company’s 2025 Employee Stock Purchase Plan, (5) ratify the appointment of Deloitte & Touche LLP as our independent registered public accounting firm for the year ending December 31, 2025, and (6) act on any other business matters properly brought before the meeting.
We encourage you to review the information beginning on page 25 detailing the skills and qualifications of our director and why we believe they are the right people to oversee the long-term success of our Company.
We value your vote, so it is important that your shares are represented at the meeting. I urge you to promptly vote by submitting your proxy via the Internet, phone, or by mail.
Looking Ahead
As a global leader of innovative and comprehensive laboratory services, we provide insights and advance science through our unparalleled diagnostics and drug development laboratory capabilities. We are excited about the year ahead and will continue to deliver the best possible laboratory solutions for our customers.
I want to thank our nearly 70,000 employees around the globe for their hard work and dedication as we pursue our mission to improve health and improve lives. We believe the future is bright for Labcorp and the patients, customers, and shareholders that put their trust in us every day.
On behalf of Labcorp’s management and the Board, thank you for your investment in Labcorp. We look forward to your participation during the 2025 Annual Meeting.
Sincerely,
Adam H. Schechter
Chairman, President, and Chief Executive Officer
April 4, 2025
LABCORP HOLDINGS INC.
LETTER TO SHAREHOLDERS
Letter from our Lead Independent Director

|
“In 2024, Labcorp executed on strategic priorities and expanded our leadership position in key growth markets, underpinned by our solid financial performance. Our growth in 2024 is a result of our team’s commitment to science and innovation and the contributions of our nearly 70,000 dedicated employees across the globe.”
GARHENG KONG, M.D., Ph.D. |
Dear Shareholder,
In 2024, Labcorp executed on strategic priorities and expanded our leadership position in key growth markets, underpinned by our solid financial performance. Our growth in 2024 is a result of our team’s commitment to science and innovation and the contributions of our nearly 70,000 dedicated employees across the globe.
In the past year, we have made notable advancements in each of our focus areas:
| • | serving as the partner of choice for health systems and local and regional laboratories; |
| • | delivering diagnostic and therapeutic advancements in key clinical areas such as oncology, women’s health, autoimmunology, and neurology; |
| • | advancing our testing capabilities with transformative solutions that enable increased accuracy, scalability, and efficiency; |
| • | expanding consumer-facing capabilities with increased accessibility; and |
| • | using our global laboratory network to provide biopharmaceutical clients with access to the Company’s comprehensive offerings of specialty testing. |
Further details on the Company’s 2024 performance are highlighted throughout this Proxy Statement.
Corporate Governance
Labcorp’s commitment to strong corporate governance practices remains a high priority. Maintaining a qualified, and majority independent board is the cornerstone of our approach to sound corporate governance. In May 2024, Dr. R. Sanders Williams and Mr. Jean-Luc Bélingard retired from the board of directors at the conclusion of their terms, during which they reached the
mandatory director retirement age of 75. We thank Dr. Sanders and Mr. Bélingard for their years of service and the significant contributions they have made to Labcorp’s advancements in science, innovation, and technology.
Lead Independent Director Responsibilities
I have served as a director of the Company since 2013, and in 2023, I was elected to the position of lead independent director by the other independent directors of our board. The board supports having in place a robust lead independent director role, with clearly defined responsibilities that support independent oversight of management, as an efficient and effective leadership structure for the Company.
In this role, I serve as a liaison between the board Chair and the independent directors, preside over executive sessions of the board, provide feedback from executive sessions to the Chair, and advise the Chair with respect to the schedule, agenda, and information for board meetings in order to facilitate timely and appropriate information flow to and from the board. The board believes this structure increases its effectiveness, strengthens ongoing dialogue between management and the independent directors, and supports effective delivery of recommendations, and certain other deliberations, to the Chair and management team.
Shareholder Engagement
Additionally, the board prioritizes two-way communication with our shareholders and works closely with the Company’s management team. We value discussions with shareholders regarding our business strategy, corporate responsibility, governance and sustainability practices, and how we give back to the communities we serve.
2025 PROXY STATEMENT
LETTER TO SHAREHOLDERS
I am confident that the Company’s extraordinary workforce will continue to deliver a meaningful impact on improving health and improving lives in a responsible, sustainable way. On behalf of the Labcorp Board of Directors, we thank you for your continued support and hope you can join us at Labcorp’s 2025 Annual Shareholder Meeting.
Sincerely,
Garheng Kong, M.D., Ph.D.
Lead Independent Director
April 4, 2025
LABCORP HOLDINGS INC.
NOTICE OF 2025 ANNUAL MEETING OF SHAREHOLDERS
Notice of 2025 Annual Meeting
of Shareholders
|
DATE & TIME
Thursday, May 15, 2025 9:00 a.m., Eastern Daylight Time
RECORD DATE
March 20, 2025 Only shareholders of record at the close of business on the record date are entitled to receive notice of, and to vote at, the 2025 Annual Meeting.
|
|
WHERE
The 2025 Annual Meeting of Labcorp Holdings Inc. will be a virtual meeting of shareholders to be held as a live webcast over the Internet at: www.virtualshareholdermeeting.com/LH2025
|
ITEMS OF BUSINESS
| 1 |
To elect ten directors from among the nominees named in the attached Proxy Statement.
| |
| 2 |
To approve, on a non-binding advisory basis, executive compensation.
| |
| 3 |
To approve the Company’s 2025 Omnibus Incentive Plan.
| |
| 4 |
To approve the Company’s 2025 Employee Stock Purchase Plan.
| |
| 5 |
To ratify the appointment of Deloitte & Touche LLP as the independent registered public accounting firm for the year ending December 31, 2025.
| |
| 6 |
To consider any other business properly brought before the 2025 Annual Meeting.
|
PROXY VOTING
Your vote is important. We encourage you to mark, date, sign, and return the enclosed proxy/voting instruction card or, if you prefer, to vote by telephone or by using the Internet.
April 4, 2025
By Order of the Board of Directors
Sandra D. van der Vaart
Secretary
Important notice regarding the availability of proxy materials for the 2025 Annual Meeting of Shareholders to be held on May 15, 2025. Our Proxy Statement and Annual Report to Shareholders are available at: www.proxyvote.com.
2025 PROXY STATEMENT
TABLE OF CONTENTS
Table of Contents
| PROXY SUMMARY | 1 | |||
| 1 | ||||
| 2 | ||||
| 2 | ||||
| 3 | ||||
| 6 | ||||
| 6 | ||||
| 8 | ||||
| 9 | ||||
| 10 | ||||
| 10 | ||||
| GENERAL INFORMATION | 11 | |||
| 11 | ||||
| 11 | ||||
| 12 | ||||
| 12 | ||||
| 14 | ||||
| 14 | ||||
| CORPORATE GOVERNANCE | 15 | |||
| 15 | ||||
| 17 | ||||
| 19 | ||||
| 21 | ||||
| 24 | ||||
| 26 | ||||
| 27 | ||||
| 28 | ||||
| 29 | ||||
| 30 | ||||
| 31 | ||||
| 31 | ||||
| 32 | ||||
| DIRECTOR COMPENSATION | 33 | |||
| 33 | ||||
| 34 | ||||
| 34 | ||||
| PROPOSAL ONE - Election Of Directors | 35 | |||
| 36 | ||||
| EXECUTIVE OFFICERS | 46 | |||
| COMPENSATION DISCUSSION & ANALYSIS | 50 | |||
| COMPENSATION AND HUMAN CAPITAL COMMITTEE REPORT | 69 | |||
| EXECUTIVE COMPENSATION | 70 | |||
| 70 | ||||
2025 PROXY STATEMENT
TABLE OF CONTENTS
Cautionary Note Regarding Forward-Looking Statements
As used in this Proxy Statement, “Labcorp,” the “Company” and “we” may refer to Labcorp Holdings Inc. itself, one or more of its subsidiaries, or Labcorp Holdings Inc. and its consolidated subsidiaries, as applicable.
This Proxy Statement contains certain forward-looking statements within the meaning of the Private Securities Litigation Reform Act of 1995, 27A of the Securities Act of 1933, as amended, and Section 21E of the Securities Exchange Act of 1934, as amended (the “Exchange Act”), that are based on current expectations, forecasts, assumptions, and other information available to Labcorp Holdings Inc. as of the date hereof. Forward-looking statements involve inherent risks and uncertainties, include statements regarding Labcorp’s expectations, beliefs, intentions, or strategies regarding the future, including with respect to business, financial, operational, compensation, and environmental, social, and governance matters, and can be identified by forward-looking words such as “anticipate,” “believe,” “could,” “estimate,” “expect,” “should,” “seeks,” “approximately,” “estimate,” “goal,” “intend,” “may,” “plan,” “should,” “will,” and “would,” or the negative of those words or other similar terminology. Labcorp’s actual results, performance, or events may differ materially from these forward-looking statements made or implied due to a number of factors, risks, and uncertainties relating to Labcorp’s business, many of which are beyond Labcorp’s control, including, but not limited to, the spin-off of Labcorp’s Clinical Development and Commercialization Services business, now Fortrea Holdings Inc., the impact of global economic and market conditions on Labcorp’s business, future business strategies, expected savings, synergies, and other benefits from acquisitions and other transactions and partnerships, and opportunities for future growth. Further information on potential factors, risks, and uncertainties that could affect actual results, performance, or events is included in Labcorp’s Annual Report on Form 10-K for fiscal year ended December 31, 2024 filed with the Security and Exchange Commission (the “SEC”) on February 25, 2025 (“2024 Annual Report”), as well as Labcorp’s other filings with the SEC. Such forward-looking statements speak only as of the time they are made and Labcorp undertakes no obligation to publicly revise or update any forward-looking statements made in this Proxy Statement, whether as a result of new information, future events or circumstances, or otherwise, except as required by law. Readers are cautioned not to place undue reliance on any of the forward- looking statements.
Information contained on or available through our website is not incorporated by reference in or made part of this Proxy Statement and any references to our website are intended to be inactive textual references only.
LABCORP HOLDINGS INC.
PROXY SUMMARY
Proxy
Summary
This summary highlights information contained elsewhere in this Proxy Statement. This summary does not contain all the information that you should consider, and you should read the entire Proxy Statement carefully before voting. Page references are supplied to help you find further information in this Proxy Statement.
Annual Meeting of Shareholders
|
DATE & TIME
Thursday, May 15, 2025,
RECORD DATE
March 20, 2025
|
MAILING DATE
This Proxy Statement was first mailed or made available to shareholders on or about | |
|
VIRTUAL MEETING
www.virtualshareholder meeting.com/LH2025 |
VOTING
Shareholders as of the
| |
Voting Matters and
Vote Recommendation
(PAGE 12)
The following table summarizes the proposals to be
considered at the 2025 Annual Meeting and the Board of
Directors’ of the Company (the “Board”) voting
recommendation with respect to each proposal.

|
1. Election of Directors
The Board recommends a vote FOR each of our director nominees |
(PAGE 35) | ||||

|
2. Advisory Vote to Approve the Compensation of our Named Executive Officers
The Board recommends a vote FOR this proposal |
(PAGE 90) |
| |||

|
3. Vote to Approve the Company’s 2025 Omnibus Incentive Plan
The Board recommends a vote FOR this proposal |
(PAGE 92) |
| |||

|
4. Vote to Approve the Company’s 2025 Employee Stock Purchase Plan
The Board recommends a vote FOR this proposal |
(PAGE 103) |
| |||

|
5. Ratification of Deloitte & Touche LLP as our Independent Registered Public Accounting Firm for 2025
The Board recommends a vote FOR this proposal |
(PAGE 108) |
| |||
2025 PROXY STATEMENT 1
PROXY SUMMARY
How to Cast Your Vote
(PAGE 13)
You can cast your votes by any of the following methods:

|
Complete, sign, and return your proxy card or voting instruction card so that it is received before the polls close on Thursday, May 15, 2025. Sign your name exactly as it appears on the proxy card. | |

|
Telephone (1-800-690-6903) until 11:59 p.m., Eastern Daylight Time on Wednesday, May 14, 2025 | |

|
Internet (www.proxyvote.com) until 11:59 p.m., Eastern Daylight Time on Wednesday, May 14, 2025 | |

|
At the Annual Meeting You may participate in and vote your shares live over the internet during the 2025 Annual Meeting by following the instructions posted at www.virtualshareholdermeeting.com/LH2025.
Even if you plan to attend the virtual Annual Meeting, we recommend that you also submit your proxy card or vote by telephone or via the Internet by the applicable deadline so that your vote will be counted if you later decide not to attend the meeting. | |
2024 Company Performance Highlights
(PAGE 51)
The Company achieved solid operational and financial performance across a broad range of measures.
|
Revenues from Continuing Operations:
Full year of $13.0 billion, versus last year’s $12.2 billion |
Diluted Earnings Per Share (“EPS”) from Continuing Operations:
Full year of $8.84, versus $4.33 last year |
Adjusted EPS from Continuing Operations:
Full year of $14.57, versus $13.56 last year(1) |
Free Cash Flow:
Full year of $1.10 billion, versus last year’s $787.7 million |
Transactions:
Announced 10 transactions and launched innovative tests meeting significant unmet medical needs in key specialty areas in full year 2024
|
| (1) | See reconciliation of Net Income to Adjusted Net Income and the Calculation of Adjusted EPS on page 52. |
2 LABCORP HOLDINGS INC.
PROXY SUMMARY
Board of Director Highlights
Snapshot of 2025 Director Nominees
Our Director Nominees Exhibit an Effective Mix of Skills, Experiences, Diversity, and Fresh Perspectives
| TENURE OF DIRECTORS | ||
| 9 Years Average Tenure |
| |
|
AGE OF DIRECTORS | ||
| 61.6 Years Average Age |
| |
|
DIVERSITY OF DIRECTORS | ||
| 60% Total Diversity
|
| |
|
All Director Nominees Exhibit:
• personal and professional integrity;
• diverse skill sets and experience to advise the Company regarding its medical, scientific, operational, strategic, technology, and governance goals;
• interest, capacity, and willingness to serve the long-term interests of the Company’s shareholders;
• ability and willingness to devote the required amount of time and intellectual effort to the Company’s affairs, including attendance at Board and Committee meetings;
• exceptional ability and judgment; and
• freedom from personal and professional relationships that would adversely affect the ability to serve the best interests of the Company and its shareholders.
|
SKILLS AND EXPERTISE

Business Strategy Experience

Corporate Finance and M&A

Corporate Governance Experience

Executive Leadership Experience

Healthcare/Clinical Research Background

International Experience

Risk Management Experience

Sales and Marketing Background

Talent Management Expertise

Technology/Cybersecurity Expertise
2025 PROXY STATEMENT 3
PROXY SUMMARY
Director Nominees (page 35)

4 LABCORP HOLDINGS INC.
PROXY SUMMARY
Board Refreshment Timeline

2025 PROXY STATEMENT 5
PROXY SUMMARY
Shareholder Engagement Highlights
(PAGE 17)
Through our robust and regular shareholder engagement process, we have received valuable feedback that informs our decisions regarding our strategy and our corporate governance practices and policies, in addition to other important topics, which we believe is a critical component to our success.
| Engaged with shareholders representing more than 80%
of our outstanding shares and participated in >300 in-person and virtual meetings and calls
|
During fiscal 2024, through our active shareholder engagement program we discussed key areas of shareholder interest, including:
• Earnings and financial performance
• Compensation practices, specifically pay-for-performance, and alignment with strategy
• Board composition, refreshment, and leadership
• Board focus and oversight relating to environmental impact and sustainability, data privacy and security, artificial intelligence, and employee health and safety
• Enterprise risk management, including compliance, cybersecurity, and third-party risk management
• Human capital management, including recruitment and retention of talent
|
Executive Compensation Highlights
Pay for Performance (page 86)
Labcorp’s executive compensation program is designed to attract, motivate, and retain executives in a highly competitive environment. Our executive compensation philosophy is to pay for performance by rewarding the achievement of specific short-term and long-term financial, operational, and human capital related goals.
Labcorp seeks to achieve outstanding performance for our shareholders through focusing our executives on adjusted operating income, revenues, adjusted EPS, net orders for our Biopharma Laboratory Services (“BLS”) segment, and relative Total Shareholder Return (“TSR”) compared to the peer group of companies we use for executive compensation purposes. Our compensation program rewards our executives for achieving financial objectives, while providing us the opportunity to modify their payouts based on achievement of corporate and environmental, social, and governance goals and individual contributions. A majority of the value of our named executive officers’ annual target compensation opportunity, including performance-based cash compensation and performance shares, is subject to the achievement of Company objectives, which provides a strong incentive to drive Company performance and increase shareholder value.
Last year, our annual advisory vote on the compensation of our named executive officers received support from approximately 92% of the shares represented and entitled to vote at the 2024 Annual Meeting of Shareholders. We are committed to refining our compensation program to incentivize our leaders and align with our strategy, the key value drivers of our business, and the expectations of our shareholders. We regularly seek input from our shareholders and this input is incorporated in the Compensation and Human Capital Committee’s (“CHC Committee”) annual review of our compensation program.
2024 Executive Total Compensation (page 70)
The CHC Committee takes several factors into consideration when establishing our executive compensation target opportunity and structure, including:
| • | alignment of compensation programs with growth drivers of the Company’s business; |
| • | competitive market data (including peer companies, supplemented by published survey data) in order to tailor total compensation (base salary plus the target amounts under our annual cash incentive and long-term incentive arrangements) to be competitive with the market; |
| • | Company and individual performance, role and contribution, and executive skill and experience, in order to make adjustments for individual pay levels; |
| • | emerging best practices in executive compensation presented by its independent compensation consultant; |
| • | input from shareholders; and |
| • | a greater emphasis on the variable or at-risk portion of compensation relative to fixed compensation. |
6 LABCORP HOLDINGS INC.
PROXY SUMMARY
For 2024, approximately 76% of the total target compensation set by the CHC Committee in February 2024 for Mr. Schechter, our President and Chief Executive Officer (“CEO”), was performance-based and at-risk. For the other Named Executive Officers (“NEOs”), except for Ms. Wang, who was not an employee of the Company as of February 2024, approximately 68% of the average total target compensation was performance-based and at-risk. The charts below show the mix of pay elements included in total compensation opportunities for 2024 for our CEO and an average for our other NEOs (other than Ms. Wang):
CEO PAY MIX BASED ON TARGET AWARD OPPORTUNITIES

OTHER NEO PAY MIX BASED ON TARGET AWARD OPPORTUNIES1


|
| (1) | NEO pay excludes Ms. Wang |
2025 PROXY STATEMENT 7
PROXY SUMMARY
Our market-leading compensation practices are designed with features to further align the interests of our executives with those of our shareholders:
|
What We Do
| ||||
|
|
Maintain robust stock ownership requirements for executives (six times base salary for the Chief Executive Officer and three times base salary for Executive Vice Presidents)
| |||
|
|
Cap annual incentive opportunity to discourage inappropriate risk-taking
| |||
|
|
Cap cash severance payments to executive officers under arrangements subject to the Company’s Cash Severance Policy at 2.99x the sum of the executive officer’s base salary and target annual incentive award
| |||
|
|
Provide only “double trigger” change-in-control accelerated vesting provisions
| |||
|
|
Maintain a robust Incentive Compensation Recoupment Policy that requires clawback of cash- and incentive-based compensation upon the occurrence of certain events
| |||
|
|
Provide annual incentives linked to strategic and objective financial goals, which take into account company-wide performance
| |||
|
|
||||
|
|
Provide an annual target mix of performance oriented long-term incentives that include performance shares (generally 60% of target grant value), with the remainder split between non-qualified stock options (20% of target grant value), and restricted stock units (20% of target grant value) with multi-year vesting
|
|||
|
|
Conduct annual shareholder outreach to engage on a variety of matters, including executive compensation
|
|||
|
|
Accrue dividend equivalent rights on restricted stock units and performance shares, which are only paid if and when the underlying shares vest
|
|||
|
|
Maintain an insider trading policy that, among other things, requires pre-clearance of all Company common stock transactions and limits transactions to a specified trading window for key employees
|
|||
|
What We Don’t Do
| ||||
|
|
Allow pledging or hedging of Company common stock
| |||
|
|
Provide tax gross-ups, including on severance or change-in-control payments
| |||
|
|
Use employment agreements except in connection with the hiring of our Chief Executive Officer
| |||
|
|
||||

|
Offer excessive change-in-control benefits
|
|||
|
|
Pay dividends on unvested performance awards and restricted stock units that are not earned
|
|||
Compensation Plan Proposal Highlights
Adoption of 2025 Omnibus Incentive Plan (page 92)
We ask that our shareholders approve adoption of the proposed 2025 Omnibus Incentive Plan. The Board believes that the Company’s incentive compensation plans are valuable compensation tools that align individual and corporate performance with the interests of the Company’s shareholders. The proposed 2025 Omnibus Incentive Plan renews and updates our long-standing performance-based incentive programs, including replacing the Labcorp Holdings Inc. Amended and Restated 2016 Omnibus Incentive Plan, and retains compensation-related best practices, such as, without limitation: with respect to options and stock appreciation rights, requiring minimum vesting periods, prohibiting repricing and liberal recycling, and generally prohibiting exercise price being less than 100% of fair market value; placing limitations on non-employee director compensation; subjecting incentive compensation to the Recoupment Policy; no evergreen provision; robust transfer restrictions; and requiring shareholder approval of material amendments.
8 LABCORP HOLDINGS INC.
PROXY SUMMARY
Adoption of 2025 Employee Stock Purchase Plan (page 103)
We ask that our shareholders approve adoption of the 2025 Employee Stock Purchase Plan. The Board believes that an employee stock purchase plan encourages the Company’s employees to acquire shares of Common Stock, thereby fostering broad alignment of employees’ interests with the interests of our shareholders, fosters good employee relations, and provides the Company the ability to recruit, retain, and reward employees in an extremely competitive environment both domestically and internationally. The Board has proposed approval of the 2025 Employee Stock Purchase Plan by shareholders to replace the Labcorp Holdings Inc. Amended and Restated 2016 Employee Stock Purchase Plan.
Environmental, Social, and Governance (“ESG”) Highlights
(PAGE 15)
The Company is committed to operating responsibly in our business activities; investing in the development of our talent and supporting employee experience and well-being; undertaking meaningful and measurable environmental sustainability efforts; and having a positive social impact by supporting our communities. Below are some highlights of our activities in support of these commitments. Additional details of the Company’s efforts are available in our Corporate Responsibility Report available on the Company’s website.
|
Talent Initiatives & Ongoing Programs | ||
|
• Launched a listening strategy in 2024, features measuring employee experience, inclusion, and well-being
• Continued support of our Employee Resource Groups (ERGs), created and led by employee volunteers and open to all employees, of any background, resulting in over a 40% increase in engagement compared to 2023
• Continued support of mentoring programs, including a formal mentoring initiative
• Fostered opportunities for greater engagement between employees and management, including quarterly global town halls, interactions with front-line employees on visits to our facilities, and in-person town halls with employees across business units and functions
• Harmonized the U.S. paid holiday policies across eligible U.S. non-exempt employees
| ||
|
Community | ||
|
• The Labcorp Charitable Foundation donation to the American Red Cross Disaster Responder Program supported Red Cross efforts to have critical systems and supplies in place to help communities face natural disasters and other emergencies
• Labcorp, its employees, and The Labcorp Charitable Foundation continued their collaborative support of the annual Employee Giving campaign, which serves as an opportunity for colleagues across the globe to support identified charities aligned with our mission to improve health and improve lives, including the American Cancer Society, American Diabetes Association, American Heart Association, National Urban League, Project Hope, United Way, and new in 2024, the International Committee of the Red Cross
• Company employees mobilized to raise funds, organize donation drives, and provide direct assistance to communities impacted by hurricanes in the U.S.
• Continued support of the Team Up for Healthy Communities program, a three-month initiative mobilizing employees to volunteer in local communities
| ||
|
Environment | ||
|
• Continued our progress on meeting our Science Based Targets for combined Scope 1 and 2 emissions and Scope 3 emissions using 2020 as a baseline year, including decreasing our Scope 1 and 2 (market-based) emissions per million dollars of revenue by 23% versus 2020
• Reduced our total water withdrawal per million dollars of revenue by 21% versus 2020
• Improved fuel efficiency of our U.S. vehicle fleet by 5.8% versus 2021, with all U.S. courier fleet orders in 2024 involving hybrid vehicles
• Maintained EcoVadis Bronze rating (improving score of 52 to 58) and CDP Climate Change B rating
| ||
2025 PROXY STATEMENT 9
PROXY SUMMARY
|
Corporate Governance | ||||
|
• Annual election of directors by majority vote
• Majority voting in uncontested director elections
• All independent director nominees, other than our Chief Executive Officer
• Independent Board Committees
• Annual Board and Committee self-assessments
• Shareholder right to call special meetings
• Maintain ESG Executive Steering Committee within management
• Cap cash severance payments to executive officers under arrangements subject to the Company’s Cash Severance Policy at 2.99x the sum of the executive officer’s base salary and target annual incentive award |
• Annual “say-on-pay” advisory vote
• A strong Lead Independent Director
• Anti-Hedging, Clawback, and Anti-Pledging policies
• Shareholder proxy access right
• Robust director stock ownership guidelines
• Active shareholder engagement
• Shareholder right to act by written consent
• Oversight of Company lobbying and political contributions
• Regular executive sessions of independent Directors
• Strategy and risk oversight by full Board and committees | |||
Ratification of Auditors
(PAGE 108)
We ask that our shareholders ratify the selection of Deloitte & Touche LLP as our independent registered public accounting firm for the year ending December 31, 2025.
Below is summary information about Deloitte & Touche LLP’s fees for services provided in fiscal years 2024 and 2023 respectively.
| 2024 | 2023 | |||||||
| Audit Fees(1) |
$ | 3,125,000 | $ | 3,275,000 | ||||
| Audit Related Fees(2) |
$ | 449,550 | $ | 4,329,363 | ||||
| Tax Fees(3) |
$ | 27,603 | $ | - | ||||
| All Other Fees(4) |
$ | 1,895 | $ | 23,015 | ||||
| TOTAL |
$ | 3,604,048 | $ | 7,627,378 | ||||
| (1) | Audit Fees include fees incurred for the audit of the Company’s annual financial statements included in the Company’s Annual Report on Form 10-K, review of financial statements included in the Company’s quarterly reports on Form 10-Q, and services that were normally provided by Deloitte & Touche LLP in connection with statutory and regulatory filings or engagements. |
| (2) | Audit Related Fees include fees incurred for assurance and related services that are reasonably related to the performance of the audit or review of the |
| (3) | Tax Fees related to advisory services provided to the Company’s Canadian subsidiary. |
| (4) | All Other Fees are fees incurred for any services not included in the other categories of fees. All Other Fees consisted of accounting research software and facilitation of a subsidiary board meeting. |
Proxy Statement
Labcorp is providing you with these proxy materials in connection with its 2025 Annual Meeting of Shareholders (the “2025 Annual Meeting”). The Notice of Internet Availability of Proxy Materials (the “Notice”), this Proxy Statement and the 2024 Annual Report were first mailed to shareholders of record on or about April 4, 2025. As used in this Proxy Statement, “Labcorp,” the “Company” and “we” may refer to Labcorp Holdings Inc. itself, one or more of its subsidiaries, or Labcorp Holdings Inc. and its consolidated subsidiaries, as applicable.
10 LABCORP HOLDINGS INC.
GENERAL INFORMATION
General Information
2025 Annual Meeting of Shareholders
Labcorp’s 2025 Annual Meeting is scheduled to occur on Thursday, May 15, 2025, at 9:00 a.m., Eastern Daylight Time. The 2025 Annual Meeting will be a virtual meeting and will be webcast live at www.virtualshareholdermeeting.com/LH2025. We believe that conducting the 2025 Annual Meeting as a virtual meeting will encourage higher levels of shareholder participation, while also helping us to limit the financial and environmental costs associated with the 2025 Annual Meeting. Shareholders at the virtual-only meeting will have the same rights as at an in-person meeting, including the rights to vote and ask questions through the virtual meeting platform.
All owners of Labcorp’s common stock, par value $0.10 per share (the “Common Stock”), on March 20, 2025, the record date (the “Record Date”), are eligible to receive notice of, and to vote electronically at, the 2025 Annual Meeting over the Internet by using the 16-digit control number included in the Notice, proxy card, or the voting instructions that accompanied these proxy materials. Representatives of Deloitte & Touche LLP, independent auditor for Labcorp for the year ending December 31, 2024, will be present at the 2025 Annual Meeting, will have the opportunity to make a statement if they desire to do so, and will be available to respond to appropriate questions.
The virtual meeting platform is fully supported across browsers (Microsoft Edge, Firefox, Google Chrome, and Safari) and devices (desktops, laptops, tablets, and cell phones) running the most updated version of applicable software and plugins. Participants should ensure that they have a strong internet or WiFi connection wherever they intend to participate in the 2025 Annual Meeting. Participants should also give themselves plenty of time to dial-in to the conference call or log in and ensure that they can hear audio prior to the start of the 2025 Annual Meeting.
If you encounter any difficulties while accessing the virtual meeting during the check-in or meeting time, a technical assistance phone number will be made available on the virtual meeting registration page 15 minutes prior to the start time of the meeting.
If you wish to submit a question, or make a comment during the meeting, log into the virtual meeting platform at
www.virtualshareholdermeeting.com/LH2025, type your question into the “Ask a Question” field, and click “Submit” or send your question or comment via email to investor@Labcorp.com. Any emailed questions or comments will need to include your 16-digit control number in order to be addressed at the meeting.
Questions and comments submitted via the virtual meeting platform that are pertinent to meeting matters will be addressed during the meeting. It has been Labcorp’s policy to address all pertinent questions and comments during the meeting and, historically, management has been successful in doing so. In the unlikely event that the volume of questions increases to the point that time constraints prohibit Labcorp from answering all questions, the remaining pertinent questions will be answered on our Investor Relations site. Consistent with Labcorp’s approach when the annual meetings were held in person, questions or comments that are not related to the proposals under discussion, are about personal concerns not shared by shareholders generally, or use blatantly offensive language may be ruled out of order.
A webcast of the 2025 Annual Meeting will be archived and accessible through December 31, 2025.
Important Notice Regarding the Availability of Proxy Materials for the Shareholder Meeting to Be Held on May 15, 2025
Pursuant to the “notice and access” rules adopted by the SEC, Labcorp has elected to provide access to its proxy materials and the 2024 Annual Report over the Internet and sent the Notice to shareholders of record as of the Record Date on or about March 20, 2025. The Notice is not a form for voting and presents only an overview of the more complete proxy materials, which contain important information about the 2025 Annual Meeting. All shareholders may access the proxy materials on the website referred to in the Notice (www.proxyvote.com) and we encourage shareholders to do so prior to submitting their votes. Shareholders may request to receive a printed set of the proxy materials by following the instructions provided in the Notice.
2025 PROXY STATEMENT 11
GENERAL INFORMATION
Shareholders may also request to receive future proxy materials in printed form by mail or electronically by e-mail on an ongoing basis by following the instructions on your proxy card or at www.proxyvote.com. Choosing to receive proxy materials by e-mail will save Labcorp the cost of printing and mailing documents and will reduce the impact of Labcorp’s annual meetings on the environment. If you choose to receive future proxy materials by e-mail, you will receive an e-mail next year with instructions containing a link to those materials and a link to the proxy voting site. Your election to receive proxy materials by e-mail will remain in effect until you terminate it.
Matters Subject to a Vote of the Shareholders
Current Proposals
The following matters are subject to a vote of the shareholders at the 2025 Annual Meeting:
| • | Election of directors from among the nominees described in this Proxy Statement (see page 35); |
| • | Approval, on a non-binding advisory basis, of the compensation of our named executive officers (see page 90); |
| • | Approval of the Company’s 2025 Omnibus Incentive Plan (see page 92); |
| • | Approval of the Company’s 2025 Employee Stock Purchase Plan (see page 103); and |
| • | Ratification of the appointment of Deloitte & Touche LLP as our independent registered public accounting firm for the year ending December 31, 2025 (see page 108). |
Board Recommendations
The Board of Directors of the Company (the “Board”) unanimously recommends that shareholders vote as follows:
| • | “FOR” the election of each of the nominees for director; |
| • | “FOR” the approval, on a non-binding advisory basis, of the compensation of our named executive officers; |
| • | “FOR” the approval of the Company’s 2025 Omnibus Incentive Plan; |
| • | “FOR” the approval of the Company’s 2025 Employee Stock Purchase Plan; and |
| • | “FOR” the ratification of the appointment of Deloitte & Touche LLP as our Company’s independent registered public accounting firm for the year ending December 31, 2025. |
Other Business
The Board does not intend to bring any other business before the 2025 Annual Meeting and is not aware of any other matters to be brought before the meeting. See the section “Other Matters” on page 113 for information about presenting proposals for the 2025 Annual Meeting. Please also see the section “Identification and Evaluation of Director Candidates” on page 24 for information about shareholder nominations to the Board.
Voting Procedures and Solicitation of Proxies
Quorum and Voting Requirements
The Board is soliciting your vote at the 2025 Annual Meeting or at any later meeting should the scheduled annual meeting be adjourned or postponed for any reason. By using a proxy, which authorizes specific people to vote on your behalf, your shares can be voted whether or not you attend the 2025 Annual Meeting. At least a majority of the total number of shares of Common Stock issued and outstanding and entitled to vote on the Record Date must be present in person or by proxy at the 2025 Annual Meeting for a quorum to be established. At the close of business on the Record Date, there were 83,668,573 shares of Common Stock issued and outstanding.
Each share of Common Stock is entitled to one vote for each of the director nominees and one vote for each other matter that is properly presented at the 2025 Annual Meeting. In accordance with Labcorp’s Amended and Restated By-Laws (the “By-Laws”), director nominees in an uncontested election must receive a majority of the votes cast to be elected, which under the By-Laws means that the number of shares voted “FOR” a director must exceed 50% of the votes cast with respect to that director. The Board has adopted a policy under which a director who does not receive the required vote for election as provided in the By-Laws will submit their resignation for consideration by the Board. The affirmative vote of a majority of shares of Common Stock represented at the 2025 Annual Meeting and entitled to vote is required for approval of the other proposals noted above. While the vote to approve the compensation of our named executive officers is advisory in nature and non-binding, the Board will review the voting results and expects to take them into consideration when making future decisions regarding executive compensation. Abstentions will have no effect on the election of the directors, but will have the same effect as a vote against the other proposals scheduled for the 2025 Annual Meeting.
12 LABCORP HOLDINGS INC.
GENERAL INFORMATION
|
Voting by Record Holders | ||||||
| If your name is registered in Labcorp’s shareholder records as the owner of shares, there are four ways that you can vote your shares: | ||||||
| You can cast your votes by any of the following methods:
| ||||||
|
Complete, sign, and return your proxy card or voting instruction card so that it is received before the polls close on Thursday, May 15, 2025. Sign your name exactly as it appears on the proxy card.
|
INTERNET (www.proxyvote.com) until 11:59 p.m., Eastern Daylight Time on Wednesday, May 14, 2025 |
TELEPHONE (1-800-690-6903) until 11:59 p.m., Eastern Daylight Time | ||||
|
At the Annual Meeting You may participate in and vote your shares live over the Internet during the 2025 Annual Meeting by following the instructions posted at www.virtualshareholdermeeting.com/LH2025. Even if you plan to attend the virtual Annual meeting, we recommend that you also submit your proxy card or vote by telephone or via the Internet by the applicable deadline so that your vote will be counted if you later decide not to attend the meeting.
| ||||||
You may change your vote or revoke a proxy at any time prior to the 2025 Annual Meeting by:
| • | Entering new instructions on either the telephone or Internet voting system before 11:59 p.m. Eastern Daylight Time on Wednesday, May 14, 2025; |
| • | Sending a new proxy card with a later date than the previously submitted proxy card. The new proxy card must be received before the polls close at the 2025 Annual Meeting on Thursday, May 15, 2025; or |
| • | Writing to Labcorp at 358 South Main Street, Burlington, North Carolina 27215, Attention: Sandra D. van der Vaart, Secretary. Your letter should contain the name in which your shares are registered, the date of the proxy you wish to revoke or change, your new voting instructions, if applicable, and your signature. Your letter must be received before the polls close at the 2025 Annual Meeting on Thursday, May 15, 2025. |
All proxies duly executed and received by Labcorp will be voted in accordance with the instructions provided by the person executing the proxy or, in the absence of any instruction, will be voted in accordance with the Board’s recommendations on each proposal. Proxies will have the discretion to vote on any other matters that come before the 2025 Annual Meeting that are not otherwise specified in the Notice.
Voting by Holders in Street Name
If you hold shares through a bank, broker, or other custodian (referred to as shares held in “street name”), the custodian will provide you with a copy of the Proxy Statement and a voting instruction form. Brokers and other holders of record have discretionary authority to vote shares without instructions from beneficial owners only on matters considered “routine” by the New York Stock Exchange (the “NYSE”), such as the advisory vote on the selection of the independent auditors. On non-routine matters, such as the election of directors, the approval of the Company’s 2025 Omnibus Incentive Plan, and the approval of the Company’s 2025 Employee Stock Purchase Plan, these banks, brokers, and other holders of record do not have discretion to vote uninstructed shares and thus are not “entitled to vote” on such proposals, resulting in a broker non-vote for those shares. We encourage you to provide voting instructions so that your shares can be counted in the election of directors and the other matters to be considered at the 2025 Annual Meeting.
Even if your shares are held in street name, you may participate in the virtual 2025 Annual Meeting and vote your shares during the meeting by visiting www.virtualshareholdermeeting.com/LH2025, listening to the live webcast and casting your vote online. See “2025 Annual Meeting of Shareholders” above for information about participating in the 2025 Annual Meeting.
2025 PROXY STATEMENT 13
GENERAL INFORMATION
Proxy Expenses
Labcorp will bear the expenses to prepare proxy materials and to solicit proxies for the 2025 Annual Meeting. Labcorp expects to reimburse banks, brokers, and other persons for their reasonable, out-of-pocket expenses in handling proxy materials for beneficial owners. Labcorp has also retained Morrow Sodali LLC for solicitation of holders of record as well as non-objecting beneficial owners. Labcorp paid Morrow Sodali LLC a fee of approximately $11,000 for these services, plus reimbursement of expenses. These solicitations may be made personally or by mail, facsimile, telephone, messenger, email, or otherwise.
Results of the 2025 Annual Meeting
The voting results of the 2025 Annual Meeting will be disclosed no later than four business days after the 2025 Annual Meeting in a Current Report on Form 8-K filed with the SEC.
14 LABCORP HOLDINGS INC.
CORPORATE GOVERNANCE
Corporate Governance
Labcorp is committed to social and environmental matters and to maintaining strong corporate governance practices. Our commitment to these matters stems from our belief that the measure of a company is not just how well it does, but how it goes about its business, how its people and customers feel about it, and the mark it leaves on society. We believe that our investments in our people and our communities and in our actions aimed at preserving the environment and evolving our operations in increasingly sustainable ways, support our commitment to improving health and improving lives across our global communities.
Environmental, Social, and Governance
We publish a Corporate Responsibility Report, which highlights our commitment to environmental and social responsibility, including our progress against our 2025 environmental sustainability goals. A copy of our 2024 Corporate Responsibility Report will be available under the Corporate Governance section of the Investors page on our website. Nothing on our website, including our 2024 Corporate Responsibility Report, shall be deemed incorporated by reference into this Proxy Statement.
Labcorp’s ESG Executive Steering Committee (“ESC”), comprised of cross-functional and senior management leaders, drives our long-term vision and strategic priorities in key ESG areas. The ESC regularly evaluates our performance across environmental sustainability, employee well-being, corporate social responsibility, governance, and relevant public policy issues. The co-Chairs of the ESC regularly report to the Executive Committee and the Board on ESG matters to provide alignment, consistency, and efficiency on oversight and implementation of ESG matters.
Environmental
We received approval in 2023 of our Science Based Targets (“SBTs”) for combined Scope 1 and 2 emissions and Scope 3 emissions from the Science Based Targets initiative. We also continued to assess and act on opportunities within our operations and activities linked to our sustainability drivers and made notable progress toward our near-term environmental and sustainability targets. For example, we have decreased our Scope 1 and 2 (market-based) emissions per million dollars of revenue by 23% versus 2020 and reduced our total water withdrawal per million dollars of revenue by 21% versus 2020. Moreover, versus our 2021 baseline, we have improved the fuel efficiency of our U.S. vehicle fleet by 5.8% and, versus our 2020 baseline, we have increased waste reclaimed per million dollars of revenue by 27%. (To more accurately reflect our operations following the spin-off of Fortrea Holdings Inc. (“Spin-Off”) in 2023, our energy, waste, and water data has been rebaselined.)
We also continue to participate in the EcoVadis and CDP environmental sustainability ratings. In 2024, we received a Bronze Rating from EcoVadis, improving our score from 52 to 58. For CDP Climate Change, we maintained our “B” rating. We have used the knowledge gained from our CDP and EcoVadis participation to refine our carbon and energy reduction strategy.
Our Board has delegated the oversight of our environmental risks and initiatives to our Quality and Compliance Committee.
Human Rights
We recognize the importance of maintaining and promoting fundamental human rights in our operations and throughout our supply chain, and we operate under principles and guidance derived from the United Nations, the International Labor Organization, and the Organization for Economic Cooperation and Development. Our Quality and Compliance Committee and CHC Committee have oversight over these risks and report regularly to the Board. The Company operates under policies and programs that (i) promote fair and equitable wages, benefits, and other conditions of employment in accordance with local laws, (ii) recognize employees’ right to freedom of association, (iii) provide humane and safe working conditions, (iv) support a work environment that is free from human and sexual trafficking, forced and bonded labor, and unlawful child labor, (v) promote a workplace free of discrimination and harassment, and (vi) address the human rights and environmental issues connected with the mining and trading of conflict minerals.
Talent Initiatives and Ongoing Programs
Our global talent is core to our ability to innovate and meet a wide range of patient and customer needs. Our talent initiatives support the development of inclusive leadership and culture, enhancing the team member experience, and supporting community engagement and patient focus.
2025 PROXY STATEMENT 15
CORPORATE GOVERNANCE
Our workforce composition demonstrates Labcorp’s commitment to a well-balanced, stable workforce that reflects the patients, customers, and communities we serve. In 2024, Labcorp was named to The American Opportunity Index, Top 100 Employer; Disability Equality Index, Best Places to Work for People with Disabilities; Forbes, America’s Best Employers for Diversity; Forbes, America’s Best Large Employers; Forbes, Best In-State; Fortune, World’s Most Admired Companies; Military Friendly, Military Friendly Employer; and Time, World’s Most Sustainable Companies.
The CHC Committee oversees our strategic framework to advance our culture. With a workforce of nearly 70,000 employees across 17 countries, our mission to improve health and improve lives is at the core of our culture. To drive our global growth strategy and advance our mission, we prioritize building an engaged, highly skilled, and inclusive workforce. Our Employee Value Proposition, “Embrace Possibilities, Change Lives,” reflects insights from comprehensive employee surveys and aligns with our values, mission, and strategic objectives. Our efforts to be an employer of choice are guided by four pillars: (i) Impact; (ii) Team Member Experience; (iii) Customer Engagement; and (iv) Patient Focus. In support of these pillars, in 2024 the Company continued to implement actions including:
| • | Launching a listening strategy, featuring measuring employee experience, inclusion, and well-being; |
| • | Recognition of locally relevant celebrations of cultural events reflecting the breadth of different cultures, constituencies, and observances throughout the year; |
| • | Continued deployment of anti-harassment training to employees around the world; |
| • | Continued support of mentoring programs, including a formal mentoring initiative; |
| • | Continued opportunities for greater engagement between employees and management, including quarterly global town halls, which are held virtually and are open to all employees, interactions with front-line employees on visits to our facilities, and in-person town halls with employees across business units and functions; and |
| • | Harmonized the U.S. paid holiday policy to now recognize six company-designated holidays and one floating holiday – providing a more consistent and inclusive experience for eligible U.S. non-exempt employees. By offering the flexibility of a floating holiday, we aim to better accommodate the unique needs, beliefs, and backgrounds of our workforce. |
Our employees also have continued to engage through our expanding array of ERGs, another avenue through which we strive to support inclusiveness. ERGs are led by employee volunteers and are important resources to foster cross-company connections, encourage belonging, support career development, and champion employee voices. The Company now has eight unique ERGs with 118 chapters globally. Each ERG has executive sponsorship from senior leadership and is open to all employees, of any background.
Community
Labcorp’s mission to improve health and improve lives around the globe extends beyond healthcare settings. The Access for All initiative, established in 2023, leads community engagement efforts of Labcorp, its employees, and The Labcorp Charitable Foundation. With a focus on health and welfare, education and community development, we leverage our resources and operations to deliver meaningful assistance through strategic philanthropy and dedicated employee volunteerism.
In 2024, colleagues continued to support the Company’s global Employee Giving Campaign. Through this campaign colleagues collectively supported the following charities: American Cancer Society; American Diabetes Association; American Heart Association; American Red Cross; National Urban League; Project HOPE; United Way; and new in 2024 to expand our global reach, the International Committee of the Red Cross. These agencies align with our mission by leading the way in healthcare research, providing services to benefit the underserved, and supporting those affected by disaster.
The Labcorp Charitable Foundation, a private 501(c)(3) organization funded by Labcorp, is committed to creating a positive impact for communities around the globe. Through its support of programs and initiatives aligning within the areas of health, education, and community, the Foundation serves as a catalyst for Labcorp’s commitment to improve health and improve lives. Since its inception, the Foundation has invested in over 500 grants, including over 200 grants awarded in 2024. These contributions address social determinants of health, support medical research and screenings, promote a healthy lifestyle in disadvantaged communities, and support access to STEM educational programming.
Amidst global challenges, The Labcorp Charitable Foundation is also committed to supporting communities in distress through support of the American Red Cross Disaster Responder Program. This ongoing commitment enables the American Red Cross to provide individual emergency assistance; disaster preparedness; food, shelter and relief items; health and emotional support; and community recovery leading up to and following a disaster or crisis. Notably, in response to the devastation caused by storms such as Hurricane Helene and Milton in the U.S., Labcorp employees also directly mobilized to raise funds, organize supply donation drives, and provide in-person assistance to impacted communities.
16 LABCORP HOLDINGS INC.
CORPORATE GOVERNANCE
In addition to The Labcorp Charitable Foundation’s grant investments, it also supports Labcorp’s Double Your Donation and Dollars for Doers employee programs. The Double Your Donation program offers a 1:1 match by The Labcorp Charitable Foundation for Labcorp employee donations to qualifying non-profit organizations up to an employee’s annual cap. The Dollars for Doers program encourages Labcorp employees to support their communities through volunteer service by offering a monetary donation from The Labcorp Charitable Foundation in recognition of their volunteer or board service to eligible non-profit organizations.
For the second consecutive year, Labcorp supported the Team Up for Healthy Communities contest, a three-month program that supports the Access for All initiative and mobilized employees from across the globe to volunteer in local communities in different teams. Additionally, The Labcorp Charitable Foundation provided financial support to the selected nonprofit of each winning team, strengthening the impact of each team’s dedication.
Shareholder Engagement
In 2024, we continued our active shareholder engagement program. Our outreach to shareholders extends beyond operational results and business strategy; we also engage in outreach efforts to specifically discuss corporate governance, executive compensation, ESG, and other matters important to our shareholders. In 2024, we engaged with shareholders that represented more than 80% of the Company’s outstanding shares, including over 300 in-person and virtual meetings and calls, to review and receive input on our corporate governance practices and executive compensation program, our performance, our differentiated and innovative solutions, our social and environmental initiatives and policies, our progress in executing on our strategic priorities as a leading global life sciences company, and our enterprise risk management.
We value the input received from our shareholder engagement program. After reviewing the shareholder feedback with management, the Board uses this input as it considers long-term business strategy, executive compensation, corporate governance, and other emerging areas of shareholder concern.
We also consider the outcome of our annual say-on-pay votes when making executive compensation decisions. See “Proposal Two” below for this year’s “say-on-pay” proposal. Last year, approximately 92% of the shareholders’ votes represented at the 2024 Annual Meeting of Shareholders and entitled to vote on this proposal voted in favor of the proposal. The CHC Committee believes that this approval by a substantial majority of our shareholders demonstrates strong support for our approach to executive compensation and, as a result, the CHC Committee continues to evaluate executive compensation using the same clear principles of performance-based compensation.
| Shareholder Engagement in 2024
| ||
| TYPES OF OUTREACH |
KEY AREAS OF SHAREHOLDER INTEREST | |
| • Healthcare and Investor Conferences and Other Presentations
• One-on-one in-person and virtual meetings and calls
|
• Earnings and financial performance
• Compensation practices, specifically pay-for-performance, and alignment with strategy
• Board composition, refreshment, and leadership
• Board focus and oversight relating to environmental impact and sustainability, data privacy and security, artificial intelligence, and employee health and safety
• Enterprise risk management, including compliance, cybersecurity, and third-party risk management
• Human capital management, including recruitment and retention of talent
| |
2025 PROXY STATEMENT 17
CORPORATE GOVERNANCE
As a result of our shareholder engagement we took action that demonstrates our strong commitment to corporate governance:
| • | ESG Executive Steering Committee (ESC). In 2024, the ESC, along with enterprise risk management leadership, continued to oversee significant ESG matters that reflect our most significant economic, environmental, and social impacts. |
| • | Continued Focus on Company Culture. To drive our global strategy and advance our mission, we prioritize building an engaged, highly skilled, and inclusive workforce. |
| • | Prioritizing Business Diversity. We engage diverse vendors for various aspects of Labcorp’s operations. This includes laboratory supplies, contracted and professional services, collection materials, cleaning and facility management. In 2024, we did business with approximately 1,000 diverse suppliers, many of them small businesses. We also include small-owned businesses in our bidding processes when applicable. |
| • | Commitment to the Environment. Throughout 2024, we continued our focus on sustainability, and our efforts included our ongoing work towards our enterprise-wide carbon and energy reduction goals. Notable actions included investing over $8 million in hybrid and electric vehicles, resulting in a 5.8% improvement in fuel efficiency versus 2021. In addition, we reduced our total water withdrawal per million dollars of revenue by 21% versus 2020. |
| • | Commitment to our Communities. In 2024, supporting the communities in which employees live and work remained a top priority. Through the Access for All initiative, Labcorp’s collaborative approach with its employees and The Labcorp Charitable Foundation supported programs committed to providing access to health, education, and healthy communities worldwide. In addition to the year-round employee engagement programs, Labcorp, its employees, and The Labcorp Charitable Foundation collectively supported company-wide, global campaigns benefiting communities in need through volunteer efforts and donations. Our employees assisted in building homes, collecting food, serving meals, and providing essential items to help in underserved communities. |
| • | Continued Focus on Cybersecurity. We continue to focus on risk-based decision-making and expanded programs designed to assess and address security and data privacy risks of our valued suppliers, outsourced services providers, and other business partners. We also increased data monitoring and protection, including in light of existing and increased risks related to the number of employees that continue to work remotely, risks associated with geopolitical events, and other events beyond the Company’s control, with innovative technology including advanced analytics, artificial intelligence, and machine learning, with the goal of reducing the time to detect, contain, and remediate cyberattacks. |
18 LABCORP HOLDINGS INC.
CORPORATE GOVERNANCE
Board Structure and Independence
Our Board believes that strong corporate governance is the key to maintaining the trust and confidence of our investors, employees, customers, and the communities that we serve. Our Board structure and independence helps establish the foundation needed to operate our business with integrity and accountability and in alignment with the long-standing interests of our shareholders. Below are highlights of how our Board facilitates strong corporate governance at Labcorp.
| Governance Highlights | ||||
| Highly Independent and Diverse Board | • Nine of our ten director nominees are independent
• All Board committees are 100% independent
• Six of our director nominees, representing two-thirds of our independent director nominees, are diverse (i.e., female or ethnic/racial minorities) |
• Directors bring a wide array of qualifications, skills, backgrounds, and attributes to our Board; see “Evaluation of Director Candidates” on page 25 | ||
| Active Board Refreshments | • Five of our independent director nominees, representing over half of the independent director nominees, joined the Board within the past 10 years
• New Lead Independent Director in 2023
• New Chair of the Quality and Compliance Committee in 2024, in addition to new Chairs in 2023 of the CHC Committee and Nominating and Corporate Governance Committee |
• Balanced mix of short- and long-tenured non-executive directors; average tenure of nine years for our director nominees
• Director nominees of varying ages from 49 to 70, providing a mix of perspectives
• Annual review of the appropriate skills and characteristics required of the Board in the context of the Company’s current business needs and strategic priorities to ensure a diverse and robust range of necessary skill sets | ||
| Strong Lead Independent Director | • Active Lead Independent Director with a clearly defined role and responsibilities |
| ||
| Frequent Executive Sessions | • Independent directors meet regularly without management, led by our Lead Independent Director |
• Five executive sessions held in 2024 | ||
| Accountability and Engagement | • Annual election of directors using majority vote standard (no staggered board); plurality standard for contested elections
• Active shareholder engagement, with regular shareholder outreach on issues including Company performance, executive compensation, and ESG policies and practices
• Annual self-assessment of performance and effectiveness conducted by the Board and each Committee |
• 2024 outreach to shareholders representing over 80% of voting shares, including over 300 in-person and virtual meetings and discussions, including discussions with our largest institutional holders | ||
| Proxy Access | • Proxy access allows eligible shareholders to submit nominees to be included in the Company’s Proxy Statement |
| ||
| Shareholder Rights | • Shareholders can act by written consent between meetings |
• Shareholders owning 10% of our common stock can call a special meeting of our shareholders in accordance with our By-Laws | ||
| Equity Ownership Guidelines | • Six times annual base salary for the CEO • Three times annual base salary for all Executive Vice Presidents |
• A value of five times annual director retainer for independent directors | ||
| Succession Planning | • The CHC Committee has primary responsibility for CEO and key executive succession planning |
• Succession and executive development are discussed with the CEO, as well as without the CEO present in executive sessions | ||
| Director Orientation and Development | • Orientation and training programs for new directors on topics that include strategic plans, financial statements, governance, and key policies and practices |
• Continuing education and ongoing training for directors | ||
| Risk Management Oversight | • Board has principal responsibility for oversight of our risk management process, including data security, privacy, and ESG matters |
• The Audit, Compensation and Human Capital, Quality and Compliance, and Nominating and Corporate Governance Committees each are responsible for certain significant functional areas of risk management as outlined under “Board’s Role in Risk Management” (page 22) | ||
2025 PROXY STATEMENT 19
CORPORATE GOVERNANCE
Board Composition
| The cornerstone of our governance philosophy is an independent and highly qualified Board. All directors are elected annually by a majority of votes cast by shareholders. All Board committees are composed entirely of independent directors.
Labcorp’s By-Laws and Corporate Governance Guidelines provide for a Board comprised of no fewer than one and no more than fifteen directors, and no fewer than eight and no more than fifteen directors, respectively. There are currently ten members of the Board, and each member is standing for election at the 2025 Annual Meeting. For more details about the nominees for directors and their biographies, please see “Proposal One – Election of Directors” (page 35).
The Board carefully evaluates each director candidate based on selection criteria and overall priorities for Board composition, including the Board’s commitment to actively developing an inclusive pool of individuals from which director nominees may be selected. The selection criteria are periodically reviewed by the Nominating and Corporate Governance Committee, with input from the rest of the directors. As our directors’ commitments change, the Nominating and Corporate Governance Committee annually evaluates each director’s prior service on and contributions to the Board, to ensure that their service continues to be in the best interests of the Company and our shareholders. We believe that a range of tenure among Board members, coupled with a variety of backgrounds, ensures a balanced mix of longer tenured directors with deep perspectives on our business with fresh and diverse perspectives in the boardroom. Five of the nine non-employee director nominees joined the Board within the past ten years.
It is the policy of the Board that any director who experiences a significant change in responsibilities in such director’s present job will tender their resignation to the Chair of the Board for consideration by the Nominating and Corporate Governance Committee, which will recommend to the Board the action, if any, to be taken with respect to the resignation. In December 2024, Mr. Davis announced he was stepping down in 2025 as Chief Financial Officer of Dollar Tree and, accordingly, submitted an offer of resignation to the Board. Following a review and upon a recommendation of the Nominating and Corporate Governance Committee, the Board declined his offer of resignation. |
The following charts provide information on the expected composition of the directors on our Board if the current nominees are elected at the 2025 Annual Meeting.
DIRECTORS
| |
|
DIRECTOR DIVERSITY
| ||
|
DIRECTOR TENURE
| ||
|
DIRECTOR AGE
|
20 LABCORP HOLDINGS INC.
CORPORATE GOVERNANCE
Board Best Practices
We expect high standards of ethical conduct from our directors and management as described in our Corporate Governance Guidelines and Code of Conduct and Ethics, both of which are available under the Corporate Governance section of the Investors page of our website at www.Labcorp.com. We have included some highlights from these principles and a summary of key governance practices below.
Board Independence
The Board believes that a substantial majority of its members should be independent, non-employee directors. The Board has established guidelines for determining director independence that are consistent with the current listing standards of the NYSE (the “Listing Standards”). In addition, director affiliations and transactions are regularly reviewed to ensure that there are no conflicts or relationships that might impair a director’s independence from the Company, senior management, and our independent registered accounting firm, as defined in the Listing Standards. Other than Mr. Schechter, all of our current Board members and all of the nominees for director qualify as “independent” as defined in the Listing Standards.
Board Leadership
The Chair of the Board leads the Board and oversees Board meetings and the delivery of information necessary for the Board’s informed decision making. The Chair also serves as the principal liaison between the Board and our management. The Board and the Board’s Nominating and Corporate Governance Committee routinely evaluate whether the roles of Chair and CEO should be separated or combined based on its judgment as to the structure that best serves the interests of the Company at the time. At this time, the Board believes that the positions of Chair and CEO should be held by the same person, as this combination provides unified leadership and direction in the management of the Company, contributing to cohesive, strong, and effective long-term vision and strategy, and delivering superior performance for our shareholders. This perspective also takes into account that the Company’s business is complex, with nearly 70,000 people employed worldwide. Our CEO has a deep understanding of the Company’s complex and multifaceted business and global operations, and we therefore believe that he is best placed to raise critical issues that require Board attention and facilitate timely and unfiltered communication between the Board and management.
Since 2009, the Board has required that an independent director serve as Lead Independent Director when (i) the CEO also serves as Chair; or (ii) the Chair otherwise is not an independent director. Accordingly, since 2009, the Board has appointed an active Lead Independent Director, with clearly defined roles and responsibilities that support independent oversight of management. In appointing the Lead Independent Director, the Board carefully considers the skills and experience necessary to undertake the role. The Board believes that appointing a Lead Independent Director provides an efficient and effective leadership model for the Company by fostering clear accountability, effective decision-making, robust risk oversight, alignment on corporate strategy between the Board and management, and a cohesive public face for the Company’s independent Board members. In May 2023, the Board amended the Company’s Corporate Governance Guidelines to provide for the election of the Lead Independent Director by the independent directors of the Board, rather than the full Board.
The Lead Independent Director, among other responsibilities as set forth in the Company’s Corporate Governance Guidelines, presides at executive sessions of the Board, serves as a liaison between the Chair and the other directors, provides feedback from executive sessions to the Chair, remains available, as appropriate, to communicate with the Company’s shareholders and other stakeholders, and advises the Chair with respect to consultants who report directly to the Board. Pursuant to the Company’s Corporate Governance Guidelines, the Lead Independent Director’s responsibilities also specifically include reviewing and approving meeting agendas, working with the Chair to facilitate timely and appropriate information flow to the Board, and reviewing and approving meeting schedules to assure that there is sufficient time for discussion of all agenda items. The Board believes that the Company’s Corporate Governance Guidelines further underscore the robust role of our Lead Independent Director in providing appropriate leadership to the independent directors of the Board and oversight of management.
Effective June 5, 2023, our independent directors appointed Dr. Kong as our Lead Independent Director. In his role as the Lead Independent Director, Dr. Kong meets regularly with Mr. Schechter to review Board agendas, operations, and strategic issues discussed with the Board and other matters relating to the Board’s oversight functions. Dr. Kong also leads the Board in its review of the Company’s enterprise risk management process and the comprehensive assessment of key risks to the Company. Dr. Kong also serves as the Chair of the Nominating and Corporate Governance Committee and, therefore, oversees the Committee’s role in the Board self-assessment process.
In addition, the Company’s Corporate Governance Guidelines provide that the independent directors shall meet on a periodic basis, but no fewer than five times a year on the same day as the regularly scheduled Board meetings. Accordingly, the independent directors of the Board hold executive sessions without Company management. These sessions are generally held at each regularly scheduled meeting of
2025 PROXY STATEMENT 21
CORPORATE GOVERNANCE
the Board, and at each special meeting of the Board upon the request of a majority of the independent directors attending the special meeting. In 2024, Dr. Kong, in his capacity as Lead Independent Director, chaired five meetings of the independent directors to discuss strategy, executive compensation, succession planning, and other matters.
Annual Self-Assessment
As part of its commitment to strong governance, the Board conducts an annual self-assessment of its performance and effectiveness. The purpose of the self-assessment is to determine whether the Board and its committees are functioning effectively and to improve the performance of the Board as a unit. The self-assessment process fosters frank exchanges between directors and helps guide suggested changes or additions to committee responsibilities and operations. As part of the assessment, each director completes detailed questionnaires (including a peer evaluation and an evaluation of each committee on which the director is serving) developed by the Lead Independent Director, and the Lead Independent Director then conducts individual interviews with each director. The Lead Independent Director then leads a discussion of the results of the annual self-assessment with the Nominating and Corporate Governance Committee and separately with the full Board. In addition, each Board committee conducts a similar self-assessment of its performance focused on such committee’s key responsibilities. Feedback from the committees’ self-assessments is reviewed in the applicable committee and also presented to the full Board for review and discussion. These processes allow for each director to individually reflect on Board and committee effectiveness, as well as to discuss performance as a group, providing a meaningful tool to focus on individual and collective areas for improvement. As part of the self-assessment process and the process of considering non-employee directors for reappointment, the Nominating and Corporate Governance Committee also reviews each director’s commitments, including each director’s prior service on and contributions to the Board, job responsibilities, service on other public company boards and leadership positions on any such boards, in accordance with the requirements of our Corporate Governance Guidelines, including related to limitations on serving on other public company boards, and confirms the commitment of each director. All of our directors are currently in compliance with our director commitments policy as set forth in our Corporate Governance Guidelines.
Board’s Role in Risk Management & Committee Structure
The Board oversees management’s establishment and maintenance of the Company’s risk management processes and regularly receives direct reports from those responsible for the operations of the Company. The Board delegates certain significant functional areas of risk management to the Board’s committees. Each committee also conducts its own risk assessment and risk management activities throughout the year, some of which are highlighted in the “Board Committees and Their Functions” section below and reports its conclusions to the Board. The Board also encourages management to promote a corporate culture that integrates risk management into the Company’s corporate strategy and day-to-day business operations in a way that is consistent with the Company’s targeted risk profile.
The Board annually reviews the Company’s enterprise risk management process. This includes assessment of key financial, operational, information technology and security, medical and scientific standards of care, and regulatory risks. The Board also evaluates risks related to the Company’s strategic plan, competitive activities, human capital management, and technological developments, as well as factors that may mitigate those risks.
22 LABCORP HOLDINGS INC.
CORPORATE GOVERNANCE

Cybersecurity Risk Management
The Audit Committee regularly reviews the Company’s cybersecurity and other information technology risks, controls, and procedures, including the potential impact of such risks on the Company’s business, financial results, operations, and reputation, and plans to mitigate cybersecurity risks and respond to cybersecurity incidents. The Audit Committee routinely receives reports at its regularly scheduled meetings from the Chief Information Risk Officer and the Chief Information and Technology Officer on, among other things, the Company’s cyber risks and threats, the status of projects to strengthen the Company’s information security systems, assessments of the Company’s security program, prior incidents, and the emerging cyber threat landscape. In addition, the Board receives briefings from the Chief Information Risk Officer and the Chief Information and Technology Officer at least annually.
Compensation Risk Assessment
The CHC Committee regularly reviews the Company’s compensation policies and procedures to ensure that those practices are consistent with emerging best practices, are aligned with the shareholders’ interests, and support the Company’s objective to attract and retain skilled and talented employees. Throughout the year, management reviews compensation policies, practices, and changes in applicable regulations with the CHC Committee, including the impact of the Company’s pay practices on the Company’s risk profile. The CHC Committee also works directly with its independent compensation consultant, Frederic W. Cook & Co. (“FW Cook”), evaluating the Company’s compensation philosophy and objectives to identify potential risks in the Company’s pay practices. After reviewing FW Cook’s analysis and the CHC Committee’s findings, the Board has concluded that our compensation policies and practices are aligned with the interests of shareholders, appropriately reward pay for performance, and do not create risks that are reasonably likely to have a material adverse effect on the Company.
Board Oversight of ESG
The Board has principal responsibility for oversight of ESG topics, including environmental, social, human capital management, and governance, and delegates targeted oversight of specific areas of focus to its standing committees. For example, our CHC Committee oversees our human capital management risks, and regularly receives updates at its meetings from our Chief Human Resources Officer. Our Quality and Compliance Committee has oversight of our environmental sustainability and health and safety risks. Our Audit Committee is
2025 PROXY STATEMENT 23
CORPORATE GOVERNANCE
responsible for the review of the system and controls over reporting that the Company has in place to ensure the accuracy of key disclosures related to environmental, social, and governance matters. Our Nominating and Corporate Governance Committee has oversight of our governance risks. Each committee regularly reports to the full Board.
Identification and Evaluation of Director Candidates
Identification of Director Candidates
The Nominating and Corporate Governance Committee recommends a slate of directors to the Board for election by the Company’s shareholders at each annual meeting of shareholders and also recommends candidates to the Board to fill any vacancies. Members of the Board are encouraged to identify potential candidates, who are evaluated by the Committee. In addition, the Committee is authorized to engage professional search firms at the Company’s expense to assist with the identification, evaluation, and due diligence of potential nominees for the Board. The Committee believes it is important to maintain a Board with diverse experiences and expertise in a range of areas including industry, operations, scientific and medical, financial, global business, and executive leadership.
The Committee annually evaluates each director’s prior service on and contributions to the Board and considers other commitments of Board members and candidates, including other public company leadership roles and service on other public company boards, including board and board committee leadership roles. Relatedly, we limit the number of public company boards on which directors who are executive officers of the Company and non-employee directors can serve to two and five, respectively, each including our Board. We also limit the number of public company board audit committees that directors can serve on to three, including the Audit Committee of our Board, unless the Board determines that such service would not impair the ability of the director to effectively serve on the Company’s Audit Committee. Each of our directors are in compliance with these Board and Board committee time commitment policies.
Shareholders may also suggest individuals to be considered by the Board as potential nominees for election to the Board. A shareholder may submit an individual for consideration by the Board of Directors in connection with the 2026 Annual Meeting of Shareholders by providing certain information as set forth in the By-Laws, in writing, to the Corporate Secretary of the Company at 358 South Main Street, Burlington, North Carolina 27215. These suggestions for the 2026 Annual Meeting must be received no earlier than the 120th day prior to the anniversary date of the 2025 Annual Meeting (i.e., January 15, 2026) and no later than the 60th day prior to the anniversary date of the 2025 Annual Meeting (i.e., March 16, 2026). Nominees that comply with the foregoing procedures will receive the same consideration as other candidates identified by or to our Nominating and Corporate Governance Committee.
Under the Company’s proxy access by-law, eligible shareholders also may submit their own nominations to the Board to be included in the Company’s Proxy Statement for the 2026 Annual Meeting of Shareholders. The By-Laws permit a shareholder, or a group of up to 20 shareholders, owning three percent or more of the Company’s outstanding Common Stock continuously for at least three years, to nominate and have included in the Company’s proxy materials persons for election to the Board constituting up to 20% of the Board, provided that the shareholder(s) and the nominee(s) satisfy certain requirements specified in the By-Laws. For a shareholder nominee to be included in the Company’s Proxy Statement for the 2026 Annual Meeting of Shareholders under the proxy access by-law, the information required by the By-Laws must be received by the Corporate Secretary of the Company at the address provided above no earlier than the close of business on the 150th day prior to the anniversary date of the distribution of this Proxy Statement (i.e., November 5, 2025) and no later than the close of business on the 120th day prior to the anniversary date of the distribution of this Proxy Statement (i.e., December 5, 2025).
The By-Laws may be obtained free of charge by writing to the Company’s Corporate Secretary and are included as Exhibit 3.2 to the 2024 Annual Report.
24 LABCORP HOLDINGS INC.
CORPORATE GOVERNANCE
Evaluation of Director Candidates

|

|

|

|

|

|

|

|

|

|
|||||||||||||||||||||||||||||||||
| QUALIFICATIONS AND EXPERIENCE |
||||||||||||||||||||||||||||||||||||||||||
|
|
Business Strategy Experience |
● |
|
● |
|
● |
|
● |
|
● |
|
● |
|
● |
|
● |
|
● |
| |||||||||||||||||||||||
|
|
Corporate Finance and M&A |
● |
|
● |
|
● |
|
● |
|
● |
|
● |
|
● |
|
● |
|
● |
|
● |
| |||||||||||||||||||||
|
|
Corporate Governance Experience |
● |
|
● |
|
● |
|
● |
|
● |
|
● |
|
● |
|
● |
|
● |
|
● |
| |||||||||||||||||||||
|
|
Executive Leadership Experience |
● |
|
● |
|
● |
|
● |
|
● |
|
● |
|
● |
|
● |
|
● |
|
● |
| |||||||||||||||||||||
|
|
Healthcare/Clinical Research Background |
● |
|
● |
|
● |
|
● |
|
● |
|
● |
| |||||||||||||||||||||||||||||
|
|
International Experience |
● |
|
● |
|
● |
|
● |
|
● |
|
● |
|
● |
|
● |
| |||||||||||||||||||||||||
|
|
Risk Management Experience |
● |
|
● |
|
● |
|
● |
|
● |
|
● |
|
● |
|
● |
|
● |
|
● |
| |||||||||||||||||||||
|
|
Sales and Marketing Background |
● |
|
● |
|
● |
|
● |
|
● |
|
|||||||||||||||||||||||||||||||
|
|
Talent Management Expertise |
● |
|
● |
|
● |
|
● |
|
● |
|
● |
|
● |
|
● |
|
● |
|
● |
| |||||||||||||||||||||
|
|
Technology/Cybersecurity Experience |
● |
|
● |
|
● |
|
● |
|
● |
|
● |
| |||||||||||||||||||||||||||||
When evaluating prospective candidates for director, including those nominated by shareholders, the Nominating and Corporate Governance Committee conducts individual evaluations of the candidates, taking into account the criteria enumerated in the Company’s Corporate Governance Guidelines (see description below). Among other things, the Committee considers whether prospective candidates have:
| • | personal and professional integrity; |
| • | skills and experience to advise the Company regarding its medical, scientific, operational, strategic, and governance goals; |
| • | interest, capacity, and willingness to serve the long- term interests of the Company’s shareholders; |
| • | ability and willingness to devote the required amount of time to the Company’s affairs, including attendance at Board and Committee meetings; |
| • | exceptional ability and judgment; and |
| • | freedom from personal and professional relationships that would adversely affect the ability to serve the best interests of the Company and its shareholders. |
The Company’s Corporate Governance Guidelines provide that the Nominating and Corporate Governance Committee is responsible for reviewing with the Board the appropriate skills and characteristics required of Board members in the context of the Company’s business needs and the current composition of the Board. This assessment includes, among other characteristics, background, skills, and expertise in the context of the perceived needs of the Board at the time of such assessment. The Company believes that Board membership should reflect diversity in its broadest sense, including persons diverse in demographics, skills, experience, and geography, and actively considers these factors in its analysis of potential nominees. The Board seeks independent directors who represent a mix of backgrounds and experiences that will enhance the quality of the Board’s deliberations and decisions, including experience with publicly traded national, international, or multinational companies, executive or financial management experience, and/or achievement with distinction in their chosen fields. The Board believes that its composition reflects a balance of skills, experiences, diversity, and expertise that provides strong and broad oversight, practical experience, and strategic vision to the Company.
2025 PROXY STATEMENT 25
CORPORATE GOVERNANCE
Director candidates, other than sitting directors, may be interviewed by the Chair of the Nominating and Corporate Governance Committee, other directors, the CEO, the Chief Human Resources Officer, and the Corporate Secretary. The results of these interviews, as well as any other materials received by the Nominating and Corporate Governance Committee that it deems relevant, are considered by the Nominating and Corporate Governance Committee in making its recommendation to the Board.
Communications with the Board
Shareholders and interested parties may communicate with the Board, individually or as a group, by submitting written communications to the appropriately addressed Board member(s), c/o Corporate Secretary, Labcorp Holdings Inc., 358 South Main Street, Burlington, North Carolina 27215.
All communications with the Board will be reviewed initially by the Corporate Secretary, who will relay all communications to the appropriate director or directors unless the communication is:
| • | an advertisement or other commercial solicitation or communication; |
| • | obviously frivolous or obscene; |
| • | unduly hostile, threatening, or illegal; or |
| • | related to trivial matters (in which case it will be delivered to the intended recipient for review at the next regularly scheduled Board meeting). |
Directors may decide whether any of the communications addressed to their attention should be presented to the full Board, to one or more of its committees, or to the Company’s management. Each director also has the discretion to determine whether a response to the person sending the communication is appropriate. Any response will be made through the Company’s Corporate Secretary in accordance with the Company’s policies and procedures and applicable law, and regulations relating to the disclosure of information.
The Nominating and Corporate Governance Committee, comprised entirely of independent, non-employee directors, has reviewed and approved the foregoing procedures and is responsible for recommending changes to the procedures as necessary.
26 LABCORP HOLDINGS INC.
CORPORATE GOVERNANCE
Board Committees and Their Functions
| The Board has four standing committees that are each composed entirely of independent directors. The Nominating and Corporate Governance Committee reviews committee and committee Chair assignments annually and recommends committee rosters to the full Board after considering factors such as the directors’ business and corporate governance experience, their preferences, criteria for specific committee service, and the directors’ other responsibilities and scheduling flexibility. While there is no specific requirement for committee refreshment, the Nominating and Corporate Governance Committee will recommend changes that are intended to ensure that the membership of each committee reflects the appropriate mix of tenure, experience, and fresh perspectives. Committee membership shown below is as of March 20, 2025. |
25
Board and Committee meetings held in 2024
|
| Name |
Audit Committee | Compensation and Human Capital Committee |
Nominating and Corporate Governance Committee |
Quality and Compliance Committee | ||||||||||||
|
|
KERRII B. ANDERSON |

|

|
|||||||||||||
|
|
JEFFREY A. DAVIS |

Chair |

| |||||||||||||
|
|
D. GARY GILLILAND, M.D., |

|

| |||||||||||||
|
|
KIRSTEN M. KLIPHOUSE |

|
||||||||||||||
|
|
GARHENG KONG, M.D., PH.D. Lead Independent Director |

|
Chair | |||||||||||||
|
|
PETER M. NEUPERT |

|
||||||||||||||
|
|
RICHELLE P. PARHAM |
Chair |

|
|||||||||||||
|
|
PAUL B. ROTHMAN, M.D. |

|
Chair | |||||||||||||
|
|
ADAM H. SCHECHTER Chair |
|||||||||||||||
|
|
KATHRYN E. WENGEL |

|

| |||||||||||||
 Member
Member
 Financial Expert
Financial Expert
Charters for each of the committees are available under the Corporate Governance tab of the Investors page of our website at www.ir.labcorp.com. Each committee reviews its respective charter on an annual basis.
2025 PROXY STATEMENT 27
CORPORATE GOVERNANCE
|
|
Audit Committee
|
8 MEETINGS HELD IN 2024
|
|
Members
Mr. Davis (Committee Chair, Financial Expert)
Ms. Anderson (Financial Expert)
Dr. Gilliland
Ms. Kliphouse |
The Audit Committee is responsible for assisting the Board with the following functions:
• the selection, appointment, compensation, and oversight of the work of any independent registered public accounting firm employed by the Company;
• reviewing the qualifications and independence of the Company’s independent registered public accounting firm;
• assisting the Board with oversight of the integrity of the financial statements of the Company;
• ensuring that the Company complies with legal and regulatory requirements as they impact the Company’s financial statements or reporting systems;
• overseeing the Company’s internal audit functions and internal controls, including approving a risk-based internal audit plan and approving the Internal Audit Charter on an annual basis;
• reviewing the system and controls over reporting that the Company has in place to ensure the accuracy of its key disclosures related to environmental, social, and governance matters;
• overseeing the Company’s management of financial risks, including with respect to risk assessment and risk management;
• reviewing all related party transactions in accordance with the Company’s Related Party Transactions Policy;
• producing an Audit Committee report as required by the SEC to be included in the Company’s annual Proxy Statement; and
• regularly overseeing and reviewing the Company’s cybersecurity and other information technology risks, controls and procedures, including the potential impacts of such risks on the Company’s business, financial results, operations, and reputation, and the Company’s plans to mitigate cybersecurity risks and to respond to data breaches, and regularly receiving reports from, and meeting with, the Chief Information Risk Officer and Chief Information and Technology Officer to review cybersecurity issues.
The Audit Committee meets regularly and in executive sessions with the Company’s independent auditor, management, and the Company’s internal auditors. In its meetings with the independent auditor and the internal auditors, the Audit Committee discusses, among other things, the overall scope and plans for their respective audits, the results of their examinations, critical audit matters, and their evaluations of the Company’s internal controls.
The Audit Committee constitutes a separately designated standing audit committee established in accordance with Section 3(a)(58)(A) of the Securities Exchange Act of 1934, as amended (the “Exchange Act”). The Board has determined that Ms. Anderson and Mr. Davis are each an “audit committee financial expert” as defined in the SEC’s rules. The Board has also determined that Ms. Anderson and Mr. Davis each have the “accounting or related financial management expertise” required by the Listing Standards.
|
28 LABCORP HOLDINGS INC.
CORPORATE GOVERNANCE
|
|
Compensation and Human Capital Committee
|
4 MEETINGS HELD IN 2024
|
|
Members
Ms. Parham (Committee Chair)
Dr. Kong
Dr. Rothman
Ms. Wengel
|
The CHC Committee is responsible for assisting the Board with the following functions:
• reviewing the Company’s compensation and benefit policies, procedures and objectives, including any perquisites paid to the CEO and other executive officers and directors;
• reviewing, approving, and making recommendations to the independent directors of the Board regarding the CEO’s compensation, taking into account the corporate goals and objectives relevant to CEO compensation and evaluating the CEO’s performance in light of those goals and objectives, and reviewing and approving the compensation arrangements for other executive officers;
• reviewing and evaluating the compensation of the Company’s non-employee directors;
• reviewing the CEO’s annual report on management development and periodic updates on the short-term succession plan and assisting the Board in overseeing management succession plans;
• monitoring the evolving executive compensation landscape and considering shareholder feedback;
• reviewing and overseeing the Company’s incentive compensation and equity plans;
• evaluating the Company’s pay practices in relation to the Company’s risk profile and compensation philosophy;
• approving and periodically assessing the effectiveness of any policies or plans related to the recoupment of incentive compensation, or “clawback” policies;
• overseeing policies, objectives, disclosures, and risks related to the Company’s culture and human capital management;
• producing a CHC Committee report as required by the SEC to be included in the Company’s annual Proxy Statement; and
• assisting the Board in overseeing development and corporate succession plans for the corporate senior leadership team.
|
2025 PROXY STATEMENT 29
CORPORATE GOVERNANCE
|
|
Nominating and Corporate Governance Committee
|
4 MEETINGS HELD IN 2024
|
|
Members
Dr. Kong (Committee Chair)
Ms. Anderson
Mr. Neupert
Ms. Parham
|
The Nominating and Corporate Governance Committee is responsible for assisting the Board with the following functions:
• identifying individuals qualified to become Board members, consistent with criteria approved by the Board and succession planning;
• evaluating and analyzing annually the independence and commitments of each member of the Board, including each director’s prior service to the Board, job responsibilities, service on other public company boards, and leadership positions on any such boards, prior to recommending a director or nominee for election to the Board;
• recommending to the Board the director nominees for the annual meeting of shareholders and the director nominees for each Board Committee;
• reviewing the Board’s committee assignments and considering the rotation of Chair and members; • reviewing and discussing with the Board the Company’s engagement with, and responsiveness to, shareholder votes on governance matters;
• reviewing and evaluating any actual or potential conflicts of interest relating to any director that may affect a director’s continued service on the Board;
• reviewing and reassessing, on an annual basis, the adequacy of the corporate governance principles of the Company and recommending any proposed changes to the Board for approval;
• evaluating each director’s prior service on and contributions to the Board and considering other commitments of Board members and candidates annually or as necessary;
• Oversight of the Company’s Lobbying and Political Contributions Policy and oversight of the Company’s lobbying expenditures and activities and political contributions, on which the Committee will receive updates, by the Company’s Chief Legal Officer and Senior Vice President of Global Government Relations & Public Policy; and
• leading the Board in its annual self-assessment.
|
30 LABCORP HOLDINGS INC.
CORPORATE GOVERNANCE
|
|
Quality and Compliance Committee
|
4 MEETINGS HELD IN 2024
|
|
Members
Dr. Rothman (Committee Chair)
Mr. Davis
Dr. Gilliland
Ms. Wengel
|
The Quality and Compliance Committee is responsible for assisting the Board in carrying out its oversight responsibility with respect to quality and compliance issues. This oversight responsibility includes ensuring that management adopts and implements policies and procedures that require the Company’s employees to act in accordance with high ethical standards, deliver high quality services, and comply with healthcare and other legal requirements. The Quality and Compliance Committee is responsible for reviewing the Company’s processes intended to assure excellent performance and meet scientific, medical, and regulatory quality performance benchmarks.
In furtherance of the foregoing, the Quality and Compliance Committee annually reviews the Company’s programs and practices related to scientific, medical, and regulatory quality and compliance, including a periodic reassessment of the adequacy of:
• quality and compliance policy development;
• quality and compliance reporting/tracking systems;
• investigation and remediation practices for quality and compliance issues; quality and compliance reporting/tracking systems;
• meeting scientific, medical, and regulatory quality performance benchmarks;
• education and training of Company personnel on quality and compliance;
• quality and compliance function responsibilities, staffing and budget; and
• the Company’s programs for management of ESG activities and objectives and disclosures relating to environmental, sustainability, employee health and safety, and compliance and quality matters.
Additionally, the Quality and Compliance Committee meets regularly, but no less than annually, with each of the Company’s Chief Compliance Officer and Chief Medical Officer and, as necessary, heads of the Company’s corporate compliance and quality functions, regarding the implementation and effectiveness of the Company’s scientific, medical, and regulatory compliance program, and receives and reviews periodic reports regarding, among other things:
• compliance-related activities and on-going compliance training programs;
• the quality assurance activities conducted by the quality functions;
• compliance audit plans and results;
• the results of internal quality audits;
• the status and results of audits, inspections, investigations, and enforcement actions by regulatory authorities;
• any significant deviations observed by the Company’s quality functions; and
• the status of any corrective and preventative action plans initiated by those functions.
|
Board and Committee Meetings
During 2024, the Board held five meetings and the Board’s standing committees held a total of 20 meetings. Each of the directors attended 100% of the Board meetings and no less than 88% of the total meetings of the Board and the Committees of which such director was a member.
In his capacity as the Lead Independent Director, Dr. Kong chaired five meetings of the independent and non-employee directors on the same days as regularly scheduled Board meetings. Members of the Board are encouraged to attend our annual meetings, and all of the current directors who were then serving attended the 2024 Annual Meeting of Shareholders.
2025 PROXY STATEMENT 31
CORPORATE GOVERNANCE
Corporate Governance Policies and Procedures
Corporate Governance Guidelines
The Board has adopted a set of Corporate Governance Guidelines that address a number of topics, including composition of the Board, director independence, director commitments, including limits on their ability to serve on other boards, annual self-assessment by the Board and its Committees, retirement of directors, and succession planning. The Nominating and Corporate Governance Committee reviews the Corporate Governance Guidelines on a regular basis and any proposed additions or amendments are submitted to the full Board for its consideration. Shareholders may request a printed copy of the Corporate Governance Guidelines from the Corporate Secretary or access a copy under the Corporate Governance tab of the Investors page of Labcorp’s website at www.Labcorp.com.
Code of Conduct and Ethics
The Board has also adopted a Code of Conduct and Ethics (the “Code”) that is applicable to all directors, officers, and employees, agents, representatives, consultants, vendors, and contractors of the Company. The Code sets forth Company policies and expectations on a number of topics, including but not limited to, conflicts of interest, confidentiality, compliance with laws (including insider trading laws), preservation and use of Company assets, and business ethics. The Code also sets forth procedures for reporting and handling any potential violation of the Code, conflicts of interest, and the appearance of any conflict of interest. The Code is regularly reviewed by management, the Audit Committee, and the Quality and Compliance Committee, and proposed additions or amendments are considered by the Board. Shareholders may request a printed copy of the Code of Conduct and Ethics from the Corporate Secretary or access a copy under the Corporate Governance tab of the Investors page on Labcorp’s website at www.Labcorp.com. In addition, any waivers for directors, officers, and employees of the Company or amendments to the Code will also be posted on Labcorp’s website.
Related Party Transactions
The Board has adopted a Related Party Transaction Policy pursuant to which, and in accordance with its charter, the Board’s Audit Committee, or the full Board, is responsible for reviewing and approving the terms and conditions of related party transactions. The Company’s directors and key employees, including all members of senior management, complete annual reports disclosing, or certifying the absence of, any related party transactions. The Audit Committee reviews all potential transactions involving related persons (as such transactions are defined by Item 404(a) of Regulation S-K as promulgated by the SEC) before allowing the Company to enter into any such transaction. Based on the Company’s review of its transactions, there have been no transactions or proposed transactions considered to be related party transactions since January 1, 2024.
32 LABCORP HOLDINGS INC.
DIRECTOR COMPENSATION
Director Compensation
The Company’s non-employee director compensation is designed to attract and retain highly qualified, independent directors to represent shareholders on the Board and act in their best interest. The CHC Committee, which consists solely of independent directors, has primary responsibility for setting our non-employee director compensation. FW Cook, the Committee’s independent compensation consultant, assists the CHC Committee in evaluating our non-employee director compensation program.
Elements of Non-Employee Director Compensation
Labcorp’s non-employee director compensation is designed to align with emerging best practices and reflect the Board’s belief that non-employee director compensation should not depend upon the number of meetings held, but rather on the ongoing work and role of the directors throughout the year. The 2024 elements of our non-employee director compensation included the following:
| • | Annual Retainer. An annual retainer of $120,000 was paid to each non-employee director in quarterly installments. |
| • | Committee Chair Annual Retainer. The Chair of each standing committee of the Board received an additional retainer, paid on a quarterly basis. The retainer for the Chair of the Audit Committee is $25,000 and the retainer for the Chairs of the CHC Committee, the Nominating and Corporate Governance Committee, and the Quality and Compliance Committee each are $20,000. |
| • | Lead Independent Director Annual Retainer. The additional retainer for the Lead Independent Director is $45,000, paid on a quarterly basis. |
| • | Equity Compensation. Each non-employee director who was then serving on the Board received a grant of restricted stock units having a value of approximately $210,000, with the exception of Mr. Bélingard and Dr. Williams, who each received a grant of restricted stock units having a value of approximately |
| $52,500, on February 6, 2024, subject to the requirements of the Company’s Director Stock Ownership Program (as further described below). The number of restricted stock units granted was determined by using the closing price of the Company’s Common Stock on the grant date ($222.28). The restricted stock units vested fully on February 6, 2025, except for restricted stock units granted to Mr. Bélingard and Dr. Williams, which vested fully on May 14, 2024, the date of each of their retirements from the Board. |
| • | Reimbursement of Expenses. Each director is reimbursed for such director’s reasonable out-of-pocket expenses incurred in connection with travel to and from, and attendance at, meetings of the Board or its Committees, as well as for related activities such as director education courses and materials consistent with our policies concerning reimbursement for travel, entertainment, and other expenses. |
Effective January 1, 2025, the annual grant of restricted stock units to each non-employee director was increased in value to approximately $220,000, subject to the requirements of the Company’s Director Stock Ownership Program. Following a study of non-employee director compensation relative to the Company’s peer group and broader industry practice, FW Cook recommended the increase in order to remain competitive with anticipated market movement.
2025 PROXY STATEMENT 33
DIRECTOR COMPENSATION
Director Stock Ownership Program
Maintaining a significant personal level of stock ownership ensures that each director is financially aligned with the interests of our shareholders. The Board believes that by holding an equity position in the Company, directors demonstrate their alignment with the long-term strategy and initiatives of the Company. Each non-employee director is required to acquire and maintain shares having a value equal to five times that of the annual cash retainer.
For purposes of determining whether the stock ownership requirement is satisfied, a calculation is performed for each director annually as of the business day closest to June 30 of each year (the “Measurement Date”), utilizing the average closing price of the Company’s Common Stock for the 90-day period ending on the Measurement Date. For new participants, the stock ownership requirement is initially determined as of the date that the director becomes a participant, utilizing the average closing price of the Company stock for the 90-day period ending on that date.
Until the required level of ownership is met, a director is required to hold 50% of any shares of Common Stock acquired upon the lapse of restrictions on any stock grant. If a director fails to meet or show progress towards satisfying these requirements, the CHC Committee may reduce future equity grants to that director. Once satisfied, each director is required to maintain the required level of stock ownership for such director’s entire tenure of service on the Board. Each member of our Board is currently in compliance with the director stock ownership program, either through satisfying the required level of ownership, or by satisfying the holding requirement.
Summary of 2024 Director Compensation
The compensation paid by the Company to the directors for 2024, other than Mr. Schechter, is set forth in the table below. Information on compensation for Mr. Schechter is set forth in the “Executive Compensation” section below (page 70).
| Name |
Fees Earned or Paid in Cash ($)(1) |
Restricted Stock Unit Awards ($)(2) |
All Other Compensation ($)(3) |
Total ($) | ||||||||||||||||
| KERRII B. ANDERSON |
$ | 120,000 | $ | 209,832 | $ | 168 | $ | 330,000 | ||||||||||||
| JEAN-LUC BÉLINGARD |
$ | 44,505 | $ | 52,458 | $ | 196 | $ | 97,159 | ||||||||||||
| JEFFREY A. DAVIS |
$ | 145,000 | $ | 209,832 | $ | 168 | $ | 355,000 | ||||||||||||
| D. GARY GILLILAND, M.D., Ph.D. |
$ | 120,000 | $ | 209,832 | $ | 168 | $ | 330,000 | ||||||||||||
| KIRSTEN M. KLIPHOUSE |
$ | 120,000 | $ | 209,832 | $ | 168 | $ | 330,000 | ||||||||||||
| GARHENG KONG, M.D., Ph.D. |
$ | 185,000 | $ | 209,832 | $ | 168 | $ | 395,000 | ||||||||||||
| PETER M. NEUPERT |
$ | 120,000 | $ | 209,832 | $ | 168 | $ | 330,000 | ||||||||||||
| RICHELLE P. PARHAM |
$ | 140,000 | $ | 209,832 | $ | 168 | $ | 350,000 | ||||||||||||
| PAUL B. ROTHMAN, M.D. |
$ | 131,429 | $ | 209,832 | $ | 168 | $ | 341,429 | ||||||||||||
| KATHRYN E. WENGEL |
$ | 120,000 | $ | 209,832 | $ | 168 | $ | 330,000 | ||||||||||||
| R. SANDERS WILLIAMS, M.D. |
$ | 51,923 | $ | 52,458 | $ | 42 | $ | 104,423 | ||||||||||||
| (1) | Includes annual retainer payments of $120,000 for each director, with the exception of Mr. Bélingard and Dr. Williams, each of whom received prorated annual retainer payments of $44,505 due to their retirement from the Board on May 14, 2024. Also includes committee Chair annual retainer payments of $25,000 to Mr. Davis, $20,000 to Dr. Kong and Ms. Parham, and prorated payments of $11,429 to Dr. Rothman and $7,418 to Dr. Williams. Dr. Kong received a retainer payment of $45,000 for serving as Lead Independent Director during 2024. |
| (2) | Amounts represent the aggregate grant date fair value computed in accordance with Financial Accounting Standards Board Accounting Standards Codification Topic 718 (“FASB ASC Topic 718”) for restricted stock units awarded to each director in 2024. For a discussion of the assumptions made in these valuations, see Notes 1 and 14 to the Company’s audited financial statements included within its 2024 Annual Report. The aggregate number of restricted stock units held by each director as of December 31, 2024, was 944 with the exception of Mr. Bélingard and Dr. Williams, who each held no restricted stock units as of December 31, 2024 due to the accelerated vesting of previously held restricted stock units in connection with each of their retirements from the Board on May 14, 2024. The aggregate grant date fair value excludes cash paid in lieu of fractional shares, which is reflected in the “All Other Compensation” column. |
| (3) | Includes cash paid in lieu of fractional shares in connection with the issuance of restricted stock unit awards or the satisfaction of tax obligations related thereto. |
34 LABCORP HOLDINGS INC.
|
|
||||
ELECTION OF DIRECTORS
|
PROPOSAL ONE
|
The Board unanimously recommends that shareholders vote “FOR” the election of the following nominees. | |||
| Election of
| ||||
The full Board, upon recommendation of the Nominating and Corporate Governance Committee, has nominated each of Kerrii B. Anderson, Jeffrey A. Davis, D. Gary Gilliland, Kirsten M. Kliphouse, Garheng Kong, Peter M. Neupert, Richelle P. Parham, Paul B. Rothman, Adam H. Schechter, and Kathryn E. Wengel for election at the 2025 Annual Meeting to hold office until the next annual meeting of shareholders or until such director’s death, resignation, or removal. All nominees have consented to serve, and the Board does not know of any reason why any nominee would be unable to serve. No director nominee is related to any of our other director nominees or executive officers, and there are no arrangements or understandings between a director and any other person pursuant to which such person was selected as a director nominee. If a nominee becomes unavailable or unable to serve before the 2025 Annual Meeting, the Board can either reduce its size or designate a substitute nominee. If the Board designates a substitute, your proxy will be voted for the substitute nominee.
Information about each nominee is included below, including details about the nominee’s qualifications, skills, and experiences that supported the determination by the Nominating and Corporate Governance Committee and the Board that the person should serve as a director of Labcorp.
The Board unanimously recommends that shareholders vote “FOR” the election of each of our ten nominees for director.
2025 PROXY STATEMENT 35
ELECTION OF DIRECTORS
Nominees to the Board of Directors

| Adam H. Schechter
Chairman, President and Chief Executive Officer
Age: 60 Director Since: April 2013 |
| Professional Highlights: Adam H. Schechter has served as a director of the Company since April 2013, President and Chief Executive Officer of the Company since November 2019, and Chairman of the Board since May 2020. Prior to that, Mr. Schechter was President of Global Human Health and an Executive Vice President of Merck & Co., Inc., a pharmaceutical company, from 2010 to 2018, where he was a member of Merck’s executive committee. He served as special advisor to the CEO of Merck from January 2019 to July 2019. Prior to becoming President, Global Human Health, Mr. Schechter served as President, Global Pharmaceutical Business from 2007 to 2010. Mr. Schechter holds a bachelor’s degree in biology from La Salle University and was awarded an honorary Doctor of Humane Letters degree from La Salle University in 2021.
Skills and Qualifications: • Global and U.S.-focused leadership roles, while at Merck, spanning sales, marketing, and managed markets, as well as business and product development
• Deep knowledge of the pharmaceutical and healthcare industries and extensive experience collaborating with many of the industries’ key stakeholders to achieve patient-focused outcomes
• CERT Certificate in Cybersecurity Oversight
Current Public Company Board Experience: • DaVita Inc.
Other Current Relevant Experience: • Vice Chair of the Board of Directors for the American Clinical Laboratory Association
• Water.org, Board Member
• Corporate Advisory Council for the National Alliance for Hispanic Health |
Skills
|
|||||||
|
Business Strategy |
Corporate Finance and M&A | |||||||
|
Corporate Governance |
Executive Leadership | |||||||
|
Healthcare/ Clinical Research |
International | |||||||
|
Risk Management |
Sales and Marketing | |||||||
|
Talent Management |
Technology/ Cybersecurity | |||||||
36 LABCORP HOLDINGS INC.
ELECTION OF DIRECTORS

| Kerrii B. Anderson
Independent Director
Age: 67 Director Since: May 2006 |
| Professional Highlights Kerrii B. Anderson has served as a director of the Company since May 2006. Ms. Anderson was Chief Executive Officer of Wendy’s International, Inc., a restaurant operating and franchising company, from April 2006 until September 2008, when the company merged with Triarc. Ms. Anderson served as Executive Vice President and Chief Financial Officer of Wendy’s International from 2000 to 2006. Prior to this position, she was Chief Financial Officer, Senior Vice President of M/I Schottenstein Homes, Inc. from 1987 to 2000. Ms. Anderson holds a Bachelor of Arts in Business Administration from Elon University and a Master of Business Administration from the Fuqua School of Business at Duke University and is a Certified Public Accountant.
Skills and Qualifications • Strong record of leadership in operations and strategy
• Audit committee financial expert with CEO and CFO experience
• Extensive public company board, governance, and audit committee experience
• Extensive financial, mergers and acquisitions, international, talent management, corporate governance, and executive compensation experience
• CERT Certificate in Cybersecurity Oversight
Committees: • Audit Committee (Financial Expert)
• Nominating and Corporate Governance Committee
Current Public Company Board Experience: • Worthington Enterprises, Inc.
• Abercrombie & Fitch Co.
• The Sherwin-Williams Company
Previous Public Company Board Experience: • Chiquita Brands International Inc., Chairwoman
• PF Chang’s China Bistro, Inc.
Other Current Relevant Experience: • The Columbus Foundation, Chairperson of the Audit Committee
• Elon University, Board of Trustees and Audit Committee |
Skills
|
|||||||
|
Business |
Corporate Finance and M&A | |||||||
|
Corporate Governance |
Executive | |||||||
|
International |
Risk | |||||||
|
Sales and |
Talent | |||||||
|
Technology/Cybersecurity |
||||||||
2025 PROXY STATEMENT 37
ELECTION OF DIRECTORS

| Jeffrey A. Davis
Independent Director
Age: 61 Director Since: December 2019 |
| Professional Highlights Jeffrey A. Davis has served as a director of the Company since December 2019 and Chairman of the Audit Committee since June 2023. Mr. Davis previously served as the Chief Financial Officer of Dollar Tree, Inc., a leading operator of discount variety stores, from October 2022 to March 2025. Prior to his time at Dollar Tree, Inc., Mr. Davis served as Chief Financial Officer of Qurate Retail Group, a leading retailer and media conglomerate comprised of eight retail brands including QVC, HSN, and Zulily from October 2018 through August 2022. Prior to Qurate Retail Group, Mr. Davis served as Chief Financial Officer of J. C. Penney Company Inc., a retail company, from July 2017 until September 2018. Prior to joining J. C. Penney, Mr. Davis served as Chief Financial Officer of Darden Restaurants, Inc., a restaurant operator, from July 2015 until March 2016 and Chief Financial Officer of the Walmart U.S. segment of Walmart Inc. from January 2014 to May 2015, and in various other positions of increasing responsibility at Walmart U.S. from 2006 to 2013. Mr. Davis’ experience also includes nine years in senior executive roles at Lakeland Tours LLC and McKesson Corporation. Mr. Davis is a certified public accountant and holds a Bachelor of Science in Accounting from the Pennsylvania State University and a Master of Business Administration from the Joseph M. Katz Graduate School of Business at the University of Pittsburgh.
Skills and Qualifications • Extensive executive leadership experience, including financial management and public company leadership experience as a CFO across multiple industries
• Extensive experience in operations, finance, capital structure, and mergers and acquisition
• Audit Committee financial expert
• Executive sponsor of diversity initiatives
Committees: • Audit Committee (Chair) (Financial Expert)
• Quality and Compliance Committee |
Skills
|
|||||||
|
Business Strategy |
Corporate Finance and M&A | |||||||
|
Corporate Governance |
Executive Leadership | |||||||
|
International |
Risk Management | |||||||
|
Sales and Marketing |
Talent Management | |||||||
38 LABCORP HOLDINGS INC.
ELECTION OF DIRECTORS

| D. Gary Gilliland, M.D., Ph.D.
Independent Director
Age: 70 Director Since: April 2014 |
| Professional Highlights D. Gary Gilliland has served as a director of the Company since April 2014. Dr. Gilliland has served as President and Director Emeritus of the Fred Hutchinson Cancer Center, a research organization, since January 2020. From January 2015 to January 2020, Dr. Gilliland previously served as President and Director of the Fred Hutchinson Cancer Center. Prior to that, he was the inaugural Vice Dean and Vice President for Precision Medicine at the University of Pennsylvania Perelman School of Medicine from October 2013 to January 2015, where he was responsible for synthesizing research and clinical-care initiatives across all medical disciplines including cancer, heart and vascular medicine, neurosciences, genetics, and pathology, to create a national model for the delivery of precise, personalized medicine. From 2009 until he joined Penn Medicine in 2013, Dr. Gilliland was Senior Vice President of Merck Research Laboratories and Oncology Franchise Head. At Merck, Dr. Gilliland oversaw first-in-human studies, proof-of-concept trials, and Phase II/III registration trials that included the development of pembrolizumab (anti-PD1) for treatment of cancer, and managed all preclinical and clinical oncology-licensing activities. Prior to joining Merck, Dr. Gilliland was a member of the faculty at Harvard Medical School for nearly 20 years, where he served as Professor of Medicine and a Professor of Stem Cell and Regenerative Biology. He was also an Investigator of the Howard Hughes Medical Institute from 1996 to 2009, Director of the Leukemia Program at the Dana-Farber/Harvard Cancer Center from 2002 to 2009, and Director of the Cancer Stem Cell Program of the Harvard Stem Cell Institute from 2004 to 2009. Dr. Gilliland has a Doctor of Philosophy in Microbiology from UCLA and a Doctor of Medicine from UCSF.
Skills and Qualifications • Board-certified in Internal Medicine and Fellowship training in Hematology and Oncology, each at Harvard Medical School
• Expertise in cancer genetics and experience working within medical communities ranging from academia to the pharmaceutical industry
• Executive experience in clinical research and healthcare finance and mergers and acquisitions
Committees: • Audit committee
• Quality and Compliance Committee
Current Public Company Board Experience: • Nuvalent, Inc.
Other Current Relevant Experience: • Fellow of the American Association for Cancer Research (AACR)
• Member of the American Society for Clinical Investigation (ASCI)
• Member of the Association of American Physicians (AAP)
• Member of the American Academy of Arts and Sciences (AAA&S)
• Member of the National Academy of Medicine (NAM) |
Skills
|
|||||||
|
Corporate Finance and M&A |
Corporate Governance | |||||||
|
Executive Leadership |
Healthcare/ Clinical Research | |||||||
|
Risk Management |
Talent Management | |||||||
2025 PROXY STATEMENT 39
ELECTION OF DIRECTORS

| Kirsten M. Kliphouse
Independent Director
Age: 58 Director Since: October 2022 |
| Professional Highlights Kirsten M. Kliphouse has served as a director of the Company since October 2022. Ms. Kliphouse previously served as the President of Google Cloud Americas, a position she held from March 2022 to July 2023, where she was responsible for leading and growing the sales, go-to-market, customer engagement, channel, and services organizations. At Google Cloud, she also served as the Global Chair of the Aspiring Leadership Academy and Women@Google Cloud. Prior to her position as President, Ms. Kliphouse served as President of the North American division of Google Cloud from June 2019 to March 2022. Prior to Google Cloud, Ms. Kliphouse was Senior Vice President at Red Hat, Inc., a subsidiary of International Business Machines Corporation, Chief Executive Officer of Yardarm Technologies, a hardware and software solutions company, and founder and Chief Executive Officer of Scaling Ventures, a technology investment and advisory firm. Prior to her position at Yardarm, Ms. Kliphouse spent more than 25 years at Microsoft, Inc., where she was part of the executive leadership team and held numerous executive positions in Enterprise Sales, Original Equipment Manufacturers (OEM), Partner and Channels, and as Corporate Vice President of Customer Support, Success and Professional Services, during which she led more than 10,000-employees globally. Ms. Kliphouse is a recipient of the Founders Award for her superior leadership and contributions to the business. Ms. Kliphouse holds a Bachelor of Science in Computer Information Sciences and Business from Muhlenberg College.
Skills and Qualifications • Global cybersecurity incident response and remediation
• Executive leadership experience including by delivering operational and financial results
Committees: • Audit committee
Current Public Company Board Experience: • Dun & Bradstreet Holdings, Inc.
• Global Payments, Inc. |
Skills
|
|||||||
|
Business Strategy |
Corporate Finance and M&A | |||||||
|
Corporate Governance |
Executive Leadership | |||||||
|
International |
Risk Management | |||||||
|
Sales and Marketing |
Talent Management | |||||||
|
Technology/ Cybersecurity |
||||||||
40 LABCORP HOLDINGS INC.
ELECTION OF DIRECTORS

| Garheng Kong, M.D., Ph.D.
Independent Director
Age: 49 Director Since: December 2013 |
| Professional Highlights Garheng Kong has served as a director of the Company since December 2013 and Lead Independent Director since June 2023. Dr. Kong also serves as the Chair of the Nominating and Corporate Governance Committee for the Company. Dr. Kong is the managing partner of HealthQuest Capital, a healthcare-focused investment firm, a role he has held since he founded HealthQuest Capital in 2012. He was previously a general partner at Sofinnova Capital, a position he held from 2010 to 2013. Before joining Sofinnova, Dr. Kong was a general partner from 2000 to 2010 at Intersouth Partners, a venture capital firm, where he was a founding investor or board member for various life science ventures, several of which were acquired by large pharmaceutical companies. Prior to his investing career, Dr. Kong was employed by GlaxoSmithKline, McKinsey & Company, and TherOx. Dr. Kong received undergraduate degrees in both Chemical Engineering and Biological Sciences from Stanford, and earned a Doctor of Medicine, and Doctor of Philosophy and Master of Business Administration from Duke University.
Skills and Qualifications • Knowledge and experience in both the healthcare and finance fields
• Executive leadership experience
• Life science-related venture capital experience
• Corporate governance expertise through service on public company boards
Committees: • Lead Independent Director
• Compensation and Human Capital Committee
• Nominating and Corporate Governance Committee (Chair)
Current Public Company Board Experience: • Lunit Inc. (KOSDAQ: 328130)
• Xeris Biopharma Holdings, Inc. (formerly Strongbridge Biopharma plc)
Previous Public Company Board Experience: • Venus Concept Inc.
• Histogenics Corporation
• Avedro, Inc.
• Melinta Therapeutics, Inc.
• Alimera Sciences, Inc.
Other Current Relevant Experiences: • Duke University School of Medicine Board of Visitors
• Be the Match, Board of Directors
• Dell Children’s Foundation, Board of Trustees
• Austin Healthcare Council |
Skills
|
|||||||
|
Business Strategy |
Corporate Finance and M&A | |||||||
|
Corporate Governance |
Executive Leadership | |||||||
|
Healthcare/ Clinical Research |
Risk Management | |||||||
|
Talent Management |
||||||||
2025 PROXY STATEMENT 41
ELECTION OF DIRECTORS

| Peter M. Neupert
Independent Director
Age: 69 Director Since: January 2013 |
| Professional Highlights Peter M. Neupert has served as a director of the Company since January 2013. Mr. Neupert was an Operating Partner at Health Evolution Partners, a health only, middle market private equity firm, from January 2012 until June 2015. Prior to that, Mr. Neupert served as Corporate Vice President of the Microsoft Health Solutions Group from its formation in 2005 to January 2012. In addition, Mr. Neupert was a member of the Institute of Medicine’s Roundtable on Value & Science-Driven Healthcare from 2007 to 2012, a workshop dedicated to transforming the way evidence on clinical effectiveness is generated and used to improve health and healthcare. Mr. Neupert also served on the U.S. President’s Information Technology Advisory Committee, co-chairing the Health Information Technology Subcommittee and helping to drive the “Revolutionizing Health Care Through Information Technology” report, published in June 2004. Mr. Neupert served as the founding President and Chief Executive Officer of drugstore.com from 1998 to 2001 and as Chairman of the board of directors through September 2004. Mr. Neupert holds a Master of Business Administration from the Tuck School of Business at Dartmouth College and a Bachelor of Arts in Philosophy from Colorado College.
Skills and Qualifications • Expertise in health information technology, shareholder value creation and leveraging business strategies with technology
• Audit committee financial expert
• Corporate governance and business strategy expertise
• Expertise and experience in cybersecurity matters
Committees: • Nominating and Corporate Governance Committee
Current Public Company Board Experience: • Adaptive Biotechnologies Corporation, Lead Independent Director
• Fortrea Holdings Inc.
Previous Public Company Board Experience: • Quality Systems, Inc. (now NextGen Healthcare, Inc.)
• aQuantive.com
• drugstore.com, Chairman |
Skills
|
|||||||
|
Business Strategy |
Corporate Finance and M&A | |||||||
|
Corporate Governance |
Executive Leadership | |||||||
|
Healthcare/ Clinical Research |
International | |||||||
|
Risk Management |
Talent Management | |||||||
|
Technology/ Cybersecurity |
||||||||
42 LABCORP HOLDINGS INC.
ELECTION OF DIRECTORS

| Richelle P. Parham
Independent Director
Age: 57 Director Since: February 2016 |
| Professional Highlights Richelle P. Parham has served as a director of the Company since February 2016 and Chair of the Compensation and Human Capital Committee since June 2023. Ms. Parham currently serves as the President of Global E-Commerce and Business Development for Universal Music Group, a music-based entertainment company, a position she has held since June 2021. Prior to Universal Music Group, Ms. Parham served as a Managing Director of WestRiver Group, which is a collaboration of leading investment firms that provides integrated capital solutions to the global innovation economy with investments focused on technology, life sciences, energy, and experiential sectors from October 2019 to May 2021. She is also currently a Strategic Advisor at Camden Partners, a private equity firm, where she previously served as a General Partner from October 2016 to October 2019. Prior to Camden Partners, Ms. Parham served as Vice President, Chief Marketing Officer of eBay from November 2010 to March 2015. Ms. Parham was responsible, globally, for eBay brand strategy and brand marketing, to reach over 108+ million active eBay users, Internet marketing and for customer relationship management. Prior to joining eBay, Ms. Parham served as head of Global Marketing Innovation and Initiatives and head of Global Marketing Services at Visa, Inc. from 2008 to 2010. Ms. Parham founded and serves as Executive Chairman of the Board of Directors for Shyn, an oral care product company since January 2018. Her experience also includes 13 years at Digitas, Inc., a leading marketing agency, where she held a variety of senior leadership roles, including senior vice president and general manager of the agency’s Chicago office. Ms. Parham holds Bachelor of Science degrees in Business Administration and Design Arts from Drexel University.
Skills and Qualifications • Extensive senior-level executive experience, including in corporate finance, and mergers and acquisitions
• More than 20 years of global strategy and marketing experience, as well as expertise in understanding consumers and the consumer decision journey
Committees: • Compensation and Human Capital Committee (Chair)
• Nominating and Corporate Governance Committee
Current Public Company Board Experience: • Best Buy Co., Inc.
Previous Public Company Board Experience: • Scripps Network Interactive Inc.
• e.l.f. Beauty, Inc.
Other Current Relevant Experience: • Drexel University, Board of Trustees |
Skills
|
|||||||
|
Business Strategy |
Corporate Finance and M&A | |||||||
|
Corporate Governance |
Executive Leadership | |||||||
|
International |
Risk Management | |||||||
|
Sales and Marketing |
Talent Management | |||||||
2025 PROXY STATEMENT 43
ELECTION OF DIRECTORS

| Paul B. Rothman, M.D.
Independent Director
Age: 66 Director Since: June 2023 |
| Professional Highlights Paul B. Rothman has served as a director of the Company and member of the Quality and Compliance Committee since June 2023. He has served as the Chair of the Quality and Compliance Committee since June 2024. Dr. Rothman, a rheumatologist and molecular immunologist, was previously the Dean of the Medical Faculty for Johns Hopkins University School of Medicine and CEO of Johns Hopkins Medicine, during which time he oversaw both the Johns Hopkins Health System and the School of Medicine. Prior to serving at Johns Hopkins, Dr. Rothman held various leadership positions at Columbia University and the University of Iowa. Dr. Rothman holds a Bachelor of Science in Biology from the Massachusetts Institute of Technology and a Doctor of Medicine from Yale University.
Skills and Qualifications • Extensive expertise in patient care, science, and medicine relevant to the clinical laboratory business
• Operational, management, and executive leadership experience
• Deep understanding of the complexity of the U.S. healthcare delivery system and policy development
Committees: • Compensation and Human Capital Committee
• Quality and Compliance Committee (Chair)
Current Public Company Board Experience: • Merck and Co.
Previous Public Company Board Experience: • Cancer Genetics, Inc.
Other Current Relevant Experience: • King Faisal Specialist Hospital and Research Center in Saudi Arabia, Board of Directors
• Member of the American Society for Clinical Investigation (ASCI)
• Member of the Association of American Physicians (AAP)
• Member of the American Academy of Arts and Sciences (AAA&S)
• Member of the National Academy of Medicine (NAM)
• Member of the American Association for the Advancement of Sciences (AAAS) |
Skills
|
|||||||
|
Business Strategy |
Corporate Finance and M&A | |||||||
|
Corporate Governance |
Executive Leadership | |||||||
|
Healthcare/ Clinical Research |
International | |||||||
|
Risk Management |
Talent Management | |||||||
|
Technology/ Cybersecurity
|
44 LABCORP HOLDINGS INC.
ELECTION OF DIRECTORS

| Kathryn E. Wengel
Independent Director
Age: 59 Director Since: March 2021 |
| Professional Highlights Kathryn E. Wengel has served as a director of the Company since March 2021. Ms. Wengel currently serves as Executive Vice President, Chief Technical Operations and Risk Officer, and a member of the Executive Committee of Johnson & Johnson. Since joining Johnson & Johnson in 1988, Ms. Wengel has served in various positions of increasing responsibility across the enterprise, both in the United States and various locations globally, including Executive Vice President and Chief Global Supply Chain Officer from 2018 to January 2023, Worldwide Vice President, Chief Global Supply Chain Officer from March 2014 to July 2018, and Chief Quality Officer from April 2010 to March 2014. Ms. Wengel holds a Bachelor of Science in Civil Engineering and operations research from Princeton University.
Skills and Qualifications • Extensive global experience in managing complex supply chains, operations, and quality and compliance
• Knowledge and experience in the healthcare field
• Executive leadership experience
• Long-term experience with corporate sustainability matters
• Advocate and sponsor of several key diversity initiatives
Committees: • Compensation and Human Capital Committee
• Quality and Compliance Committee
Other Current Relevant Experiences: • GS1 Global, Management Board member
• National Association of Manufacturers, Chair of the Board of Directors
• Advancing Women’s Excellence in Supply Chain Operations Management and Education, Board of Advisors |
Skills
|
|||||||
|
Business Strategy |
Corporate Finance and M&A | |||||||
|
Corporate Governance |
Executive Leadership | |||||||
|
Healthcare/ Clinical Research |
International | |||||||
|
Risk Management |
Talent Management | |||||||
|
Technology/ Cybersecurity |
||||||||
2025 PROXY STATEMENT 45
EXECUTIVE OFFICERS
Executive Officers
Information regarding each of Labcorp’s current executive officers and their relevant business experience is summarized below.
Adam H. Schechter
President and Chief Executive Officer
See “Proposal One - Election of Directors” (page 35) for information about Mr. Schechter.
Megan D. Bailey
Executive Vice President and President, Central Laboratories and International
Megan D. Bailey (45) has served as Executive Vice President and President, Central Laboratories and International since September 2024. From May 2023 to August 2024, Ms. Bailey served as Executive Vice President and Chief Strategy and Transformation Officer. Prior to that, Ms. Bailey served as Chief of Staff to the Chief Executive Officer and an Executive Committee member since July 2022. Ms. Bailey served as Chief Executive Officer and a member of the Board of Directors of Personal Genome Diagnostics (PGDx), a cancer genomics company, prior to its acquisition by Labcorp, from April 2020 to July 2022, as well as Chief Commercial Officer, from January 2020 to April 2020, and Vice President, Marketing, from March 2018 to January 2020. Ms. Bailey has more than 20 years of leadership experience in the healthcare industry, including more than 10 years at Roche Diagnostics, most recently serving as Senior Director of Commercial Operations, where she was responsible for leading commercial organizations across four divisions that spanned clinical chemistry, molecular diagnostics, tissue diagnostics, and point of care portfolios addressing multiple market segments. Ms. Bailey serves as a member of the Novo Holdings Advisory Group, on the University of Maryland Baltimore Foundation Board of Trustees, and on the Army West Point Athletic Association Board of Directors. Ms. Bailey is a graduate of the United States Military Academy at West Point and holds a Master of Public Health from the University of North Carolina at Chapel Hill.
Lance V. Berberian
Executive Vice President, Special Advisor, Strategy
Lance V. Berberian (62) has served as Executive Vice President, Special Advisor, Strategy since November 2024. From February 2020 to October 2024, Mr. Berberian served as Executive Vice President and Chief Information and Technology Officer. Prior to that he served as Senior Vice President and Chief Information Officer from February 2014. Prior to joining Labcorp, he served as the Chief Information Officer at IDEXX Laboratories, Inc., a global leader in diagnostics and IT solutions for animal health and food and water quality, from 2007 to 2014. Mr. Berberian also served as Chief Information Officer and President of Kellstrom Defense Aerospace Inc., a fully integrated supply chain firm, from 2000 to 2007. Prior to that, he was the Chief Information Officer of Interim HealthCare Inc. from 1997 to 2000. Mr. Berberian serves as a Strategic Advisory Board member for North Carolina State University’s Department of Computer Science, on the Advisory Board of the Master of Science in Informatics and Analytics program for University of NC Greensboro, on the University of Chapel Hill’s Carolina Health Informatics Program Health IT Advisory Board, and on the Board of Trustees at Elon University. Mr. Berberian holds Bachelors of Science in Business Administration and Information Technology from Thomas Edison State College.
Brian J. Caveney, M.D., J.D.
Executive Vice President and President, Early Development Research Laboratories and Chief Medical and Scientific Officer
Brian J. Caveney (51) has served as Executive Vice President and President Early Development Research Laboratories and Chief Medical and Scientific Officer since May 2023, having previously served as Executive Vice President and President, Diagnostics and Chief Medical Officer since November 2019. Prior to that he served as Senior Vice President and Chief Medical Officer, beginning in September 2017. From 2011 until joining the Company, Dr. Caveney worked at Blue Cross and Blue Shield of North Carolina (Blue Cross NC), a health care insurance
46 LABCORP HOLDINGS INC.
EXECUTIVE OFFICERS
provider, where he served as Blue Cross NC’s Chief Medical Officer. In addition to various roles in the Healthcare Division of the core health plan, Dr. Caveney also served as Chief Clinical Officer of Mosaic Health Solutions, a wholly owned subsidiary of Blue Cross NC for strategic investments in diversified health solutions businesses. Prior to joining Blue Cross NC, Dr. Caveney was a practicing physician and assistant professor at Duke University Medical Center and also provided consulting services for several companies in the Research Triangle Park, North Carolina region. Dr. Caveney holds an M.D. from the West Virginia University School of Medicine, a J.D. from the West Virginia University College of Law, and a Master of Public Health in Health Policy and Administration from the University of North Carolina at Chapel Hill. He completed his residency at Duke University Medical Center and is board-certified in preventive medicine, with a specialty in occupational and environmental medicine.
Glenn A. Eisenberg
Executive Vice President
Glenn A. Eisenberg (63) has served as Executive Vice President since December 2024, having previously served as Executive Vice President and Chief Financial Officer since June 2014. From 2002 until joining the Company, he served as the Executive Vice President of Finance and Administration and Chief Financial Officer at The Timken Company, a global manufacturer of highly engineered bearings and alloy steels and related products and services. Previously, he served as President and Chief Operating Officer of United Dominion Industries, a diversified industrial manufacturer, now a subsidiary of SPX Corporation, after working in several roles in finance, including Executive Vice President and Chief Financial Officer. With respect to Mr. Eisenberg’s public company board experience, Mr. Eisenberg serves on the board of directors and chairs the audit committee of both Solventum Corporation and AMSURG. Previously, Mr. Eisenberg served on the Board of Directors of U.S. Ecology, Inc. from November 2019 to May 2022, where he chaired the Audit Committee, on the Board of Perspecta Inc., from May 2019 to May 2021, where he served on the Audit Committee, on the Board of Directors of Family Dollar Stores Inc. from November 2002 to July 2015, where he chaired the Audit Committee, and Alpha Natural Resources Inc. from July 2009 to May 2015, where he served as lead independent director and chaired the Nominating and Corporate Governance Committee. Mr. Eisenberg holds a Bachelor of Arts degree from Tulane University and a Master of Business Administration from Georgia State University.
Anita Z. Graham
Executive Vice President and Chief Human Resources Officer
Anita Z. Graham (53) has served as Executive Vice President and Chief Human Resources Officer since April 2023. Before joining Labcorp, Anita served as Executive Vice President, Chief Human Resources Officer and Public Affairs at VF Corporation, a footwear and apparel company, from January 2019 until January 2023, and as Vice President, Chief Human Resources Officer from January 2014 until January 2019. In addition to leading the human resources function through major business transformations, she also oversaw VF Corporation’s public affairs initiatives, including corporate communications, government relations, community relations, and the VF Foundation. Prior to her time at VF Corporation, Ms. Graham was Senior Vice President, Chief Human Resources and Administration Officer at ADT Corporation (now ADT Inc.), an electronic security, fire protection, and alarm monitoring company, where she led the human resources, environment, health and safety, and corporate communications functions. Previously, she was also the Executive Vice President, Chief Administrative Officer at Shire plc, a global biopharmaceutical company that is now part of Takeda Pharmaceuticals. Ms. Graham currently plays a leadership role in several professional organizations, including the Human Resources Policy Association, the Center on Executive Compensation, and the Center on Executive Succession. Ms. Graham holds a Bachelor of Science in Industrial and Labor Relations from Cornell University and a Master of Business Administration in finance from the Stern School of Business at New York University.
Akinbolade Oyegunwa, Ph.D.
Executive Vice President and Chief Information and Technology Officer
Akinbolade Oyegunwa (42) has served as Executive Vice President and Chief Information and Technology Officer since November 2024. Since joining Labcorp in 2019 as Vice President of Decentralized Clinical Trials Technology, Mr. Oyegunwa has pioneered advancements in remote clinical trial technology, significantly enhancing patient accessibility to trials. He went on to serve as Chief Information Officer of Labcorp’s Drug Development segment, where he led a comprehensive digital transformation, expanded robotic process automation, and developed solutions for investigators and sponsors alike. In his most recent role as Senior Vice President of Enterprise Systems, Data and Technology, Mr. Oyegunwa oversaw essential functions, such as laboratory systems, corporate systems, robotics, and data engineering. His leadership delivered transformative technology solutions across Labcorp’s Diagnostics and Biopharma Laboratory Services segments. Before Labcorp, Mr. Oyegunwa held leadership positions as Global Head of Virtual Trials Technology and Director of Corporate Strategy at
2025 PROXY STATEMENT 47
EXECUTIVE OFFICERS
IQVIA and Global Head of Corporate and Digital Strategy at Cenduit, LLC. He has also advised private equity and venture capital firms and served as a board advisor for Headlands Research, a KKR & Co. Inc. portfolio company. Mr. Oyegunwa holds a Doctor of Philosophy in Microbiology and Immunology, a Master of Microbial Biotechnology, and a Master of Business Administration from North Carolina State University.
Mark S. Schroeder
Executive Vice President and President, Diagnostics Laboratories and Chief Operations Officer
Mark Schroeder (64) has served as Executive Vice President and President, Diagnostics Laboratories and Chief Operations Officer since May 2023, having previously served as Executive Vice President, and President, Diagnostics Laboratory Operations and Global Supply Chain since November 2019. From March 2016 until November 2019, Mr. Schroeder served as Chief Supply Chain Officer. In that role, he was responsible for Labcorp’s global supply chain management function and overseeing Diagnostics and Drug Development supply chain operations around the world. Prior to that role, he served as Senior Vice President, Integrated Genetics, Oncology and Supply Chain Operations from 2014 to 2016. He was the Senior Vice President, Supply Chain Operations prior to that role, a position he held since joining the Company in May 2007. Mr. Schroeder serves on the FedEx Healthcare Industry Advisory Board and on the Flare Capital Industry Advisory Board. Mr. Schroeder holds a Bachelor of Science in Interdisciplinary Engineering and Management from Clarkson University.
Amy B. Summy
Executive Vice President and Chief Marketing Officer
Amy B. Summy (59) has served as Executive Vice President and Chief Marketing Officer since March 2020. Prior to joining Labcorp, she was Partner, Marketing & Insights Practice Leader for the Americas for Ernst & Young LLP, a public accounting firm, from February 2018 to February 2020. From January 2013 to January 2018, Ms. Summy was Senior Vice President and Chief Marketing Officer for TE Connectivity Ltd., a technology and manufacturing company, where she led the global marketing organization, brand, digital platforms, customer insights, and communications for the company. Prior to that, Ms. Summy was Vice President, Marketing from July 2011 to December 2012. Ms. Summy also worked for Sapient Corporation, a global services company that provides strategy, marketing, and digital technology services from 1996 to 2011, where she held executive leadership roles, including Managing Director and General Manager of its New York and West Coast offices and Chief Marketing Officer. Ms. Summy co-founded and is a member of the Board of Directors of No More Kids with Cancer and serves as a member of the Corporate Council and Brain Tumor Board of Visitors for The Children’s Hospital of Philadelphia. Ms. Summy received her Bachelor of Business Administration in Finance from Kent State University and holds a Master of Business Administration from New York University’s Stern School of Business.
Sandra D. van der Vaart, J.D.
Executive Vice President, Chief Legal Officer, and Corporate Secretary
Sandra D. van der Vaart (65) has served as Executive Vice President, Chief Legal Officer and Corporate Secretary since February 2020. From February 2020 until April 2024, Ms. van der Vaart also served as Chief Compliance Officer. From February 2019 to February 2020, Ms. Van der Vaart served as Senior Vice President, Global General Counsel and Chief Compliance Officer and Corporate Secretary. Prior to that she served as Labcorp’s Senior Vice President, Deputy Chief Legal Officer from September 2015 until February 2019 and Senior Vice President, General Counsel and Assistant Secretary from January 2009 until September 2015. Prior to serving in these roles, Ms. van der Vaart served in various other roles within the legal department at the Company beginning in January 2001. Ms. van der Vaart holds a Bachelor of Science in Nursing from University of North Carolina at Chapel Hill and received a Juris Doctorate from the University of Virginia.
Julia A. Wang
Executive Vice President and Chief Financial Officer
Julia A. Wang (54) has served as Executive Vice President and Chief Financial Officer since December 2024. Prior to joining Labcorp, she was in various positions at BeiGene, Ltd., including most recently as its Senior Advisor from July 2024 to August 2024 and Chief Financial Officer from June 2021 to July 2024. Prior to joining BeiGene in 2020, Ms. Wang served as Senior Vice President, Global Business Finance and Corporate Planning at Alexion Pharmaceuticals, Inc. Before Alexion, she held leadership positions at Quest Diagnostics Incorporated, including Vice President of U.S. Regional Finance and Enterprise Commercial, and Vice President of Finance, Value Creation. Earlier in her
48 LABCORP HOLDINGS INC.
EXECUTIVE OFFICERS
career, Ms. Wang held senior leadership roles at Johnson & Johnson as Chief Financial Officer of certain of its medical device and pharmaceuticals operating businesses. Previously, she also led finance initiatives at PepsiCo, Inc. Ms. Wang earned her Master of Business Administration from Fuqua School of Business at Duke University and a Bachelor of Arts in British Language and Literature from Shandong Normal University.
Peter J. Wilkinson
Senior Vice President and Chief Accounting Officer
Peter J. Wilkinson (54) has served as Senior Vice President and Chief Accounting Officer since April 2019. From January 2019 to April 2019, Mr. Wilkinson served as Labcorp’s Senior Vice President, Accounting. Prior to that, Mr. Wilkinson served as Executive Vice President and Chief Financial Officer of Syneos Health, Inc.’s clinical division, a biopharmaceuticals services organization, from August 2017 to July 2018, and as Senior Vice President and Chief Accounting Officer of INC Research Holdings, Inc., the publicly traded predecessor to Syneos Health, from February 2016 to August 2017. Mr. Wilkinson also previously served as Senior Vice President in the INC Research finance department from April 2014 to February 2016. Prior to his position with INC Research, Mr. Wilkinson worked as a self-employed financial consultant, following earlier positions as the Chief Accounting Officer at Pharmaceutical Product Development, Inc, a clinical research organization, and as an auditor with Deloitte & Touche LLP. Mr. Wilkinson holds a Bachelor of Science in Finance from Liberty University.
2025 PROXY STATEMENT 49
COMPENSATION DISCUSSION & ANALYSIS
Compensation
Discussion & Analysis
| 51 | ||||
| 52 | ||||
| Compensation Program Overview and Alignment with Company Performance and Shareholder Interests |
53 | |||
| 70 | ||||
| 77 | ||||
| The Company’s executive compensation policies are designed to assist us in attracting and retaining qualified executives by providing competitive levels of compensation that take into account the Company’s financial and business performance, execution of the Company’s strategic plan, leadership, and operational performance. The Company uses variable compensation to motivate and reward executive performance, as well as to align executive compensation with the Company’s actual performance and shareholder returns. In 2024, the CHC Committee approved annual incentive payouts to the NEOs who received payouts solely based on enterprise performance at 99.5% of target, which is consistent with our 2024 financial results, as discussed below in the section “2024 Company Performance Highlights,” on page 51.
In addition, all participants with performance shares, for the three-year measurement period that ended in 2024, earned 114.2% for such performance share awards, which is consistent with our three-year cumulative EPS, revenue, and our relative TSR modifier.
To ensure shareholder input is reflected in our programs, we engage with our shareholders throughout the year to discuss their views on our compensation programs. Over the last five years, our annual advisory vote on the compensation of our named executive officers has averaged support of approximately 91% of the shares voted. | ||||||||
|
This Compensation Discussion and Analysis describes the Company’s executive compensation program and decisions for 2024. This section details the compensation framework applied by the CHC Committee and, in particular, our compensation philosophy, elements of executive pay, compensation decisions, and the link between executive pay and performance. In accordance with the rules of the SEC, the NEOs for 2024 were: |
||||
|
• Adam H. Schechter Chairman, President and Chief Executive Officer
• Julia A. Wang Executive Vice President and Chief Financial Officer
• Brian J. Caveney Executive Vice President and President, Early Development Research Laboratories and Chief Medical and Scientific Officer
• Anita Z. Graham Executive Vice President and Chief Human Resources Officer
|
• Mark S. Schroeder Executive Vice President and President, Diagnostics Laboratories and Chief Operations Officer
• Glenn A. Eisenberg Executive Vice President and Former Chief Financial Officer |
|||
50 LABCORP HOLDINGS INC.
COMPENSATION DISCUSSION & ANALYSIS
2024 Company Performance Highlights
During 2024, we built on our position as a global leader of innovative and comprehensive laboratory services that provides vital information to help doctors, hospitals, pharmaceutical companies, researchers, and patients make clear and confident decisions.
We made notable progress in 2024 on both our near-term and longer-term strategic opportunities, which include:
| • | Be the Partner of Choice for health systems and local and regional laboratories; |
| • | Lead in the development, licensing, and scaling of specialty testing, including companion diagnostics; |
| • | Establish leadership and partnership capabilities in cell and gene therapy; |
| • | Expand consumer-centric capabilities; and |
| • | Expand global reach, including through companion diagnostics. |
The Company achieved solid operational and financial performance across a broad range of measures in 2024.
| • | Revenues from Continuing Operations: Full year of $13.0 billion, versus last year’s $12.2 billion |
| • | Diluted EPS from Continuing Operations: Full year of $8.84, versus $4.33 last year |
| • | Adjusted EPS from Continuing Operations: Full year of $14.57, versus $13.56 last year(1) |
| • | Free Cash Flow: Full year of $1.10 billion, versus last year’s $787.7 million |
| • | Transactions: Announced 10 transactions and launched innovative tests meeting significant unmet medical needs in key specialty areas in full year 2024 |
REVENUES AND ADJUSTED EPS EXCLUDING AMORTIZATION: 2022 – 2024
The below graph shows the revenues and adjusted EPS for fiscal years 2022 through 2024. For fiscal years 2022 and 2023, the full year consolidated results of the Company do not reflect the operations of Fortrea because they have been treated as discontinued operations in those years in light of the Spin-Off.

| (1) | Adjusted EPS, as presented, represents adjusted, non-GAAP financial measures. See reconciliation of Net Income to Adjusted Net Income and the calculation of Adjusted EPS below. |
2025 PROXY STATEMENT 51
COMPENSATION DISCUSSION & ANALYSIS
The table below reconciles Net Income to Adjusted Net Income and the calculation of Adjusted EPS.
| Year Ended December 31, | ||||||||||||
|
|
2022 | 2023 | 2024 | |||||||||
| NET INCOME |
$ | 1,279.1 | $ | 418.0 | $ | 746.0 | ||||||
| AMORTIZATION OF INTANGIBLES AND OTHER ASSETS |
193.6 | 219.8 | 256.4 | |||||||||
| RESTRUCTURING AND OTHER CHARGES |
54.0 | 49.1 | 46.0 | |||||||||
| ASSET IMPAIRMENTS |
261.7 | 349.0 | 5.3 | |||||||||
| ACQUISITION AND DISPOSITION-RELATED COSTS |
63.7 | 56.0 | 146.4 | |||||||||
| LAUNCHPAD COSTS |
- | - | 65.7 | |||||||||
| SPIN-OFF TRANSACTION COSTS |
6.5 | 94.1 | - | |||||||||
| COVID-19 RELATED COSTS |
27.1 | 59.6 | - | |||||||||
| CUSTOMER AND VENDOR CYBER-RELATED COSTS |
- | - | 24.1 | |||||||||
| (GAINS) LOSSES ON VENTURE FUND INVESTMENTS, NET |
12.0 | 4.8 | 3.2 | |||||||||
| (GAINS) LOSS ON SALE OF BUSINESS |
- | - | (6.4 | ) | ||||||||
| PENSION SETTLEMENT |
3.1 | 10.8 | - | |||||||||
| OTHER |
34.5 | 46.6 | 152.4 | |||||||||
| INCOME TAX IMPACT OF ADJUSTMENTS |
(233.3 | ) | (155.7 | ) | (146.1 | ) | ||||||
| EARNINGS FROM DISCONTINUED OPERATIONS, NET OF TAX |
(277.1 | ) | (38.8 | ) | - | |||||||
| CLINICAL DEVELOPMENT AND COMMERCIALIZATION SERVICES (“CDCS”) NOT INCLUDED IN DISCONTINUED OPERATIONS |
100.7 | 74.4 | - | |||||||||
| ADJUSTED NET INCOME |
$ | 1,525.6 | $ | 1,187.7 | $ | 1,230.3 | ||||||
| WEIGHTED AVERAGE SHARES OUTSTANDING |
91.6 | 87.6 | 84.4 | |||||||||
| ADJUSTED EPS |
$ | 16.66 | $ | 13.56 | $ | 14.57 | ||||||
Shareholder Engagement
Over the last five years, our annual advisory vote on the compensation of our named executive officers has averaged support of approximately 91% of the shares voted. Last year, at our 2024 Annual Meeting of Shareholders, our annual advisory vote on the compensation of our named executive officers received support from approximately 92% percent of the votes cast. We consider this level of approval an indicator that the vast majority of our shareholders support our compensation program. We remain committed to a compensation program that incentivizes our leaders and aligns with our strategy, the key value drivers of our business, and the expectations of our shareholders.
When the CHC Committee established its overall compensation program and long-term and short-term incentive plans, it considered shareholder feedback, along with other factors, such as the Company’s strategy and level of acquisition activity, the ability of leaders across the enterprise to influence different metrics, context on peer group practices provided by the CHC Committee’s independent compensation consultant FW Cook, the ability to establish meaningful goals, and the correlation to long-term shareholder value. To ensure shareholder input is reflected in our programs, we continue to engage with our shareholders throughout the year to discuss their views on our compensation and corporate governance programs, as well as other topics of emerging concern and focus. Input from our shareholders on compensation is shared with the CHC Committee and discussed as part of the CHC Committee’s annual review of our compensation program. Specific comments received from shareholders are discussed with the CHC Committee and considered in the evolution of our executive compensation program and compensation best practices, as well as our corporate governance practices.
As part of its regular review of our compensation programs and as a result of specific feedback from a shareholder, in late 2024, the CHC Committee considered incorporating return on invested capital (“ROIC”) as a potential performance metric for our long-term incentive (“LTI”) plan. The CHC Committee, together with FW Cook, evaluated the market practices of our comparative peer group and healthcare companies generally, our business strategy and level of acquisition activity, the relevance of ROIC to plan participants, and the governance processes in place supporting stewardship of capital and acquisition decisions. After a comprehensive review, the CHC Committee decided to retain the Company’s current LTI plan design, which aligns with prevailing market practice, the Company’s strategy, and key financial metrics, and includes metrics strongly correlated to TSR and well understood by plan participants. Similarly, based on strong shareholder support for our compensation programs, as indicated in our “say-on-pay” results, guidance from FW Cook, and our belief that the program
52 LABCORP HOLDINGS INC.
COMPENSATION DISCUSSION & ANALYSIS
was effective at aligning pay and performance, the CHC Committee decided to retain most of the other incentive plan design elements and performance metrics for 2024, but see the “Annual Cash Incentive Pay (LBP)” section below for a discussion of changes made to the Labcorp Bonus Plan (“LBP”) design to account for the Spin-Off and changes to the Company’s continuing operations.
The CHC Committee continues to periodically review its compensation programs to drive continued alignment with the Company’s evolving strategic goals and shareholder expectations.
Compensation Program Overview and Alignment with Company Performance and Shareholder Interests
Labcorp’s executive compensation program is designed to attract, motivate, and retain talented executives in a highly competitive environment. Our executive compensation philosophy is to pay for performance by rewarding the achievement of specific short-term and long-term financial, operational, and strategic goals. We believe our executive compensation program discourages unnecessary risk-taking and aligns executive pay with company performance, and the interests of our shareholders with the performance of our executives. This program reflects our strong commitment to a results-driven compensation program.
The CHC Committee considers the Company’s financial and business performance, execution of the Company’s strategic plan, leadership, and operational performance in making compensation decisions. The CHC Committee believes that talent is the key to the daily operating and long-term success of the Company, and has adopted a compensation program to support a pay for performance culture based on: (i) attraction, retention, and motivation of top talent; (ii) pay differentiation based on individual, business unit, and enterprise level results; (iii) compensation packages that are market competitive; (iv) fair, equitable, and compliant pay practices that support internal equity; (v) motivating performance and rewarding results that lead to profitable growth over time; and (vi) support of shareholder interests and returns.
In support of the CHC’s Committee’s philosophy, our executives’ compensation structure is:
| • | Focused on performance-based and variable compensation. Performance-based compensation comprises a significant part of total compensation, with the combined percentage of variable and at-risk compensation highest for our CEO; |
| • | Long-term performance oriented. Equity-based compensation comprises the largest part of total compensation and vests over a multi-year period to align the long-term interests of executive officers and shareholders; |
| • | Sensitive to performance variability. The size and the realizable values of incentive awards provided to executive officers varies significantly with performance achievements; |
| • | Benchmarked to industry peers. Compensation opportunities for executive officers are evaluated against those offered by companies that are in similar industries and are similar in size and scope of operations; and |
| • | Designed to recognize varying levels of responsibility. Differences in executive compensation within the Company reflect varying levels of responsibility and/or performance. |
The CHC Committee has structured our executive compensation program to align compensation with performance using three key elements of compensation: (i) annual salary; (ii) annual cash incentive pay; and (iii) long-term incentive awards. The CHC Committee generally seeks to establish total target compensation for these three elements that is competitive in relation to the median market compensation as reflected in data provided by FW Cook, its independent consultant, while continuing to emphasize the variable or at-risk portion of compensation when establishing the mix among these elements.
Approximately 76% of our CEO’s total target compensation, set by the CHC Committee in February 2024, was performance-based and at-risk and an additional approximately 16% of his total target compensation was variable and based on the performance of the Company’s stock. We believe the significant portion of total compensation delivered in equity tightly aligns our CEO’s performance with the Company’s objectives and shareholder expectations.
2025 PROXY STATEMENT 53
COMPENSATION DISCUSSION & ANALYSIS
The charts below show the mix of pay elements included in total compensation opportunities for 2024 for our CEO and an average for our other NEOs (other than Ms. Wang).
CEO PAY MIX BASED ON TARGET AWARD OPPORTUNITIES

OTHER NEO PAY MIX BASED ON TARGET AWARD OPPORTUNITIES1


| (1) | NEO pay excludes Ms. Wang. |
Labcorp seeks to achieve outstanding performance for our shareholders through focusing our executives on adjusted operating income, revenues, adjusted EPS, net orders for our BLS segment, and relative TSR (compared against our peer group). Our compensation program rewards our executives for achieving goals set for these financial metrics, as well as provides them a direct incentive to both preserve and create shareholder value and increase the Company’s stock price. A substantial majority of the executives’ 2024 compensation opportunity was in the form of variable and performance-based awards, including performance-based cash compensation under our LBP, performance shares, non-qualified stock options, and restricted stock units, all of which provide our executives a strong incentive to drive Company performance and increase shareholder value. Incentive compensation is guided by the following principles:
| • | executives receive payments only if performance goals are met or exceeded; |
| • | payments under the LBP, if any, are based on a mix of (i) Company goals common to all executives; (ii) an ESG modifier based on Company-wide performance on ESG initiatives; and (iii) an individual performance modifier for each executive addressing areas such as leadership and strategic objectives; |
| • | by granting performance shares on overlapping cycles, the Company can adjust multi-year performance goals each year, as appropriate; |
| • | a significant portion of long-term incentive target value (approximately 60%) is earned only if three-year financial performance goals are met; and |
| • | both LBP payouts and the earned number of performance shares are capped at 200% of target. |
The CHC Committee believes these principles reflect our strong commitment to a results-driven compensation program and the amounts earned in 2024 by our NEOs reflect this approach. Our annual performance in 2024 exceeded target in our Diagnostics segment and fell below target in our BLS segment. As a result of performance against our goals under the LBP and after taking into account the ESG Modifier (as defined below), the CEO and other NEOs who received an LBP payout solely on enterprise performance received a payout at 99.5% of target. Executives who received performance shares in 2022 received a share payout of 114.2% of target, reflecting our solid performance for the three-year performance period ending in 2024.
54 LABCORP HOLDINGS INC.
COMPENSATION DISCUSSION & ANALYSIS
Our commitment to paying for performance is demonstrated in the graph below, which shows the total payout of the annual non-equity incentive compensation to the CEO of the Company at the time, for each year from 2020 to 2024. During the period from 2020 through 2024, the Company reported strong growth in revenues, adjusted earnings per share, and stock price, driven in part by organic growth and disciplined acquisitions.

| (1) | Amounts shown reflect adjustments made to performance goals upon completion of the Spin-Off. |
The graph above shows the cumulative total return assuming an investment of $100 on December 31, 2019, in the Company’s common stock. For the purpose of this graph, the distribution of 100% of the outstanding common stock of Fortrea to our shareholders, pursuant to which Fortrea became an independent company, is treated as a non-taxable cash dividend of $33.11 per share, an amount equal to the opening price of the common stock of Fortrea when it began trading on June 20, 2023, that was deemed reinvested in the Company’s common stock at the closing price on June 20, 2023. The graph also shows our annual incentive plan payout to our CEO at the time. The relationship reflects the Company’s commitment to aligning our annual incentive payouts with performance.
2025 PROXY STATEMENT 55
COMPENSATION DISCUSSION & ANALYSIS
Compensation Practices
Our market-leading compensation practices are designed with features to further align the interests of our executives with those of our shareholders:
|
What We Do
| ||||
|
|
Maintain robust stock ownership requirements for executives (six times base salary for the Chief Executive Officer and three times base salary for Executive Vice Presidents)
| |||
|
|
Cap annual incentive opportunity to discourage inappropriate risk-taking
| |||
|
|
Cap cash severance payments to executive officers under arrangements subject to the Company’s Cash Severance Policy at 2.99x the sum of the executive officer’s base salary and target annual incentive award
| |||
|
|
Provide only “double trigger” change-in-control accelerated vesting provisions
| |||
|
|
Maintain a robust Incentive Compensation Recoupment Policy that requires clawback of cash- and incentive-based compensation upon the occurrence of certain events
| |||
|
|
Provide annual incentives linked to strategic and objective financial goals, which take into account company-wide performance
| |||
|
|
||||
|
|
Provide an annual target mix of performance oriented long-term incentives that includes performance shares (generally 60% of target grant value), with the remainder split between non-qualified stock options (20% of target grant value) and restricted stock units (20% of target grant value) with multi-year vesting
|
|||
|
|
Conduct annual shareholder outreach to engage on a variety of matters, including executive compensation
|
|||
|
|
Accrue dividend equivalent rights on restricted stock units and performance shares, which are only paid if and when the underlying shares vest
|
|||
|
|
Maintain an insider trading policy that, among other things, requires pre-clearance of all Company common stock transactions and limits transactions to a specified trading window for key employees
|
|||
|
What We Don’t Do
| ||||
|
|
Allow pledging or hedging of Company common stock
| |||
|
|
Provide tax gross-ups, including on severance or change-in-control payments
| |||
|
|
Use employment agreements except in connection with the hiring of our Chief Executive Officer
| |||
|
|
||||

|
Offer excessive change-in-control benefits
|
|||
|
|
Pay dividends on unvested performance awards and restricted stock units that are not earned
|
|||
The Role of the CHC Committee
The CHC Committee’s oversight responsibilities include the Company’s compensation and benefits, as well as human capital management. The CHC Committee believes that a strong focus on inclusion and belonging aligns with shareholder goals, and regular updates on the Company’s talent initiatives and programs are provided to the CHC Committee and the full Board. With respect to the NEOs and other executive officers, the CHC Committee establishes compensation and benefits plans, sets compensation targets and performance goals, and evaluates performance against those plans and goals. The CHC Committee meets throughout the year to review compensation trends, evaluate emerging best practices, and consider changes to the executive compensation programs that align pay with performance and provide our senior management with an incentive to achieve superior financial results for the Company. In determining whether changes to the executive compensation programs are needed, the CHC Committee considers the goals and strategic objectives of the Company, including changes to strategy that should be reflected in the incentive structure of the management team. The CHC Committee also considers the results of prior advisory votes on compensation, direct shareholder feedback, and input from FW Cook in determining changes to the executive compensation program. The CHC Committee approves any changes to each component of executive officer compensation, including increases in base salary, annual incentive awards, and long-term equity incentive awards.
56 LABCORP HOLDINGS INC.
COMPENSATION DISCUSSION & ANALYSIS
Compensation Decisions for our CEO
With regard to compensation decisions for our CEO, the CHC Committee considers the results of his performance assessment, including input from all independent non-employee directors, as well as the Company’s financial and business performance. In an executive session, the Chair of the CHC Committee led the independent non-employee directors through a review of Mr. Schechter’s annual accomplishments, a review and approval of compensation actions recommended by the CHC Committee, and a review of performance objectives for 2024. The Board (except for Mr. Schechter) reviewed and ratified the CHC Committee’s decisions with respect to Mr. Schechter’s compensation. In setting Mr. Schechter’s compensation for 2024, the CHC Committee took into consideration his leadership of the Company, the Company’s outstanding performance during his tenure, including the successful Spin-Off, and competitive practice at peer companies. Additionally, as described in more detail below, as part of Mr. Schechter’s compensation for 2024, Mr. Schechter received a one-time $2,000,000 long-term incentive plan award to recognize the success of the Spin-Off.
The Role of Management
Annually, and for 2024, the CEO is invited to provide input on the CHC Committee’s executive compensation decisions for his direct reports, including input on the individual performance modifier under the LBP for each NEO, subject to the approval of the CHC Committee. Mr. Schechter’s input on compensation proposals for the other NEOs are based on his assessment of past and expected individual performance and contribution. In addition, both the Company’s Chief Human Resources Officer and Senior Vice President of Total Global Rewards generally attend and participate in meetings of the CHC Committee and provide input on the design and implementation of the Company’s executive compensation program.
The Role of the Independent Consultant
FW Cook, the CHC Committee’s independent compensation consultant, plays an integral role in supporting the CHC Committee in the compensation-setting process, and one or more of its representatives typically attends the CHC Committee meetings to serve as a resource for the CHC Committee. FW Cook provides insight and advice related to the Company’s compensation plans and policies, and provides recommendations based on compensation trends and regulatory and compliance developments. To encourage independent review and discussion of executive compensation matters, the CHC Committee and its Chair regularly meet with FW Cook in executive sessions without management present. The CHC Committee has sole authority to retain or replace the independent compensation consultant. To maintain consultant independence, the CHC Committee’s pre-approval is required for all services performed by the independent compensation consultant.
The CHC Committee assesses the independence of its consultant annually, considering, among other factors, the independence factors established by the NYSE. Specifically, FW Cook provides no services to the Company or its management other than the services provided to the CHC Committee in its capacity as the CHC Committee’s independent adviser on executive compensation matters. FW Cook affirmed that no member of the consulting team has any business or personal relationship with the CEO or any member of the Company’s CHC Committee. FW Cook also affirmed that neither FW Cook nor any member of the consulting team serving the Company’s CHC Committee owns any stock of the Company. In addition, the CHC Committee evaluated the work of FW Cook and determined that its work raised no conflict of interest, including under applicable NYSE independence factors. Considering all of these factors, the CHC Committee concluded FW Cook was independent.
Use of Peer Group
In evaluating executive compensation, the CHC Committee considers both absolute performance of the Company, as well as external comparisons relative to an established peer group. The peer group is used as a reference to evaluate market pay levels for certain of our NEOs, understand peer market pay practices, and provide a comparison for the relative TSR component of our performance share awards. Annually, FW Cook prepares a review of competitive total compensation for certain of the Company’s executives versus total compensation for similar positions at our peer group companies. FW Cook also utilizes national general industry and life sciences survey data for executives for whom there is insufficient comparable information in the peer company proxy statements. The combination of the peer group data and survey data are used by the CHC Committee as market data for purposes of assessing the competitiveness of compensation. With input from FW Cook, and recognizing that the Company has limited directly comparable competitors, the comparative peer group is selected by the CHC Committee from public companies in the life science and healthcare industries that are close to Labcorp in terms of scope of services, have similar business characteristics, have connecting peer relationships (i.e., companies viewing Labcorp as a peer), and are of a similar size in terms of revenue and market capitalization. Each year, with the support of FW Cook, the CHC Committee reviews the previous year’s peer group to ensure it remains appropriate for benchmarking purposes and makes adjustments as needed to reflect changes in business strategy and other circumstances (e.g., mergers and acquisitions).
2025 PROXY STATEMENT 57
COMPENSATION DISCUSSION & ANALYSIS
In August 2023, the CHC Committee updated the peer group used for setting 2024 compensation, taking into account an annual review by FW Cook. The CHC Committee removed DaVita Inc., Syneos Health, and Thermo Fisher Scientific, and added Edwards Life Sciences and Universal Health Services. DaVita was removed to avoid any potential conflict of interest resulting from Mr. Schechter serving on the compensation committee of DaVita’s board of directors. Syneos Health was removed because it was no longer a business fit following the Spin-Off and because it was in the process of being acquired by a private equity group. Thermo Fisher Scientific was removed due to its significantly larger size compared to Labcorp in terms of revenue and market capitalization. The CHC Committee added Edwards Life Sciences and Universal Health Services to the peer group because they both align well with the Company in terms of revenue and market capitalization and reflect industry alignment. No other changes were made to the peer group at that time.
The companies included in the 2024 comparative peer group were:
Agilent Technologies, Inc.
Baxter International Inc.
Becton, Dickinson and Company Incorporated
Boston Scientific Corporation
Charles River Laboratories
Edwards Life Sciences
Henry Schein, Inc.
IQVIA Holdings, Inc.
Molina Healthcare
Quest Diagnostics Incorporated
Stryker Corporation
Universal Health Services
Viatris
Zimmer Biomet Holdings, Inc.
In April 2024, the CHC Committee established the 2025 comparative peer group considering, among other things, FW Cook’s annual review of the peer group and changes to the Company’s size and business profile following the Spin-Off. The CHC Committee removed IQVIA Holdings because it was no longer aligned with the operations of the Company following the Spin-Off. The CHC Committee added Hologic, Inc. and Tenet Healthcare Corporation to the peer group as they both align well with the Company in terms of revenue and market capitalization and reflect industry alignment.
2024 Elements of Compensation
Our executive compensation program focuses on three key elements of compensation: (i) annual salary; (ii) annual cash incentive pay; and (iii) LTI awards. The following chart shows how these elements were used by the CHC Committee in 2024.
| LABCORP—2024 EXECUTIVE COMPENSATION STRUCTURE AND ACTIONS | ||||||
| BASE SALARY |
In February 2024, the CHC Committee approved base salary increases of 2.9% for Mr. Schechter, 3.0% for Ms. Graham, and 3.1% for each of Dr. Caveney, Mr. Schroeder, and Mr. Eisenberg, effective as of June 2024.
| |||||
| LABCORP BONUS PLAN (LBP) |
PERFORMANCE METRICS
| |||||
|
Consolidated Revenues
Consolidated Adjusted Operating Income
Segment Specific Metrics
Subject to modification based on individual performance and Company-wide ESG performance
|
Payouts to the CEO and other NEOs under the LBP ranged from 91.4% to 102.7% of target performance. The payout factor for the enterprise pool was 99.5%.
| |||||
| LONG-TERM INCENTIVE (LTI) |
PERCENT OF TARGET LTI
|
PERFORMANCE METRICS
|
||||
|
60% – Performance Shares |
70% – EPS |
Payouts of the 2022-2024 performance share cycle were 114.2% of Target for the NEOs who received awards in 2022. | ||||
|
30% – Revenue
| ||||||
|
Total Shareholder Return (25% Modifier)
| ||||||
|
|
20% – Restricted Stock Units | Service During Vesting Period | ||||
|
|
20% – Non-qualified Stock Options | Service During Vesting Period | ||||
In addition to the three main elements of our compensation program, we also provide limited perquisites, severance benefits, and legacy post-retirement benefits as part of a standard and competitive compensation package.
58 LABCORP HOLDINGS INC.
COMPENSATION DISCUSSION & ANALYSIS
Base Salary
While the CHC Committee generally targets salary levels of the NEOs at the median of the peer group, it retains the flexibility to adjust individual compensation to take into account variations in the individual’s job experience and responsibilities, including as reviewed and recommended to the CHC Committee by the CEO. Annual changes in base salaries are determined using several factors, including Company performance, the individual’s performance and experience in the role, increases generally provided to our employees, and how specific executive responsibilities compare to other executives within Labcorp, as well as to the most appropriate market reference data provided by FW Cook.
In February 2024, the CHC Committee approved base salary increases for each of the NEOs (excluding Ms. Wang) as set forth in the table below. Ms. Wang’s base salary of $725,000 was established as part of her overall compensation package when she joined the Company in December 2024. In establishing Ms. Wang’s compensation package, the CHC Committee considered, among other things, her track record as a seasoned public company chief financial officer with relevant industry experience and the compensation levels for other chief financial officers within our peer group, provided by FW Cook. For more details regarding Ms. Wang’s compensation package refer to “Other Compensation Arrangements” on page 83.
The table below sets forth the base salary changes for the NEOs during 2024, effective June 16, 2024, unless otherwise noted.
| Executive |
January 1, 2024 Salary |
June 16, 2024 Salary |
Percent Change | ||||||||||||
| ADAM H. SCHECHTER |
$ | 1,394,000 | $ | 1,435,000 | 2.9 | % | |||||||||
| JULIA A. WANG(1) |
$ | - | $ | 725,000 | - | % | |||||||||
| BRIAN J. CAVENEY |
$ | 650,000 | $ | 670,000 | 3.1 | % | |||||||||
| ANITA Z. GRAHAM |
$ | 560,000 | $ | 577,000 | 3.0 | % | |||||||||
| MARK S. SCHROEDER |
$ | 650,000 | $ | 670,000 | 3.1 | % | |||||||||
| GLENN A. EISENBERG |
$ | 817,000 | $ | 842,000 | 3.1 | % | |||||||||
| (1) | Salary took effect upon hire on December 2, 2024. |
Annual Cash Incentive Pay (LBP)
The LBP is an enterprise-wide bonus plan that covers the majority of our executives and other management eligible for bonuses, including the NEOs. The LBP is designed to reward participants for achieving annual goals that further the Company’s strategy and create shareholder value. The LBP was originally introduced in 2021 to better (i) support the Company strategy through its strong focus on enterprise-wide performance; (ii) harmonize practices across the enterprise; and (iii) align with the range of performance opportunity observed with peer group and market practice. In 2022, an enterprise ESG modifier (“the ESG Modifier” as described in more detail below) that applies specifically to Section 16 officers, including the NEOs, was incorporated into the design.
For 2024, the LBP design remained in place with minor changes to account for the Spin-Off and changes to the Company’s continuing operations, including revision of the weighting of metrics applicable to the Biopharma Laboratory Services segment from 50% Adjusted Operating Income and 50% Net Orders to 70% Adjusted Operating Income and 30% Net Orders, and specific objectives applicable to the ESG Modifier, as well as to reflect 2024 financial targets.
Bonus awards for NEOs under the LBP are based on three performance factors:
| • | a Business Performance Factor, which is based on Company financial metrics; |
| • | the ESG Modifier based on overall Company performance; and |
| • | the executive’s Individual Performance Modifier. |
2025 PROXY STATEMENT 59
COMPENSATION DISCUSSION & ANALYSIS
Each NEO’s Business Performance Factor is based entirely on enterprise financial metrics, or on a combination of enterprise financial and segment financial and operating metrics, depending on the executive’s responsibility. The table below shows the metrics and weightings that determine the Business Performance Factor for each NEO, except for Ms. Wang, who was not eligible to participate in the LBP in 2024 due to the timing of her start date with the Company.
| Metrics |
Enterprise Group | Diagnostics Segment Group |
Biopharma Laboratory Services Segment Group |
|||||||||
| Executives |
|
ADAM H. SCHECHTER ANITA Z. GRAHAM GLENN A. EISENBERG |
|
MARK S. SCHROEDER | BRIAN J. CAVENEY | |||||||
| Consolidated Revenues |
50 | % | 25 | % | 35 | % | ||||||
| Consolidated Adjusted Operating Income |
50 | % | 25 | % | 35 | % | ||||||
| Diagnostics Segment Revenues |
- | 25 | % | - | ||||||||
| Diagnostics Segment Adjusted Operating Income |
- | 25 | % | - | ||||||||
| Biopharma Laboratory Services Segment Net Orders |
- | - | 9 | % | ||||||||
| Biopharma Laboratory Services Segment Adjusted Operating Income |
- | - | 21 | % | ||||||||
| Total |
100 | % | 100 | % | 100 | % | ||||||
Setting and Evaluating Performance Targets
Company financial goals may be achieved by the NEOs at a threshold, target, or superior level. If actual performance for Company financial goals falls between either the threshold and target levels or the target and superior levels, the payouts are interpolated accordingly based on payout levels shown below. Each goal is measured separately and if the threshold level of performance for a particular goal is not achieved, the payout for that goal is zero. The Business Performance Factor is calculated based on the weighted average for each metric.
| Performance Level |
Payout Level | |
| Threshold |
50% of Target | |
| Target |
100% of Target | |
| Superior |
200% of Target | |
The CHC Committee introduced the ESG Modifier in 2022 in response to shareholder feedback and evolving market trends. It was designed to incorporate overall Company performance on ESG matters. Performance is evaluated based on a holistic, qualitative review of Labcorp’s success relative to ESG performance objectives. The ESG Modifier has the potential to decrease, but not increase, the executive’s bonus based on achievement of the ESG performance objectives and can range from 90% to 100%. The ESG Modifier included the three following goals for 2024:
| • | cultivating and advancing an inclusive culture and continuing to build a robust talent pipeline; |
| • | establishing and supporting initiatives to reduce greenhouse gas emissions and employee injuries; and |
| • | advancing our commitment to data privacy, security, and compliance and ethics. |
In addition, there is an Individual Performance Modifier that increases or decreases the executive’s bonus based on individual performance, which may address individual, strategic, and operational objectives, as well as soft skills such as leadership and collaboration. The Individual Performance Modifier may range from 0% to 150%, provided that the modifier may not increase the payout to more than 200% of target under the LBP, the overall plan cap on payouts. If one or more of the individual performance metrics are not achieved (resulting in 0%), then the corresponding LBP payout could result in an amount less than the threshold level amount.
The threshold, target, and superior goals for the revenues, adjusted operating income, and BLS net orders measures were based on various outcomes considered by the CHC Committee, with the target amounts aligning to the Company’s and segment’s operating budget approved by the Board. Our 2024 goals took into consideration the Company’s and each segment’s internal outlook and expectations, and the outlook for 2024 provided to the public markets in early 2024.
60 LABCORP HOLDINGS INC.
COMPENSATION DISCUSSION & ANALYSIS
Results for 2024 Company and Segment Financial Goals
The 2024 goals and the result for the year for each goal are set forth in the following table.
| Company Goals |
Threshold | Target | Superior | 2024 Result | Achievement(7) | ||||||||||||||||||||
| Consolidated Revenues(1) |
$ | 11.6 billion | $ | 12.9 billion | $ | 14.2 billion | $ | 13.1 billion | 101.0 | % | |||||||||||||||
| Consolidated Adjusted Operating Income(2) |
$ | 1.5 billion | $ | 1.9 billion | $ | 2.1 billion | $ | 1.8 billion | 95.0 | % | |||||||||||||||
| Diagnostics Segment |
Threshold | Target | Superior | 2024 Result | Achievement(7) | ||||||||||||||||||||
| Segment Revenues(3) |
$ | 8.9 billion | $ | 9.9 billion | $ | 10.8 billion | $ | 10 billion | 102.0 | % | |||||||||||||||
| Segment Adjusted Operating Income(4) |
$ | 1.3 billion | $ | 1.7 billion | $ | 1.8 billion | $ | 1.6 billion | 97.0 | % | |||||||||||||||
| Biopharma Laboratory Services Segment |
Threshold | Target | Superior | 2024 Result | Achievement(7) | ||||||||||||||||||||
| Segment Net Orders(5) |
$ | 3.1 billion | $ | 3.4 billion | $ | 4.7 billion | $ | 2.9 billion | 86.0 | % | |||||||||||||||
| Segment Adjusted Operating Income(6) |
$ | 416.1 million | $ | 462.3 million | $ | 647.2 million | $ | 468.9 million | 101.0 | % | |||||||||||||||
| (1) | The Consolidated Revenues item represents the Company’s consolidated revenues as reported in the 2024 Annual Report, adjusted for foreign currency impact versus budgeted exchange rates. |
| (2) | Consolidated Adjusted Operating Income represents the Company’s consolidated adjusted operating income (excluding amortization, restructuring charges, special items, and impairments) as reported in the Company’s 2024 earnings release on February 6, 2025, adjusted for foreign currency impact versus budgeted exchange rates. |
| (3) | The Diagnostics Segment Revenues item represents Labcorp Diagnostics revenues as reported in the Company’s 2024 earnings release on February 6, 2025, adjusted for foreign currency impact versus budgeted exchange rates and adjusted to remove 70% of the impact of acquisitions, which reduced revenue by $0.12 billion. |
| (4) | Diagnostics Segment Adjusted Operating Income represents Labcorp Diagnostics adjusted operating income as reported in the Company’s 2024 earnings release on February 6, 2025, adjusted for foreign currency impact versus budgeted exchange rates and adjusted to remove 70% of the impact of acquisitions, which increased Adjusted Operating Income by $0.017 billion. |
| (5) | Segment Net Orders represents Biopharma Laboratory Services reported net orders at constant currency basis. |
| (6) | Biopharma Laboratory Services Adjusted Operating Income represents Biopharma Laboratory Services adjusted operating income as reported in the Company’s 2024 earnings release on February 6, 2025, adjusted for foreign currency impact versus budgeted exchange rates. There were no Biopharma Laboratory Services acquisitions in 2024. |
| (7) | Percentage achieved as a percentage of the target goal. Note that goals shown in the table have been rounded for presentation purposes. |
The table below shows for our NEOs who received awards under the 2024 LBP, the bonus opportunity, the Business Performance Factor, the ESG Modifier, the Individual Performance Modifier, and the resulting LBP award. In 2024, given the Company’s continued solid financial performance and ability to meet the continued needs of patients, providers, and pharmaceutical clients, the Individual Performance Modifier was set at 100% for each NEO. In addition, after a review of the Company’s performance against the 2024 ESG goals, the CHC Committee approved an overall ESG Modifier of 100%.
| Executive |
Prorated Salary(1) |
Bonus Target (%) of Salary |
Target Opportunity |
Business Performance Factor(2) |
Business Performance Factor Payout % |
ESG Modifier |
Individual Performance Modifier |
Bonus Payout $ | ||||||||||||||||||||||||||||||||
| ADAM H. SCHECHTER |
$ | 1,416,292 | 150% | $ | 2,124,438 | Enterprise | 99.5% | 100.0% | 100.0% | $ | 2,113,816 | |||||||||||||||||||||||||||||
| BRIAN J. CAVENEY |
$ | 660,874 | 100% | $ | 660,874 | |
Enterprise and BLS |
|
91.4% | 100.0% | 100.0% | $ | 604,039 | |||||||||||||||||||||||||||
| ANITA Z. GRAHAM |
$ | 569,243 | 85% | $ | 483,857 | Enterprise | 99.5% | 100.0% | 100.0% | $ | 481,437 | |||||||||||||||||||||||||||||
| MARK S. SCHROEDER |
$ | 660,874 | 100% | $ | 660,874 | |
Enterprise and Diagnostics |
|
102.7% | 100.0% | 100.0% | $ | 678,718 | |||||||||||||||||||||||||||
| GLENN A. EISENBERG |
$ | 830,593 | 100% | $ | 830,593 | Enterprise | 99.5% | 100.0% | 100.0% | $ | 826,440 | |||||||||||||||||||||||||||||
| (1) | Represents prorated salary for each executive. |
| (2) | Business Factor Performance for Dr. Caveney and Mr. Schroeder used different weighted segment metrics. See metrics table above on page 60 for additional information. |
Long-Term Incentive Awards
LTI awards for 2024 continued to be comprised of a mix of performance shares, non-qualified stock options, and restricted stock units. Performance shares vest based on performance at the end of a three-year performance measurement period. Non-qualified stock options and restricted stock units generally vest in equal one-third increments on the first, second, and third anniversary of the grant date. Performance shares are intended to comprise 60% or more of the target value on the grant date, with the remainder split between restricted stock units and non-qualified stock options (based on the Black-Scholes option pricing model).
2025 PROXY STATEMENT 61
COMPENSATION DISCUSSION & ANALYSIS
In setting 2024 long-term compensation, the CHC Committee determined that a balanced program using performance-based awards, non-qualified stock options, and restricted stock units would achieve all of the following:
| • | reward stock-price growth; |
| • | deliver performance-based, at-risk compensation through performance shares; |
| • | ensure longer-term business focus through the use of multi-year operational performance goals to determine the number of performance shares ultimately earned; |
| • | provide retention features through multi-year vesting of equity awards; |
| • | align interests of executive officers, including the NEOs, with interests of all shareholders; and |
| • | align with practices of the market and peer group. |
The CHC Committee annually evaluates the size of LTI award values to assess whether when combined with base salary and the target LBP payout, the total target pay opportunity generally aligns with the median of the peer group and/or other applicable market comparisons. In addition to the review of market comparisons, the CHC Committee retains the flexibility to adjust individual award levels, taking into account variations in the individual’s job experience and responsibility, including as reviewed and recommended to the CHC Committee by Mr. Schechter for executives other than himself. In 2024, the CHC Committee applied a target LTI mix of 60% performance shares, 20% non-qualified stock options, and 20% restricted stock units. In determining the target LTI award values for 2024, the CHC Committee considered whether total target pay opportunities for all of our NEOs would be within what the CHC Committee considered to be a competitive range of within 15% of the market median. The values ultimately selected were based on the Company’s desire to attract and retain executive talent; the Company’s stated objective of placing a greater emphasis on performance-based pay; internal equity; and the CHC Committee’s assessment of the executive’s individual contribution; and the Company’s performance.
Each year, the CHC Committee assesses the appropriateness of the metrics used to determine the actual number of performance shares to be earned, if any, at the end of the next three-year period. This assessment takes into consideration a number of factors, including alignment with long-term business objectives, feedback from shareholders, ability to establish meaningful long-term goals, and alignment to shareholder value creation, among others. For the 2024-2026 performance cycle, the CHC Committee determined that EPS, revenue, and relative TSR remained appropriate because they (i) are critical to the long-term success of the Company; (ii) are transparent to shareholders and the NEOs; (iii) reinforce alignment between the NEOs and shareholders through the TSR modifier; and (iv) create an appropriate balance between profitability and top-line growth, which is important to shareholder value and discourages unnecessary risk taking.
In setting Mr. Schechter’s 2024 compensation in February 2024, the CHC Committee approved an 18% increase to his LTI award value in recognition of his outstanding leadership of the Company and its strong performance under his tenure, as well as to position his pay more competitively relative to peers. As disclosed in the Company’s 2024 Proxy Statement, the CHC Committee also approved for Mr. Schechter a 15% increase to his annual LTI award of $2,000,000 to recognize his efforts contributing to the successful Spin-Off. This one-time increase had the same vehicle mix as other LTI awards, with approximately 60% in the form of performance shares. The incremental amount for Mr. Schechter is not part of his total target compensation for 2025.
The table below presents an overview of the 2024-2026 performance share awards, which are based on cumulative three-year EPS, cumulative three-year revenue, and a modifier based on TSR relative to our peer group in effect at the time of the grant.
2024-2026 Performance Share Award Targets
| Goal |
Weighting | Threshold | Target | Superior | ||||||
| EPS (three-year cumulative EPS) |
70% | $44.25 | $48.25 | $52.25 | ||||||
| REVENUE (three-year cumulative revenue) |
30% | $38.4 billion | $40.1 billion | $41.8 billion | ||||||
| RELATIVE TOTAL SHAREHOLDER RETURN MODIFIER(1) |
N/A | Bottom 25th Percentile -25% |
Between the 26th and 75th Percentile No adjustment |
Top 25th Percentile +25% | ||||||
| (1) | Refers to the percentile among our peer group based on TSR. |
62 LABCORP HOLDINGS INC.
COMPENSATION DISCUSSION & ANALYSIS
Performance shares are earned based on EPS and revenue performance as set forth in the below table. The calculation payout is based on a weighted average of the EPS and revenue performance. If the three-year cumulative relative TSR falls below the 26th percentile of our comparative peer group, the calculated payout of the performance shares will be reduced by 25%. If the three-year cumulative relative TSR is above the 75th percentile, the calculated payout of the performance shares will be increased by 25%, subject to an overall cap at 200%.
| Performance Level |
Proportion of Performance Shares Earned (Prior to application of the relative TSR Modifier) | |
| Below Threshold |
0% | |
| Threshold |
50% | |
| Target |
100% | |
| Superior |
200% | |
Details related to the grant size for each NEO can be found in the Grants of Plan-Based Awards table on page 72.
Arrangements with Ms. Wang
In connection with Ms. Wang’s appointment as Executive Vice President and Chief Financial Officer, the CHC Committee authorized compensation arrangements that were viewed as necessary to attract her to the Company. To incentivize Ms. Wang to join the Company, to better align her new compensation package with that of her prior employer, and because of her ineligibility to participate in the LBP program for 2024 due to her start date, the CHC Committee authorized an award of a one-time sign-on bonus of $400,000. As a result of negotiations with Ms. Wang, it was agreed that $200,000 of the sign-on bonus was to be paid within 30 days of Ms. Wang’s start date and $200,000 was subject to her remaining with the Company until December 2, 2025. If Ms. Wang terminates her employment with the Company or she is terminated for Cause, as defined in the Laboratory Corporation of America Holdings Amended and Restated Master Senior Executive Severance Plan (the “Severance Plan”), by the Company prior to December 2, 2025, she will not receive the latter portion of the sign-on bonus.
In addition, also in connection with Ms. Wang joining the Company, the CHC Committee approved equity awards to Ms. Wang that were structured in the same fashion as those provided to the other NEOs for 2024 in order to ensure that all of our NEOs have the same incentives under their LTI arrangements. Ms. Wang received equity grants with an aggregate initial award value of $3,200,000 in the same vehicle mix and on the same terms as the LTI awards granted to the other NEOs for 2024 and as described above. These equity grants were comprised of 20% restricted stock units, 20% non-qualified stock options, and 60% performance share awards, subject to the terms and conditions set forth in the applicable grant award agreements. By using a mix of award types, including the one-time sign-on bonus discussed above, the Company was able to meet the objective of attracting Ms. Wang to the Company and aligning her interests with those of other NEOs and our shareholders.
For more details regarding Ms. Wang’s compensation package refer to “Other Compensation Arrangements” on page 81.
2025 PROXY STATEMENT 63
COMPENSATION DISCUSSION & ANALYSIS
2022-2024 Performance Shares Earned
We granted performance shares in 2022 that would be earned only to the extent the stated performance goals over the three-year performance period ending December 31, 2024, were realized. The awards were based on cumulative three-year EPS and cumulative three-year revenue, with a modifier based on TSR relative to the peer group at the time of the grant. The awards provided that achievement at the Threshold level would result in earning 50% of the related portion of the award, achievement at the Target level would result in earning 100% of the related portion of the award, and achievement at the Superior level would result in earning 200% of the related portion of the award. In light of the Spin-Off, the Labcorp performance targets were revised to remove CDCS business forecast incorporated in the original targets and to exclude CDCS business results after the first quarter of 2023 as further described in footnote 1 to the below table. As a result of the performance, and as described below, awards were earned at 114.2% of target and vested on March 27, 2025.
| Goal |
Weighting | Threshold | Target | Superior | 2022-2024 Result | |||||||
| EPS(1) (three-year cumulative EPS) |
70% | $43.44(1) | $48.93(1) | $54.53(1) | $48.69 | |||||||
| REVENUE(1) (three-year cumulative revenue) |
30% | $39.5 billion(1) | $40.7 billion(1) | $41.9 billion(1) | $41.3B | |||||||
| RELATIVE TOTAL SHAREHOLDER RETURN MODIFIER(2) |
N/A | Bottom 25th Percentile -25% |
Between the 26th and 75th Percentile No adjustment |
Top 25th Percentile +25% |
47th Percentile | |||||||
| (1) | The 2022-2024 performance share award goal amounts shown were adjusted to remove the CDCS business forecast for the second quarter of 2023 through the fourth quarter of 2024, which had been included in the January 2022 five-year forecast used to set the original targets. The first quarter of 2023 was the last time Fortrea was treated as part of continuing operations, and thus the CDCS business was included in measuring performance against the targets through the first quarter of 2023. Following the first quarter of 2023, the CDCS business was treated as discontinued operations for purposes of the award and excluded from the measurement of performance against the targets. |
| (2) | Refers to the percentile among our peer group based on TSR. The performance share awards provided that if the three-year cumulative relative TSR was below the 26th percentile of our peer group, the calculated payout of the performance share awards earned would be reduced by 25%; if the three-year cumulative relative TSR was above the 75th percentile, the calculated payout of the performance share awards earned would be increased by 25%; and if the three-year cumulative relative TSR was in range from the 26th to the 75th percentile, then no adjustment would be made. |
The chart below shows the total payout of the performance share awards earned by our NEOs who received grants in each three-year period from 2020 to 2024.

64 LABCORP HOLDINGS INC.
Position |
Company Stock Ownership Requirements as a Multiple of Base Salary | |
Chief Executive Officer |
6x | |
Executive Vice Presidents |
3x | |
All Other Executive Officers |
1x | |
• |
purchases of Company stock on margin and/or any pledge of Company stock including holding Company stock in a marginable account and/or in any account other than a cash account ; |
• |
short sales; |
• |
the buying or selling “puts” or “calls”; and |
• |
other forms of hedging transactions, such as “prepaid variable forwards,” “equity swaps,” “collars,” and “exchange funds ”. |
COMPENSATION DISCUSSION & ANALYSIS
Perquisites
The CHC Committee has determined that financial services, long-term disability, a wellness exam allowance, and certain security services are appropriate benefits that help ensure that the Company’s executives maintain appropriate fiscal and physical health, which contributes to stable executive leadership for the Company.
Pursuant to Mr. Schechter’s employment agreement, the Company had agreed to pay up to $150,000 per calendar year for use of a corporate aircraft for nonbusiness purposes and $400,000 in incremental costs per calendar year for flights for Mr. Schechter to commute between the vicinity of his residence and his primary place of employment in Burlington, North Carolina to promote his safety and security while traveling and enhance his overall productivity and efficiency. In November 2024, the Company and Mr. Schechter entered into an aircraft time sharing agreement, to facilitate Mr. Schechter’s reimbursement to the Company for amounts in excess of the agreed amounts. In light of incidents raising additional questions regarding the safety of senior executives in public companies, particularly in the healthcare sector, the Board directed the Company to engage a third party to perform a security assessment for Mr. Schechter, because Mr. Schechter’s safety is critical for the Company’s performance and reputation and shareholder value creation. The security firm’s assessment included a review of the Company’s aircraft policies, arrangements with respect to Mr. Schechter’s travel. Upon a review of the assessment in February 2025, the CHC Committee and the Board directed the Company to require stricter measures with respect to Mr. Schechter’s travel and directed him to use the corporate aircraft for security reasons while on business and personal travel. As a result, beginning in February 2025, Mr. Schechter is no longer subject to the caps for use of corporate aircraft established by the previously agreed allowances. Mr. Schechter’s employment agreement also provides that he be provided with a car and driver for local commuting and business use. Mr. Schechter is responsible for all other commuting costs and does not receive tax reimbursement for any imputed income associated with personal travel. Additional information on the perquisites for Mr. Schechter are set forth below under the section “Mr. Schechter’s Employment Agreement – Benefits and Perquisites” on page 81.
In July 2021, the CHC Committee also authorized Mr. Schechter to review and approve limited non-business use of the corporate aircraft by executive management and employees provided that Mr. Schechter determines that it is appropriate for such employee’s productivity, privacy, safety, and security.
The CHC Committee believes that the perquisites the Company provides are appropriate and beneficial to the Company, and there are no tax gross-up payments associated with these perquisites. For more information on perquisites provided in 2024, including the valuation and amounts, see the “Summary Compensation Table” below.
Termination and Change-in-Control Payments
The Severance Plan provides participants with financial protection in circumstances involving a qualifying termination. The Severance Plan was established to provide a competitive benefit necessary to attract and retain executives, and so that in the context of a change in control the executive would consider corporate actions that would benefit shareholders without regard to personal finances.
We believe that the Severance Plan is appropriately structured and consistent with current market practice. For example, the Severance Plan provides for severance payments, a portion of which is based on the executive’s average actual annual incentive payouts over a three-year period prior to the termination of employment, rather than target, and does not have tax gross-up payments associated with change-in-control payments. For additional information on the termination and change-in-control benefits under the Severance Plan, see “Potential Payments Upon Termination or Change-in-Control” on page 77.
The Labcorp Holdings Inc. Amended and Restated 2016 Omnibus Incentive Plan provides that if awards are assumed or substituted in connection with a change in control, only a qualifying termination event will result in accelerated vesting (i.e., “double trigger”). The plan does not provide for any tax gross-ups. We believe these provisions are consistent with current compensation trends.
Mr. Schechter does not participate in the Severance Plan. For a discussion of Mr. Schechter’s severance arrangements, which are governed by the provisions of his employment agreement, see the section “Mr. Schechter’s Severance Arrangements” on page 82.
Cash Severance Payments to Executive Officers
Pursuant to the Company’s Executive Officer Cash Severance Policy, effective February 2024, any employment agreement, any severance, separation, or change of control agreement or similar arrangement, and any severance plans or policies, with or applicable to any of our executive officers entered into subsequently, will not permit cash severance benefits to exceed 2.99 times the sum of the executive officer’s base salary and annual target bonus without the approval of our shareholders.
2025 PROXY STATEMENT 67
COMPENSATION DISCUSSION & ANALYSIS
Deferred Compensation Plan
At the end of 2021, Labcorp froze both the Laboratory Corporation of America Holdings Deferred Compensation Plan and the Covance Deferred Compensation Plan and established a new plan, the Laboratory Corporation of America Holdings Nonqualified Deferred Compensation Plan (“DCP”), effective January 1, 2022. The DCP was established to provide a competitive benefit as part of the overall benefits package available to executives and provides them with a tax efficient strategy for retirement savings and capital accumulation without significant cost to the Company. Under the DCP, certain of Labcorp’s executives, including the NEOs, may elect to defer up to 90% of their annual cash incentive pay and/or up to 50% of their annual base salary and/or eligible commissions subject to annual limits established by the federal government. The deferral limits were based on the CHC Committee’s assessment of best practices at the time the DCP was established. Labcorp makes no matching contributions to the DCP. For additional information on the DCP, see “Deferred Compensation Plan” and accompanying table beginning on page 76.
Retirement Plans
The Company currently offers a 401(k) plan, which is a defined contribution retirement savings plan. Participation in this plan is available to substantially all eligible U.S.-based employees, including executives. Company contribution information for executives is reflected in the “Summary Compensation Table” below.
The Company previously adopted a supplemental retirement plan, the Pension Equalization Plan (the “PEP”) for executives, including the NEOs who have met the Plan’s service requirements. The PEP is an unfunded, non-contributory, non-qualified plan that was designed to provide income continuation benefits at retirement and work in conjunction with the Company’s Cash Balance Retirement Plan (the “Cash Balance Plan”), a qualified and funded defined benefit plan available to substantially all employees. Effective January 1, 2010, both the PEP and the Cash Balance Plan were frozen; after that date, no new participants have been admitted and no further service credits were awarded to current participants. Mr. Schroeder is the only NEO who participates in these plans.
68 LABCORP HOLDINGS INC.
COMPENSATION AND HUMAN CAPITAL COMMITTEE REPORT
Compensation and Human Capital Committee Report
The Compensation and Human Capital Committee of the Board of the Company has reviewed and discussed with management the Compensation Discussion and Analysis required by Item 402(b) of Regulation S-K. Based on such review and discussions, the Compensation and Human Capital Committee recommended to the Board that the Compensation Discussion and Analysis be included in this Proxy Statement and in the Company’s Annual Report on Form 10-K (for the year ended December 31, 2024 through incorporation by reference to this Proxy Statement).
The Compensation and Human Capital Committee
Richelle P. Parham, Chair
Garheng Kong
Paul B. Rothman
Kathryn E. Wengel
2025 PROXY STATEMENT 69
EXECUTIVE COMPENSATION
Executive Compensation
Summary Compensation Table
The compensation paid, accrued, or awarded during the years ended December 31, 2022, 2023, and 2024 to the Company’s NEOs is set forth below.
| Name and Principal Position |
Year | Salary ($)(1) |
Bonus ($)(2) |
Non-Qualified Stock Options ($)(3) |
Stock Awards ($)(3) |
Non-Equity Incentive Plan Compensation ($)(4) |
Change in Pension Value and Nonqualified Deferred Compensation Earnings ($)(5) |
All Other Compensation ($)(6) |
Total ($) | ||||||||||||||||||||||||||||||||||||
| ADAM H. SCHECHTER President and Chief Executive Officer |
2024 | $ | 1,416,077 | $ | - | $ | 3,015,965 | $ | 12,162,271 | $ | 2,113,816 | $ | - | $ | 619,225 | $ | 19,327,354 | ||||||||||||||||||||||||||||
| 2023 | $ | 1,373,692 | $ | - | $ | 2,250,072 | $ | 9,071,320 | $ | 2,346,018 | $ | - | $ | 938,253 | $ | 15,979,355 | |||||||||||||||||||||||||||||
| 2022 | $ | 1,317,500 | $ | - | $ | 2,142,125 | $ | 9,063,244 | $ | 1,675,221 | $ | - | $ | 729,207 | $ | 14,927,297 | |||||||||||||||||||||||||||||
| JULIA A. WANG Executive Vice President and Chief Financial Officer |
2024 | $ | 55,769 | $ | - | $ | 638,067 | $ | 2,668,417 | $ | - | $ | - | $ | 133 | $ | 3,362,386 | ||||||||||||||||||||||||||||
| BRIAN J. CAVENEY Executive Vice President and President, Early Development Research Laboratories and Chief Medical and Scientific Officer |
2024 | $ | 660,769 | $ | - | $ | 451,666 | $ | 1,825,122 | $ | 604,039 | $ | - | $ | 26,161 | $ | 3,567,757 | ||||||||||||||||||||||||||||
| 2023 | $ | 617,635 | $ | - | $ | 432,955 | $ | 1,745,352 | $ | 609,719 | $ | - | $ | 70,782 | $ | 3,476,443 | |||||||||||||||||||||||||||||
| 2022 | $ | 538,000 | $ | - | $ | 343,045 | $ | 1,440,880 | $ | 641,792 | $ | - | $ | 44,750 | $ | 3,008,467 | |||||||||||||||||||||||||||||
| ANITA Z. GRAHAM Executive Vice President and Chief Human Resources Officer |
2024 | $ | 569,154 | $ | 500,000 | $ | 218,548 | $ | 890,976 | $ | 481,437 | $ | - | $ | 25,432 | $ | 2,685,547 | ||||||||||||||||||||||||||||
| 2023 | $ | 420,000 | $ | 500,000 | $ | 196,708 | $ | 1,012,330 | $ | 405,331 | $ | - | $ | 21,622 | $ | 2,555,991 | |||||||||||||||||||||||||||||
| MARK S. SCHROEDER Executive Vice President and President, Diagnostics Laboratories and Chief Operations Officer |
2024 | $ | 660,769 | $ | - | $ | 502,661 | $ | 2,027,426 | $ | 678,718 | $ | 280 | $ | 116,453 | $ | 3,986,307 | ||||||||||||||||||||||||||||
| 2023 | $ | 617,635 | $ | - | $ | 461,625 | $ | 1,892,720 | $ | 718,807 | $ | 13,815 | $ | 90,506 | $ | 3,795,108 | |||||||||||||||||||||||||||||
| 2022 | $ | 538,000 | $ | - | $ | 343,045 | $ | 1,440,880 | $ | 456,051 | $ | - | $ | 65,079 | $ | 2,843,055 | |||||||||||||||||||||||||||||
| GLENN A. EISENBERG Executive Vice President and Former Chief Financial Officer |
2024 | $ | 830,462 | $ | - | $ | 655,645 | $ | 2,634,274 | $ | 826,440 | $ | - | $ | 55,087 | $ | 5,001,908 | ||||||||||||||||||||||||||||
| 2023 | $ | 805,462 | $ | - | $ | 615,878 | $ | 2,473,816 | $ | 917,054 | $ | - | $ | 144,567 | $ | 4,956,777 | |||||||||||||||||||||||||||||
| 2022 | $ | 780,500 | $ | - | $ | 586,988 | $ | 6,551,496 | $ | 661,630 | $ | - | $ | 101,879 | $ | 8,682,493 | |||||||||||||||||||||||||||||
| (1) | Values reflect the amounts actually paid to the NEOs in each year. Base salary adjustments, if any, typically occur at the end of June or early July of each year. Base salary adjustments are typically not retroactive to the beginning of the year. |
| (2) | Represents amounts paid as a discretionary bonus. In January 2025, Ms. Wang was paid $200,000 of her sign-on bonus in connection with commencing her new employment in recognition of her foregoing compensation opportunities from her previous employer and attract her to the Company. In April 2023, Ms. Graham was paid a one-time sign-on bonus in connection with commencing her new employment to compensate her for forfeited compensation opportunities from her previous employer. In January 2024, Ms. Graham was paid a one-time retention bonus as per the terms of her employment agreement. |
70 LABCORP HOLDINGS INC.
EXECUTIVE COMPENSATION
| (3) | Represents the aggregate grant date fair value of options, restricted stock units, and performance shares for each NEO granted during each respective year, computed in accordance with accounting standards for stock-based compensation. The grant date fair value of restricted stock units is based on the closing price of the Common Stock on the applicable grant date. For the 2024 performance share awards, the grant date fair value is based on a Monte Carlo simulated fair value for the relative (to the peer group at the time of the grant) TSR component of the performance awards. The Monte Carlo simulation model relies upon assumptions, including the historical and expected volatility of the Company’s stock price and the relevant comparator index, correlation coefficients, and interest rates. Assumptions used in these calculations are included on page F-33 of our 2024 Annual Report. The February 2024 performance share awards included in the above totals are valued assuming achievement of the EPS and revenues goals at target, which was the probable outcome determined for accounting purposes at the time of grant. The threshold and superior grant date values of performance share awards granted in 2024 included above are as set forth in the table below. |
| Name |
Grant Date Threshold |
Grant Date Superior | ||||||||
| ADAM H. SCHECHTER |
$ | 4,594,082 | $ | 18,376,330 | ||||||
| JULIA A. WANG |
$ | 1,011,764 | $ | 4,047,057 | ||||||
| BRIAN J. CAVENEY |
$ | 689,170 | $ | 2,756,678 | ||||||
| ANITA Z. GRAHAM |
$ | 336,571 | $ | 1,346,285 | ||||||
| MARK S. SCHROEDER |
$ | 765,871 | $ | 3,063,485 | ||||||
| GLENN A. EISENBERG |
$ | 994,831 | $ | 3,979,325 | ||||||
| (4) | Represents the amounts earned by each NEO during 2024 pursuant to the Company’s LBP. |
| (5) | Represents solely the aggregate change in the actuarial present value of each NEO’s accumulated benefit under the Company’s pension plans from December 31, 2021 to December 31, 2022, December 31, 2022 to December 31, 2023, and December 31, 2023 to December 31, 2024, respectively. For the assumptions made in the 2024 valuations, see Note 16 to the Company’s audited financial statements included within our 2024 Annual Report. These assumptions change from year to year to reflect current market conditions. |
| (6) | Includes the value of the following perquisites: financial services; cash dividends; executive long-term disability premiums; and security and travel, pursuant to the policies in effect for a particular year. Financial services amounts are based on the actual amounts paid by the Company to its third-party vendor for financial services. Cash dividends include amounts paid or to be paid at vesting for awards granted in 2021, reflecting dividends paid on the Company’s common stock in 2024. Dividend equivalent rights are not paid out unless the underlying shares vest. Also includes Company 401(k) Plan contributions, which are applicable to all eligible employees. |
Perquisites
The table below details the perquisites, including those that exceeded 10% of the total perquisites, received by the NEOs during 2024, plus the Company contributions into each executive’s 401(k) account during 2024, except for Ms. Wang due to the timing of her start date.
| Name |
Year | Financial Services(1) |
Cash Dividends(2) |
Long-Term Disability(1) |
Security and Travel(3) |
Company Paid 401-K(4) | ||||||||||||||||||||||||
| ADAM H. SCHECHTER |
2024 | $ | 20,000 | $ | 52,154 | $ | 1,908 | $ | 532,886 | $ | 12,277 | |||||||||||||||||||
| BRIAN J. CAVENEY |
2024 | $ | - | $ | 8,320 | $ | 1,590 | $ | 1,438 | $ | 14,813 | |||||||||||||||||||
| ANITA Z. GRAHAM |
2024 | $ | 10,900 | $ | - | $ | 1,590 | $ | - | $ | 12,942 | |||||||||||||||||||
| MARK S. SCHROEDER |
2024 | $ | 20,000 | $ | 8,320 | $ | 1,590 | $ | 70,043 | $ | 16,500 | |||||||||||||||||||
| GLENN A. EISENBERG |
2024 | $ | 20,000 | $ | 14,423 | $ | 1,590 | $ | 4,787 | $ | 14,287 | |||||||||||||||||||
| (1) | Represents the actual cost of the perquisite, which is taxable to the NEO, and for which taxes are not reimbursed by the Company. |
| (2) | Represents dividend equivalent rights associated with restricted stock units or performance shares granted prior to 2022. Because these awards were granted prior to the Company’s announcement of its intent to introduce a dividend, the dividend was not incorporated into the grant date fair value. Includes the total dividends paid, less any amounts included in the prior year’s compensation. Dividend equivalent rights are not paid out unless the underlying shares vest. |
| (3) | The Board instructed each of Messrs. Schechter, Eisenberg, Schroeder and Dr. Caveney to take certain actions to enhance their security, which for Mr. Schechter included using a specified company vehicle and resulted in his employment agreement providing that he be provided with a car and driver for local commuting and business use. Rather than disclose a lower amount based on the use of the automobile attributable to what is deemed to be personal use, which is permitted under applicable rules, this column reflects all the costs, both personal and business, incurred by the Company in 2024 for the vehicle used by Mr. Schechter ($44,644). Pursuant to Mr. Schechter’s employment agreement, he received a personal travel allowance for use of the corporate aircraft of up to $150,000 per year, however, he will not receive tax reimbursement for any imputed income associated with personal travel. In addition, pursuant to his employment agreement, Mr. Schechter is entitled to flights to commute between the vicinity of his residence and his primary place of employment in Burlington, North Carolina, with an incremental cost to the Company of up to $400,000 per calendar year. In November 2024, the Company and Mr. Schechter entered into an aircraft time sharing agreement, whereby Mr. Schechter must reimburse the Company for amounts in excess of his $150,000 personal allowance and his $400,000 commuting allowance. The cost for his personal use was calculated using the Company’s aggregate incremental direct operating costs, including the hourly cost of fuel, landing, ramp and parking fees, and other variable costs incurred by the Company for the flights, as well as any fixed hourly rate charged to the Company for the trip-specific aircraft. In 2024, Mr. Schechter reimbursed the Company for his personal use of the corporate aircraft in excess of the personal allowance of $150,000. Mr. Schechter’s calculated cost for commuting travel in 2024 was $334,766. For 2024, Mr. Schroeder’s calculated cost for personal use of the corporate aircraft was $68,605. He will not receive tax reimbursement for any imputed income associated with personal travel. For security-related services in 2024, the Company paid $3,477 for Mr. Schechter, $4,787 for Mr. Eisenberg, and $1,438 for each of Dr. Caveney and Mr. Schroeder. |
| (4) | Includes the Company’s matching contribution to 401(k), which is applicable to all eligible employees. |
2025 PROXY STATEMENT 71
EXECUTIVE COMPENSATION
Grants of Plan-Based Awards
The table below outlines the restricted stock units, performance shares, non-qualified stock options, and annual cash incentive awards pursuant to the LBP that were made to the NEOs during 2024.
| Estimated Possible Payouts Under Non-Equity Incentive Plan |
|
Estimated Future Payouts Under Equity Incentive Plan Awards(2) |
All Other Number of Underlying |
Exercise Price of |
All Other |
Grant |
||||||||||||||||||||||||||||||||||||||||||||
| Name
|
Award Type
|
Grant
|
Threshold ($)
|
Target ($)
|
Maximum ($)
|
|
Threshold (#)
|
Target (#)
|
Maximum (#)
|
Options (#)(3)
|
Awards ($/SH)
|
Units (#)(4)
|
Awards ($)(5)
|
|||||||||||||||||||||||||||||||||||||
| ADAM H. SCHECHTER |
Restricted Stock Units | 2/6/2024 | 13,380 | $ | 2,974,106 | |||||||||||||||||||||||||||||||||||||||||||||
| Performance Shares | 2/6/2024 | 20,065 | 40,130 | 80,260 | $ | 9,188,165 | ||||||||||||||||||||||||||||||||||||||||||||
| Stock Options | 2/6/2024 | 41,400 | $ | 222.28 | $ | 3,015,965 | ||||||||||||||||||||||||||||||||||||||||||||
| LBP | 3/31/2024 | $ | 1,065,129 | $ | 2,130,259 | $ | 4,260,518 | |||||||||||||||||||||||||||||||||||||||||||
| JULIA A. WANG |
Restricted Stock Units | 12/2/2024 | 2,680 | $ | 644,888 | |||||||||||||||||||||||||||||||||||||||||||||
| Performance Shares | 12/2/2024 | 4,025 | 8,050 | 16,100 | $ | 2,023,529 | ||||||||||||||||||||||||||||||||||||||||||||
| Stock Options | 12/2/2024 | 8,100 | $ | 240.63 | $ | 638,067 | ||||||||||||||||||||||||||||||||||||||||||||
| BRIAN J. CAVENEY |
Restricted Stock Units | 2/6/2024 | 2,010 | $ | 446,783 | |||||||||||||||||||||||||||||||||||||||||||||
| Performance Shares | 2/6/2024 | 3,010 | 6,020 | 12,040 | $ | 1,378,339 | ||||||||||||||||||||||||||||||||||||||||||||
| Stock Options | 2/6/2024 | 6,200 | $ | 222.28 | $ | 451,666 | ||||||||||||||||||||||||||||||||||||||||||||
| LBP | 3/31/2024 | $ | 331,343 | $ | 662,685 | $ | 1,325,370 | |||||||||||||||||||||||||||||||||||||||||||
| ANITA Z. GRAHAM |
Restricted Stock Units | 2/6/2024 | 980 | $ | 217,834 | |||||||||||||||||||||||||||||||||||||||||||||
| Performance Shares | 2/6/2024 | 1,470 | 2,940 | 5,880 | $ | 673,142 | ||||||||||||||||||||||||||||||||||||||||||||
| Stock Options | 2/6/2024 | 3,000 | $ | 222.28 | $ | 218,548 | ||||||||||||||||||||||||||||||||||||||||||||
| LBP | 3/31/2024 | $ | 242,591 | $ | 485,182 | $ | 970,364 | |||||||||||||||||||||||||||||||||||||||||||
| MARK S. SCHROEDER |
Restricted Stock Units | 2/6/2024 | 2,230 | $ | 495,684 | |||||||||||||||||||||||||||||||||||||||||||||
| Performance Shares | 2/6/2024 | 3,345 | 6,690 | 13,380 | $ | 1,531,742 | ||||||||||||||||||||||||||||||||||||||||||||
| Stock Options | 2/6/2024 | 6,900 | $ | 222.28 | $ | 502,661 | ||||||||||||||||||||||||||||||||||||||||||||
| LBP | 3/31/2024 | $ | 331,343 | $ | 662,685 | $ | 1,325,370 | |||||||||||||||||||||||||||||||||||||||||||
| GLENN A. EISENBERG |
Restricted Stock Units | 2/6/2024 | 2,900 | $ | 644,612 | |||||||||||||||||||||||||||||||||||||||||||||
| Performance Shares | 2/6/2024 | 4,345 | 8,690 | 17,380 | $ | 1,989,662 | ||||||||||||||||||||||||||||||||||||||||||||
| Stock Options | 2/6/2024 | 9,000 | $ | 222.28 | $ | 655,645 | ||||||||||||||||||||||||||||||||||||||||||||
| LBP | 3/31/2024 | $ | 402,747 | $ | 832,868 | $ | 1,610,986 | |||||||||||||||||||||||||||||||||||||||||||
| (1) | Amounts represent the range of possible payouts denominated in dollars pursuant to the LBP, as established by the CHC Committee in February 2024. Pursuant to the LBP, base salary amounts used to calculate target bonus amounts are prorated to reflect base salary increases effective June 2024 for Mr. Schechter, Dr. Caveney, Ms. Graham, Mr. Schroeder and Mr. Eisenberg. Actual amounts paid out pursuant to the plan are included in the Non-Equity Incentive Plan Compensation column of the Summary Compensation Table above. For a discussion of the performance criteria applicable to these awards, see “Compensation Discussion and Analysis – Annual Cash Incentive Pay (LBP)” above. |
| (2) | Amounts represent the range of estimated potential shares to be earned under performance share awards. The performance share awards vest at the end of three years provided that certain performance metrics are met. For a discussion of the performance criteria applicable to these awards, see “Compensation Discussion and Analysis – Long-Term Incentive Awards” above. |
| (3) | Amounts represent stock option awards that vest ratably over three years, beginning on the first anniversary of the grant date, based on continued service, including Ms. Wang’s December 2, 2024 grant, which will vest ratably over three years, beginning with the first vesting on February 6, 2025. |
| (4) | Amounts represent restricted stock unit awards that vest ratably over three years, beginning on the first anniversary of the grant date, based on continued service, including Ms. Wang’s December 2, 2024 grant, which will vest ratably over three years, beginning with the first vesting on February 6, 2025. |
| (5) | Amounts represent the full grant date fair value of restricted stock unit, non-qualified stock option, and performance share awards as computed in accordance with accounting standards for stock-based compensation, but excluding the effect of estimated forfeitures. The amounts shown in this column will likely vary from the amount actually realized by any NEO based on a number of factors, including the number of shares that ultimately vest, the satisfaction or failure to meet any performance criteria, the timing of any exercise or sale of shares, and the price of the Company’s Common Stock. The value for non-qualified stock options is calculated using the Black-Scholes option pricing model. The value of the performance share awards granted in 2024 as of the grant date if they are achieved at the maximum payout, is as follows: Mr. Schechter – $18,376,330; Ms. Wang—$4,047,057; Dr. Caveney—$2,756,678; Ms. Graham—$1,346,285; Mr. Schroeder—$3,063,485, and Mr. Eisenberg—$3,979,325. |
72 LABCORP HOLDINGS INC.
EXECUTIVE COMPENSATION
Outstanding Equity Awards at Fiscal Year-End
The following table shows, as of December 31, 2024, the number of outstanding non-qualified stock options, restricted stock units, and performance shares held by the NEOs.
| Option Awards | Stock Awards | |||||||||||||||||||||||||||||||||||||||||||||||||
| Name |
Grant Date |
Number of Securities Underlying Unexercised Options (#) Exercisable(1) |
Number of Securities Underlying Unexercised Options (#) Unexercisable(1) |
Option Price |
Option Expiration Date |
|
Number of Shares or Units of |
Market Value of Shares or Units of Stock That Have Not Vested ($)(3) |
Equity Awards: or Other |
Equity Awards: | ||||||||||||||||||||||||||||||||||||||||
| ADAM H. SCHECHTER |
|
11/1/2019
|
|
|
27,661
|
|
|
-
|
|
$
|
149.31
|
|
|
10/31/2029
|
|
|||||||||||||||||||||||||||||||||||
|
|
11/1/2019 |
|
72,612 | - | $ | 171.70 | 10/31/2029 | |||||||||||||||||||||||||||||||||||||||||||
| 2/4/2020 | 50,862 | - | $ | 163.63 | 2/3/2030 | |||||||||||||||||||||||||||||||||||||||||||||
| 2/2/2021 | 32,346 | - | $ | 209.25 | 2/1/2031 | |||||||||||||||||||||||||||||||||||||||||||||
| 2/11/2022 | 20,893 | 10,449 | $ | 247.68 | 2/10/2032 | |||||||||||||||||||||||||||||||||||||||||||||
| 2/7/2023 | 10,186 | 20,375 | $ | 221.67 | 2/6/2033 | |||||||||||||||||||||||||||||||||||||||||||||
| 2/6/2024 | - | 41,400 | $ | 222.28 | 2/5/2034 | |||||||||||||||||||||||||||||||||||||||||||||
| 2/11/2022 | 2,963 | $ | 679,475 | |||||||||||||||||||||||||||||||||||||||||||||||
| 2/7/2023 | 6,499 | $ | 1,490,351 | |||||||||||||||||||||||||||||||||||||||||||||||
| 2/6/2024 | 13,380 | $ | 3,068,302 | |||||||||||||||||||||||||||||||||||||||||||||||
| 2/11/2022 | 30,469 | $ | 6,987,151 | |||||||||||||||||||||||||||||||||||||||||||||||
| 2/7/2023 | 58,470 | $ | 13,408,340 | |||||||||||||||||||||||||||||||||||||||||||||||
| 2/6/2024 | 80,260 | $ | 18,405,223 | |||||||||||||||||||||||||||||||||||||||||||||||
| JULIA A. WANG |
|
12/2/2024
|
|
|
-
|
|
|
8,100
|
|
$
|
240.63
|
|
|
12/1/2034
|
|
|||||||||||||||||||||||||||||||||||
|
|
12/2/2024 |
|
2,680 | $ | 614,578 | |||||||||||||||||||||||||||||||||||||||||||||
| 12/2/2024 | 16,100 | $ | 3,692,052 | |||||||||||||||||||||||||||||||||||||||||||||||
| BRIAN J. CAVENEY |
|
2/12/2018
|
|
|
3,011
|
|
|
-
|
|
$
|
151.06
|
|
|
2/11/2028
|
|
|||||||||||||||||||||||||||||||||||
|
|
2/12/2019 |
|
3,903 | - | $ | 131.43 | 2/11/2029 | |||||||||||||||||||||||||||||||||||||||||||
| 2/4/2020 | 8,142 | - | $ | 163.63 | 2/3/2030 | |||||||||||||||||||||||||||||||||||||||||||||
| 2/2/2021 | 5,130 | - | $ | 209.25 | 2/1/2031 | |||||||||||||||||||||||||||||||||||||||||||||
| 2/11/2022 | 3,346 | 1,673 | $ | 247.68 | 2/10/2032 | |||||||||||||||||||||||||||||||||||||||||||||
| 2/7/2023 | 1,635 | 3,272 | $ | 221.67 | 2/6/2033 | |||||||||||||||||||||||||||||||||||||||||||||
| 5/5/2023 | 371 | 744 | $ | 200.70 | 5/4/2033 | |||||||||||||||||||||||||||||||||||||||||||||
| 2/6/2024 | - | 6,200 | $ | 222.28 | 2/5/2034 | |||||||||||||||||||||||||||||||||||||||||||||
| 2/11/2022 | 473 | $ | 108,468 | |||||||||||||||||||||||||||||||||||||||||||||||
| 2/7/2023 | 1,034 | $ | 237,117 | |||||||||||||||||||||||||||||||||||||||||||||||
| 5/5/2023 | 223 | $ | 51,138 | |||||||||||||||||||||||||||||||||||||||||||||||
| 2/6/2024 | 2,010 | $ | 460,933 | |||||||||||||||||||||||||||||||||||||||||||||||
| 2/11/2022 | 4,840 | $ | 1,109,909 | |||||||||||||||||||||||||||||||||||||||||||||||
| 2/7/2023 | 9,304 | $ | 2,133,593 | |||||||||||||||||||||||||||||||||||||||||||||||
| 5/5/2023 | 1,986 | $ | 455,430 | |||||||||||||||||||||||||||||||||||||||||||||||
| 2/6/2024 | 12,040 | $ | 2,761,013 | |||||||||||||||||||||||||||||||||||||||||||||||
2025 PROXY STATEMENT 73
EXECUTIVE COMPENSATION
| Option Awards | Stock Awards | |||||||||||||||||||||||||||||||||||||||||||||||||
| Name |
Grant Date |
Number of Securities Underlying Unexercised Options (#) Exercisable(1) |
Number of Securities Underlying Unexercised Options (#) Unexercisable(1) |
Option Price |
Option Expiration Date |
|
Number of Shares or Units of |
Market Value of Shares or Units of Stock That Have Not Vested ($)(3) |
Equity Awards: or Other |
Equity Awards: | ||||||||||||||||||||||||||||||||||||||||
| ANITA Z. GRAHAM |
|
4/5/2023
|
|
|
1,115
|
|
|
2,231
|
|
$
|
209.80
|
|
|
4/4/2033
|
|
|||||||||||||||||||||||||||||||||||
|
|
2/6/2024 |
|
- | 3,000 | $ | 222.28 | 2/5/2034 | |||||||||||||||||||||||||||||||||||||||||||
| 4/5/2023 | 736 | $ | 168,780 | |||||||||||||||||||||||||||||||||||||||||||||||
| 2/6/2024 | 980 | $ | 224,734 | |||||||||||||||||||||||||||||||||||||||||||||||
| 4/5/2023 | 6,604 | $ | 1,514,429 | |||||||||||||||||||||||||||||||||||||||||||||||
| 2/6/2024 | 5,880 | $ | 1,348,402 | |||||||||||||||||||||||||||||||||||||||||||||||
| MARK S. SCHROEDER |
|
2/12/2018
|
|
|
3,011
|
|
|
-
|
|
$
|
151.06
|
|
|
2/11/2028
|
|
|||||||||||||||||||||||||||||||||||
|
|
2/12/2019 |
|
3,903 | - | $ | 131.43 | 2/11/2029 | |||||||||||||||||||||||||||||||||||||||||||
| 2/4/2020 | 8,142 | - | $ | 163.63 | 2/3/2030 | |||||||||||||||||||||||||||||||||||||||||||||
| 2/2/2021 | 5,130 | - | $ | 209.25 | 2/1/2031 | |||||||||||||||||||||||||||||||||||||||||||||
| 2/11/2022 | 3,346 | 1,673 | $ | 247.68 | 2/10/2032 | |||||||||||||||||||||||||||||||||||||||||||||
| 2/7/2023 | 1,635 | 3,272 | $ | 221.67 | 2/6/2033 | |||||||||||||||||||||||||||||||||||||||||||||
| 5/5/2023 | 519 | 1,042 | $ | 200.70 | 5/4/2033 | |||||||||||||||||||||||||||||||||||||||||||||
| 2/6/2024 | - | 6,900 | $ | 222.28 | 2/5/2034 | |||||||||||||||||||||||||||||||||||||||||||||
| 2/11/2022 | 473 | $ | 108,468 | |||||||||||||||||||||||||||||||||||||||||||||||
| 2/7/2023 | 1,034 | $ | 237,117 | |||||||||||||||||||||||||||||||||||||||||||||||
| 5/5/2023 | 328 | $ | 75,217 | |||||||||||||||||||||||||||||||||||||||||||||||
| 2/6/2024 | 2,230 | $ | 511,384 | |||||||||||||||||||||||||||||||||||||||||||||||
| 2/11/2022 | 4,840 | $ | 1,109,909 | |||||||||||||||||||||||||||||||||||||||||||||||
| 2/7/2023 | 9,304 | $ | 2,133,593 | |||||||||||||||||||||||||||||||||||||||||||||||
| 5/5/2023 | 2,968 | $ | 680,622 | |||||||||||||||||||||||||||||||||||||||||||||||
| 2/6/2024 | 13,380 | $ | 3,068,302 | |||||||||||||||||||||||||||||||||||||||||||||||
| GLENN A. EISENBERG |
|
2/11/2022
|
|
|
5,725
|
|
|
2,863
|
|
$
|
247.68
|
|
|
2/10/2032
|
|
|||||||||||||||||||||||||||||||||||
|
|
2/7/2023 |
|
- | 5,577 | $ | 221.67 | 2/6/2033 | |||||||||||||||||||||||||||||||||||||||||||
| 2/6/2024 | - | 9,000 | $ | 222.28 | 2/5/2034 | |||||||||||||||||||||||||||||||||||||||||||||
| 2/11/2022 | 807 | $ | 185,061 | |||||||||||||||||||||||||||||||||||||||||||||||
| 2/7/2023 | 1,770 | $ | 405,896 | |||||||||||||||||||||||||||||||||||||||||||||||
| 2/6/2024 | 2,900 | $ | 665,028 | |||||||||||||||||||||||||||||||||||||||||||||||
| 2/11/2022 | 8,305 | $ | 1,904,503 | |||||||||||||||||||||||||||||||||||||||||||||||
| 2/7/2023 | 15,952 | $ | 3,658,113 | |||||||||||||||||||||||||||||||||||||||||||||||
| 2/6/2024 | 17,380 | $ | 3,985,582 | |||||||||||||||||||||||||||||||||||||||||||||||
| (1) | Stock option awards vest ratably over three years, beginning on the first anniversary of the grant date, except for Dr. Caveney and Mr. Schroeder’s May 5, 2023 grants and Ms. Graham’s April 5, 2023 grant, each of which vest ratably over three years, beginning with the first vesting on February 7, 2024. Ms. Wang’s December 2, 2024 grant vests ratably over three years beginning with the first vesting on February 6, 2025. |
| (2) | Restricted stock units vest ratably over three years, beginning on the first anniversary of the grant date, except for Dr. Caveney and Mr. Schroeder’s May 5, 2023 grants and Ms. Graham’s April 5, 2023 grant, each of which vest ratably over three years, beginning with the first vesting on February 7, 2024. Ms. Wang’s December 2, 2024 grant vests ratably over three years beginning with the first vesting on February 6, 2025. |
| (3) | Aggregate market value is calculated based on the Company’s common stock price on December 31, 2024, which was $229.32 per share, multiplied by the number of shares or units, respectively, for each unvested performance share or stock award. |
74 LABCORP HOLDINGS INC.
EXECUTIVE COMPENSATION
| (4) | Represents the number of shares subject to the February 11, 2022, performance awards that vested on March 27, 2025, following the performance period ending December 31, 2024. |
| (5) | Based on performance to date, represents the number of shares subject to the February 7, 2023, performance share awards, or, in the case of Dr. Caveney and Mr. Schroeder, the May 5, 2023, performance share awards, or in the case of Ms. Graham, the April 5, 2023, performance share award, for the performance period ending December 31, 2025, as adjusted to account for the Spin-Off, assuming achievement at superior. Information on the threshold, target, and superior awards are provided in the “Grants of Plan-Based Awards” table in the Company’s Proxy Statement for its 2024 Annual Meeting of Shareholders. |
| (6) | Based on performance to date, represents the number of shares subject to the February 6, 2024 performance share awards, or, in the case of Ms. Wang the December 2, 2024 performance share award, assuming achievement at superior. Information on the threshold, target, and superior awards are provided in the “Grants of Plan-Based Awards” table above. |
Option Exercises and Stock Vested
The following table shows, for 2024, the number and value of non-qualified stock options exercised and the number and value of vested restricted stock units and performance shares for each of the NEOs.
| Option Awards |
|
Stock Awards | |||||||||||||||||||||||
|
|
Number of Acquired on Exercise (#)(1) |
Value Realized on Exercise ($)(2) |
|
Number of Acquired on Vesting (#)(1) |
Value Realized on Vesting ($) | ||||||||||||||||||||
| ADAM H. SCHECHTER(3) |
- | $ | - | 81,743 | $ | 17,773,912 | |||||||||||||||||||
| BRIAN J. CAVENEY(4) |
- | $ | - | 13,152 | $ | 2,860,415 | |||||||||||||||||||
| ANITA Z. GRAHAM(5) |
- | $ | - | 369 | $ | 82,549 | |||||||||||||||||||
| MARK S. SCHROEDER(4) |
2,119 | $ | 214,782 | 13,203 | $ | 2,871,824 | |||||||||||||||||||
| GLENN A. EISENBERG(6) |
25,765 | $ | 1,077,509 | 43,039 | $ | 9,049,294 | |||||||||||||||||||
| (1) | The numbers in this column reflect the equity award adjustments made in connection with the Spin-Off for those stock option awards that vested after the date of the Spin-Off. For additional information about the effect of the Spin-Off on equity awards, see “Compensation Discussion and Analysis - Summary of Spin-Off Equity Award Adjustments” in the 2024 Annual Proxy Statement. |
| (2) | The value realized on exercise was based on the price at which these shares were sold, which occurred simultaneously with the exercise. Consequently, the value realized was the sale price minus the strike price, multiplied by the number of shares exercised and sold. |
| (3) | Represents one-third of the restricted stock units granted on February 2, 2021 that vested on February 2, 2024 at $221.54 per share, the closing price on that date; one-third of the restricted stock units granted on February 11, 2022 that vested on February 11, 2024 at $227.45 per share, the closing price on February 12, 2024; one-third of the restricted stock units granted on February 7, 2023 that vested on February 7, 2024 at $223.71 per share, the closing price on that date; and the performance shares granted on February 2, 2021 that converted into restricted stock units upon completion of the Spin-Off that vested on March 27, 2024 at $216.57 per share, the closing price on that date. |
| (4) | Represents one-third of the restricted stock units granted on February 2, 2021 that vested on February 2, 2024 at $221.54 per share, the closing price on that date; one-third of the restricted stock units granted on February 11, 2022 that vested on February 11, 2024 at $227.45 per share, the closing price on February 12, 2024; one-third of the restricted stock units granted on February 7, 2023 that vested on February 7, 2024 at $223.71 per share, the closing price on that date; one-third of the restricted stock units granted on May 5, 2023 that vested on February 7, 2024 at $223.71 per share, the closing price on that date; and the performance shares granted on February 2, 2021 that converted into restricted stock units upon completion of the Spin-Off that vested on March 27, 2024 at $216.57 per share, the closing price on that date. |
| (5) | Represents one-third of the restricted stock units granted on April 5, 2023 that vested on February 7, 2024 at $223.71 per share, the closing price on that date. |
| (6) | Represents one-third of the restricted stock units granted on February 2, 2021 that vested on February 2, 2024 at $221.54 per share, the closing price on that date; one-third of the restricted stock units granted on February 11, 2022 that vested on February 11, 2024 at $227.45 per share, the closing price on February 12, 2024; all of the restricted stock units granted on November 1, 2022 that vested on April 15, 2024 at $203.32 per share, the closing price on that date; all of the performance shares granted on November 1, 2022 that vested on April 30, 2024 at $201.37, the closing price on that date; one-third of the restricted stock units granted on February 7, 2023 that vested on February 7, 2024 at $223.71 per share, the closing price on that date; and the performance shares granted on February 2, 2021 that converted into restricted stock units upon completion of the Spin-Off that vested on March 27, 2024 at $216.57 per share, the closing price on that date. |
Retirement Benefits
Prior to January 1, 2010, substantially all employees, including Mr. Schroeder (the only NEO eligible to participate as of January 2010), were eligible to participate in the Cash Balance Plan; the Cash Balance Plan was funded by the Company both in terms of an annual service
credit, which is a percentage of base salary, and an interest credit, currently at four percent per year. Eligibility requirements under the Cash Balance Plan included one year of service (participants entered the plan in either January or July after meeting the service requirement) and the attainment of 21 years of age. Mr. Schroeder has met the eligibility requirements.
As discussed above, the Company also has a PEP. In October 2009, the Board froze any additional service-based credits for any years of service after December 31, 2009, with respect to both the Cash Balance Plan and the PEP. Both plans are closed to new entrants. Current participants in the Cash Balance Plan and PEP, including Mr. Schroeder (the only NEO currently eligible to participate), have stopped earning service-based credits, but will continue to earn interest credits.
2025 PROXY STATEMENT 75
EXECUTIVE COMPENSATION
Under both the Cash Balance Plan and the PEP, a participant is eligible for benefits at normal retirement (the date a participant has both attained age 65 and completed five years of service) or early retirement (the date a participant has both attained age 55 and completed ten years of service), subject to reduced benefits for each year under age 65. For early retirement at or after age 55 with reduced benefits, there is a reduction of one-half percent per month applied to the full retirement benefit for every month under the age of 65.
Before the Cash Balance Plan was frozen for any additional service-based credits, the Cash Balance Plan, as supplemented by the PEP, was designed to provide an employee having 25 years of credited service with an annuity equal to 52% of “final average pay” less 50% of estimated individual Social Security benefits. “Final average pay” is defined as the highest five consecutive years of base salary during the ten years of employment preceding termination or retirement. The participant, if single, has one payment option: ten-year certain and life annuity. If married, the participant has two payment options: (i) ten-year certain and life annuity; or (ii) 50% joint and survivor annuity. The ten-year certain and life annuity offers a guaranteed minimum payment for ten years. The 50% joint and survivor annuity offers half the annuity payments to the surviving spouse.
The formula for calculating the amount payable to the participants in the Cash Balance Plan, in conjunction with the PEP, is illustrated as follows (ten-year certain and life annuity payment option):
[(0.52) x (Final Average Pay) – (0.50) x (Estimated Social Security Benefit)] x (Credited Service up to 25 years) ÷ (25)
The amount payable could be less if a married participant elected to receive benefits under the 50% joint and survivor annuity option. The reduction for the 50% joint and survivor annuity is determined using the actuarial basis defined by the pension plans and reflects the possibility that the spouse may outlive the participant, which extends the length of payments.
The following table shows, as of December 31, 2024, the present value of accumulated benefits under the Company’s Cash Balance Plan and PEP for each NEO eligible to participate in the plans.
| Name |
Plan Name | Number of Years Credited Service (#)(1) |
Present Value of Accumulated Benefit ($)(2) |
Payments During Last Fiscal Year ($) | ||||||||||||||||
| MARK S. SCHROEDER |
Cash Balance Plan | 1.5 | $ | 19,323 | $ | - | ||||||||||||||
| Pension Equalization Plan | 2.67 | $ | 131,701 | $ | - | |||||||||||||||
| (1) | The Company’s Cash Balance Plan had been offered to substantially all employees after a year of service and after reaching 21 years of age. Plan entry dates were January and July of each year. The PEP was amended January 1, 2004, to waive the one-year service requirement. Because of these differing service crediting provisions, there could be a difference of up to 1.5 years between Cash Balance Plan service and PEP service reflected in the column. Credited years of service equals actual years of service with the Company, subject to the crediting provisions above. |
| (2) | The calculation of present value of accumulated benefit is based on a normal retirement age of 65, as defined by each plan, and credited service and certain discount rate and mortality inputs. For the assumptions made in the valuations, see Note 16 to the Company’s audited financial statements included within the 2024 Annual Report. |
Deferred Compensation Plan
At the end of 2021, Labcorp froze both the Laboratory Corporation of America Holdings Deferred Compensation Plan and the Covance Deferred Compensation Plan and established the DCP, effective January 1, 2022. The DCP offers eligible participants another vehicle to accumulate savings for retirement. See “Compensation Discussion & Analysis – Deferred Compensation Plan” above. Amounts deferred by a participant are credited to a bookkeeping account maintained on behalf of each participant, which is used for the measurement and determination of amounts to be paid to a participant, or such participant’s designated beneficiary, pursuant to the terms of the DCP. Deferred amounts are the Company’s general unsecured obligations and are subject to claims by Labcorp’s creditors. The Company’s general assets or existing Rabbi Trust may be used to fund payment obligations and pay DCP benefits.
According to the terms of the DCP, a participant has the opportunity to allocate deferred amounts to one or more of 25 measurement funds offered. Amounts in these accounts can earn variable returns, including negative returns. Labcorp makes no matching contributions to the DCP.
Under the DCP, a participant may make separate distribution elections with respect to each year’s deferrals. These distribution elections include the ability to elect a single lump-sum payment or annual installment payments.
76 LABCORP HOLDINGS INC.
EXECUTIVE COMPENSATION
The following table summarizes the NEO’s contributions, earnings, and aggregate balance under the frozen and current DCPs as of December 31, 2024.
| Name |
Executive Last FY ($)(1) |
Registrant Last FY ($) |
Aggregate Last FY ($) |
Aggregate Withdrawals/ Distributions ($) |
Aggregate Balance at Last FYE ($) | ||||||||||||||||||||
| BRIAN J. CAVENEY |
$ | 99,000 | $ | - | $ | 251,089 | $ | - | $ | 1,316,388 | |||||||||||||||
| (1) | Amounts in this column are included in the “Salary” column of the Summary Compensation Table above. |
Potential Payments Upon Termination or Change in Control
The tables that follow provide information related to compensation payable to each NEO, assuming termination of such executive’s employment on December 31, 2024, or assuming a change in control with a corresponding qualifying termination occurred on December 31, 2024. Amounts also assume the price of Common Stock was $229.32, the closing price on December 31, 2024.
| Adam H. Schechter |
Voluntary Termination |
Early Retirement |
Normal Retirement |
Involuntary Not for Cause or Good Reason Termination |
For Cause Termination |
Change-in- Control(1) |
Disability(2) | Death | ||||||||||||||||||||||||
| Severance (Related to Base Compensation) |
$ | - | $ | - | $ | - | $ | 2,870,000 | $ | - | $ | 4,305,000 | $ | - | $ | - | ||||||||||||||||
| Severance (Related to Annual Incentive Cash Payments) |
$ | - | $ | - | $ | - | $ | 5,215,538 | $ | - | $ | 7,823,307 | $ | - | $ | - | ||||||||||||||||
| Stock Options |
$ | 175,075 | $ | 175,075 | $ | 175,075 | $ | 175,075 | $ | - | $ | 447,325 | $ | 447,325 | $ | 447,325 | ||||||||||||||||
| Restricted Stock Units |
$ | 2,500,977 | $ | 2,500,977 | $ | 2,500,977 | $ | 2,500,977 | $ | - | $ | 5,335,494 | $ | 5,335,494 | $ | 5,335,494 | ||||||||||||||||
| Performance Shares |
$ | 18,771,442 | $ | 18,771,442 | $ | 18,771,442 | $ | 18,771,442 | $ | - | $ | 22,506,255 | $ | 22,506,255 | $ | 22,506,255 | ||||||||||||||||
| Health & Welfare Benefits |
$ | - | $ | - | $ | - | $ | - | $ | - | $ | - | $ | 2,100,000 | $ | 1,500,000 | ||||||||||||||||
| TOTAL |
$ | 21,447,494 | $ | 21,447,494 | $ | 21,447,494 | $ | 29,533,032 | $ | - | $ | 40,417,381 | $ | 30,389,074 | $ | 29,789,074 | ||||||||||||||||
| Julia A. Wang |
Voluntary Termination |
Early Retirement |
Normal Retirement |
Involuntary Not for Cause or Good Reason Termination |
For Cause Termination |
Change-in- Control |
Disability(2) | Death | ||||||||||||||||||||||||
| Severance (Related to Base Compensation) |
$ | - | $ | - | $ | - | $ | 1,450,000 | $ | - | $ | 1,450,000 | $ | - | $ | - | ||||||||||||||||
| Severance (Related to Annual Incentive Cash Payments) |
$ | - | $ | - | $ | - | $ | 1,450,000 | $ | - | $ | 1,450,000 | $ | - | $ | - | ||||||||||||||||
| Stock Options |
$ | - | $ | - | $ | - | $ | - | $ | - | $ | - | $ | - | $ | - | ||||||||||||||||
| Restricted Stock Units |
$ | - | $ | - | $ | - | $ | - | $ | - | $ | 614,578 | $ | 614,578 | $ | 614,578 | ||||||||||||||||
| Performance Shares |
$ | - | $ | - | $ | - | $ | - | $ | - | $ | 1,846,026 | $ | 1,846,026 | $ | 1,846,026 | ||||||||||||||||
| Health & Welfare Benefits |
$ | - | $ | - | $ | - | $ | - | $ | - | $ | - | $ | 3,600,000 | $ | 1,450,000 | ||||||||||||||||
| TOTAL |
$ | - | $ | - | $ | - | $ | 2,900,000 | $ | - | $ | 5,360,604 | $ | 6,060,604 | $ | 3,910,604 | ||||||||||||||||
2025 PROXY STATEMENT 77
EXECUTIVE COMPENSATION
| Brian J. Caveney |
Voluntary Termination |
Early Retirement |
Normal Retirement |
Involuntary Not for Cause or Good Reason Termination |
For Cause Termination |
Change-in- Control |
Disability(2) | Death | ||||||||||||||||||||||||
| Severance (Related to Base Compensation) |
$ | - | $ | - | $ | - | $ | 1,340,000 | $ | - | $ | 1,340,000 | $ | - | $ | - | ||||||||||||||||
| Severance (Related to Annual Incentive Cash Payments) |
$ | - | $ | - | $ | - | $ | 1,524,259 | $ | - | $ | 1,524,259 | $ | - | $ | - | ||||||||||||||||
| Stock Options |
$ | - | $ | - | $ | - | $ | 37,678 | $ | - | $ | 89,972 | $ | 89,972 | $ | 89,972 | ||||||||||||||||
| Restricted Stock Units |
$ | - | $ | - | $ | - | $ | 415,309 | $ | - | $ | 873,923 | $ | 873,923 | $ | 873,923 | ||||||||||||||||
| Performance Shares |
$ | - | $ | - | $ | - | $ | 3,193,910 | $ | - | $ | 3,727,467 | $ | 3,727,467 | $ | 3,727,467 | ||||||||||||||||
| Health & Welfare Benefits |
$ | - | $ | - | $ | - | $ | 24,700 | $ | - | $ | 24,700 | $ | 4,525,000 | $ | 1,340,000 | ||||||||||||||||
| TOTAL |
$ | - | $ | - | $ | - | $ | 6,535,856 | $ | - | $ | 7,580,321 | $ | 9,216,362 | $ | 6,031,362 | ||||||||||||||||
| Anita Z. Graham |
Voluntary Termination |
Early Retirement |
Normal Retirement |
Involuntary Not for Cause or Good Reason Termination |
For Cause Termination |
Change-in- Control |
Disability(2) | Death | ||||||||||||||||||||||||
| Severance (Related to Base Compensation) |
$ | - | $ | - | $ | - | $ | 1,154,000 | $ | - | $ | 1,154,000 | $ | - | $ | - | ||||||||||||||||
| Severance (Related to Annual Incentive Cash Payments) |
$ | - | $ | - | $ | - | $ | 810,662 | $ | - | $ | 810,662 | $ | - | $ | - | ||||||||||||||||
| Stock Options |
$ | - | $ | - | $ | - | $ | 28,805 | $ | - | $ | 64,669 | $ | 64,669 | $ | 64,669 | ||||||||||||||||
| Restricted Stock Units |
$ | - | $ | - | $ | - | $ | 162,148 | $ | - | $ | 399,990 | $ | 399,990 | $ | 399,990 | ||||||||||||||||
| Performance Shares |
$ | - | $ | - | $ | - | $ | 1,132,966 | $ | - | $ | 1,456,278 | $ | 1,456,278 | $ | 1,456,278 | ||||||||||||||||
| Health & Welfare Benefits |
$ | - | $ | - | $ | - | $ | 24,700 | $ | - | $ | 24,700 | $ | 3,775,000 | $ | 1,154,000 | ||||||||||||||||
| TOTAL |
$ | - | $ | - | $ | - | $ | 3,313,281 | $ | - | $ | 3,910,299 | $ | 5,695,937 | $ | 3,074,937 | ||||||||||||||||
| Mark S. Schroeder |
Voluntary Termination |
Early Retirement |
Normal Retirement |
Involuntary Not for Cause or Good Reason Termination |
For Cause Termination |
Change-in- Control |
Disability(2) | Death | ||||||||||||||||||||||||
| Severance (Related to Base Compensation) |
$ | - | $ | - | $ | - | $ | 1,340,000 | $ | - | $ | 1,340,000 | $ | - | $ | - | ||||||||||||||||
| Severance (Related to Annual Incentive Cash Payments) |
$ | - | $ | - | $ | - | $ | 1,473,157 | $ | - | $ | 1,473,157 | $ | - | $ | - | ||||||||||||||||
| Stock Options |
$ | 43,589 | $ | 43,589 | $ | 43,589 | $ | 43,589 | $ | - | $ | 103,428 | $ | 103,428 | $ | 103,428 | ||||||||||||||||
| Restricted Stock Units |
$ | 444,444 | $ | 444,444 | $ | 444,444 | $ | 444,444 | $ | - | $ | 949,608 | $ | 949,608 | $ | 949,608 | ||||||||||||||||
| Performance Shares |
$ | 3,386,978 | $ | 3,386,978 | $ | 3,386,978 | $ | 3,386,978 | $ | - | $ | 3,998,075 | $ | 3,998,075 | $ | 3,998,075 | ||||||||||||||||
| Health & Welfare Benefits |
$ | - | $ | - | $ | - | $ | 24,700 | $ | - | $ | 24,700 | $ | 750,000 | $ | 1,340,000 | ||||||||||||||||
| TOTAL |
$ | 3,875,011 | $ | 3,875,011 | $ | 3,875,011 | $ | 6,712,868 | $ | - | $ | 7,888,968 | $ | 5,801,111 | $ | 6,391,111 | ||||||||||||||||
78 LABCORP HOLDINGS INC.
EXECUTIVE COMPENSATION
| Glenn A. Eisenberg |
Voluntary Termination |
Early Retirement |
Normal Retirement |
Involuntary Not for Cause or Good Reason Termination |
For Cause Termination |
Change-in- Control |
Disability(2) | Death | ||||||||||||||||||||||||
| Severance (Related to Base Compensation) |
$ | - | $ | - | $ | - | $ | 1,684,000 | $ | - | $ | 1,684,000 | $ | - | $ | - | ||||||||||||||||
| Severance (Related to Annual Incentive Cash Payments) |
$ | - | $ | - | $ | - | $ | 2,052,920 | $ | 2,052,920 | $ | - | $ | - | ||||||||||||||||||
| Stock Options |
$ | 106,024 | $ | 106,024 | $ | 106,024 | $ | 106,024 | $ | - | $ | 106,024 | $ | 106,024 | $ | 106,024 | ||||||||||||||||
| Restricted Stock Units |
$ | 1,280,362 | $ | 1,280,362 | $ | 1,280,362 | $ | 1,280,362 | $ | - | $ | 1,280,362 | $ | 1,280,362 | $ | 1,280,362 | ||||||||||||||||
| Performance Shares |
$ | 7,712,987 | $ | 7,712,987 | $ | 7,712,987 | $ | 7,712,987 | $ | - | $ | 5,614,362 | $ | 5,614,362 | $ | 5,614,362 | ||||||||||||||||
| Health & Welfare Benefits |
$ | - | $ | - | $ | - | $ | 24,700 | $ | - | $ | 24,700 | $ | 900,000 | $ | 1,500,000 | ||||||||||||||||
| TOTAL |
$ | 9,099,373 | $ | 9,099,373 | $ | 9,099,373 | $ | 12,860,993 | $ | - | $ | 10,762,368 | $ | 7,900,748 | $ | 8,500,748 | ||||||||||||||||
| (1) | The amounts payable to Mr. Schechter in the event of a change-in-control may be subject to reduction, including for the excise tax imposed on “excess parachute payments” under Sections 280G and 4999 of the Internal Revenue Code. |
| (2) | Reflects the expected total of the executive’s disability income benefits as of December 31, 2024 payable over time determined by assuming full disability at December 31, 2024 and continuing until the NEOs’ normal retirement age in effect under the Social Security Act as of the effective date of the Disability Plan. |
Equity Awards: Stock Incentive Plan
The restricted stock unit, non-qualified stock option, and performance share awards shown in the table above, “Potential Payments Upon Termination or Change in Control”, include Mr. Schechter’s Sign-On Grants, as further discussed below. The treatment of each of the equity awards varies depending on the type of termination.
The form of award agreement for the non-qualified stock options and restricted stock units provides that if the executive has a Separation of Service by reason of death, disability, or for “good reason” or without “cause” within 24 months of a “change of control,” each as defined in the applicable agreements, then all of the restricted stock unit and non-qualified stock option awards will accelerate in full as of the date of termination. If, unrelated to a change of control, the executive receives a notice of an involuntary Separation of Service without cause or incurs a voluntary Separation of Service for good reason, on or after 6 months following the grant date, then all restricted stock units and non-qualified stock options that were scheduled to vest within 12 months immediately following the Separation of Service will vest in full on the date of Separation of Service.
Additionally, in the event of a Separation of Service at a time when the executive has attained the age of 65 and completed five full years of service (“Retirement at Age 65 Plus 5”) and (i) the Separation of Service occurs on or after 6 months following the grant date, but before 9 months after the grant date, the restricted stock units and non-qualified stock options that were scheduled to vest within 12 months immediately following the Separation of Service will vest upon the date of the Separation of Service; or (ii) if the Separation of Service occurs on or after 9 months from the grant date, then all of the restricted stock unit and non-qualified stock option awards will vest in full as of the date of the Separation of Service. In the event of a Separation of Service on or after 6 months following the grant date at a time when the executive has attained the age of 55 and the sum of the executive’s age plus years of service equals or exceeds 70 (“Rule of 70 Retirement”), the restricted stock units and options that were scheduled to vest within 12 months immediately following the Separation of Service will vest upon the date of the Separation of Service. The executive (or the executive’s heir or executor/executrix, as the case may be) may exercise vested non-qualified stock options at any time within one year after the date of death, disability, Retirement at age 65 Plus 5, Rule of 70 Retirement, or a specified termination within 24 months of a change in control. (For other terminations, the executive may exercise vested options within 90 days of the executive’s termination.)
The non-qualified stock options and restricted stock units granted to Mr. Eisenberg have slightly different terms than those described above, in that if he has a Separation of Service at a time when he has attained age 61 and on or after 6 months following the grant date but before 9 months after the grant date, the restricted stock units and non-qualified stock options that were scheduled to vest within 12 months of his Separation of Service will vest, and if he has a Separation of Service at a time when he has attained age 61 and on or after nine months following the grant date, his awards will vest in full.
2025 PROXY STATEMENT 79
EXECUTIVE COMPENSATION
The forms of award agreement for the performance share awards provide that in the event that an executive’s Separation of Service occurs by reason of death or disability or an involuntary Separation of Service without cause or voluntary Separation of Service for good reason within 24 months of a change of control, then the performance share awards will accelerate at 100% of the target level on the date of the Separation of Service. In the event of a Retirement at Age 65 Plus 5, and (i) the Separation of Service occurs on or after 6 months following the grant date but before 9 months after the grant date, the performance shares will continue to be eligible to vest in a prorated number based on actual achievement of performance metrics as if the executive had not had a Separation of Service; or (ii) if the Separation of Service occurs on or after 9 months after the grant date for performance share awards granted in 2020 or later, then all of the performance shares will be eligible to vest in the number of shares set forth in the grant based on actual achievement of performance metrics as if the service had not terminated. In the event of a Rule of 70 Retirement on or after 6 months following the grant date, the performance shares will continue to vest in a prorated number based on actual achievement of performance metrics as if the service had not terminated. If the executive receives a notice of an involuntary Separation of Service without cause or incurs a voluntary Separation of Service for good reason, on or after 6 months following the grant date, then the performance shares will continue to vest in a prorated number based on actual achievement of performance metrics as if the service had not terminated.
The performance share awards granted to Mr. Eisenberg have slightly different terms than those described above, in that if he has a Separation of Service at a time when he has attained age 61 and on or after 6 months following the grant date but before 9 months after the grant date the performance shares will continue to be eligible to vest in a prorated number based on actual achievement of performance metrics as if Mr. Eisenberg had not had a Separation of Service and if he has a Separation of Service at a time when he has attained age 61 and on or after nine months following the grant date, his awards will continue to be eligible to vest based on the attainment of the specified performance metrics as if his service had not terminated.
For the purposes of the forms of award agreements, a Separation of Service generally has the meaning set forth in Section 409A of the Internal Revenue Code and occurs when the Company reasonably anticipates that an executive’s level of services will permanently decrease to 20% or less of the average level of services the executive has performed over the immediately preceding 36-month period.
Compensation and Annual Incentive Cash Payments
No additional base compensation amounts are payable for terminations resulting from the following events: voluntary termination by the officer without good reason, normal retirement, termination for cause, or termination due to disability or death. A prorated annual incentive cash payment may be made for each of the termination events mentioned in the tables above, except for a voluntary termination or a termination for cause. Provisions for base compensation and annual incentive cash payments in the event of an involuntary not for cause or good reason termination or a termination in connection with a change in control are detailed below.
Mr. Schechter’s Employment Agreement
In connection with his appointment as President and CEO of the Company, the Company entered into an employment agreement with Mr. Schechter, the term of which commenced on November 1, 2019. The terms of Mr. Schechter’s employment agreement were agreed to by the other independent members of the Board of Directors after negotiations between Mr. Schechter and the CHC Committee. In negotiating the agreement with Mr. Schechter, the CHC Committee considered a variety of factors, including the advice of FW Cook and market practice among the Company’s peers. The CHC Committee also considered what the Committee concluded was necessary to attract Mr. Schechter to the position in light of the other opportunities that he would likely have, and Mr. Schechter’s experience and profile as a seasoned executive. The CHC Committee concluded that these and other factors supported not only the terms of the agreement, but also for varying from its recent practice of not entering into employment agreements. In connection with the Company’s holding company reorganization that was implemented on May 17, 2024, Laboratory Corporation of America Holdings transferred and assigned all of its rights and obligations under Mr. Schechter’s employment agreement to the Company. The terms of Mr. Schechter’s employment agreement were unchanged.
Pursuant to his employment agreement, Mr. Schechter is entitled to the following compensation:
Annual Base Salary: Mr. Schechter’s initial annual base salary was $1,250,000. Mr. Schechter’s base salary is reviewed annually for increase by the CHC Committee of the Board.
Annual Cash Incentive Pay: Mr. Schechter is eligible to receive an annual bonus pursuant to the Company’s cash incentive plan with an annual target of 150% of his base salary, with achievement to be based on specific performance objectives determined by the CHC Committee.
Sign-On Equity Grants: On November 1, 2019, in connection with his appointment and pursuant to his employment agreement, Mr. Schechter received the following one-time grants (collectively, the “Sign-On Grants”), each of which vested in equal installments on each of the first through third anniversaries of November 1, 2019: non-qualified stock options with an aggregate grant date fair
80 LABCORP HOLDINGS INC.
EXECUTIVE COMPENSATION
value of $1,000,000; restricted stock units with an aggregate grant date fair value of $1,000,000; and premium priced non-qualified stock options with an exercise price equivalent to 115% of the fair market value of a share of Labcorp common stock on November 1, 2019, and with an aggregate grant date fair value of $2,000,000.
In addition to a fair and competitive annual total compensation package (i.e., base salary, target LBP opportunity, annual LTI award), the Committee felt it important to offer the Sign-On Grants outlined above to help induce Mr. Schechter’s employment at Labcorp given the demand for an executive with his profile and experience, especially given the competitive labor market for executive talent in our industry. In determining the size and form of the Sign-On Grants, the CHC Committee strongly believed the award should be aligned with the long-term interests of shareholders. As such, 75% of the Sign-On Grants were delivered in the form of non-qualified stock options. Further, to emphasize the importance of growing the stock price above and beyond the stock price on the date of grant, 50% of the Sign-On Grants were delivered via premium priced non-qualified stock options, requiring the price of Labcorp stock, once vested, to be at least 15% higher than the grant date stock price in order to be exercisable.
The equity and non-equity incentives for Mr. Schechter are subject to the Company’s Incentive Compensation Recoupment Policy, and Mr. Schechter is subject to the stock ownership guidelines of the Company’s executive stock ownership program. For more information on this Policy, see the section “Equity Grant Practices; Clawback Requirement” on page 65 and on the executive stock ownership program, see the section “Stock Ownership Guidelines” on page 65.
2020 Equity Awards: Under his employment agreement, Mr. Schechter was entitled to receive equity awards having a grant date fair value of not less than $9,400,000 in 2020 at the same time as, and with the terms and conditions that apply to, the other NEOs. On February 4, 2020, the CHC Committee approved an award of $9,400,000 pursuant to this contractual obligation, which vested in three equal annual installments beginning with the first vesting on February 4, 2021. In addition to the more general factors discussed above, the CHC Committee concluded that the size and amount of the 2020 grants was appropriate and competitive relative to peer group practice (i.e., slightly above the then market median). Further, when the 2020 equity award was combined with the approved base salary and target annual cash opportunity, the target total compensation package was also competitive relative to peers (i.e., slightly above median).
Benefits and Perquisites: Mr. Schechter is entitled to participate in all employee benefit plans, practices, and programs that are generally made available to senior executives of the Company. Mr. Schechter is also entitled to financial planning and wellness perquisites and other fringe benefits and perquisites available to executives generally, as well as security-related perquisites, including use of a car and driver for commuting and business use and use of a private aircraft for nonbusiness purposes in an amount not exceeding $150,000 per calendar year. In addition, pursuant to his employment agreement, the Company agreed to pay up to $400,000 in incremental costs for flights for Mr. Schechter to commute between the vicinity of his residence and his primary place of employment in Burlington, North Carolina. In November 2024, the Company and Mr. Schechter entered into an aircraft time sharing agreement, whereby, among other things, Mr. Schechter must reimburse the Company for amounts in excess of his $150,000 personal allowance and his $400,000 commuting allowance. See the above “Perquisites” section on page 71 for additional information regarding security-related changes made to Mr. Schechter’s corporate aircraft travel allowances, effective as of February 2025.
For additional information on Mr. Schechter’s termination and change-in-control benefits under the employment agreement, see the section “Potential Payments Upon Termination or Change in Control” on page 77.
Other Compensation Arrangements
In connection with Ms. Wang’s joining the Company in December 2024, the CHC Committee approved the initial employment arrangements for Ms. Wang, as also described in the Compensation Discussion and Analysis above. In setting Ms. Wang’s compensation, the CHC Committee considered the recommendations of FW Cook and its assessment of peer group information, as well as the CHC Committee’s stated practice of targeting compensation for its NEOs in line with the median of the peer group, while retaining the flexibility to adjust individual compensation to take into account variations in the individual’s job experience, responsibility and performance. In evaluating the role of Ms. Wang and peer compensation data, the CHC Committee concluded the following arrangements were appropriate. These arrangements included establishing her base salary, an LTI award, and in recognition of her foregoing compensation opportunities from her previous employer and to attract her to the Company, the award of a $400,000 sign on bonus, with $200,000 payable within 30 days of her start date and the remaining $200,000 payable on the one-year anniversary of her start date, or December 2, 2025. If Ms. Wang terminates her employment with the Company or she is terminated for Cause, as defined in the Severance Plan, by the Company prior to December 2, 2025, she will be ineligible to receive the latter portion of her sign-on bonus. The initial LTI equity award grant value for Ms. Wang of $3,200,000 was comprised of 20% restricted stock units, 20% non-qualified stock options, and 60% performance share awards, subject to the terms and conditions set forth in the applicable grant award agreement, which reflects the structure of LTI grants provided to the other NEOs for 2024 in order to ensure that all of our NEOs have the same incentives under their LTI arrangements. The performance share award will cliff vest in March 2027 at the end of the three-year performance period if performance goals are met. The restricted stock units and non-qualified stock options vest ratably over three years beginning with the first vesting on February 6, 2025. For additional information regarding compensation received by Ms. Wang in 2024, see the tables above.
2025 PROXY STATEMENT 81
EXECUTIVE COMPENSATION
Amended and Restated Master Senior Executive Severance Plan
The Severance Plan provides the Company’s NEOs (other than Mr. Schechter), as well as the Company’s other executive vice presidents (“EVPs”), with severance payments upon, respectively, a “qualifying termination”. A “qualifying termination” is generally defined as an involuntary termination without cause or voluntary termination with “good reason.” “Cause” means that the executive shall have committed prior to termination of employment any of the following acts: an intentional act of fraud, embezzlement, theft, or any other material violation of law in connection with such executive’s duties or in the course of the executive’s employment with the Company; the conviction of or entering of a plea of nolo contendere to a felony; alcohol intoxication on the job or current illegal drug use; intentional wrongful damage to tangible assets of the Company; intentional wrongful disclosure of material confidential information of the Company and/or materially breaching the noncompetition or confidentiality provisions covering the executive’s activities; knowing and intentional breach of any employment policy of the Company; or gross neglect or misconduct, disloyalty, dishonesty, or breach of trust in the performance of the executive’s duties that is not corrected to the Board’s satisfaction within 30 days of notice thereof. “Good reason” means, without consent of the executive, a reduction in base salary or targeted incentive cash payment as a percentage of salary, relocation to an office location more than 75 miles from the employee’s current office, or a material reduction in job responsibilities or transfer to another job.
For purposes of a change in control, “change in control” is defined in the Company’s Amended and Restated 2016 Omnibus Incentive Plan.
The severance payments for the Company’s NEOs (other than Mr. Schechter), as well as the Company’s other EVPs under the Severance Plan in the event of a qualifying termination, are equal to two times the sum of the annual salary and the three-year average LBP payments of the EVP. For purposes of the severance calculation, annual salary is the greatest of (i) the EVP’s annual salary as of the qualifying termination; (ii) the EVP’s annual salary as of the date the executive gives a valid notice of “good reason”; and (iii) if the qualifying termination occurs within 36 months of a change in control, the EVP’s annual salary rate as of the change in control. Such cash payments, if contemplated by any new employment agreement, any new severance, separation, or change of control agreement or similar arrangement, and any new severance plans or policies with or applicable to any of our executive officers entered into or adopted after February 6, 2024, shall not exceed 2.99 times the sum of the executive officer’s base salary and annual target bonus without the approval of our shareholders. See the section “Cash Severance Payments to Executive Officers” on page 67 for more information.
The Severance Plan does not provide a reimbursement to participants for excise taxes on “excess parachute payments” imposed by Section 4999 of the Internal Revenue Code.
Mr. Schechter’s Severance Arrangements
Pursuant to his employment agreement, in the event that Mr. Schechter’s employment is terminated for any reason, including by the Company for Cause or by Mr. Schechter without Good Reason, Mr. Schechter will be entitled to (i) his base salary and accrued unused vacation due through the termination date; and (ii) the sum of any (w) deferred compensation, (x) amounts or benefits owed under the then applicable benefit plans of the Company, (y) any amounts owed for the reimbursement of expenses properly incurred, and (z) any other benefits or amounts owed under the terms of any plan, program or arrangement of the Company, in each case of (w)-(z) owed as of the termination date (collectively (i) and (ii), the “Accrued Benefits”).
In the event that Mr. Schechter’s employment is terminated by reason of death or disability, Mr. Schechter will, in addition to the Accrued Benefits, be entitled to payment of any earned but unpaid incentive bonus for a prior completed performance period and any Partial Year Bonus (collectively with the Accrued Benefits, the “Accrued Amounts”).
In the event that Mr. Schechter’s employment is terminated by the Company without Cause or by Mr. Schechter with Good Reason, Mr. Schechter will, in addition to the Accrued Amounts, be entitled to severance benefits, subject to the execution of a severance agreement, that include: (i) an amount equal to the product of two (or three if the termination occurs within 36 months following a Change in Control, as such term is defined in the Labcorp Holdings Inc. Amended and Restated 2016 Omnibus Incentive Plan), multiplied by the sum of (x) Mr. Schechter’s base salary plus (y) the amount equal to the average of his last three incentive bonuses (or, if less than three, the average of the number of incentive bonuses received), 50% of which shall be paid within 30 days following the execution of a severance agreement and 50% paid within 30 days of the one-year anniversary of the execution of a severance agreement; (ii) reimbursement for COBRA continuation coverage for up to 18 months following the termination date; and (iii) vesting of any unvested portion of the Sign-On Grants.
Mr. Schechter’s rights with respect to equity or equity-related awards shall be governed by the applicable terms of the related plan or award agreements.
82 LABCORP HOLDINGS INC.
EXECUTIVE COMPENSATION
For the purpose of Mr. Schechter’s employment agreement, the following definitions apply:
“Cause” means
| • | an intentional act of fraud, embezzlement, theft, or any other material violation of law in connection with Mr. Schechter’s duties or in the course of his employment with the Company; |
| • | conviction of or entering of a plea of nolo contendere to a felony; |
| • | alcohol intoxication on the job or current illegal drug use; |
| • | intentional wrongful damage to tangible assets of the Company; |
| • | intentional wrongful disclosure of material confidential information of the Company and/or material breach of the provisions of the Company’s Confidentiality/ Non-Competition/ |
| Non-Solicitation Agreement or any other noncompetition or confidentiality provisions covering the activities of Mr. Schechter; |
| • | knowing and intentional breach of any employment policy of the Company; |
| • | gross neglect or gross misconduct, disloyalty, dishonesty, or breach of trust in the performance of Mr. Schechter’s duties that is not corrected to the Board’s satisfaction within 30 days of receiving notice thereof; or |
| • | misconduct that causes reputational harm to the Company. |
“Good Reason” means:
| • | a material reduction in base salary or any reduction of the target bonus amount; |
| • | relocation to an office location more than 75 miles from either Mr. Schechter’s principal office location or his principal residence as of the date of notice of relocation; |
| • | the Board shall fail to appoint Mr. Schechter as Chairman of the Board on the earlier of the date on which the Board Chairman on the date hereof ceases to be the Chairman or December 31, 2020; |
| • | the Board shall fail to re-nominate Mr. Schechter for re-election to the Board; or |
| • | a material diminution in title, duties, or responsibilities, including reporting responsibilities, of Mr. Schechter’s in his capacity as an employee. |
“Partial Year Bonus” means the amount payable to Mr. Schechter for the year of his termination in the event the Company performance criteria for payment of an incentive bonus are achieved as of the close of the year based on the actual performance level achieved for such year; provided, however, that if a qualifying termination occurs after a Change in Control, the performance criteria shall be deemed satisfied at the target level, and prorated to reflect the number of days of employment in such year.
Health and Welfare Benefits
In the event of a qualifying termination under the Severance Plan, the executive is also eligible for a Medical Stipend payment annually determined by the Company. For 2024, the stipend was $21,700. Executives are also provided with reimbursement for outplacement services up to $3,000.
In the event an executive dies while an active employee, the executive’s beneficiary will receive two times such executive’s base annual earnings up to a maximum of $1,500,000 from the Company’s group term life plan. In addition, eligible, enrolled dependents will receive Company-paid COBRA continuation of coverage for the first six months following the executive’s death (not included in the tables above). If the executive was traveling on Company business at the time of death, the beneficiary will also receive $1,000,000 of business travel accident insurance; this is not reflected in the tables above.
If an executive becomes disabled (i.e., such executive is not able to perform the material duties of executive’s occupation solely because of disease or injury), the executive is generally eligible for a monthly benefit payable until the earlier of (a) the later of the NEOs’ normal retirement age in effect under the Social Security Act as of the effective date of the Disability Plan or age 65 if the period of disability starts at the age of 60 or under; or (b) if the period of disability starts at age 61 or older, the length of the maximum benefit period for disability as defined by the Disability Plan. For Mr. Schechter, the monthly net benefit is a maximum of $30,000, and for the other NEOs the monthly net benefit is a maximum of $25,000.
Cash Balance Plan
Under the Cash Balance Plan, upon a termination of employment the NEOs are entitled to receive the same amounts set forth for each officer in the Present Value of Accumulated Benefit column in the Pension Benefits Table above, regardless of reason, except for death, which pays at 50% of such value.
2025 PROXY STATEMENT 83
EXECUTIVE COMPENSATION
Pension Equalization Plan
PEP payments are subject to Section 409A of the Internal Revenue Code and require a six-month waiting period following separation of service before distribution of the first payment. Under the PEP, upon a termination the NEOs are entitled to receive the same amounts set forth for each officer in the Present Value of Accumulated Benefit column in the Pension Benefits Table above, regardless of reason, except for death, which pays at 50% of such value.
Deferred Compensation Plan
The DCP was amended to grandfather participants prior to December 31, 2004 to remove the six-month waiting period for distributions following separation of service. Distribution elections made after December 31, 2004 require a six-month waiting period following separation of service before distribution of the first payment, as required by Section 409A of the Internal Revenue Code. Otherwise, distribution elections include the ability to elect a single lump-sum payment or annual installment payments. Under the DCP, upon termination the NEOs are entitled to receive the same amounts set forth for each officer in the Aggregate Balance column of the Nonqualified Deferred Compensation Table above, regardless of reason for the termination.
Perquisites
Pursuant to the Severance Plan, all perquisites offered to participating NEOs immediately terminate upon the executive’s termination for executives participating in these plans.
Equity Compensation Plan Information
The following table summarizes the Company’s equity compensation plan information as of December 31, 2024. All equity compensation plans have been approved by Company shareholders.
| Plan Category |
Common Shares to be Issued Upon Exercise of Outstanding Options, Warrants, and Rights A(1) |
Weighted- Average Exercise Price of Outstanding Options, Warrants, and Rights B(2) |
Common Shares Available for Future Issuance Under Equity Plans Securities Reflected in Column A) C | ||||||||||||
| Equity compensation plans approved by Company shareholders |
630,717 | $ | 180.29 | 9,191,924 | (3) | ||||||||||
| Equity compensation plans not approved by Company shareholders |
- | - | - | ||||||||||||
| (1) | Amounts in this column exclude purchase rights under the Labcorp Holdings Inc. Amended and Restated 2016 Employee Stock Purchase Plan. |
| (2) | Represents the weighted-average exercise price of the outstanding non-qualified stock options and does not include restricted stock units or performance shares. |
| (3) | Includes 9,035,186 shares available for future issuance under the Labcorp Holdings Inc. Amended and Restated 2016 Omnibus Incentive Plan and 156,738 shares available for future issuance under the Labcorp Holdings Inc. Amended and Restated 2016 Employee Stock Purchase Plan. |
As required by the Dodd-Frank Wall Street Reform and Consumer Protection Act, the Company is presenting the ratio of our CEO’s annual total compensation to our median employee’s annual total compensation.
84 LABCORP HOLDINGS INC.
EXECUTIVE COMPENSATION
For purposes of identifying our median employee, we used year-to-date taxable income as of November 1, 2024 (the “Determination Date”) to calculate a reasonable estimate of the annual total compensation for each employee based on our internal records. The employees we used for the foregoing calculations included all our full-time, part-time, seasonal, and temporary employees as of the Determination Date, other than our CEO. We annualized year-to-date earnings for employees who were hired in 2024 prior to the Determination Date, except for those designated as seasonal or temporary. Our analysis included over 68,849 employees located in 17 countries. As permitted by SEC rules, we excluded from our employee population our contractors and leased employees. Once we identified the median employee, we calculated that employee’s total annual compensation in accordance with the applicable SEC rules and determined that it included characteristics that we viewed as anomalous. As we have a large number of employees closely arrayed in compensation, we substituted another employee who had substantially similar year-to-date income and who is more representative of our workforce as permitted under SEC guidance.
We calculated total annual compensation for the median employee and the CEO using the same methodology we use for our NEOs as set forth in the Summary Compensation Table. In addition to the compensation elements reported, we added the value of employer provided health and welfare benefits to both the CEO and the median employee compensation, as such benefits represent a significant component of our employees’ total compensation. Using this methodology, the 2024 annual total compensation for our CEO was $19,340,547. The 2024 annual total compensation for our median employee was $57,316. The ratio of our CEO’s annual total compensation to our median employee’s total compensation for fiscal year 2024 is 337 to 1. This ratio was determined using reasonable estimates as permitted by the SEC’s rules and should not be used as a comparison with pay ratios disclosed by other companies.
2025 PROXY STATEMENT 85
Year (1) |
SCT Total Pay for CEO (2) |
CAP to CEO (3) |
Average SCT Total Pay for Other NEOs (2) |
Avg. CAP to Other NEOs (3) |
Value of Initial $100 Investment Based On: (4) |
Net Income ($ Millions) (5) |
Adjusted Operating Income ($ Millions) (6) | |||||||||||||
Company TSR |
Peer Group TSR | |||||||||||||||||||
2024 |
$ | $ | $ |
$ |
$ |
$ |
$ |
$ | ||||||||||||
2023 |
$ | $ | $ |
$ |
$ |
$ |
$ |
$ | ||||||||||||
2022 |
$ | $ | ( |
) | $ |
$ |
$ |
$ |
$ |
$ | ||||||||||
2021 |
$ | $ | $ |
$ |
$ |
$ |
$ |
$ | ||||||||||||
2020 |
$ | $ | $ |
$ |
$ |
$ |
$ |
$ | ||||||||||||
| (1) | For each year shown, the CEO was |
• |
2024: Glenn Eisenberg, Brian Caveney, Anita Graham, Mark Schroeder, and Julia Wang |
• |
2023: Glenn Eisenberg, Brian Caveney, Anita Graham, Mark Schroeder, Paul Kirchgraber, and Thomas Pike |
• |
2020-2022: Glenn Eisenberg, Brian Caveney, Mark Schroeder, and Paul Kirchgraber |
| (2) | These amounts reflect (i) the total compensation reported in the SCT for the applicable year in the case of our CEO; and (ii) the average of the total compensation reported in the SCT for the applicable year for our Other NEOs. See the footnotes to the SCT for further detail regarding the amounts in this column for 2024, 2023, 2022, 2021, and 2020. |
| (3) | Amounts reported in these columns represent CAP; adjustments were made to the amounts reported in the SCT for the applicable year. A reconciliation of the adjustments for our CEO and for the average of the Other NEOs is set forth in the following tables, which describe the adjustments, each of which is prescribed by SEC rules to calculate the CAP amounts from SCT amounts. The fair value of options was determined by using the Black-Scholes option pricing method. The fair value of the performance share awards was determined by using a Monte Carlo simulation pricing model and the probable outcome of the performance vesting conditions as of each measurement date and Company actual performance payouts for each completed performance period for the respective fiscal year. The fair value of the restricted stock was determined using the stock price on the appropriate measurement date. |
| (4) |
| (5) | “Net income” is equivalent to “Net earnings” as reported in the Company’s financial statements. |
| (6) | non-GAAP measure. See reconciliation of adjusted operating income and operating income on page 115 of this Proxy Statement. This performance measure may not have been the most important financial performance measure for years 2023, 2022, 2021 and 2020 and we may determine a different financial performance measure to be the most important financial performance measure in future years. |
Year |
SCT Total for CEO |
Minus Stock Award Value & Option Award Value Reported in SCT for the Covered Year |
Plus Year End Fair Value of Equity Awards Granted During the Covered Year that Remain Outstanding and Unvested as of Last Day of the Covered Year |
Plus Year over Year Change in Fair Value as of the Last Day of the Covered Year of Outstanding and Unvested Equity Awards Granted in Prior Years |
Plus Year over Year Change in Fair Value as of the Vesting Date of Equity Awards Granted in Prior Years that Vested During the Covered Year |
Minus Fair Value at the End of the Prior Year of Equity Awards that Failed to Meet Vesting Conditions in the Covered Year |
Plus Value of Dividends or Other Earnings Paid on Stock or Option Awards Not Otherwise Reflected in Fair Value or Total Compensation for the Covered Year |
Minus Change in Pension Value Reported in SCT for Covered Year |
Plus Pension Adjustment |
CEO CAP | ||||||||||||||||||||||||||||||||||||||||
2024 |
$ | $ | $ | $ | ( |
) | $ | ( |
) | - | $ | - | - | $ | ||||||||||||||||||||||||||||||||||||
2023 |
$ | $ | $ | $ | $ | ( |
) | - | $ | - | - | $ | ||||||||||||||||||||||||||||||||||||||
2022 |
$ | $ | $ | $ | ( |
) | $ | ( |
) | - | $ | - | - | $ | ( |
) | ||||||||||||||||||||||||||||||||||
2021 |
$ | $ | $ | $ | $ | - | - | - | - | $ | ||||||||||||||||||||||||||||||||||||||||
2020 |
$ | $ | $ | $ | $ | - | - | - | - | $ | ||||||||||||||||||||||||||||||||||||||||
Year |
SCT Average for Other NEOs |
Minus Stock Award Value & Option Award Value Reported in SCT for the Covered Year |
Plus Year End Fair Value of Equity Awards Granted During the Covered Year that Remain Outstanding and Unvested as of Last Day of the Covered Year |
Plus Year over Year Change in Fair Value as of the Last Day of the Covered Year of Outstanding and Unvested Equity Awards Granted in Prior Years |
Plus Fair Value as of Vesting Date of Equity Awards Granted and Vested During the Covered Year |
Plus Year over Year Change in Fair Value as of the Vesting Date of Equity Awards Granted in Prior Years that Vested During the Covered Year |
Minus Fair Value at the End of the Prior Year of Equity Awards that Failed to Meet Vesting Conditions in the Covered Year |
Plus Value of Dividends or Other Earnings Paid on Stock or Option Awards Not Otherwise Reflected in Fair Value or Total Compensation for the Covered Year |
Minus Change in Pension Value Reported in SCT for Covered Year |
Plus Pension Adjustment |
Average Other NEO CAP | ||||||||||||||||||||||||||||||||||||||||||||
2024 |
$ | $ | $ | $ | ( |
) | - | $ | ( |
) | - | $ | $ | - | $ | ||||||||||||||||||||||||||||||||||||||||
2023 |
$ | $ | $ | $ | $ | $ | ( |
) | $ | $ | $ | - | $ | ||||||||||||||||||||||||||||||||||||||||||
2022 |
$ | $ | $ | $ | ( |
) | - | $ | ( |
) | - | $ | - | - | $ | ||||||||||||||||||||||||||||||||||||||||
2021 |
$ | $ | $ | $ | - | $ | - | - | - | - | $ | ||||||||||||||||||||||||||||||||||||||||||||
2020 |
$ | $ | $ | $ | - | $ | - | - | $ | - | $ | ||||||||||||||||||||||||||||||||||||||||||||
Measure |
||



|
|
||||
ADVISORY VOTE TO APPROVE EXECUTIVE COMPENSATION
|
PROPOSAL TWO
|
The Board unanimously recommends that shareholders vote “FOR” the approval of the compensation of our named executive officers.
| |||
| Advisory Vote to Approve Executive | ||||
| Compensation | ||||
As required by the Dodd-Frank Wall Street Reform and Consumer Protection Act (Section 14A of the Securities Exchange Act), the Company is seeking shareholder approval, through a non-binding advisory vote, of the compensation of the Company’s named executive officers as disclosed in this Proxy Statement. Pursuant to the vote of the shareholders at the 2024 Annual Meeting of Shareholders, the Company seeks shareholder approval of the Company’s executive compensation (a “say-on-pay” vote) on an annual basis.
The CHC Committee works throughout the year reviewing compensation trends, evaluating emerging best practices, engaging with shareholders, and considering changes to executive compensation that will provide our senior management with an incentive to achieve superior financial results for the Company and align pay with performance.
Compensation Program Overview and Evolution
Labcorp’s executive compensation program, as discussed in the “Compensation Discussion and Analysis” section on page 50 is designed to attract, motivate, and retain executives in a highly competitive environment. Our executive compensation philosophy is to pay for performance by rewarding the achievement of specific short-term and long-term financial, operational, and strategic goals. We believe our executive compensation program avoids unnecessary risk taking and aligns the interests of our shareholders with the performance of our executives. This program reflects our strong commitment to a results-driven compensation program.
Last year, our annual advisory vote on the compensation of our named executive officers received support from approximately 92% of the shares represented at the 2024 Annual Meeting of Shareholders and entitled to vote. We consider this level of approval to indicate the support of the vast majority of our shareholders. We remain committed to a compensation program that incentivizes our leaders and aligns with our strategy, the key value drivers of our business and the expectations of our shareholders. We have a practice of regularly seeking input from our shareholders, and this input is incorporated in the CHC Committee’s annual review of our executive compensation program. We continue to evolve our programs based on input from shareholders and external competitive practices.
Pay for Performance
As described in the “Compensation Discussion and Analysis” section beginning on page 50 of this Proxy Statement, our executive compensation program is designed to reward the achievement of specific short-term and long-term operational, financial and strategic goals. By paying for performance, we believe our compensation program aligns the interests of our executive officers with those of our shareholders. The Company believes that through an effective executive compensation program, it can be successful in attracting and retaining talented employees who will sustain the Company’s financial performance and continue creation of shareholder value.
90 LABCORP HOLDINGS INC.
ADVISORY VOTE TO APPROVE EXECUTIVE COMPENSATION
In support of the CHC Committee’s overarching pay for performance compensation philosophy, our executives’ compensation structure is:
| • | Focused on performance-based and variable compensation. Performance-based compensation comprises a significant part of total compensation, with the percentage of variable or at-risk compensation highest for our CEO; |
| • | Long-term performance oriented. Equity-based compensation comprises the largest part of total compensation and vests over a multi-year period to align the long-term interests of executive officers and shareholders; |
| • | Benchmarked to peers. Compensation opportunities for executive officers are evaluated against those offered by companies in similar industries and are similar in size and scope of operations; |
| • | Sensitive to performance variability. The size and the realizable values of incentive awards provided to executive officers varies significantly with performance achievements; and |
| • | Designed to recognize varying levels of responsibility. Differences in executive compensation within the Company reflect varying levels of responsibility and/or performance. |
In addition, certain features of the Company’s executive compensation program enhance the alignment of the interests of our executive officers and those of our shareholders, such as:
| • | Robust stock ownership guidelines (six times base salary for CEO and three times base salary for EVPs); |
| • | Prohibition on pledging and hedging Company common stock; |
| • | Fully performance-based annual cash incentive program; |
| • | Incentive plan goals directly linked to strategic and objective financial goals; |
| • | Cap on annual incentive opportunities; |
| • | No employment agreements except in connection with the hiring of our Chief Executive Officer; |
| • | Limited perquisites; |
| • | No tax gross-ups; |
| • | Cap cash severance payments to executive officers under arrangements at 2.99x the sum of the executive officer’s base salary and target annual incentive award; |
| • | “Double trigger” change-in-control accelerated vesting provisions; |
| • | Performance-oriented mix of long-term incentives with performance shares (60% of targeted grant value), non-qualified stock options (20% of targeted grant value) and restricted stock units (20% of targeted grant value) with multi-year vesting; |
| • | Dividend equivalent rights accrue on restricted stock units and performance shares but are only paid if and when the underlying shares vest; |
| • | Three-year performance measurement period for performance share awards; and |
| • | Robust Clawback Policy. |
Advisory Resolution
The Board recommends that shareholders vote in favor of the following resolution:
“RESOLVED, that the compensation of the Company’s Named Executive Officers, as disclosed pursuant to the rules of the Securities and Exchange Commission, including in the Compensation Discussion and Analysis, compensation tables and narrative discussion in the Company’s 2025 Proxy Statement, is hereby APPROVED.”
The vote is advisory and is not binding on the Board. However, the CHC Committee expects to take into account the outcome of the vote as it continues to consider the Company’s executive compensation program.
2025 PROXY STATEMENT 91
|
|
||||
VOTE TO APPROVE THE 2025 OMNIBUS INCENTIVE PLAN
Management Proposals
|
PROPOSAL THREE
|
The Board unanimously recommends that shareholders vote “FOR” the approval of the proposed 2025 Omnibus Incentive Plan | |||
| VoteApprove the 2025 Omnibus | ||||
| Incentive Plan | ||||
We are asking our shareholders to approve adoption of the proposed Labcorp Holdings Inc. 2025 Omnibus Incentive Plan (the “2025 Omnibus Incentive Plan”), which the Board approved on March 27, 2025. If the 2025 Omnibus Incentive Plan is approved by our shareholders, 3,050,000 shares of our common stock, par value $0.10 per share, will be available for awards under the 2025 Omnibus Incentive Plan.
The Board believes that approval of the 2025 Omnibus Incentive Plan is in the best interest of the Company and its shareholders. The Board has adopted and recommends that the shareholders adopt and approve the 2025 Omnibus Incentive Plan. Some of the key features of the 2025 Omnibus Incentive Plan that reflect the Company’s commitment to effective management of incentive compensation are as follows:
| • | Plan Limits. Total awards under the 2025 Omnibus Incentive Plan are limited to 3,050,000 shares of Common Stock, reduced by the number of shares of Common Stock underlying grants made under the 2016 Omnibus Incentive Plan (as defined below), after February 28, 2025 and before the effective date of the plan, and subject to further adjustment as described below. If the 2025 Omnibus Incentive Plan is approved by our shareholders, shares of Common Stock remaining authorized and available for future issuance under the 2016 Omnibus Incentive Plan will no longer be available for issuance. |
| • | Counting of Awards. Under the 2025 Omnibus Incentive Plan, the authorized shares of Common Stock reserved would be reduced by one share of Common Stock for every one share subject to any award type granted. |
| • | If any shares of Common Stock subject to an award under the 2025 Omnibus Incentive Plan or under the 2016 Omnibus Incentive Plan are not purchased or are forfeited or expire or otherwise terminate without delivery of shares of Common Stock, then the number of shares of Common Stock subject that award will again be available for making awards under the 2025 Omnibus Incentive Plan. |
| • | Minimum Vesting Periods. Stock options and stock appreciation rights require a performance period of at least twelve months or one-year minimum vesting period. |
| • | No Repricing. Repricing of stock options and stock appreciation rights (including reduction in the exercise price of stock options or replacement of an award with cash or another award type) is prohibited without prior shareholder approval. |
| • | Exercise Price. The exercise price of stock options and stock appreciation rights may not be less than 100% of fair market value on the date of grant, except for stock options and stock appreciation rights assumed in connection with the acquisition of another company. |
| • | Limitation on Non-Employee Director Awards. The 2025 Omnibus Incentive Plan contains an annual limit on the total equity and cash compensation that can be paid or granted to any non-employee director in a single fiscal year. |
| • | Prohibition on Liberal Recycling for Appreciation Awards. Shares of Common Stock tendered by a participant or withheld by the Company to satisfy any tax withholding obligation with respect to any option or stock appreciation right or to pay an exercise price with respect to any option or stock appreciation right do not become available for issuance as future awards under the 2025 Omnibus Incentive Plan. |
| • | Forfeiture/Clawback. The Company has a Recoupment Policy (as defined below) that covers officers (as defined by Rule 16a-1(f) promulgated under the Exchange Act) of the Company, and applies to cash and equity awards granted to such officers. The Recoupment Policy, as may be amended from time to time, is described in more detail on page 65 of this Proxy Statement. |
92 LABCORP HOLDINGS INC.
VOTE TO APPROVE THE 2025 OMNIBUS INCENTIVE PLAN
| • | Dividends and Dividend Equivalent Units. Dividends and dividend equivalents are subject to restrictions and risk of forfeiture to the same extent as the underlying award with respect to which such dividends or dividend equivalents are accrued and will not be paid unless and until such award has vested. |
| • | No Evergreen Provision. The 2025 Omnibus Incentive Plan does not include an evergreen provision, which would automatically add shares to the share authorization each year. |
| • | Transfer Restrictions. The 2025 Omnibus Incentive Plan contains robust transfer restrictions. |
| • | Limitation on Amendments. No material amendments to the 2025 Omnibus Incentive Plan can be made without shareholder approval if any such amendment would materially increase the number of shares reserved under the 2025 Omnibus Incentive Plan or that would diminish the prohibitions on repricing stock options or SARs. |
Upon the recommendation of the Compensation and Human Capital Committee, the Board approved the 2025 Omnibus Incentive Plan on March 27, 2025 subject to the receipt of shareholder approval at the Annual Meeting. The Board believes that approval of the 2025 Omnibus Incentive Plan is in the best interests of the Company and its shareholders.
The Board has proposed shareholder approval of the 2025 Omnibus Incentive Plan to replace the Company’s Amended and Restated 2016 Omnibus Incentive Plan (the “2016 Omnibus Incentive Plan”). Following shareholder approval of the 2025 Omnibus Incentive Plan, no additional awards will be made under the existing equity incentive plans.
No awards under the 2025 Omnibus Incentive Plan have been granted or will be granted unless and until the 2025 Omnibus Incentive Plan is approved by the Company’s shareholders at the Annual Meeting. Grants of awards under the 2025 Omnibus Incentive Plan will be in the discretion of the Compensation and Human Capital Committee and any other committee authorized to grant awards under the plan. Accordingly, it is not possible as of the date of this Proxy Statement to determine the nature or amount of any awards under the 2025 Omnibus Incentive Plan that may be subject to future grants to employees, officers, and directors of the Company and its subsidiaries and other affiliates, or to other persons who will be eligible to participate in the 2025 Omnibus Incentive Plan. If shareholders do not approve the 2025 Omnibus Incentive Plan, compensatory equity-based grants to employees, officers, or directors of the Company or an affiliate, or consultants, or advisers (who are natural persons), will continue to be made under the existing incentive plans to the extent that shares of Common Stock remain available for issuance under such plans, which for future grants totaled an estimated 1,916,000(1) shares as of February 28, 2025 (without giving effect to additional shares that may become available upon the future expiration, forfeiture, or cancellation of outstanding awards).
Potential Share Dilution as of February 28, 2025:
The following table sets forth certain information as of February 28, 2025, unless otherwise noted, with respect to the Company’s outstanding equity awards.
| Shares Available for Grant under the 2016 Plan |
1,916,000(1) | |
| Shares Requested for Approval under the 2025 Plan |
3,050,000(2) | |
| Shares Subject to Outstanding Stock Options / SARs |
696,000 | |
| Weighted-average Exercise Price of Outstanding Stock Options / SARs |
$187.20 | |
| Weighted-Average Remaining Term of Outstanding Stock Options / SARs |
5.9 | |
| Shares Subject to Outstanding Full-Value Stock Awards |
1,015,000(3) | |
| Total Outstanding Stock Options/SARs and Full-Value Stock Awards |
1,711,000 | |
| Shares of Common Stock Outstanding as of February 28, 2025 |
83,668,336 |
| (1) | Number of shares remaining in the 2016 Plan, assuming grant as full value shares. No additional awards will be granted under the 2016 Plan once the 2025 Plan is effective. |
| (2) | The proposed share reserve under the 2025 Plan will be reduced by any award granted under the 2016 Plan after February 28, 2025. |
| (3) | Performance awards for the 2022 grant are counted at the board approved payout rate and the 2023-2025 grants are counted at target. |
Summary of Material Provisions of 2025 Omnibus Incentive Plan
The following summary of the material provisions of the 2025 Omnibus Incentive Plan is qualified in its entirety by reference to the complete text of the 2025 Omnibus Incentive Plan, which is attached as Annex A to this Proxy Statement and incorporated by reference into this proposal. You are urged to read this proposal and the text of the 2025 Omnibus Incentive Plan in their entirety.
Unless the context requires otherwise, references to “the Company” in the following summary refer solely to the Company and not to subsidiaries of the Company.
2025 PROXY STATEMENT 93
VOTE TO APPROVE THE 2025 OMNIBUS INCENTIVE PLAN
Purpose.
The 2025 Omnibus Incentive Plan is intended to (1) provide participants in the 2025 Omnibus Incentive Plan with an incentive to contribute to the Company’s success and to manage the Company’s business in a manner that will provide for the Company’s long-term growth and profitability to benefit its shareholders and other important stakeholders and (2) provide a means of obtaining, rewarding, and retaining key personnel.
Eligible Participants.
Awards may be granted under the 2025 Omnibus Incentive Plan to individuals who are employees, officers or directors of the Company or an affiliate, or consultants, or advisers (who are natural persons) providing services to the Company or an affiliate. Any other individual whose participation in the 2025 Omnibus Incentive Plan is determined to be in the best interests of the Company may also be granted awards.
As of February 28, 2025, approximately 62,800 employees, approximately 12 Section 16 officers and approximately 9 non-employee Directors of the Company or any of its subsidiaries or other affiliates would have been eligible to participate.
Effective Date.
The 2025 Omnibus Incentive Plan will be effective on May 15, 2025 if our shareholders approve the plan at the Annual Meeting. If our shareholders approve the 2025 Omnibus Incentive Plan, no awards will be made under any of the Company’s existing equity incentive plans (other than the 2025 Omnibus Incentive Plan), including the 2016 Omnibus Incentive Plan.
Term.
The 2025 Omnibus Incentive Plan will terminate automatically the day before the tenth anniversary of its effective date, unless it is earlier terminated by the Board.
Administration.
The 2025 Omnibus Incentive Plan generally will be administered by a committee, which we refer to as the “Committee,” consisting of two or more directors of the Company. Each such director will be required to qualify as an “independent director” under the New York Stock Exchange listing rules and a “non-employee director” within the meaning of Rule 16b-3 under the Exchange Act. The Committee initially will be the Compensation and Human Capital Committee and may be a subcommittee of the Compensation Committee that satisfies the foregoing requirements.
The Board also will be authorized to appoint one or more committees of the Board consisting of one or more directors of the Company who need not be non-employee directors. Any such committees would be authorized to administer the 2025 Omnibus Incentive Plan with respect to participants in the plan who are not Company “officers” within the meaning of Rule 16a-1(f) under the Securities Exchange Act or Company directors and, in this capacity, would be authorized to grant awards under the 2025 Omnibus Incentive Plan to such participants and to determine all terms of such awards.
The Board will retain the authority under the 2025 Omnibus Incentive Plan to exercise any or all of the powers and authorities related to the administration and implementation of the 2025 Omnibus Incentive Plan. Except where the authority to act on such matters is specifically reserved to the Board under the 2025 Omnibus Incentive Plan or applicable law, the Committee and each other committee acting in accordance with the foregoing plan provisions will have full power and authority to interpret and construe all provisions of the 2025 Omnibus Incentive Plan, any award or any award agreement, and to make all related determinations, including the power and authority to:
| • | designate grantees of awards; |
| • | determine the type or types of awards to be made to a grantee; |
| • | determine the number of shares of Common Stock subject to an award; |
| • | establish the terms and conditions of each award; |
| • | prescribe the form of each award agreement; |
| • | subject to limitations in the 2025 Omnibus Incentive Plan (including the prohibition on repricing of options and stock appreciation rights without shareholder approval), amend, modify or supplement the terms of any outstanding award; |
| • | accelerate the vesting of awards; and |
| • | make substitute awards. |
Amendment and Termination.
The Board will be authorized to amend, suspend or terminate the 2025 Omnibus Incentive Plan as to any shares of Common Stock as to which awards have not been made. Any amendment to the 2025 Omnibus Incentive Plan, however, will be subject to receipt of the approval of the Company’s shareholders if shareholder approval of the amendment is required by any law or regulation or the listing rules of the New
94 LABCORP HOLDINGS INC.
VOTE TO APPROVE THE 2025 OMNIBUS INCENTIVE PLAN
York Stock Exchange (or any other stock exchange on which the Common Stock is listed in future), or to the extent determined by the Board. Shareholder approval will be required for any proposed amendment to the 2025 Omnibus Incentive Plan provisions, which are described below, that prohibit the repricing of outstanding stock options or stock appreciation rights or that generally require the option price of any stock option to be at least equal to the fair market value of the Common Stock on the option grant date. Without the consent of the affected grantee of an outstanding award, no amendment, suspension or termination of the 2025 Omnibus Incentive Plan materially may impair the rights or obligations under that award.
Awards.
The following type of awards may be made under the 2025 Omnibus Incentive Plan, subject to the limitations set forth in the plan:
| • | stock options, which may be either incentive stock options or non-qualified stock options; |
| • | restricted stock; |
| • | restricted stock units and deferred stock units; |
| • | performance shares or other performance-based awards; |
| • | dividend equivalent rights; |
| • | stock appreciation rights, or “SARs”; |
| • | other equity-based awards, including unrestricted stock; and |
| • | cash awards. |
An incentive stock option is an option that meets the requirements of Section 422 of the Internal Revenue Code, and a non-qualified stock option is an option that does not meet those requirements. Restricted stock is an award of common stock on which vesting restrictions are imposed that subject the underlying shares of Common Stock to a substantial risk of forfeiture, as defined in Section 83 of the Internal Revenue Code. A restricted stock unit is an award that represents a conditional right to receive shares of common stock in the future and that may be made subject to the same types of restrictions and risk of forfeiture as restricted stock. A deferred stock unit is a restricted stock unit that may be settled at some point in the future. Performance-based awards are awards of options, restricted stock, restricted stock units, SARs, other equity-based awards or cash made subject to the achievement of one or more pre-established performance goals over a performance period established by the Committee. An award of performance shares is a performance-based award representing a right or interest denominated or payable in stock, valued by reference to stock, or otherwise based on or related to stock that is made subject to the achievement of one or more pre-established performance goals over a performance period of up to ten years. Dividend equivalent rights are awards entitling the grantee to receive cash, stock, other awards under the 2025 Omnibus Incentive Plan or other property equal in value to dividends or other periodic payments paid or made with respect to a specified number of shares of stock. A SAR is a right to receive upon exercise, in the form of common stock, cash or a combination of common stock and cash, the excess of the fair market value of one share of common stock on the exercise date over the grant price of the SAR. Unrestricted stock is an award of shares of common stock that is free of restrictions other than those imposed under federal or state securities laws.
The 2025 Omnibus Incentive Plan provides that each award will be evidenced by an award agreement, which may specify terms and conditions of the award that differ from the terms and conditions that would apply under the 2025 Omnibus Incentive Plan in the absence of the different terms and conditions in the award agreement.
Awards under the 2025 Omnibus Incentive Plan may be granted alone or in addition to, in tandem with, or in substitution or exchange for any other award under the 2025 Omnibus Incentive Plan, other awards under another compensatory plan of the Company or any of its affiliates (or any business entity that has been a party to a transaction to the Company or any of the Company’s affiliates), or other rights to payment from the Company or any of its affiliates. Awards granted in addition to or in tandem with other awards may be granted either at the same time or at different times.
Awards under the 2025 Omnibus Incentive Plan may be settled in cash, common stock, and other awards under the 2025 Omnibus Incentive Plan or other property. The Committee may permit or require the deferral of any payment pursuant to any award into a deferred compensation arrangement, which may include provisions for the payment or crediting of interest or dividend equivalent rights, in accordance with rules and procedures established by the Committee. No dividend equivalent rights may be granted in connection with, or related to, an award of options or SARs. Awards under the 2025 Omnibus Incentive Plan generally will be granted for no consideration other than past services by the grantee of the award or, if provided for in the award agreement or in a separate agreement, the grantee’s promise to perform future services to the Company or one of its subsidiaries or other affiliates.
2025 PROXY STATEMENT 95
VOTE TO APPROVE THE 2025 OMNIBUS INCENTIVE PLAN
Clawback; Forfeiture.
Any award granted pursuant to the 2025 Omnibus Incentive Plan will be subject to mandatory repayment by the grantee to the Company to the extent set forth in the plan or in an award agreement or to the extent the grantee is, or in the future becomes, subject to (1) any Company or affiliate “clawback” or recoupment policy that is adopted to comply with the requirements of any applicable law, rule or regulation, or otherwise, or (2) any law, rule or regulation which imposes mandatory recoupment, under circumstances set forth in any such law, rule or regulation.
Our policy for equity compensation awards, including awards under the 2025 Omnibus Incentive Plan, provides that awards can be subject to repayment of gains on such awards in the event of certain accounting restatements. Our policy also currently provides that if a grantee takes action in violation or breach of or in conflict with any employment agreement, non-competition agreement, agreement prohibiting solicitation of employees or clients of the Company or any affiliate, confidentiality obligation with respect to the Company or any affiliate, Company policy or procedure, other agreement, or, if the grantee incurs a termination for cause, the Company has the right to cause an immediate forfeiture of the rights under the applicable award.
Shares Available for Issuance.
Subject to the adjustments described below, the maximum number of shares of Common Stock that will be available for issuance under the 2025 Omnibus Incentive Plan will be equal to 3,050,000 shares of Common Stock, reduced by the number of shares of Common Stock underlying grants made under the 2016 Omnibus Incentive Plan, after February 28, 2025 and before the effective date of the plan.
Shares subject to an award granted under the 2025 Omnibus Incentive Plan will be counted against the maximum number of shares of Common Stock available for issuance under the plan as one share for every one share of Common Stock subject to such an award. Shares subject to an award of stock-settled SARs will be counted against the maximum number of shares available for issuance under the plan as one share for every one share of Common Stock subject to such an award regardless of the number of shares of Common Stock actually issued to settle such SARs upon the exercise of those rights.
Shares subject to an award granted under the 2025 Omnibus Incentive Plan or subject to awards granted under existing equity incentive plans that are forfeited on or after the effective date of the 2025 Omnibus Incentive Plan will become available for issuance under the 2025 Omnibus Incentive Plan on a one-for-one basis if the award terminates by expiration, forfeiture, cancellation, or otherwise without the issuance of such shares (except as set forth below).
Shares tendered or withheld or subject to an award (other than an option or SAR), or to awards (other than options or SARs) outstanding under the existing plans as of the effective date, surrendered in connection with the purchase of shares of Common Stock or deducted or delivered from payment of such award in connection with the Company’s tax withholding obligations will again be available for making awards under the 2025 Omnibus Incentive Plan in the same number as such shares were counted against the share limit, provided that any such shares subject to an award granted under the existing plans will be available for making awards under the 2025 Omnibus Incentive Plan.
The number of shares of Common Stock available for issuance under the 2025 Omnibus Incentive Plan will not be increased by the number of shares of Common Stock (i) tendered, withheld, or subject to an option granted under the 2025 Omnibus Incentive Plan surrendered in connection with the payment of the option price upon exercise of an option or in connection with the Company’s tax withholding obligations with respect to Options or stock-settled SARs, (ii) that were not issued upon the net settlement or net exercise of a stock-settled SAR, or (iii) purchased by the Company with proceeds from Option exercises.
Upon shareholder approval of the 2025 Omnibus Incentive Plan, no additional awards will be made under the existing equity incentive plans. Shares of Common Stock reserved under the existing incentive plans before the shareholder approval of the 2025 Omnibus Incentive Plan may be issued and delivered following the shareholder approval of the 2025 Omnibus Incentive Plan to settle such awards granted under the existing incentive plans before the Board approval of the 2025 Omnibus Incentive Plan.
The 2025 Omnibus Incentive Plan provides that the maximum number of shares of Common Stock subject to awards granted during a single fiscal year to any non-employee director, taken together with any cash fees paid to such non-employee director during the fiscal year, may not exceed $750,000 in total value (calculating the value of any such awards based on the grant date fair value of such awards for financial reporting purposes); provided, that the Board may make exceptions to this limit for individual non-employee directors in extraordinary circumstances as the Board may determine in its sole discretion, so long as (x) the aggregate limit does not exceed $1,000,000 in total value during a fiscal year and (y) the non-employee director receiving such additional compensation does not participate in the decision to award such compensation or in other contemporaneous compensation decisions involving non-employee directors.
96 LABCORP HOLDINGS INC.
VOTE TO APPROVE THE 2025 OMNIBUS INCENTIVE PLAN
The number and kinds of shares of Common Stock for which awards may be made under the 2025 Omnibus Incentive Plan, including the share limits described above, will be adjusted proportionately and accordingly by the Committee if the number of outstanding shares of Common Stock is increased or decreased or the shares of Common Stock are changed into or exchanged for a different number of shares or kind of capital stock or other securities of the Company on account of any recapitalization, reclassification, stock split, reverse stock split, spin-off, combination of stock, exchange of stock, stock dividend or other distribution payable in capital stock, or other increase or decrease in shares of Common Stock effected without receipt of consideration by the Company.
Shares of Common Stock to be issued under the 2025 Omnibus Incentive Plan will be authorized and unissued shares or, to the extent permitted under applicable laws, shares of treasury stock or issued shares that have been reacquired by the Company.
On February 28, 2025, the closing price of a share of Common Stock as reported on the New York Stock Exchange was $251.04 per share.
Fair Market Value Determination.
For so long as the shares of Common Stock remains listed on the New York Stock Exchange, the fair market value of the Common Stock on an award grant date will be the closing price of the Common Stock as reported on the New York Stock Exchange on such date. If there is no such reported closing price on such date, the fair market value of a share of Common Stock will be the closing price of the Common Stock as reported on the New York Stock Exchange on the next preceding date on which any sale of shares of Common Stock has been reported on the New York Stock Exchange. For purposes of determining taxable income and the amount of the related tax withholding obligation fair market value can be determined by the Company using any reasonable method. For same day sales, the 2025 Omnibus Incentive Plan provides that the sale price can be used as the proper basis for fair market value instead of the closing price.
Stock Options.
An option granted under the 2025 Omnibus Incentive Plan will be exercisable only to the extent that it is vested. Each option will become vested and exercisable at such times and under such conditions as the Committee may approve consistent with the terms of the 2025 Omnibus Incentive Plan. No option may be exercisable more than ten years after the option grant date. The Committee may include in the option agreement provisions specifying the period during which an option may be exercised following termination of the grantee’s service.
The exercise price per share of Common Stock for each option granted under the 2025 Omnibus Incentive Plan may not be less than 100%, or 110% in the case of an incentive stock option granted to a Ten Percent Shareholder (as defined in the 2025 Omnibus Incentive Plan), of the fair market value of a share of Common Stock on the option grant date, except in the case of an option granted upon assumption of, or in substitution for, outstanding awards previously granted under a compensatory plan by a business entity acquired or to be acquired by the Company or an affiliate or with which the Company or an affiliate has combined or will combine.
For options (other than substitute awards) granted on or after the effective date of the 2025 Omnibus Incentive Plan, the vesting of an option that is based solely upon performance criteria will be subject to a performance period of not less than twelve (12) months and the exercise of an option that is based solely upon continued service and/or the passage of time may not vest or be exercised in full or in part prior to the satisfaction of a one (1) year minimum vesting period, provided that up to five percent (5%) of the share limit under the 2025 Omnibus Incentive Plan, as adjusted for certain corporate events, may be granted pursuant to the Plan without being subject to these limitations or the similar limitations that apply to SARs.
Except in connection with a corporate transaction involving the Company (including any stock dividend, distribution (whether in the form of cash, shares of stock, other securities or other property), stock split, extraordinary cash dividend, recapitalization, change in control, reorganization, merger, consolidation, split-up, spin-off, combination, repurchase or exchange of shares of stock or other securities or similar transaction), the Company may not, without obtaining shareholder approval, (1) amend the terms of outstanding options to reduce the exercise price of such outstanding options, (2) cancel outstanding options in exchange for options with an exercise price that is less than the exercise price of the original options or (3) cancel outstanding options with an exercise price above the current stock price in exchange for cash or other securities.
Payment of the exercise price for shares purchased pursuant to the exercise of an option may be made in such forms as are approved by the Committee. These forms may include, in the Committee’s discretion, cash, cash equivalents acceptable to the Company, shares of the Common Stock and net issuance.
Restricted Stock and Restricted Stock Units.
Subject to the provisions of the 2025 Omnibus Incentive Plan, the Committee will determine the terms and conditions of each award of restricted stock and restricted stock units, including the restricted period for all or a portion of the award, the restrictions applicable to the award and the purchase price, if any, for the shares of Common Stock subject to the award. A grantee of restricted stock will have all the rights of a shareholder, including the right to vote the shares and, to the extent the shares of restricted stock become vested, to receive dividends, except to the extent limited by the Committee. Grantees of restricted stock units will have no voting or dividend rights or other rights associated with stock ownership, although the Committee may award dividend equivalent rights on such units.
2025 PROXY STATEMENT 97
VOTE TO APPROVE THE 2025 OMNIBUS INCENTIVE PLAN
Grantees will not vest in dividends paid on awards of restricted stock or in dividend equivalent rights paid on awards of restricted stock units if the underlying award does not become vested.
Dividend Equivalent Rights.
The Committee will be authorized to grant rights to dividend equivalents to a participant in connection with an award under the 2025 Omnibus Incentive Plan, or without regard to any other award, except that no dividend equivalent rights may be granted in connection with, or related to, an award of options or SARs. Dividend equivalent rights will entitle the participant to receive cash, stock, other awards under the 2025 Omnibus Incentive Plan or other property equal in value to dividends paid, or other periodic payments made, with respect to a specified number of shares of Common Stock. The terms and conditions of awards of dividend equivalent rights will be specified in the applicable award agreement.
Performance Shares and Other Performance-Based Awards.
The Committee may award performance shares and other performance-based awards in such amounts and upon such terms as the Committee may determine. Each grant of a performance-based award will have an initial value or target number of shares of Common Stock that is established by the Committee at the time of grant. The Committee may set performance goals in its discretion which, depending on the extent to which they are met, will determine the value and number of performance shares or other performance-based awards that will be paid out to a grantee. The performance goals generally will be based on one or more of the performance measures described above. The Committee will establish the performance periods for performance-based awards. Performance-based awards may be payable in cash or shares of Common Stock, or a combination thereof, as determined by the Committee.
Stock Appreciation Rights.
SARs may be granted in conjunction with all or a part of any option or other award granted under the 2025 Omnibus Incentive Plan, or without regard to any option or other award. The Committee will determine at the SAR grant date or thereafter the time or times at which and the circumstances under which a SAR may be exercised in whole or in part, the time or times at which and the circumstances under which a SAR will cease to be exercisable, the method of exercise, the method of settlement, the form of consideration payable in settlement, the method by which shares will be delivered or deemed delivered to grantees, and any other terms or conditions of any SAR.
For SARs (other than substitute awards) granted on or after the effective date of the 2025 Omnibus Incentive Plan, the vesting of a SAR that is based solely upon performance criteria will be subject to a performance period of not less than twelve (12) months and the exercise of a SAR that is based solely upon continued service and/or the passage of time may not vest or be exercised in full or in part prior to the satisfaction of a one (1) year minimum vesting period, provided that up to five percent (5%) of the share limit under the 2025 Omnibus Incentive Plan, as adjusted for certain corporate events, may be granted pursuant to the Plan without being subject to these limitations or the similar limitations that apply to stock options.
Upon exercise of a SAR, the holder will be entitled to receive, in the specified form of consideration, the excess of the fair market value of one share of Common Stock on the exercise date over the exercise price of the SAR, as determined by the Committee. The exercise price of a SAR may not be less than the fair market value of a share of Common Stock on the grant date.
Except in connection with a corporate transaction involving the Company (including any stock dividend, distribution (whether in the form of cash, shares of stock, other securities or other property), stock split, extraordinary cash dividend, recapitalization, change in control, reorganization, merger, consolidation, split-up, spin-off, combination, repurchase or exchange of shares of stock or other securities or similar transaction), the Company may not, without obtaining shareholder approval, (1) amend the terms of outstanding SARs to reduce the exercise price of such outstanding SARs, (2) cancel outstanding SARs in exchange for SARs with an exercise price that is less than the exercise price of the original SARs or (3) cancel outstanding SARs with an exercise price above the current stock price in exchange for cash or other securities.
Other Equity-Based Awards.
The Committee may grant other types of equity-based or equity-related awards, including the grant or offer for sale of shares of unrestricted stock, in such amounts and subject to such terms and conditions as the Committee may determine. Any such awards may involve the transfer of shares of Common Stock to participants, or payment in cash or otherwise of amounts based on the value of the shares of Common Stock. Any other equity-based awards granted by the Committee may be subject to performance goals established by the Committee based on one or more of the performance measures described above.
Effect of Corporate Transactions.
The 2025 Omnibus Incentive Plan contains provisions, which are described below, that provide for adjustments to the terms of some types of outstanding awards upon the occurrence of specified kinds of corporate transactions, including transactions that would be deemed to constitute a change in control of the Company within the meaning of the 2025 Omnibus Incentive Plan, as described below, which we refer to as a “Change in Control.” The provisions of the 2025 Omnibus Incentive Plan governing such transactions will apply unless a different treatment of the applicable award is specified in the applicable award agreement at the time of grant, in another agreement with the grantee of the award, or in another writing.
98 LABCORP HOLDINGS INC.
VOTE TO APPROVE THE 2025 OMNIBUS INCENTIVE PLAN
Change in Capitalization.
The Committee will adjust the terms of outstanding awards under the 2025 Omnibus Incentive Plan to preserve the proportionate interests of the holders in such awards if the number of outstanding shares of Common Stock is increased or decreased or the shares of Common Stock are changed into or exchanged for a different number of shares of kind of capital stock or other securities of the Company on account of any merger, reorganization, recapitalization, reclassification, stock split, reverse stock split, spin-off, combination of stock, exchange of stock, stock dividend or other distribution payable in capital stock, or other increase or decrease in shares of Common Stock effected without receipt of consideration by the Company. The adjustments will include proportionate adjustments to (1) the share limits set forth in the plan, (2) the number and kind of shares of stock subject to outstanding awards, (3) the per share option price of outstanding options and the per share SAR price of outstanding SARs, and (4) the performance conditions of any outstanding performance-based awards.
In the event of any distribution to the Company’s shareholders of securities of any other entity or other assets (including an extraordinary dividend, but excluding a non-extraordinary dividend, declared and paid by the Company) without receipt of consideration by the Company, the Committee will make appropriate adjustments to (1) the share limits set forth in the plan, (2) the number and kind of shares of stock subject to outstanding awards, and (3) the per share option price of outstanding options and the per share SAR price of outstanding SARs.
Reorganization not Constituting a Change in Control.
If the Company is the surviving entity in any reorganization, merger or consolidation of the Company with one or more other entities which does not constitute a Change in Control, any outstanding option or SAR will pertain to the securities to which a holder of the number of shares of stock subject to such option or SAR would have been entitled immediately after the transaction, with a corresponding proportionate adjustment to the per share option price and per share SAR price. Further, in the event of any such transaction, performance-based awards (and the related performance measures if deemed appropriate by the Committee, so that the holder is neither advantaged of disadvantaged) will be adjusted to apply to the securities that a holder of the number of shares of stock subject to such performance-based awards would have been entitled to receive immediately after the transaction.
Change in Control in which Awards are not Assumed.
Except as otherwise provided in an award agreement, another agreement with the grantee, or another writing, upon the occurrence of a Change in Control in which outstanding awards of options, SARs, restricted stock, restricted stock units, dividend equivalent rights or other equity-based awards are not assumed or continued, the following provisions will apply to the awards (to the extent the awards are not assumed or continued). Except with respect to performance-based awards, all outstanding awards of restricted stock, restricted stock units and dividend equivalent rights will be deemed to have vested, and the shares of Common Stock subject to such restricted stock units and dividend equivalent rights will be delivered immediately before the Change in Control, and either or both of the following two actions will be taken:
| • | At least 15 days before the scheduled completion of the Change in Control, all outstanding options and SARs will become immediately exercisable and will remain exercisable for a period of 15 days (subject to completion of the Change in Control); and/or |
| • | The Committee may elect to cancel any outstanding awards of options, SARs, restricted stock, restricted stock units and/or dividend equivalent rights and require payment or delivery to the holders of such awards an amount in cash or securities having a value (as determined by the Committee), (1) in the case of restricted stock, restricted stock units and dividend equivalent rights (for shares of stock subject thereto), equal to the price per share paid to holders of stock pursuant to the Change in Control and (2) in the case of options or SARs, equal to the product of the number of shares of stock subject to such options or SARs multiplied by the amount, if any, by which (a) the price per share paid to holders of stock pursuant to the Change in Control exceeds (b) the option price or SAR price applicable to such options and SARs. |
For performance-based awards denominated in stock or cash, (1) if less than half of the performance period has lapsed, the awards will be treated as though target performance has been achieved, (2) if at least half of the performance period has lapsed, actual performance to date shall be determined as of a date reasonably proximal to the date of consummation of the Change in Control, and that level of performance will be treated as achieved immediately prior to the Change in Control, and (3) if actual performance is not determinable, the awards will be treated as though target performance has been achieved. Awards that arise out of this treatment of performance-based awards in a Change in Control will be settled under the Change in Control provisions above for the applicable award type.
Other equity-based awards will be governed by the terms of the applicable award agreement.
Change in Control in which Awards are Assumed.
Except as otherwise provided in the applicable award agreement, another agreement with the grantee, or another writing, upon the occurrence of a Change in Control in which outstanding awards are being assumed or continued, the 2025 Omnibus Incentive Plan and such awards (to the extent the awards are assumed or confirmed) will continue in the manner and under the terms specified in any writing providing for assumption or continuation of such awards, which may specify the substitution for such awards of new common stock
2025 PROXY STATEMENT 99
VOTE TO APPROVE THE 2025 OMNIBUS INCENTIVE PLAN
options, stock appreciation rights, restricted stock, restricted stock units, performance-based awards, dividend equivalent rights or other equity-based awards relating to the stock of a successor entity, or a parent or subsidiary thereof. In the event of such a substitution, appropriate adjustments will be made to the number of shares subject to the original awards (disregarding any transaction consideration that is not common stock), the performance conditions applicable to performance-based awards, and to option and SAR exercise prices. In the event an award, other than a performance-based award is assumed, continued or substituted upon a change in control and the holder’s employment is terminated without cause within one year following the change in control (or such longer or shorter period as may be determined by the Committee), the award will fully vest and may be exercised in full, to the extent applicable, beginning on the date of such termination and for the one-year period immediately following such termination or for such longer period as the Committee shall determine.
Definition of Change in Control.
The 2025 Omnibus Incentive Plan generally defines a “Change in Control” to mean the first to occur of any of the following events:
| • | any transaction (including without limitation a merger or reorganization in which the Company is the surviving entity) which results in any person (other than any employee benefit plan (or related trust) of the Company) owning thirty percent (30%) or more of the combined voting power of all classes of voting stock; excluding, however, the following: (1) any acquisition directly from the Company, other than as a result of the exercise of a conversion privilege, (2) any repurchase by the Company, (3) any acquisition by any employee benefit plan (or related trust) of the Company or any entity controlled by the Company, or (4) any acquisition pursuant to a transaction described in clause (i), (ii) or (iii) of the third bullet point in this definition of change in control; |
| • | individuals who constitute the Board on the effective date of the 2025 Omnibus Incentive Plan (the “Incumbent Board”) cease for any reason to constitute at least a majority thereof, provided that any person becoming a director subsequent to the date of the 2025 Omnibus Incentive Plan whose election was approved by a vote of at least three-quarters of the directors comprising the Incumbent Board, or whose nomination for election by the Company’s shareholders was approved by the Incumbent Board, shall be for purposes of this clause, considered as though he or she were a member of the Incumbent Board; |
| • | the Company consolidates with, or merges with or into, any person, or any person consolidates with, or merges with or into, the Company (regardless of whether the Company is the surviving person), other than any such transaction in which (i) all or substantially all of the holders of equity securities of the Company immediately prior to a reorganization, merger, or consolidation involving the Company (or other equity securities into which such equity securities are converted as part of such reorganization, merger, or consolidation transaction) own directly or indirectly at least a majority of the voting power of the voting stock of the surviving person in such reorganization, merger, or consolidation transaction immediately after such transaction, (ii) no person (other than the Company, any employee benefit plan (or related trust) of the Company or such corporation resulting from such reorganization, merger or consolidation) will beneficially own, directly or indirectly, thirty percent (30%) or more of the combined voting power of the voting stock of the surviving person in such reorganization, merger or consolidation, except to the extent such ownership derives from ownership that existed prior to such reorganization, merger or consolidation, and (iii) individuals who were members of the Board immediately prior to such reorganization, consolidation or merger will constitute at least a majority of the members of the board of directors of the surviving person resulting from such reorganization, merger or consolidation; |
| • | the dissolution or liquidation of the Company; or |
| • | the sale of substantially all of the assets of the Company to another person. |
Resale of Shares by Participants
Shares of Common Stock issued pursuant to the 2025 Omnibus Incentive Plan will be eligible for sale by participants in the public market without restriction under the “Securities Act” except that any shares purchased by an “affiliate” of the Company, as that term is defined in Rule 144 under the Securities Act, will be subject to the resale limitations of Rule 144.
A participant who is an affiliate of the Company may sell in the public market the shares issued to the participant only in accordance with the limitations and conditions of Rule 144, other than the holding period condition. In general, Rule 144 provides that any such person (or persons whose shares are aggregated) is entitled to sell within any three-month period the number of shares that does not exceed the greater of (1) one percent (1%) of the then-outstanding shares of Common Stock and (2) the reported average weekly trading volume of the then-outstanding shares of Common Stock during the four calendar weeks immediately preceding the date on which the notice of sale is filed with the SEC. Sales under Rule 144 by affiliates also are subject to provisions relating to the manner and notice of sale and the availability of current public information about the Company.
100 LABCORP HOLDINGS INC.
VOTE TO APPROVE THE 2025 OMNIBUS INCENTIVE PLAN
Federal Income Tax Consequences
The following summarizes the federal income tax consequences of awards that may be granted under the 2025 Omnibus Incentive Plan.
Incentive Stock Options.
An option holder will not realize taxable income upon the grant of an incentive stock option under the 2025 Omnibus Incentive Plan. In addition, an option holder generally will not realize taxable income upon the exercise of an incentive stock option. An option holder’s alternative minimum taxable income, however, will be increased by the amount by which the aggregate fair market value of the shares underlying the option, which is generally determined as of the date of exercise, exceeds the aggregate exercise price of the option. Further, except in the case of an option holder’s death or disability, if an option is exercised more than three months after the option holder’s termination of employment, the option will cease to be treated as an incentive stock option and will be subject to taxation under the rules applicable to non-qualified stock options, as summarized below.
If an option holder sells the option shares acquired upon exercise of an incentive stock option, the tax consequences of the disposition will depend upon whether the disposition is “qualifying” or “disqualifying.” The disposition of the option shares will be a qualifying deposition if it is made at least two years after the date on which the incentive stock option was granted and at least one year after the date on which the incentive stock option was exercised. If the disposition of the option shares is qualifying, any excess of the sale price of the option shares over the exercise price of the option will be treated as long-term capital gain taxable to the option holder at the time of the sale. If the disposition is a disqualifying disposition, the excess of the fair market value of the option shares on the date of disposition over the exercise price will be taxable income to the option holder at the time of the disposition. Of that income, the amount up to the excess of the fair market value of the shares at the time the option was exercised over the exercise price will be ordinary income for income tax purposes and the balance, if any, will be long-term or short-term capital gain, depending upon whether or not the shares were sold more than one year after the option was exercised.
Unless an option holder engages in a disqualifying disposition, the Company will not be entitled to a deduction with respect to an incentive stock option. If an option holder engages in a disqualifying disposition, the Company will be entitled to a deduction equal to the amount of compensation income taxable to the option holder.
If an option holder pays the exercise price of an incentive stock option by tendering shares with a fair market value equal to part or all of the exercise price, the exchange of shares will be treated as a nontaxable exchange, except that this treatment will not apply if the option holder acquired the shares being tendered pursuant to the exercise of an incentive stock option and has not satisfied the special holding period requirements summarized above. The tax basis of the shares tendered to pay the exercise price will be treated as the substituted tax basis for an equivalent number of shares received, and the new shares will be treated as having been held for the same holding period as the holding period that expired with respect to the tendered shares.
Non-Qualified Stock Options.
An option holder will not realize taxable income upon the grant of a non-qualified stock option. When an option holder exercises the option, however, the difference between the exercise price of the option and the fair market value of the shares subject to the option on the date of exercise will constitute compensation income taxable to the option holder. The Company will be entitled to a deduction equal to the amount of compensation income taxable to the option holder subject to the limitations imposed by Section 162(m) of the Internal Revenue Code.
If an option holder tenders shares in payment of part or all of the exercise price of a non-qualified stock option, no gain or loss will be recognized with respect to the shares tendered, even if the shares were acquired pursuant to the exercise of an incentive stock option. In such an event, the option holder will be treated as receiving an equivalent number of shares pursuant to the exercise of the option in a nontaxable exchange. The tax basis of the shares tendered will be treated as the substituted tax basis for an equivalent number of shares received, and the shares received will be treated as having been held for the same holding period as the holding period that expired with respect to the tendered shares. The difference between the aggregate exercise price and the aggregate fair market value of the shares received pursuant to the exercise of the option will be taxed as ordinary income, just as if the option holder had paid the exercise price in cash.
Restricted Stock.
A grantee of restricted stock will not recognize any taxable income for federal income tax purposes in the year of the award if the shares of Common Stock subject to the award are subject to restrictions (that is, the restricted stock is nontransferable and subject to a substantial risk of forfeiture). The grantee, however, may elect under Section 83(b) of the Internal Revenue Code to recognize compensation income in the year of the award in an amount equal to the fair market value of the shares of Common Stock on the date of the award, determined without regard to the restrictions. If the grantee does not make such a Section 83(b) election, the fair market value of the shares on the date on which the restrictions lapse will be treated as compensation income to the grantee and will be taxable in the year in which the
2025 PROXY STATEMENT 101
VOTE TO APPROVE THE 2025 OMNIBUS INCENTIVE PLAN
restrictions lapse. The Company generally will be entitled to a deduction for compensation paid equal to the amount treated as compensation income to the grantee in the year in which the grantee is taxed on the income, subject to the limitations imposed by Section 162(m) of the Code.
Dividend Equivalents Rights.
Grantees under the 2025 Omnibus Incentive Plan who receive awards of dividend equivalent rights will be required to recognize ordinary income in the amount distributed to the grantee pursuant to the award. The Company will be entitled to a business expense deduction in the same amount and generally at the same time as the grantee recognizes ordinary income, subject to the limitations imposed by Section 162(m) of the Internal Revenue Code.
Restricted Stock Units and Performance-Based Awards.
A distribution of shares of Common Stock or a payment of cash in satisfaction of restricted stock units or a performance-based award will be taxable as ordinary income when the distribution or payment is actually or constructively received by the recipient. The amount taxable as ordinary income is the aggregate fair market value of the shares of Common Stock determined as of the date it is received or, in the case of a cash award, the amount of the cash payment. The Company will be entitled to deduct the amount of such payments when such payments are taxable as compensation to the recipient, subject to the limitations imposed by Section 162(m) of the Internal Revenue Code.
Stock Appreciation Rights
The grant of SARs will not result in taxable income to the participant or a deduction to the Company. Upon exercise of a SAR, the holder will recognize ordinary income in an amount equal to the cash or the fair market value of the Common Stock received by the holder. The Company will be entitled to a deduction equal to the amount of any compensation income taxable to the grantee, subject to the limitations imposed by Section 162(m) of the Internal Revenue Code.
Unrestricted Stock
A holder of shares of unrestricted stock will be required to recognize ordinary income in an amount equal to the fair market value of the shares on the date of the award, reduced by the amount, if any, paid for such shares. The Company will be entitled to deduct the amount of any compensation income taxable to the grantee, subject to the limitations imposed by Section 162(m) of the Internal Revenue Code.
Upon the holder’s disposition of shares of unrestricted stock, any gain realized in excess of the amount reported as ordinary income will be reportable by the holder as a capital gain, and any loss will be reportable as a capital loss. Capital gain or loss will be long-term if the holder has held the shares for more than one year. Otherwise, the capital gain or loss will be short-term.
Tax Withholding
Payment of the taxes imposed on awards made under the 2025 Omnibus Incentive Plan may be made by withholding from payments otherwise due and owing to the holder.
The Board recommends that shareholders vote “FOR” the approval of the adoption of the proposed Labcorp Holdings Inc. 2025 Omnibus Incentive Plan and certain material terms and conditions relating to performance-based compensation under the 2025 Omnibus Incentive Plan.
102 LABCORP HOLDINGS INC.
|
|
||||
VOTE TO APPROVE THE 2025 EMPLOYEE STOCK PURCHASE PLAN
|
PROPOSAL FOUR
|
The Board unanimously recommends that shareholders vote “FOR” the approval of the proposed 2025 Employee Stock Purchase Plan | |||
| Vote to Approve the 2025 Employee Stock | ||||
| Purchase Plan |
||||
We are asking our shareholders to approve adoption of the proposed Labcorp Holdings Inc. 2025 Employee Stock Purchase Plan (the “2025 ESPP”).
The Board believes that an employee stock purchase plan encourages the Company’s employees to acquire shares of Common Stock, thereby fostering broad alignment of employees’ interests with the interests of our shareholders; fosters good employee relations; and provides the Company an ability to recruit, retain, and reward employees in an extremely competitive environment. To continue to provide this valuable element of the Company’s compensation program, the Board recommends that the shareholders approve the 2025 ESPP.
Upon the recommendation of the Compensation and Human Capital Committee, the Board adopted the 2025 ESPP on March 27, 2025, subject to and effective as of receipt of shareholder approval of the 2025 ESPP at the Annual Meeting. The Board believes that approval of the 2025 ESPP is in the best interests of the Company and its shareholders.
The Board has proposed approval of the 2025 ESPP by shareholders to replace the Labcorp Holdings Inc. Amended and Restated 2016 Employee Stock Purchase Plan (the “2016 ESPP”). The 2016 ESPP has been an important and broad-based opportunity for our employees for 9 years, and over such time our employees have purchased more than 2,300,000 shares of Common Stock. If the shareholders approve the 2025 ESPP, the 2025 ESPP will become effective as of the date of the Annual Meeting, with the first offering period under the 2025 ESPP to commence on July 1, 2025 and to end on December 31, 2025, and no future offering periods will commence under the 2016 ESPP following the current offering period under the 2016 ESPP, which will end on June 30, 2025. If the shareholders do not approve the 2025 ESPP, the 2025 ESPP will not become effective, and the 2016 ESPP will continue to the extent of the shares of Common Stock remaining available for issuance.
Key Features of 2025 Employee Stock Purchase Plan
As described further below, the 2025 ESPP generally:
| • | Plan Limits. The 2025 Employee Stock Purchase Plan reserves 2,500,000 shares of Common Stock for issuance; |
| • | Contribution Limits. A participant is permitted to contribute up to 10% of the participant’s eligible compensation each pay period through after-tax payroll deductions or, if permitted by the Administrator, to make cash contributions to the 2025 Employee Stock Purchase Plan to fund the participants’ ability to purchase shares of Common Stock under the 2025 Employee Stock Purchase Plan; |
| • | Offering Periods. Unless otherwise determined by the Administrator (as defined below), the 2025 Employee Stock Purchase Plan establishes six-month offering periods commencing on the first trading day of January and July of each calendar year and ending on the last trading day of June and December, respectively, except that the first offering period will commence on July 1, 2025 and end on December 30, 2025 (the last trading day of December); |
2025 PROXY STATEMENT 103
VOTE TO APPROVE THE 2025 EMPLOYEE STOCK PURCHASE PLAN
| • | Share Price Discount. The 2025 Employee Stock Purchase Plan permits participants to purchase shares of Common Stock at up to a 15% discount; and |
| • | Annual Purchase Limits. The 2025 Employee Stock Purchase Plan limits the value of shares that a participant may purchase in a calendar year to $25,000 and, unless otherwise determined by the Administrator, the number of shares that a participant may purchase in an offering period to 50,000 shares |
Summary of Material Provisions of 2025 Employee Stock Purchase Plan
A summary of the material terms of the 2025 ESPP is set forth below. This summary is qualified in its entirety by the detailed provisions of the 2025 ESPP, a copy of which is attached as Annex B to this Proxy Statement and which is incorporated by reference into this Proposal Four. We encourage shareholders to read and refer to the complete plan document in Annex B for a more complete description of the 2025 ESPP.
Interpretation. The 2025 ESPP and the options granted under the 2025 ESPP are intended to satisfy the requirements for an “employee stock purchase plan” under Section 423 of the Internal Revenue Code. Notwithstanding the foregoing, the Company is not obligated to, and is not promising that it will, maintain the qualified status of the 2025 ESPP or any options granted thereunder. Options that do not satisfy the requirements for an “employee stock purchase plan” under Section 423 of the Internal Revenue Code may be granted under the 2025 ESPP pursuant to the rules, procedures, or sub-plans adopted by the Administrator for certain eligible employees.
Share Reserve. Subject to adjustment in connection with certain corporate transactions, the maximum number of shares of Common Stock that may be purchased under the 2025 ESPP, consisting of authorized but unissued shares, treasury shares, or shares purchased on the open market, will be 2,500,000 shares.
Administration. The 2025 ESPP will be administered, at the Company’s expense, under the direction of the Board, the Compensation and Human Capital Committee, or any other committee of the Board designated by the Board from time to time (any such entity, the “Administrator”). The Administrator will have the authority to take any actions it deems necessary or advisable for the administration of the 2025 ESPP, including, without limitation, (i) interpreting and construing the 2025 ESPP and options granted thereunder, (ii) prescribing, adopting, amending, waiving, and rescinding rules and regulations it deems appropriate to implement the 2025 ESPP, (iii) correcting any defect or supplying any omission or reconciling any inconsistency in the 2025 ESPP or options granted thereunder, (iv) establishing the timing and length of offering periods and purchase periods, (v) establishing minimum and maximum contribution rates, (vi) establishing new or changing existing limits on the number of shares of Common Stock a participant may elect to purchase with respect to any offering period, if such limits are announced prior to the first offering period to be affected, (vii) adopting such rules, procedures, or sub-plans as may be deemed advisable or necessary to comply with the laws of countries other than the United States, to allow for tax-preferred treatment of the options or otherwise to provide for the participation by eligible employees who reside outside of the United States, (viii) establishing the exchange ratio applicable to amounts withheld in a currency other than U.S. dollars and permitting payroll withholding in excess of the amount designated by a participant in order to adjust for delays or mistakes in the processing of properly completed enrollment forms, and (ix) furnishing information to the custodian for the 2025 ESPP as the custodian may require. The Administrator’s decisions will be final, conclusive, and binding upon all persons.
Eligibility. Generally, natural persons who have been employees (including officers) of the Company or any subsidiary of the Company designated by the Administrator from time to time (a “participating affiliate”) for at least six months may be eligible to participate in the 2025 ESPP. But, the following employees are ineligible to participate in the 2025 ESPP: (i) employees whose customary employment is 20 hours or less per week; (ii) employees whose customary employment is for not more than five months in any calendar year; (iii) employees who, after exercising their options to purchase Common Stock under the 2025 ESPP, would own, directly or indirectly, shares of Common Stock (including shares that may be acquired under any outstanding options under the 2025 ESPP) representing 5% or more of the total combined voting power of all classes of the Company’s capital stock; and (iv) employees who are citizens or residents of a foreign jurisdiction (without regard to whether such employees are also U.S. citizens or resident aliens), if the grant of an option under the 2025 ESPP or an offering period to such employee is prohibited under the laws of such foreign jurisdiction or compliance with the laws of such foreign jurisdiction would cause the 2025 ESPP or an offering period to violate the requirements of Section 423 of the Internal Revenue Code.
Notwithstanding the foregoing, for purposes of an offering under the 2025 ESPP that is not intended to satisfy the requirements of Section 423 of the Internal Revenue Code, the Administrator will have the authority to establish a different definition of eligible employee as it may deem advisable or necessary. In addition, the Administrator may determine that highly compensated employees (within the meaning of Section 414(q) of the Internal Revenue Code) will not be eligible to participate in an offering period.
As of February 28, 2025, approximately 53,000 employees of the Company and its subsidiaries may become eligible to participate in the 2025 ESPP.
Participation Election. An eligible employee may become a participant for an offering period under the 2025 ESPP by completing and submitting an enrollment form to the Company or its designee. Such enrollment form will authorize the Company to make after-tax payroll
104 LABCORP HOLDINGS INC.
VOTE TO APPROVE THE 2025 EMPLOYEE STOCK PURCHASE PLAN
deductions in whole percentages up to 10% of the participant’s eligible compensation on each pay day following enrollment in the offering period under the 2025 ESPP, or if authorized by the Administrator, will indicate the amount of other cash contributions which a participant will make to the 2025 ESPP. The Administrator will credit the deductions or contributions to the participant’s account under the 2025 ESPP.
Subject to certain exceptions, a participant may cease his or her payroll deductions or cash contributions during an offering period, by properly completing and timely submitting a new enrollment form to the Company or its designee, at any time prior to the last day of such offering period (or purchase period). A participant may increase or decrease his or her payroll deductions or cash contributions to take effect on the first trading day of the next offering period, by properly completing and timely submitting a new enrollment form to the Company or its designee.
Once an eligible employee becomes a participant in the 2025 ESPP, the participant will automatically participate in each successive offering period until such time as the participant ceases his or her payroll deductions or is no longer eligible to participate in the 2025 ESPP or a specific offering period under the 2025 ESPP.
Offering Periods and Purchase Periods. The Administrator will determine the length and duration of the periods during which payroll deductions or other cash contributions will accumulate to purchase shares of Common Stock, which period will not exceed 27 months. Each of these periods is known as an “offering period.” The Administrator may, but is not required to, permit periodic purchases of Common Stock within a single offering period. The periods during which payroll deductions or other cash contributions will accumulate for these purchases are referred to as “purchase periods.” While the Administrator has discretion to establish the offering periods and purchase periods under the 2025 ESPP, subject to approval of the 2025 ESPP by the Company’s shareholders and until otherwise determined by the Administrator, the 2025 ESPP will have six-month offering periods commencing on the first trading day of January and July of each calendar year and ending on the last trading day of June and December, respectively, except that the first offering period under the 2025 ESPP will commence on July 1, 2025 and end on December 31, 2025.
Purchase Price. While the Administrator has discretion to establish a higher purchase price per offering period, until otherwise determined by the Administrator, the purchase price per share of Common Stock under the 2025 ESPP will be (and may not be less than) 85% of the closing price of the Common Stock on the New York Stock Exchange on (i) the first trading day of the relevant offering period or (ii) the last trading day of the relevant offering period (or purchase period).
On February 28, 2025, the closing price of the Common Stock, as reported on the New York Stock Exchange, was $251.04 per share.
Purchase of Shares. On the last trading day of the offering period (or purchase period), a participant is deemed to purchase the number of whole shares of Common Stock determined by dividing the total amount of payroll deductions withheld from the participant’s paychecks during the offering period (or purchase period) or the total value of all cash contributions made to the 2025 ESPP during the offering period (or purchase period) by the purchase price. Any cash contributions not applied to the purchase will be refunded to the participant through the payroll process.
Purchase Limitations. No participant may purchase shares of Common Stock in any calendar year under the 2025 ESPP and under all other “employee stock purchase plans” of the Company and its subsidiaries having an aggregate fair market value in excess of $25,000, determined as of the first trading day of the offering period. In addition, no participant may purchase more than 50,000 shares of Common Stock in any one offering period; provided, however, that prior to the start of an offering period, the Administrator may impose a different limit on the number of shares of Common Stock a participant may purchase during the offering period. The fair market value for this purpose will be equal to the closing price per share as reported on the New York Stock Exchange on the first trading day of the offering period.
If the Administrator determines that the total number of shares of Common Stock remaining available under the 2025 ESPP is insufficient to permit all participants to exercise their options to purchase shares, the Administrator will make a participation adjustment and proportionately reduce the number of shares purchasable by all participants.
Termination of Participation. A participant may not voluntarily withdraw from an offering period under the 2025 ESPP. A participant will automatically be withdrawn by the Company from an offering period under the 2025 ESPP (i) upon a termination of employment with the Company or a participating affiliate, (ii) in certain cases, following a leave of absence or a temporary period of ineligibility, and (iii) upon cessation of eligibility to participate in the 2025 ESPP for any reason.
Shareholder Rights. A participant shall not be a shareholder or have any rights as a shareholder with respect to shares of Common Stock subject to the participant’s options under the 2025 ESPP until the shares of Common Stock are purchased pursuant to the options and such shares of Common Stock are transferred into the participant’s name on the Company’s books and records. Shares of Common Stock purchased under the 2025 ESPP will be held by the custodian designated under the 2025 ESPP. Following purchase and transfer of shares of Common into the participant’s name on the Company’s books and records, a participant will become a shareholder with respect to the shares of Common Stock purchased and will thereupon have all dividend, voting, and other ownership rights incident thereto.
2025 PROXY STATEMENT 105
VOTE TO APPROVE THE 2025 EMPLOYEE STOCK PURCHASE PLAN
Notwithstanding the foregoing, the Administrator has the right to (i) limit transfer of the shares of Common Stock until two years from the first trading day of the offering period in which the shares were purchased and until one year from the last trading day of the offering period (or purchase period) in which the shares were purchased (the “holding period”), (ii) require that any sales of Common Stock during the holding period be performed through a licensed broker acceptable to the Company, and (iii) limit sales or other transfers of shares of Common Stock for up to two years from the date the participant purchases shares of Common Stock under the 2025 ESPP.
Transferability. A participant’s options to purchase shares of Common Stock under the 2025 ESPP may not be sold, pledged, assigned, or transferred in any manner, whether voluntarily, by operation of law, or otherwise. Any payment of cash or issuance of shares of Common Stock under the 2025 ESPP may be made only to the participant (or, in the event of the participant’s death, to the participant’s estate or beneficiary). During a participant’s lifetime, only such participant may exercise his or her options to purchase shares of Common Stock under the 2025 ESPP.
Corporate Transactions. If the number of outstanding shares of Common Stock is increased or decreased or the shares of Common Stock are changed into or exchanged for a different number or kind of shares or other securities of the Company by reason of any recapitalization, reclassification, stock split, reverse stock split, spin-off, combination of shares, exchange of shares, stock dividend, or other distribution payable in capital stock, or other increase or decrease in shares of Common Stock effected without receipt of consideration by the Company, the number and kinds of shares of Common Stock for which options may be made under the 2025 ESPP will be adjusted proportionately and accordingly by the Administrator. In addition, the number and kind of shares for which options are outstanding will be similarly adjusted so that the proportionate interest of a participant immediately following such event will, to the extent practicable, be the same as immediately prior to such event.
Upon dissolution or liquidation of the Company, upon a merger, consolidation, or reorganization of the Company with one or more other corporations in which the Company is not the surviving entity, upon a sale of all or substantially all of the Company’s assets, or upon consummation of any other transaction approved by the Board resulting in any person or entity owning more than 50% of the combined voting power of all classes of the Company’s capital stock, the 2025 ESPP and all options outstanding thereunder will terminate, except to the extent provision is made in writing in connection with such transaction for the continuation or assumption of the 2025 ESPP, or for the substitution of the options under the 2025 ESPP with new options covering the capital stock of the successor entity, with corresponding appropriate adjustments to the number and kinds of shares and purchase prices. Upon termination of the 2025 ESPP in this circumstance, the offering period will end on the last trading day prior to such termination, and the options of each participant will automatically be exercised on such last trading day.
Subject to the foregoing, if the Company is the surviving corporation in any reorganization, merger, or consolidation of the Company with one or more other corporations, all outstanding options under the 2025 ESPP will pertain to and apply to the securities to which a holder of the number of shares of Common Stock subject to such options would have been entitled immediately following such reorganization, merger, or consolidation, with corresponding appropriate adjustments to the number and kinds of shares and purchase prices.
Term. If approved by the Company’s shareholders at the Annual Meeting, the 2025 ESPP will become effective as of the date of the Annual Meeting. The 2025 ESPP will terminate on the earliest of (i) the day before the 10th anniversary of the date of the Annual Meeting, (ii) the date on which all shares of Common Stock reserved for issuance under the 2025 ESPP have been issued, (iii) the date the 2025 ESPP is terminated in connection with certain corporate transactions, and (iv) the date the Administrator terminates the 2025 ESPP.
Amendment, Suspension, or Termination. The Administrator may, at any time and from time to time, amend, suspend, or terminate the 2025 ESPP or an offering period under the 2025 ESPP; provided, however, that no amendment, suspension, or termination will, without the consent of the participant, impair any vested rights of a participant. Without shareholder approval, the Administrator may not (i) increase the number of shares reserved for issuance under the 2025 ESPP or (ii) change the eligibility requirements for participating in the 2025 ESPP.
Summary of U.S. Federal Income Tax Consequences
The following summary of U.S. federal income tax consequences is intended only as a general guide, under current U.S. federal income tax law, of participation in the 2025 ESPP and does not attempt to describe all potential tax consequences. This discussion is intended for the information of our shareholders considering how to vote at the Annual Meeting and not as tax guidance to participants in the 2025 ESPP. The following summary is not intended or written to be used, and cannot be used, for the purposes of avoiding taxpayer penalties. Tax consequences are subject to change, and a taxpayer’s particular situation may be such that some variation in application of the described rules is applicable. Accordingly, participants are advised to consult their own tax advisors with respect to the tax consequences of participating in the 2025 ESPP.
The 2025 ESPP is intended to qualify as an “employee stock purchase plan” under Section 423 of the Internal Revenue Code, and options to make purchases under the 2025 ESPP are intended to qualify under the provisions of Section 423 of the Internal Revenue Code. Amounts withheld from a participant’s earnings under the 2025 ESPP will be taxable income to the participant in the year in which the amounts otherwise would have been received, but the participant will not be required to recognize additional income for U.S. federal income tax
106 LABCORP HOLDINGS INC.
VOTE TO APPROVE THE 2025 EMPLOYEE STOCK PURCHASE PLAN
purposes either at the time the participant is deemed to have been granted an option to purchase Common Stock on the grant date or when the option to purchase Common Stock is exercised on the purchase date. No additional taxable income will be recognized for U.S. federal income tax purposes by a participant until the sale or other disposition of the shares of Common Stock acquired under the 2025 ESPP. Upon such sale or disposition, the participant will generally be subject to tax in an amount that depends upon the length of time such shares are held by the participant prior to selling or disposing of them.
If a participant holds the shares of Common Stock purchased under the 2025 ESPP for at least two years after the grant date and for at least one year from the purchase date of the shares of Common Stock, when the participant sells or disposes of the shares of Common Stock (a “qualifying disposition”), the participant will recognize as ordinary income an amount equal to the lesser of: (i) the excess of the fair market value of the shares of Common Stock on the date of such sale or disposition over the purchase price or (ii) the fair market value of the shares of Common Stock on the grant date multiplied by the discount percentage for stock purchases under the 2025 ESPP. Any additional gain will be treated as long-term capital gain. If the shares are held for the holding periods described above but are sold for a price that is less than the purchase price, there is no ordinary income, and the participant has a long-term capital loss for the difference between the sale price and the purchase price.
If a participant sells or disposes of the shares of Common Stock purchased under the 2025 ESPP within two years after the grant date or before one year has elapsed since the purchase date (a “disqualifying disposition”), the participant will recognize as ordinary income an amount equal to the excess of the fair market value of the shares on the date the shares are purchased over the purchase price. Any additional gain or loss on such sale or disposition will be long-term or short-term capital gain or loss, depending on how long the shares were held following the date they were purchased by the participant prior to selling or disposing of them.
In connection with a qualifying disposition, the Company will not receive any deduction for U.S. federal income tax purposes with respect to those shares of Common Stock or the option under which it was purchased. In connection with a disqualifying disposition, the Company will be entitled to a deduction in an amount equal to the amount that is considered ordinary income.
New Plan Benefits
Because the number of shares of Common Stock that may be purchased under the 2025 ESPP will depend on each participant’s voluntary election to participate and on the fair market value of the Common Stock at various future dates, the actual number of shares that may be purchased by any individual cannot be determined in advance. No shares of Common Stock have been issued under the 2025 ESPP as of the date of this Proxy Statement, and no shares of Common Stock will be issued under the 2025 ESPP prior to approval of the 2025 ESPP by the Company’s shareholders.
The Board unanimously recommends that shareholders vote “FOR” the approval of the Labcorp Holdings Inc. 2025 Employee Stock Purchase Plan.
2025 PROXY STATEMENT 107
|
|
||||
RATIFICATION OF INDEPENDENT REGISTERED PUBLIC ACCOUNTING FIRM
|
PROPOSAL FIVE
|
The Board unanimously recommends that shareholders vote “FOR” the ratification of the appointment of Deloitte & Touche LLP as the Company’s independent registered public accounting firm for 2025. | |||
| Ratification of
| ||||
Engagement of Deloitte & Touche LLP
The Audit Committee has appointed Deloitte & Touche LLP (“Deloitte”) to audit the accounts of the Company for the year ending December 31, 2025, and the shareholders of the Company are being asked to ratify this appointment. Deloitte has served as our independent registered public accounting firm since the fiscal year ended December 31, 2021.
The Audit Committee has ultimate authority and responsibility for the appointment, termination, compensation, evaluation, and oversight of our independent registered public accounting firm and annually evaluates the performance of our independent registered public accounting firm and considers the likely impact of changing the independent registered accounting firm. The Audit Committee also evaluates and approves the selection of the lead partner and senior members of the audit team.
Shareholder ratification of the appointment of Deloitte as the Company’s independent registered public accounting firm is not required by our By-Laws, but the Board has elected to seek such ratification as a matter of good corporate practice. Should the shareholders fail to ratify the appointment of Deloitte as the Company’s independent registered public accounting firm for the year ending December 31, 2025, the Audit Committee will consider whether to retain that firm for such year. Even if this appointment is ratified, the Audit Committee, in its discretion, may direct the appointment of a different independent registered public accounting firm at any time during the year if the Audit Committee determines that such a change would be in the interests of the Company.
Representatives of Deloitte will be present at the 2025 Annual Meeting, will have the opportunity to make a statement if they desire to do so and will be available to respond to appropriate questions.
Fees to Independent Registered Public Accounting Firm
The Audit Committee must approve, in advance, all of Deloitte’s services, whether or not related to an audit. Aggregate fees for professional services rendered for the Company by Deloitte for the years ended December 31, 2024 and 2023 are described in the table below. All the services for which fees were paid were pre-approved by the Audit Committee. The Audit Committee has considered the non-audit-related services rendered and believes that they are compatible with Deloitte remaining independent.
108 LABCORP HOLDINGS INC.
RATIFICATION OF INDEPENDENT REGISTERED PUBLIC ACCOUNTING FIRM
| 2024 | 2023 | |||||||
| Audit Fees(1) |
$ | 3,125,000 | $ | 3,275,000 | ||||
| Audit Related Fees(2) |
$ | 449,550 | $ | 4,329,363 | ||||
| Tax Fees(3) |
$ | 27,603 | $ | - | ||||
| All Other Fees(4) |
$ | 1,895 | $ | 23,015 | ||||
| TOTAL |
$ | 3,604,048 | $ | 7,627,378 | ||||
| (1) | Audit Fees include fees incurred for the audit of the Company’s annual financial statements included in the Company’s annual report on Form 10-K, review of financial statements included in the Company’s quarterly reports on Form 10-Q and services that were normally provided by Deloitte & Touche LLP in connection with statutory and regulatory filings or engagements. |
| (2) | Audit Related Fees include fees incurred for assurance and related services that are reasonably related to the performance of the audit or review of the Company’s financial statements but are not otherwise included as Audit Fees. Audit Related Fees for the years ended December 31, 2024 , and December 31, 2023, were primarily for certain carve-out audits, accounting consultations, comfort letter procedures, and other assurance services. Audit related fees decreased in 2024 due to the services provided in connection with audits of the Spin-Off in 2023. |
| (3) | Tax Fees include tax advisory services provided to the Company’s Canadian subsidiary. |
| (4) | All Other Fees are fees incurred for any services not included in the other categories of fees. All Other Fees consisted of accounting research software and facilitation of a subsidiary board meeting. |
The Board unanimously recommends that shareholders vote “FOR” the ratification of the appointment of Deloitte & Touche LLP as the Company’s independent registered public accounting firm for 2025.
2025 PROXY STATEMENT 109
AUDIT COMMITTEE REPORT
Audit Committee Report
The Audit Committee of the Board was established in accordance with Section 3(a)(58)(A) of the Securities Exchange Act of 1934, as amended. The Audit Committee, comprised entirely of non-employee directors, held eight meetings with Deloitte, the independent registered public accountant engaged for the fiscal year ended December 31, 2024, and held eight executive sessions with Deloitte, the Internal Audit Department, and the independent directors during 2024. The Board considered the “independence” and “financial literacy” of each of the Audit Committee members, as such terms are defined under the current listing standards of the New York Stock Exchange and SEC rules and has concluded that each member of its Audit Committee is independent and financially literate in satisfaction of the current requirements of the Listing Standards and the SEC. The Board further concluded that Kerrii B. Anderson and Jeffrey A. Davis are each an “audit committee financial expert” as defined by SEC rules and that Ms. Anderson and Mr. Davis have the “accounting or related financial management expertise” required by the Listing Standards.
The Audit Committee is responsible for the appointment, compensation, and oversight of the independent registered public accountants. The Audit Committee reviewed the performance and fees of Deloitte prior to recommending its appointment for the fiscal year ended December 31, 2024, and met with representatives of Deloitte to discuss the scope and results of the firm’s audit work, including the adequacy of internal controls and the quality of financial reporting, and the selection of the lead audit partner. The Audit Committee reviewed and discussed with management the Company’s audited financial statements and has discussed with Deloitte all matters required to be discussed by the applicable requirements of the Public Company Accounting Oversight Board (the “PCAOB”) and the SEC. The Audit Committee has discussed with Deloitte its independence and has received its written disclosures and certification confirming its independence, as required by the applicable requirements of the PCAOB regarding Deloitte’s communications with the Audit Committee concerning independence.
Management is responsible for the Company’s financial reporting process, including its system of internal controls, and for the preparation of consolidated financial statements in accordance with generally accepted accounting principles. The Company’s internal auditors are responsible to the Audit Committee for testing the integrity of the financial accounting and reporting control systems and such other matters as the Audit Committee and the Board determine. The Company’s independent registered public accountant is responsible for auditing the Company’s financial statements. The Audit Committee oversees the Company’s financial and accounting functions, controls, reporting processes, and audits on behalf of the Board in accordance with the Audit Committee’s written charter. The Audit Committee is responsible for providing independent, objective oversight of the integrity and quality of the Company’s consolidated financial statements, but it is not responsible for conducting audits, determining that the Company’s financial statements are complete, accurate and in accordance with GAAP, conducting investigations, resolving disagreements on financial reporting matters, if any, between management and the independent registered public accountants, or ensuring compliance with laws and regulations and the Company’s Code of Conduct or accounting reviews or procedures. In fulfilling its oversight responsibilities, the Audit Committee reviewed with management and the Company’s internal auditors the Company’s audited consolidated financial statements as of and for the fiscal year ended December 31, 2024, and discussed with management and the Company’s internal auditors the quality, not just the acceptability, of the accounting principles and policies as applied in the Company’s financial reporting, the reasonableness of significant judgments and accounting estimates, and the clarity and completeness of disclosures in the consolidated financial statements. The Audit Committee, Deloitte, and the Company’s internal auditors had full access to one another, including regular meetings without management present. Based on the reviews and discussions referenced above, the Audit Committee recommended to the Board that the audited financial statements be included in the Company’s Annual Report on Form 10-K for the year ended December 31, 2024 for filing with the SEC.
As a part of its duties, the Audit Committee also considers whether the provision of services other than audit services by the independent registered public accountant is compatible with maintaining the accountants’ independence. The Audit Committee considered the compatibility of the non-audit-related services performed by Deloitte and the related non-audit fees and determined that the registered public accounting firm’s independence has been maintained.
The Audit Committee appointed Deloitte as the Company’s independent registered public accounting firm for the fiscal year ending December 31, 2025. See “Proposal Five - Ratification of Independent Registered Public Accounting Firm.”
THE AUDIT COMMITTEE
Jeffrey A. Davis, Chair
Kerrii B. Anderson
D. Gary Gilliland
Kirsten M. Kliphouse
110 LABCORP HOLDINGS INC.
SECURITY OWNERSHIP OF CERTAIN BENEFICIAL HOLDERS AND MANAGEMENT
Security Ownership of Certain
Beneficial Holders and Management
The following table sets forth as of March 20, 2025, except as otherwise indicated below, the total number of shares of Common Stock beneficially owned, and the percent so owned, by (i) each director and director nominee of the Company; (ii) each person known to the Company to be the beneficial owner of more than five percent of the outstanding Common Stock; (iii) the individuals identified as the NEOs in the “Summary Compensation Table” set forth above; and (iv) all current directors and executive officers as a group. The number of shares owned are those “beneficially owned,” as determined under the rules of the SEC, and such information is not necessarily indicative of beneficial ownership for any other purpose. Under such rules, beneficial ownership includes any shares as to which a person has sole or shared voting power or investment power and any shares of Common Stock which the person has the right to acquire within 60 days through the exercise of any option, warrant or right, through conversion of any security, or pursuant to the automatic termination of power of attorney or revocation of trust, discretionary account, or similar arrangement. Except as otherwise indicated below, the persons named in the table have sole voting and investment power with respect to the shares beneficially owned by them as set forth opposite their respective names. Fractional shares have been rounded down to the nearest whole share. As of March 20, 2025, there were 83,668,573 shares of Common Stock outstanding.
| Beneficial Owner |
Amount and Nature of Beneficial Ownership of Common Stock |
Percent of Class | ||||||||
| BLACKROCK, INC. 50 Hudson Yards New York, NY 10001 |
9,151,775 | (1) | 10.94 | % | ||||||
| THE VANGUARD GROUP, INC. 100 Vanguard Boulevard Malvern, PA 19355 |
9,745,265 | (2) | 11.65 | % | ||||||
| ADAM H. SCHECHTER |
367,646 | (3,5) | * | |||||||
| KERRII B. ANDERSON |
13,166 | (4) | * | |||||||
| BRIAN J. CAVENEY |
65,459 | (3,5) | * | |||||||
| JEFFREY A. DAVIS |
4,563 | * | ||||||||
| GLENN A. EISENBERG |
55,926 | (3,5) | * | |||||||
| D. GARY GILLILAND |
8,656 | * | ||||||||
| ANITA Z. GRAHAM |
3,980 | (3) | * | |||||||
| KIRSTEN M. KLIPHOUSE |
2,263 | * | ||||||||
| GARHENG KONG |
12,842 | * | ||||||||
| PETER M. NEUPERT |
12,887 | * | ||||||||
| RICHELLE P. PARHAM |
9,478 | * | ||||||||
| PAUL B. ROTHMAN |
1,674 | * | ||||||||
| MARK S. SCHROEDER |
37,712 | (3,5) | * | |||||||
| JULIA A. WANG |
42,278 | (3) | ||||||||
| KATHRYN E. WENGEL |
3,236 | * | ||||||||
| ALL DIRECTORS AND EXECUTIVE OFFICERS AS A GROUP (21 PERSONS) |
703,724 | (3,4,5) | * | |||||||
| * | Less than 1% |
| (1) | As reported on Schedule 13G/A filed with the SEC on October 18, 2024, on behalf of BlackRock, Inc. (“BlackRock”). BlackRock is a parent holding company or control person in accordance with Rule 13d-1(b)(1)(ii)(G) of the Exchange Act with beneficial ownership of the above listed shares. BlackRock has sole voting power with respect to 8,499,568 shares and sole dispositive power of 9,151,775 shares. |
| (2) | As reported on Schedule 13G/A filed with the SEC on February 13, 2024, on behalf of The Vanguard Group, Inc. (“Vanguard”). Vanguard is a registered investment advisor with beneficial ownership of the above listed shares. Vanguard has shared voting power with respect to 108,648 shares, sole dispositive power with respect to 9,382,041 shares, and shared dispositive power with respect to 363,224 shares. |
2025 PROXY STATEMENT 111
SECURITY OWNERSHIP OF CERTAIN BENEFICIAL HOLDERS AND MANAGEMENT
| (3) | Beneficial ownership by directors, the NEOs and current executive officers of the Company includes shares of Common Stock that such individuals have the right to acquire upon the exercise of options that either are vested or that may vest within 60 days of March 20, 2025. The number of shares of Common Stock included in the table as beneficially owned which are subject to such options is as follows: Dr. Caveney – 31,284; Mr. Eisenberg – 14,376; Ms. Graham – 3,230; Mr. Schechter – 248,995; Mr. Schroeder – 27,912; and all directors and Executive Officers as a group – 385,433. |
| (4) | Includes 144 shares held in each of two separate trusts for the benefit of Ms. Anderson’s two children and for which the trustee is Ms. Anderson’s spouse. |
| (5) | Includes performance shares related to the 2022 Performance Award that vested on March 27, 2025. The number of performance shares included in the table is as follows: Dr. Caveney – 4,840; Mr. Eisenberg – 8,305; Mr. Schechter – 30,469; Mr. Schroeder – 4,840; and all Executive Officers as a group – 59,118. |
Delinquent Section 16(a) Reports
Section 16(a) of the Exchange Act requires the Company’s executive officers, directors, and persons who own more than ten percent of the Company’s equity securities to file reports on ownership and changes in ownership with the SEC and the securities exchanges on which its equity securities are registered. Additionally, SEC regulations require that the Company identify in its proxy statements any persons for whom one of the referenced reports was not filed on a timely basis during the most recent fiscal year or prior fiscal years. To the Company’s knowledge, based solely on a review of reports furnished to it by reporting persons, all Section 16(a) filing requirements applicable to its executive officers, directors, and more than ten percent beneficial owners were timely satisfied, except for a Form 4 in respect of the gift of 351 shares of common stock of the Company to a donor advised fund by Mr. Wilkinson on August 1, 2022, which was inadvertently filed late.
112 LABCORP HOLDINGS INC.
OTHER MATTERS
Other Matters
Shareholder Proposals and Director Nominations for 2026 Annual Meeting
Shareholder Proposals
Under the rules and regulations of the SEC as currently in effect, shareholders may submit proposals to the Company for inclusion in the Company’s proxy materials for the 2026 Annual Meeting of Shareholders. For a proposal to be considered for inclusion in the proxy materials, the shareholder must satisfy the following requirements, in addition to the requirements set forth in SEC Rule 14a-8:
| • | the proposal must be submitted in writing to the attention of Sandra D. van der Vaart, Secretary, Labcorp Holdings Inc., 358 South Main Street, Burlington, North Carolina 27215; |
| • | the proposal must be received no later than 120 days before the anniversary date of the distribution of this Proxy Statement (i.e., December 5, 2025); and |
| • | the proposal must include the name and address of the shareholder, the number of shares of Common Stock held of record or beneficially by the shareholder, the dates when the shares were acquired, documentary support for a claim of beneficial ownership and statement that the shareholder intends to continue to hold the shares through the date of the 2026 Annual Meeting. |
Holders of Common Stock who wish to have proposals submitted for inclusion in the Company’s proxy materials for future meetings of shareholders should consult the applicable rules and regulations of the SEC with respect to such proposals, including the permissible number and length of proposals and other matters governed by such rules and regulations, and should also consult the Company’s By-Laws.
Under the Company’s By-Laws, shareholders may also bring business before the 2026 Annual Meeting of Shareholders without submitting a proposal for inclusion in the Company’s proxy materials for the 2026 Annual Meeting, by providing timely notice thereof to Sandra D. van der Vaart, Secretary, Labcorp Holdings Inc., 358 South Main Street, Burlington, North Carolina 27215. The notice must be received no earlier than the 120th day prior to the anniversary date of the 2025 Annual Meeting (i.e., January 15, 2026) and no later than the 60th day prior to the anniversary date of the 2025 Annual Meeting (i.e., March 16, 2026). Shareholders who wish to do so should consult the Company’s By-Laws for additional information about the notice requirements and procedures and related matters.
Director Nominations
Shareholders may also suggest individuals to be considered by the Board as potential nominees for election to the Board. A shareholder may submit an individual for consideration by the Board of Directors in connection with the 2026 Annual Meeting of Shareholders by providing certain information as set forth in the By-Laws, in writing, to the Corporate Secretary of the Company at 358 South Main Street, Burlington, North Carolina 27215. These suggestions for the 2026 Annual Meeting must be received no earlier than the 120th day prior to the anniversary date of the 2025 Annual Meeting (i.e., January 15, 2026) and no later than the 60th day prior to the anniversary date of the 2025 Annual Meeting (i.e., March 16, 2026).
Under the Company’s proxy access by-law, eligible shareholders also may submit their own nominations to the Board to be included in the Company’s Proxy Statement for the 2026 Annual Meeting of Shareholders. The By-Laws permit a shareholder, or a group of up to 20 shareholders, owning three percent or more of the Company’s outstanding Common Stock continuously for at least three years, to nominate and have included in the Company’s proxy materials persons for election to the Board constituting up to 20% of the Board, provided that the shareholder(s) and the nominee(s) satisfy certain requirements specified in the By-Laws. For a shareholder nominee to be included in the Company’s Proxy Statement for the 2026 Annual Meeting of Shareholders under the proxy access by-law, the information required by the By-Laws must be received by the Corporate Secretary of the Company at the address provided above no earlier than the close of business on the 150th day prior to the anniversary date of the distribution of this Proxy Statement (i.e., November 5, 2025) and no later than the close of business on the 120th day prior to the anniversary date of the distribution of this Proxy Statement (i.e., December 5, 2025).
2025 PROXY STATEMENT 113
OTHER MATTERS
In addition to satisfying the foregoing advance notice requirements under our bylaws, to comply with the universal proxy rules under the Securities Exchange Act of 1934, as amended, shareholders who intend to solicit proxies in support of director nominees other than the Company’s nominees must provide notice that sets forth the information required by Rule 14a-19 under the Securities Exchange Act of 1934, as amended, no later than March 15, 2026.
The By-Laws may be obtained free of charge by writing to the Company’s Corporate Secretary and are included as Exhibit 3.2 to the 2024 Annual Report.
Householding
As permitted by the Exchange Act, the Company has adopted a procedure approved by the SEC called “householding.” Under this procedure, shareholders of record who have the same address and last name and do not participate in electronic delivery of proxy materials will receive only one copy of the Notice, this Proxy Statement, and the 2024 Annual Report unless one or more of these shareholders provides notification of their desire to receive individual copies. This procedure will reduce the Company’s printing costs and postage fees. Shareholders who participate in householding will continue to receive separate proxy cards. We will promptly deliver a separate copy of the proxy materials to such shareholders upon receipt of a written or oral request to our Corporate Secretary at 358 South Main Street, Burlington, North Carolina 27215 or by calling (336) 229-1127.
If you and other shareholders of record with whom you share an address currently receive multiple copies of annual reports and/or proxy statements, or if you hold stock in more than one account and, in either case, you wish to receive only a single copy of notices, annual reports or proxy statements for your household, please contact Broadridge Householding Department at 51 Mercedes Way, Edgewood, NY 11717 or by telephone at 1-866-540-7095 with the names in which all accounts are registered.
Beneficial shareholders, or shareholders who hold shares in “street name”, can request information about householding from their banks, brokers or other holders of record.
Additional Information
A copy of the 2024 Annual Report and this Proxy Statement has been posted on the Internet, each of which is accessible by following the instructions in the Notice. The 2024 Annual Report is not incorporated into this Proxy Statement and is not considered proxy-soliciting materials.
The Company filed its 2024 Annual Report with the SEC on February 25, 2025. The Company will mail without charge, upon written request, a copy of the 2024 Annual Report, excluding exhibits. Please send a written request for a copy to the Secretary, Labcorp Holdings Inc., 358 South Main Street, Burlington, North Carolina 27215, or access these materials on the Investors Relations page of the Company’s website at www.Labcorp.com.
By Order of the Board of Directors
Sandra D. van der Vaart
Secretary
April 4, 2025
114 LABCORP HOLDINGS INC.
USE OF NON-GAAP FINANCIAL MEASURES
Use of Non-GAAP Financial Measures
The Company has provided in this Proxy Statement “adjusted” financial information that has not been prepared in accordance with GAAP, including adjusted operating income. The Company believes that adjusted operating income is useful to investors as a supplement to GAAP measures in evaluating the Company’s operational performance. The Company further believes that the use of this non-GAAP financial measure provides an additional tool for investors in evaluating operating results and trends, and growth and shareholder returns, as well as in comparing the Company’s financial results with the financial results of other companies. Furthermore, adjusted operating income is an integral part of our compensation program and it is helpful in understanding the compensation of our NEOs. The Company notes that this adjusted measure may be different from and not directly comparable to the measures presented by other companies.
The table below sets forth the reconciliation of GAAP financial measures to non-GAAP financial measures.
(Dollars in millions)
| Year Ended December 31, | ||||||||||||||||||||
| 2024 | 2023 | 2022 | 2021 | 2020 | ||||||||||||||||
| Operating Income |
$ | 1,086.7 | $ | 725.6 | $ | 1,436.5 | $ | 3,259.5 | $ | 2,445.4 | ||||||||||
| Amortization of intangibles and other assets(a) |
256.4 | 219.8 | 193.6 | 369.6 | 275.4 | |||||||||||||||
| Restructuring and other charges(b) |
46.0 | 49.1 | 54.0 | 43.1 | 40.6 | |||||||||||||||
| Acquisition and disposition-related costs(c) |
146.4 | 56.0 | 63.7 | 28.1 | 30.2 | |||||||||||||||
| Launchpad costs(d) |
65.7 | - | - | - | ||||||||||||||||
| Spin off transaction costs(e) |
- | 94.1 | 6.5 | - | 1.3 | |||||||||||||||
| COVID-19 related costs(f) |
- | 59.6 | 27.1 | 71.9 | 14.6 | |||||||||||||||
| Asset impairments(g) |
5.3 | 349.0 | 261.7 | - | 63.9 | |||||||||||||||
| Retention bonuses(h) |
- | - | - | 18.2 | 462.1 | |||||||||||||||
| Customer and vendor cyber-event costs(i) |
24.1 | - | - | - | - | |||||||||||||||
| TSA reimbursement(j) |
80.0 | 46.1 | - | - | - | |||||||||||||||
| Other |
86.4 | 46.1 | 36.6 | - | - | |||||||||||||||
| CDCS not included in discontinued operations(k) |
- | 69.5 | 92.9 | 40.7 | (1.6 | ) | ||||||||||||||
| Adjusted operating income |
$ | 1,797.0 | $ | 1,714.9 | $ | 2,172.6 | $ | 3,831.1 | $ | 3,331.9 | ||||||||||
| (a) | Amortization of intangible assets acquired as part of business acquisitions. |
| (b) | Restructuring and other charges represent amounts incurred in connection with the elimination of redundant positions and facilities within the organization in connection with our LaunchPad initiatives, the Spin-Off, and acquisitions or dispositions of businesses by the Company. |
| (c) | Acquisition and disposition-related costs include due-diligence legal and advisory fees, retention bonuses, impact of delayed contract or license transfers, and other integration or disposition related activities. |
| (d) | LaunchPad costs include non-capitalized costs associated with the implementation of systems, consolidation of processes, and consulting costs incurred as part of various business process improvement initiatives. |
| (e) | The company incurred various costs to prepare for the Spin-Off and reorganization of the remaining Labcorp business. |
| (f) | Costs of incremental operating expenses incurred as a result of the COVID-19 pandemic. |
| (g) | Asset impairments relate primarily to goodwill within the early development reporting unit and other assets deemed impaired. |
| (h) | As a result of labor market conditions, the Company implemented a targeted retention program within the Drug Development segment for a select group of positions experiencing higher than normal turnover. |
| (i) | The Company incurred cost and additional collection reserves as the result of customer and vendor cyber events. |
| (j) | Represents transition services fees charged to Fortrea related to administrative and IT systems support. The costs to provide these services are included in operating income but the service fees are included in other income. |
| (k) | These adjustments remove the impact of the CDCS business pursuant to the Spin-Off. |
2025 PROXY STATEMENT 115
ANNEX A
LABCORP HOLDINGS INC.
2025 OMNIBUS INCENTIVE PLAN
ANNEX A
TABLE OF CONTENTS
2025 PROXY STATEMENT i
ANNEX A
ii LABCORP HOLDINGS INC.
ANNEX A
LABCORP HOLDINGS INC.
2025 OMNIBUS INCENTIVE PLAN
| 1. | PURPOSE |
The Plan is intended to (a) provide eligible individuals with an incentive to contribute to the success of the Company and to operate and manage the Company’s business in a manner that will provide for the Company’s long-term growth and profitability and that will benefit its shareholders and other important stakeholders, including its employees and customers, and (b) provide a means of recruiting, rewarding, and retaining key personnel. To this end, the Plan provides for the grant of Awards of Options, Stock Appreciation Rights, Restricted Stock, Restricted Stock Units, Deferred Stock Units, Unrestricted Stock, Dividend Equivalent Rights, Performance Shares and other Performance-Based Awards, Other Equity-Based Awards, and cash bonus awards. Any of these Awards may, but need not, be made as performance incentives to reward the holders of such Awards for the achievement of performance goals in accordance with the terms of the Plan. Options granted under the Plan may be Non-qualified Stock Options or Incentive Stock Options, as provided herein.
| 2. | DEFINITIONS |
For purposes of interpreting the Plan documents, including the Plan and Award Agreements, the following capitalized terms shall have the meanings specified below, unless the context clearly indicates otherwise:
2.1 “Affiliate” shall mean any Person that controls, is controlled by, or is under common control with the Company within the meaning of Rule 405 of Regulation C under the Securities Act, including any Subsidiary. For purposes of grants of Options or Stock Appreciation Rights, an entity may not be considered an Affiliate unless the Company holds a Controlling Interest in such entity.
2.2 “Applicable Laws” shall mean the legal requirements relating to the Plan and the Awards under (a) applicable provisions of the Code, the Securities Act, the Exchange Act, any rules or regulations thereunder, and any other laws, rules, regulations, and government orders of any jurisdiction applicable to the Company or its Affiliates, (b) applicable provisions of the corporate, securities, tax, and other laws, rules, regulations, and government orders of any jurisdiction applicable to Awards granted to residents thereof, and (c) the rules of any Stock Exchange or Securities Market on which the Stock is listed or publicly traded.
2.3 “Award” shall mean a grant under the Plan of an Option, a Stock Appreciation Right, Restricted Stock, a Restricted Stock Unit, a Deferred Stock Unit, Unrestricted Stock, a Dividend Equivalent Right, a Performance Share or other Performance-Based Award, an Other Equity-Based Award, or cash.
2.4 “Award Agreement” shall mean the written agreement, in such written, electronic, or other form as determined by the Committee, between the Company and a Grantee that evidences and sets forth the terms and conditions of an Award.
2.5 “Beneficial Owner” shall have the meaning set forth in Rule 13d-3 under the Exchange Act.
2.6 “Benefit Arrangement” shall mean any formal or informal plan or other arrangement for the direct or indirect provision of compensation to a Grantee (including groups or classes of Grantees or beneficiaries of which the Grantee is a member), whether or not such compensation is deferred, is in cash, or is in the form of a benefit to or for the Grantee.
2.7 “Board” shall mean the Board of Directors of the Company.
2.8 “Cause” shall have the meaning set forth in an applicable agreement between a Grantee and the Company or an Affiliate, and in the absence of any such agreement, shall mean, with respect to any Grantee and as determined by the Committee, (a) gross negligence or willful misconduct in connection with the performance of duties; (b) conviction of, or pleading guilty or nolo contendere to, a criminal offense (other than minor traffic offenses); or (c) material breach of any term of any employment, consulting or other services, confidentiality, intellectual property, or non-competition agreements, if any, between such Grantee and the Company or an Affiliate. Any determination by the Committee regarding whether an event constituting Cause shall have occurred shall be final, binding, and conclusive.
2.9 “Capital Stock” shall mean, with respect to any Person, any and all shares, interests, participations, or other equivalents (however designated, whether voting or non-voting) in equity of such Person, whether outstanding on the Effective Date or issued thereafter, including, without limitation, all shares of Stock.
2.10 “Change in Control” shall mean, subject to Section 18.11, the occurrence of any of the following:
(a) Any transaction (including without limitation a merger or reorganization in which the Company is the surviving entity) which results in any Person (other than any employee benefit plan (or related trust) of the Company) owning thirty percent (30%) or more of
2025 PROXY STATEMENT A-1
ANNEX A
the combined voting power of all classes of Voting Stock; excluding, however, the following: (1) any acquisition directly from the Company, other than as a result of the exercise of a conversion privilege, (2) any repurchase by the Company, (3) any acquisition by any employee benefit plan (or related trust) of the Company or any entity controlled by the Company, or (4) any acquisition pursuant to a transaction described in Section 2.10(c)(i), (ii) or (iii);
(b) Individuals who constitute the Board on the Effective Date (the “Incumbent Board”) cease for any reason to constitute at least a majority thereof, provided that any Person becoming a director subsequent to the date hereof whose election was approved by a vote of at least three-quarters of the directors comprising the Incumbent Board, or whose nomination for election by the Company’s shareholders was approved by the Incumbent Board, shall be for purposes of this clause (b), considered as though he or she were a member of the Incumbent Board;
(c) The Company consolidates with, or merges with or into, any Person, or any Person consolidates with, or merges with or into, the Company (regardless of whether the Company is the surviving Person), other than any such transaction in which (i) all or substantially all of the Prior Shareholders own directly or indirectly at least a majority of the voting power of the Voting Stock of the surviving Person in such reorganization, merger, or consolidation transaction immediately after such transaction, (ii) no Person (other than the Company, any employee benefit plan (or related trust) of the Company or such corporation resulting from such reorganization, merger or consolidation) will beneficially own, directly or indirectly, 30% or more of the combined voting power of the Voting Stock of the surviving Person in such reorganization, merger or consolidation, except to the extent such ownership derives from ownership that existed prior to such reorganization, merger or consolidation, and (iii) individuals who were members of the Board immediately prior to such reorganization, consolidation or merger will constitute at least a majority of the members of the board of directors of the surviving Person resulting from such reorganization, merger or consolidation;
(d) The dissolution or liquidation of the Company; or
(e) Sale of substantially all of the assets of the Company to another Person.
The Board shall have full and final authority, in its sole discretion, to determine conclusively whether a Change in Control has occurred pursuant to the above definition, the date of the occurrence of such Change in Control, and any incidental matters relating thereto.
2.11 “Code” shall mean the Internal Revenue Code of 1986, as amended, as now in effect or as hereafter amended, and any successor thereto. References in the Plan to any Code Section shall be deemed to include, as applicable, regulations and guidance promulgated under such Code Section.
2.12 “Committee” shall mean a committee of, and designated from time to time by resolution of, the Board, which shall be constituted as provided in Section 3.1.2 and Section 3.1.3 (or, if no Committee has been so designated, the Board).
2.13 “Company” shall mean Labcorp Holdings Inc. and any successor thereto.
2.14 “Controlling Interest” shall have the meaning set forth in Treasury Regulation Section 1.414(c)-2(b)(2)(i); provided that (a) except as specified in clause (b) below, an interest of “at least 50 percent” shall be used instead of an interest of “at least 80 percent” in each case where “at least 80 percent” appears in Treasury Regulation Section 1.414(c)-2(b)(2)(i), and (b) where a grant of Options or Stock Appreciation Rights is based upon a legitimate business criterion, an interest of “at least 20 percent” shall be used instead of an interest of “at least 80 percent” in each case where “at least 80 percent” appears in Treasury Regulation Section 1.414(c)-2(b)(2)(i).
2.15 “Deferred Stock Unit” shall mean a Restricted Stock Unit, the terms of which provide for delivery of the underlying shares of Stock, cash, or a combination thereof subsequent to the date of vesting, at a time or times consistent with the requirements of Code Section 409A.
2.16 “Disability” shall mean the inability of a Grantee to perform each of the essential duties of such Grantee’s position by reason of a medically determinable physical or mental impairment which is potentially permanent in character or which can be expected to last for a continuous period of not less than twelve (12) months; provided that, with respect to rules regarding the expiration of an Incentive Stock Option following termination of a Grantee’s Service, Disability shall mean the inability of such Grantee to engage in any substantial gainful activity by reason of a medically determinable physical or mental impairment which can be expected to result in death or which has lasted or can be expected to last for a continuous period of not less than twelve (12) months.
2.17 “Disqualified Individual” shall have the meaning set forth in Code Section 280G(c).
2.18 “Dividend Equivalent Right” shall mean a right, granted to a Grantee pursuant to Article 12, entitling the Grantee thereof to receive, or to receive credits for the future payment of, cash, Stock, other Awards, or other property equal in value to dividend payments or distributions, or other periodic payments, declared or paid with respect to a number of shares of Stock specified in such Dividend Equivalent Right (or other Award to which such Dividend Equivalent Right relates) as if such shares of Stock had been issued to and held by the Grantee of such Dividend Equivalent Right as of the record date.
A-2 LABCORP HOLDINGS INC.
ANNEX A
2.19 “Effective Date” shall mean May 15, 2025, subject to approval of the Plan by the Company’s shareholders on such date, the Plan having been adopted by the Board on March 27, 2025.
2.20 “Employee” shall mean, as of any date of determination, an employee (including an officer) of the Company or an Affiliate.
2.21 “Exchange Act” shall mean the Securities Exchange Act of 1934, as amended, as now in effect or as hereafter amended, and any successor thereto.
2.22 “Fair Market Value” shall mean the fair market value of a share of Stock for purposes of the Plan, which shall be, as of any date of determination:
(a) If on such date the shares of Stock are listed on a Stock Exchange, or are publicly traded on another Securities Market, the Fair Market Value of a share of Stock shall be the closing price of the Stock as reported on such Stock Exchange or such Securities Market (provided that, if there is more than one such Stock Exchange or Securities Market, the Committee shall designate the appropriate Stock Exchange or Securities Market for purposes of the Fair Market Value determination). If there is no such reported closing price on such date, the Fair Market Value of a share of Stock shall be the closing price of the Stock on the next preceding day on which any sale of Stock shall have been reported on such Stock Exchange or such Securities Market.
(b) If on such date the shares of Stock are not listed on a Stock Exchange or publicly traded on a Securities Market, the Fair Market Value of a share of Stock shall be the value of the Stock as determined by the Committee by the reasonable application of a reasonable valuation method, in a manner consistent with Code Section 409A.
Notwithstanding this Section 2.22 or Section 18.3, for purposes of determining taxable income and the amount of the related tax withholding obligation pursuant to Section 18.3, the Fair Market Value shall be determined by the Committee in good faith using any reasonable method as it deems appropriate, to be applied consistently with respect to Grantees; provided, further, that the Committee shall determine the Fair Market Value of shares of Stock for tax withholding obligations due in connection with sales, by or on behalf of a Grantee, of such shares of Stock subject to an Award to pay the Option Price, SAR Price, and/or any tax withholding obligation on the same date on which such shares may first be sold pursuant to the terms of the applicable Award Agreement (including broker-assisted cashless exercises of Options and Stock Appreciation Rights, as described in Section 14.3, and sell-to-cover transactions) in any manner consistent with applicable provisions of the Code, including but not limited to using the sale price of such shares on such date (or if sales of such shares are effectuated at more than one sale price, the weighted average sale price of such shares on such date) as the Fair Market Value of such shares, so long as such Grantee has provided the Company, or its designee or agent, with advance written notice of such sale.
2.23 “Family Member” shall mean, with respect to any Grantee as of any date of determination, (a) a Person who is a spouse, former spouse, child, stepchild, grandchild, parent, stepparent, grandparent, niece, nephew, mother-in-law, father-in-law, son-in-law, daughter-in-law, brother, sister, brother-in-law, or sister-in-law, including adoptive relationships, of such Grantee, (b) any Person sharing such Grantee’s household (other than a tenant or employee), (c) a trust in which any one or more of the Persons specified in clauses (a) and (b) above (and such Grantee) own more than fifty percent (50%) of the beneficial interest, (d) a foundation in which any one or more of the Persons specified in clauses (a) and (b) above (and such Grantee) control the management of assets, and (e) any other entity in which one or more of the Persons specified in clauses (a) and (b) above (and such Grantee) own more than fifty percent (50%) of the voting interests.
2.24 “Grant Date” shall mean, as determined by the Committee, the latest to occur of (a) the date as of which the Committee approves the Award, (b) the date on which the recipient of an Award first becomes eligible to receive an Award under Article 6 hereof (e.g., in the case of a new hire, the first date on which such new hire performs any Service), or (c) such subsequent date specified by the Committee in the corporate action approving the Award.
2.25 “Grantee” shall mean a Person who receives or holds an Award under the Plan.
2.26 “Incentive Stock Option” shall mean an “incentive stock option” within the meaning of Code Section 422.
2.27 “Non-qualified Stock Option” shall mean an Option that is not an Incentive Stock Option.
2.28 “Non-Employee Director” shall have the meaning set forth in Rule 16b-3 under the Exchange Act.
2.29 “Officer” shall have the meaning set forth in Rule 16a-1(f) under the Exchange Act.
2.30 “Option” shall mean an option to purchase one or more shares of Stock at a specified Option Price awarded to a Grantee pursuant to Article 8.
2.31 “Option Price” shall mean the per share exercise price for shares of Stock subject to an Option.
2025 PROXY STATEMENT A-3
ANNEX A
2.32 “Other Agreement” shall mean any agreement, contract, or understanding heretofore or hereafter entered into by a Grantee with the Company or an Affiliate, except an agreement, contract, or understanding that expressly addresses Code Section 280G and/or Code Section 4999.
2.33 “Other Equity-Based Award” shall mean an Award representing a right or other interest that may be denominated or payable in, valued in whole or in part by reference to, or otherwise based on or related to Stock, other than an Option, a Stock Appreciation Right, Restricted Stock, a Restricted Stock Unit, a Deferred Stock Unit, Unrestricted Stock, a Dividend Equivalent Right, or a Performance Share.
2.34 “Parachute Payment” shall mean a “parachute payment” within the meaning of Code Section 280G(b)(2).
2.35 “Performance-Based Award” shall mean an Award of Options, Stock Appreciation Rights, Restricted Stock, Restricted Stock Units, Deferred Stock Units, Performance Shares, Other Equity-Based Awards, or cash made subject to the achievement of performance goals (as provided in Article 13) over a Performance Period specified by the Committee.
2.36 “Performance Measures” shall mean measures on which the performance goal or goals under Performance-Based Awards are based.
2.37 “Performance Period” shall mean the period of time, up to ten (10) years, during or over which the performance goals under Performance-Based Awards must be met in order to determine the degree of payout and/or vesting with respect to any such Performance-Based Awards.
2.38 “Performance Shares” shall mean a Performance-Based Award representing a right or other interest that may be denominated or payable in, valued in whole or in part by reference to, or otherwise based on or related to Stock, made subject to the achievement of performance goals (as provided in Article 13) over a Performance Period.
2.39 “Person” shall mean an individual, a corporation, a partnership, a limited liability company, an association, a trust, or any other entity or organization, including a government or political subdivision or an agency or instrumentality thereof; provided that, for purposes of Section 2.10(a), Section 2.10(c) and Section 2.10(d), Person shall have the meaning set forth in Sections 13(d) and 14(d)(2) of the Exchange Act.
2.40 “Plan” shall mean this Labcorp Holdings Inc. 2025 Omnibus Incentive Plan, as it may be further amended from time to time.
2.41 “Prior Plan” shall mean the Labcorp Holdings Inc. Amended and Restated 2016 Omnibus Incentive Plan.
2.42 “Prior Shareholders” shall mean the holders of equity securities that represented one hundred percent (100%) of the Voting Stock of the Company immediately prior to a reorganization, merger, or consolidation involving the Company (or other equity securities into which such equity securities are converted as part of such reorganization, merger, or consolidation transaction).
2.43 “Restricted Period” shall mean a period of time established by the Committee during which an Award of Restricted Stock, Restricted Stock Units, or Deferred Stock Units is subject to restrictions.
2.44 “Restricted Stock” shall mean shares of Stock awarded to a Grantee pursuant to Article 10.
2.45 “Restricted Stock Unit” shall mean a bookkeeping entry representing the equivalent of one (1) share of Stock awarded to a Grantee pursuant to Article 10 that may be settled, subject to the terms and conditions of the applicable Award Agreement, in shares of Stock, cash, or a combination thereof.
2.46 “SAR Price” shall mean the per share exercise price of a SAR.
2.47 “Securities Act” shall mean the Securities Act of 1933, as amended, as now in effect or as hereafter amended, and any successor thereto.
2.48 “Securities Market” shall mean an established securities market.
2.49 “Separation from Service” shall have the meaning set forth in Code Section 409A.
2.50 “Service” shall mean service qualifying a Grantee as a Service Provider to the Company or an Affiliate. Unless otherwise provided in the applicable Award Agreement, a Grantee’s change in position or duties shall not result in interrupted or terminated Service, so long as such Grantee continues to be a Service Provider to the Company or an Affiliate. Subject to the preceding sentence, any determination by the Committee whether a termination of Service shall have occurred for purposes of the Plan shall be final, binding, and conclusive. If a Service Provider’s employment or other Service relationship is with an Affiliate and the applicable entity ceases to be an Affiliate, a termination of Service shall be deemed to have occurred when such entity ceases to be an Affiliate unless the Service Provider transfers his or her employment or other Service relationship to the Company or any other Affiliate.
A-4 LABCORP HOLDINGS INC.
ANNEX A
2.51 “Service Provider” shall mean (a) an Employee or director of the Company or an Affiliate, or (b) a consultant or adviser to the Company or an Affiliate (i) who is a natural person, (ii) who is currently providing bona fide services to the Company or an Affiliate, and (iii) whose services are not in connection with the Company’s sale of securities in a capital-raising transaction and do not directly or indirectly promote or maintain a market for the Company’s Capital Stock.
2.52 “Service Recipient Stock” shall have the meaning set forth in Code Section 409A.
2.53 “Share Limit” shall have the meaning set forth in Section 4.1.
2.54 “Short-Term Deferral Period” shall have the meaning set forth in Code Section 409A.
2.55 “Stock” shall mean the common stock, par value $0.10 per share, of the Company, or any security into which shares of Stock may be changed or for which shares of Stock may be exchanged as provided in Section 16.1.
2.56 “Stock Appreciation Right” or “SAR” shall mean a right granted to a Grantee pursuant to Article 9.
2.57 “Stock Exchange” shall mean the New York Stock Exchange, the NASDAQ Capital Market, the NASDAQ Global Market, the NASDAQ Global Select Market, or another established national or regional stock exchange.
2.58 “Subsidiary” shall mean any corporation (other than the Company) or non-corporate entity with respect to which the Company owns, directly or indirectly, fifty percent (50%) or more of the total combined voting power of all classes of Voting Stock. In addition, any other entity may be designated by the Committee as a Subsidiary, provided that (a) such entity could be considered as a subsidiary according to generally accepted accounting principles in the United States of America and (b) in the case of an Award of Options or Stock Appreciation Rights, such Award would be considered to be granted in respect of Service Recipient Stock under Code Section 409A.
2.59 “Substitute Award” shall mean an Award granted upon assumption of, or in substitution for, outstanding awards previously granted under a compensatory plan of the Company, an Affiliate, or a business entity acquired or to be acquired by the Company or an Affiliate or with which the Company or an Affiliate has combined or will combine.
2.60 “Ten Percent Shareholder” shall mean a natural Person who owns more than ten percent (10%) of the total combined voting power of all classes of Voting Stock of the Company, the Company’s parent (if any), or any of the Company’s Subsidiaries. In determining stock ownership, the attribution rules of Code Section 424(d) shall be applied.
2.61 “Unrestricted Stock” shall mean Stock that is free of any restrictions.
2.62 “Voting Stock” shall mean, with respect to any Person, Capital Stock of any class or kind ordinarily having the power to vote for the election of directors, managers, or other voting members of the governing body of such Person.
| 3. | ADMINISTRATION OF THE PLAN |
| 3.1 | Committee. |
| 3.1.1 | Powers and Authorities. |
The Committee shall administer the Plan and shall have such powers and authorities related to the administration of the Plan as are consistent with the Company’s certificate of incorporation and bylaws and Applicable Laws. Without limiting the generality of the foregoing, the Committee shall have full power and authority to take all actions and to make all determinations required or provided for under the Plan, any Award, or any Award Agreement and shall have full power and authority to take all such other actions and to make all such other determinations not inconsistent with the specific terms and provisions of the Plan which the Committee deems to be necessary or appropriate to the administration of the Plan, any Award, or any Award Agreement. For the avoidance of doubt, the Committee reserves the right to accelerate the vesting of all Awards granted under the Plan. All such actions and determinations shall be made by (a) the affirmative vote of a majority of the members of the Committee present at a meeting at which a quorum is present, or (b) the unanimous consent of the members of the Committee executed in writing or evidenced by electronic transmission in accordance with the Company’s certificate of incorporation and bylaws and Applicable Laws. Unless otherwise expressly determined by the Board, the Committee shall have the authority to interpret and construe all provisions of the Plan, any Award, and any Award Agreement, and any such interpretation or construction, and any other determination contemplated to be made under the Plan or any Award Agreement, by the Committee shall be final, binding, and conclusive on all Persons, whether or not expressly provided for in any provision of the Plan, such Award, or such Award Agreement.
In the event that the Plan, any Award, or any Award Agreement provides for any action to be taken by the Board or any determination to be made by the Board, such action may be taken or such determination may be made by the Committee constituted in accordance with this Section 3.1 if the Board has delegated the power and authority to do so to such Committee.
2025 PROXY STATEMENT A-5
ANNEX A
| 3.1.2 | Composition of the Committee. |
The Committee shall be a committee composed of not fewer than two (2) directors of the Company designated by the Board to administer the Plan. Each member of the Committee shall be (a) a Non-Employee Director, and (b) an independent director in accordance with the rules of any Stock Exchange on which the Stock is listed; provided that any action taken by the Committee shall be valid and effective whether or not members of the Committee at the time of such action are later determined not to have satisfied the requirements for membership set forth in this Section 3.1.2 or otherwise provided in any charter of the Committee. Without limiting the generality of the foregoing, the Committee may be the Compensation Committee of the Board or a subcommittee thereof if the Compensation Committee of the Board or such subcommittee satisfies the foregoing requirements.
| 3.1.3 | Other Committees. |
The Board also may appoint one or more committees of the Board, each composed of one or more directors of the Company, which (a) may administer the Plan with respect to Grantees who are not Officers or directors of the Company, (b) may grant Awards under the Plan to such Grantees, and (c) may determine all terms of such Awards, subject, in each case if applicable, to the requirements of Rule 16b-3 under the Exchange Act and the rules of any Stock Exchange or Securities Market on which the Stock is listed or publicly traded.
| 3.1.4 | Delegation by the Committee. |
To the extent permitted by Applicable Laws, the Committee may, by resolution, delegate some or all of its authority with respect to the Plan and Awards to the Chief Executive Officer of the Company and/or any other Employee of the Company designated by the Committee, provided that the Committee may not delegate its authority hereunder (a) to make Awards to directors of the Company, (b) to make Awards to Employees who are (i) Officers, or (ii) Employees of the Company who are delegated authority by the Committee pursuant to this Section 3.1.4, or (c) to interpret the Plan, any Award, or any Award Agreement. Any delegation hereunder shall be subject to the restrictions and limits that the Committee specifies at the time of such delegation or thereafter. Nothing in the Plan shall be construed as obligating the Committee to delegate authority to any Employee of the Company, and the Committee may at any time rescind the authority delegated to an Employee of the Company appointed hereunder and delegate authority to one or more other Employees of the Company. At all times, an Employee of the Company delegated authority pursuant to this Section 3.1.4 shall serve in such capacity at the pleasure of the Committee. Any action undertaken by any such Employee of the Company in accordance with the Committee’s delegation of authority shall have the same force and effect as if undertaken directly by the Committee, and any reference in the Plan to the “Committee” shall, to the extent consistent with the terms and limitations of such delegation, be deemed to include a reference to each such Employee.
| 3.2 | Board. |
The Board, from time to time, may exercise any or all of the powers and authorities related to the administration and implementation of the Plan, as set forth in Section 3.1 and other applicable provisions of the Plan, as the Board shall determine, consistent with the Company’s certificate of incorporation and bylaws and Applicable Laws.
| 3.3 | Terms of Awards. |
| 3.3.1 | Committee Authority. |
Subject to the other terms and conditions of the Plan, the Committee shall have full and final authority to:
(a) designate Grantees;
(b) determine the type or types of Awards to be made to a Grantee;
(c) determine the number of shares of Stock to be subject to an Award or to which an Award relates;
(d) establish the terms and conditions of each Award (including the Option Price, the SAR Price, and the purchase price for applicable Awards; the nature and duration of any restriction or condition (or provision for lapse thereof) relating to the vesting, exercise, transfer, or forfeiture of an Award or the shares of Stock subject thereto; the treatment of an Award in the event of a Change in Control (subject to applicable agreements); and any terms or conditions that may be necessary to qualify Options as Incentive Stock Options);
(e) prescribe the form of each Award Agreement evidencing an Award;
A-6 LABCORP HOLDINGS INC.
ANNEX A
(f) subject to the limitation on repricing in Section 3.4, amend, modify, or supplement the terms of any outstanding Award, which authority shall include the authority, in order to effectuate the purposes of the Plan but without amending the Plan, to make Awards or to modify outstanding Awards made to eligible natural Persons who are foreign nationals or are natural Persons who are employed outside the United States to reflect differences in local law, tax policy, or custom; provided that, notwithstanding the foregoing, no amendment, modification, or supplement of the terms of any outstanding Award shall, without the consent of the Grantee thereof, materially impair such Grantee’s rights under such Award; and
(g) make Substitute Awards.
| 3.3.2 | Forfeiture; Recoupment. |
The Committee may reserve the right in an Award Agreement to cause a forfeiture of the gain realized by a Grantee with respect to an Award thereunder on account of actions taken by, or failed to be taken by, such Grantee in violation or breach of, or in conflict with, any (a) employment agreement, (b) non-competition agreement, (c) agreement prohibiting solicitation of Employees or clients of the Company or an Affiliate, (d) confidentiality obligation with respect to the Company or an Affiliate, (e) Company or Affiliate policy or procedure, (f) other agreement, or (g) other obligation of such Grantee to the Company or an Affiliate, as and to the extent specified in such Award Agreement. If the Grantee of an outstanding Award is an Employee of the Company or an Affiliate and such Grantee’s Service is terminated for Cause, the Committee may annul such Grantee’s outstanding Award as of the date of the Grantee’s termination of Service for Cause.
Any Award granted pursuant to the Plan shall be subject to mandatory repayment by the Grantee to the Company (x) to the extent set forth in this Plan or an Award Agreement or (y) to the extent the Grantee is, or in the future becomes, subject to (1) any Company or Affiliate “clawback” or recoupment policy that is adopted to comply with the requirements of any Applicable Laws or otherwise, or (2) any Applicable Laws which impose mandatory recoupment, under circumstances set forth in such Applicable Laws.
| 3.4 | No Repricing. |
Except in connection with a corporate transaction involving the Company (including, without limitation, any stock dividend, distribution (whether in the form of cash, shares of Stock, other securities, or other property), stock split, extraordinary dividend, recapitalization, Change in Control, reorganization, merger, consolidation, split-up, spin-off, combination, repurchase or exchange of shares of Stock, or other securities or similar transaction), the Company may not: (a) amend the terms of outstanding Options or SARs to reduce the Option Price or SAR Price, as applicable, of such outstanding Options or SARs; (b) cancel outstanding Options or SARs in exchange for or substitution of Options or SARs with an Option Price or SAR Price, as applicable, that is less than the Option Price or SAR Price, as applicable, of the original Options or SARs; or (c) cancel outstanding Options or SARs with an Option Price or SAR Price, as applicable, above the current Fair Market Value in exchange for cash or other securities, in each case, unless such action is subject to and approved by the Company’s shareholders.
| 3.5 | Deferral Arrangement. |
The Committee may permit or require the deferral of any payment pursuant to any Award into a deferred compensation arrangement, subject to such rules and procedures as it may establish, which may include provisions for the payment or crediting of interest or Dividend Equivalent Rights and, in connection therewith, provisions for converting such credits into Deferred Stock Units and for restricting deferrals to comply with hardship distribution rules affecting tax-qualified retirement plans subject to Code Section 401(k)(2)(B)(IV); provided that no Dividend Equivalent Rights may be granted in connection with, or related to, an Award of Options or SARs. Any such deferrals shall be made in a manner that complies with Code Section 409A, including, if applicable, with respect to when a Separation from Service occurs.
| 3.6 | Registration; Share Certificates. |
Notwithstanding any provision of the Plan to the contrary, the ownership of the shares of Stock issued under the Plan may be evidenced in such a manner as the Committee, in its sole discretion, deems appropriate, including by book-entry or direct registration (including transaction advices) or the issuance of one or more share certificates.
2025 PROXY STATEMENT A-7
ANNEX A
| 4. | STOCK SUBJECT TO THE PLAN |
| 4.1 | Number of Shares of Stock Available for Awards. |
Subject to adjustment pursuant to Article 16, the maximum aggregate number of shares of Stock which may be issued pursuant to all Awards under the Plan shall be equal to three million fifty thousand (3,050,000), provided that such number will be reduced by the number of shares of Stock underlying any grants made under the Prior Plan after February 28, 2025 and before the Effective Date (the “Share Limit”). Such shares of Stock may be authorized and unissued shares of Stock, treasury shares of Stock, or any combination of the foregoing, as may be determined from time to time by the Board or by the Committee. Any of the shares of Stock reserved and available for issuance under the Plan may be used for any type of Award under the Plan, provided that no more than three million fifty thousand (3,050,000) of the shares of Stock available for issuance under the Plan shall be available for issuance pursuant to Incentive Stock Options.
| 4.2 | Adjustments in Authorized Shares of Stock. |
In connection with mergers, reorganizations, separations, or other transactions to which Code Section 424(a) applies, the Committee shall have the right to cause the Company to assume awards previously granted under a compensatory plan of another business entity that is a party to such transaction and to grant Substitute Awards under the Plan for such awards. The Share Limit shall neither be increased nor decreased by the number of shares of Stock subject to any such assumed awards and Substitute Awards. Shares available for issuance under a shareholder-approved plan of a business entity that is a party to such transaction (as appropriately adjusted, if necessary, to reflect such transaction) may be used for Awards under the Plan and shall not reduce the number of shares of Stock otherwise available for issuance under the Plan, subject to applicable rules of any Stock Exchange or Securities Market on which the Stock is listed or publicly traded.
| 4.3 | Share Usage. |
(a) Any shares of Stock that are subject to Awards, including shares of Stock acquired through dividend reinvestment pursuant to Article 10, shall be counted against the Share Limit as one (1) share of Stock for every one (1) share of Stock subject to an Award. The number of shares of Stock subject to an Award of stock-settled SARs shall be counted against the Share Limit as one (1) share of Stock for every one (1) share of Stock subject to such Award regardless of the number of shares of Stock actually issued to settle such SARs upon the exercise of the SARs.
(b) If, following the Effective Date, any shares of Stock subject to an Award or to awards outstanding under the Prior Plan are not purchased or are forfeited or expire or otherwise terminate without delivery of any Stock subject thereto or are settled in cash in lieu of shares, then the number of shares of Stock subject to such Award shall be available for making Awards under the Plan on a 1 for 1 basis for each share of Stock not purchased, forfeited, expired or otherwise terminated without delivery of any Stock subject thereto or settled in cash in lieu of shares. Shares of Stock tendered or withheld or subject to an Award (other than an Option or SAR), or to awards (other than options or stock appreciation rights) outstanding under the Prior Plan after the Effective Date, surrendered in connection with the purchase of shares of Stock or deducted or delivered from payment of such Award in connection with the Company’s tax withholding obligations shall again be available for making Awards under the Plan.
(c) The number of shares of Stock available for issuance under the Plan shall not be increased by the number of shares of Stock (i) tendered, withheld, or subject to an Option granted under the Plan surrendered in connection with the payment of the Option Price upon exercise of an Option or in connection with the Company’s tax withholding obligations with respect to Options or stock-settled SARs, (ii) that were not issued upon the net settlement or net exercise of a Stock-settled SAR granted under the Plan, or (iii) purchased by the Company with proceeds from Option exercises.
| 5. | TERM; AMENDMENT, SUSPENSION, AND TERMINATION |
| 5.1 | Term. |
The Plan shall become effective on the Effective Date. Following the Effective Date, no awards shall be made under the Prior Plan. Notwithstanding the foregoing, shares of Stock reserved under the Prior Plan to settle awards, including performance-based awards, which are made under the Prior Plan prior to the Effective Date may be issued and delivered following the Effective Date to settle such awards. The Plan shall terminate on the first to occur of (a) the day before the tenth (10th) anniversary of the Effective Date, (b) the date determined in accordance with Section 5.2, and (c) the date determined in accordance with Section 16.3; provided, however, that Incentive Stock Options may not be granted under the Plan after March 27, 2035. Upon such termination of the Plan, all outstanding Awards shall continue to have full force and effect in accordance with the provisions of the terminated Plan and the applicable Award Agreement (or other documents evidencing such Awards).
A-8 LABCORP HOLDINGS INC.
ANNEX A
| 5.2 | Amendment, Suspension, and Termination. |
The Board may, at any time and from time to time, amend, suspend, or terminate the Plan; provided that, with respect to Awards theretofore granted under the Plan, no amendment, suspension, or termination of the Plan shall, without the consent of the Grantee, materially impair the rights or obligations under any such Award. The effectiveness of any amendment to the Plan shall be contingent on approval of such amendment by the Company’s shareholders to the extent provided by the Board or required by Applicable Laws; provided that no amendment shall be made to the no-repricing provisions of Section 3.4, the Option Pricing provisions of Section 8.1, or the SAR Pricing provisions of Section 9.1 without the approval of the Company’s shareholders.
| 6. | AWARD ELIGIBILITY AND LIMITATIONS |
| 6.1 | Eligible Grantees. |
Subject to this Article 6, Awards may be made under the Plan to (a) any Service Provider, as the Committee shall determine and designate from time to time, and (b) any other individual whose participation in the Plan is determined to be in the best interests of the Company by the Committee.
| 6.2 | Limitation on Shares of Stock Subject to Awards and Cash Awards for Non-Employee Directors |
Subject to adjustment as provided in Article 16, the maximum number of shares of Stock subject to Awards granted during a single fiscal year to any non-employee director, taken together with any cash fees paid to such non-employee director during the fiscal year, shall not exceed $750,000 in total value (calculating the value of any such Awards based on the grant date fair value of such Awards for financial reporting purposes); provided, that the Board may make exceptions to this limit for individual non-employee directors in extraordinary circumstances as the Board may determine in its sole discretion, so long as (x) the aggregate limit does not exceed $1,000,000 in total value during a fiscal year and (y) the non-employee director receiving such additional compensation does not participate in the decision to award such compensation or in other contemporaneous compensation decisions involving non-employee directors; and
| 6.3 | Stand-Alone, Additional, Tandem, and Substitute Awards. |
Subject to Section 3.4, Awards granted under the Plan may, in the discretion of the Committee, be granted either alone or in addition to, in tandem with, or in substitution or exchange for, (a) any other Award, (b) any award granted under another plan of the Company, an Affiliate, or any business entity that has been a party to a transaction with the Company or an Affiliate, or (c) any other right of a Grantee to receive payment from the Company or an Affiliate. Such additional, tandem, exchange, or Substitute Awards may be granted at any time. If an Award is granted in substitution or exchange for another Award, or for an award granted under another plan of the Company, an Affiliate, or any business entity that has been a party to a transaction with the Company or an Affiliate, the Committee shall require the surrender of such other Award or award under such other plan in consideration for the grant of such exchange or Substitute Award. In addition, Awards may be granted in lieu of cash compensation, including in lieu of cash payments under other plans of the Company or an Affiliate. Notwithstanding Section 8.1 and Section 9.1, but subject to Section 3.4, the Option Price of an Option or the SAR Price of a SAR that is a Substitute Award may be less than one hundred percent (100%) of the Fair Market Value of a share of Stock on the original Grant Date; provided that such Option Price or SAR Price is determined in accordance with the principles of Code Section 424 for any Incentive Stock Option and consistent with Code Section 409A for any other Option or SAR.
| 7. | AWARD AGREEMENT |
Each Award granted pursuant to the Plan shall be evidenced by an Award Agreement, which shall be in such form or forms as the Committee shall from time to time determine. Award Agreements utilized under the Plan from time to time or at the same time need not contain similar provisions but shall be consistent with the terms of the Plan. Each Award Agreement evidencing an Award of Options shall specify whether such Options are intended to be Non-qualified Stock Options or Incentive Stock Options, and, in the absence of such specification, such Options shall be deemed to constitute Non-qualified Stock Options. In the event of any inconsistency between the Plan and an Award Agreement, the provisions of the Plan shall control.
| 8. | TERMS AND CONDITIONS OF OPTIONS |
| 8.1 | Option Price. |
The Option Price of each Option shall be fixed by the Committee and stated in the Award Agreement evidencing such Option. Except in the case of Substitute Awards, the Option Price of each Option shall be at least the Fair Market Value of one (1) share of Stock on the Grant
2025 PROXY STATEMENT A-9
ANNEX A
Date; provided that, in the event that a Grantee is a Ten Percent Shareholder, the Option Price of an Option granted to such Grantee that is intended to be an Incentive Stock Option shall be not less than one hundred ten percent (110%) of the Fair Market Value of one (1) share of Stock on the Grant Date. In no case shall the Option Price of any Option be less than the par value of one (1) share of Stock.
| 8.2 | Vesting and Exercisability. |
(a) Subject to Sections 8.3 and 16.3, each Option granted under the Plan shall become vested and/or exercisable at such times and under such conditions as shall be determined by the Committee and stated in the Award Agreement, in another agreement with the Grantee, or otherwise in writing; provided that no Option shall be granted to Grantees who are entitled to overtime under Applicable Laws that will vest or be exercisable within a six (6)-month period starting on the Grant Date.
(b) Notwithstanding Section 8.2(a), other than in the case of Options that are Substitute Awards, (i) the grant, issuance, retention, vesting, and/or exercise, of an Option that is based solely upon performance criteria and level of achievement versus such criteria shall be subject to a performance period of not less than twelve (12) months, and (ii) the grant, issuance, retention, vesting, and/or exercise, of an Option that is based solely upon continued Service and/or the passage of time may not vest or be exercised in full or in part prior to the satisfaction of a one (1) year minimum vesting period. Notwithstanding the foregoing, the Committee may provide for the earlier vesting and/or exercisability under any such Option (i) in the event of the Grantee’s death or Disability, or (ii) in connection with a Change in Control.
(c) Notwithstanding the limitations in Section 8.2(b) and Section 9.2(b), up to five percent (5%) of the Share Limit may be granted pursuant to the Plan without being subject to the limitations in Section 8.2(b) and Section 9.2(b). The foregoing five percent (5%) share issuance limit shall be subject to adjustment consistent with the adjustment provisions of Section 16 and the share usage rules of Section 4.3.
| 8.3 | Term. |
Each Option granted under the Plan shall terminate, and all rights to purchase shares of Stock thereunder shall cease, on the day before the tenth (10th) anniversary of the Grant Date of such Option, or under such circumstances and on such date prior thereto as is set forth in the Plan or as may be fixed by the Committee and stated in the Award Agreement relating to such Option; provided that, in the event that the Grantee is a Ten Percent Shareholder, an Option granted to such Grantee that is intended to be an Incentive Stock Option shall not be exercisable after the day before the fifth (5th) anniversary of the Grant Date of such Option.
| 8.4 | Termination of Service. |
Each Award Agreement with respect to the grant of an Option shall set forth the extent to which the Grantee thereof, if at all, shall have the right to exercise such Option following termination of such Grantee’s Service. Such provisions shall be determined in the sole discretion of the Committee, need not be uniform among all Options issued pursuant to the Plan, and may reflect distinctions based on the reasons for termination of Service.
| 8.5 | Limitations on Exercise of Option. |
Notwithstanding any provision of the Plan to the contrary, in no event may any Option be exercised, in whole or in part, after the occurrence of an event referred to in Article 16 which results in the termination of such Option.
| 8.6 | Method of Exercise. |
Subject to the terms of Article 14 and Section 18.3, an Option that is exercisable may be exercised by the Grantee’s delivery to the Company or its designee or agent of notice of exercise on any business day on the form specified by the Company and in accordance with any additional procedures specified by the Committee. Such notice shall specify the number of shares of Stock with respect to which such Option is being exercised and shall be accompanied by payment in full of the Option Price of the shares of Stock for which such Option is being exercised, plus the amount (if any) of federal and/or other taxes which the Company may, in its judgment, be required to withhold with respect to the exercise of such Option.
A-10 LABCORP HOLDINGS INC.
ANNEX A
| 8.7 | Rights of Holders of Options. |
Unless otherwise stated in the applicable Award Agreement, a Grantee or other Person holding or exercising an Option shall have none of the rights of a shareholder of the Company (for example, the right to receive cash or dividend payments or distributions attributable to the shares of Stock subject to such Option, to direct the voting of the shares of Stock subject to such Option, or to receive notice of any meeting of the Company’s shareholders) until the shares of Stock subject thereto are fully paid and issued to such Grantee or other Person. Except as provided in Article 16, no adjustment shall be made for dividends, distributions, or other rights with respect to any shares of Stock subject to an Option for which the record date is prior to the date of issuance of such shares of Stock.
| 8.8 | Delivery of Stock. |
Promptly after the exercise of an Option by a Grantee and the payment in full of the Option Price with respect thereto, such Grantee shall be entitled to receive such evidence of such Grantee’s ownership of the shares of Stock subject to such Option as shall be consistent with Section 3.6.
| 8.9 | Transferability of Options. |
Except as provided in Section 8.10, during the lifetime of a Grantee of an Option, only such Grantee (or, in the event of such Grantee’s legal incapacity or incompetency, such Grantee’s guardian or legal representative) may exercise such Option. Except as provided in Section 8.10, no Option shall be assignable or transferable by the Grantee to whom it is granted, other than by will or the laws of descent and distribution.
| 8.10 | Family Transfers. |
If authorized in the applicable Award Agreement or by the Committee, in its sole discretion, a Grantee may transfer, not for value, all or part of an Option which is not an Incentive Stock Option to any Family Member. For the purpose of this Section 8.10, a transfer “not for value” is a transfer which is (a) a gift, (b) a transfer under a domestic relations order in settlement of marital property rights, or (c) unless Applicable Laws do not permit such transfer, a transfer to an entity in which more than fifty percent (50%) of the voting interests are owned by Family Members (and/or the Grantee) in exchange for an interest in such entity. Following a transfer under this Section 8.10, any such Option shall continue to be subject to the same terms and conditions as were applicable immediately prior to such transfer. Subsequent transfers of transferred Options shall be prohibited except to Family Members of the original Grantee in accordance with this Section 8.10 or by will or the laws of descent and distribution. The provisions of Section 8.4 relating to termination of Service shall continue to be applied with respect to the original Grantee of the Option, following which such Option shall be exercisable by the transferee only to the extent, and for the periods specified, in Section 8.4.
| 8.11 | Limitations on Incentive Stock Options. |
An Option shall constitute an Incentive Stock Option only (a) if the Grantee of such Option is an Employee of the Company or any corporate Subsidiary, (b) to the extent specifically provided in the related Award Agreement, and (c) to the extent that the aggregate Fair Market Value (determined at the time such Option is granted) of the shares of Stock with respect to which all Incentive Stock Options held by such Grantee become exercisable for the first time during any calendar year (under the Plan and all other plans of the Company and its Affiliates) does not exceed one hundred thousand dollars ($100,000). Except to the extent provided in the regulations under Code Section 422, this limitation shall be applied by taking Options into account in the order in which they were granted.
| 8.12 | Notice of Disqualifying Disposition. |
If any Grantee shall make any disposition of shares of Stock issued pursuant to the exercise of an Incentive Stock Option under the circumstances provided in Code Section 421(b) (relating to certain disqualifying dispositions), such Grantee shall notify the Company of such disposition immediately but in no event later than ten (10) days thereafter.
| 9. | TERMS AND CONDITIONS OF STOCK APPRECIATION RIGHTS |
| 9.1 | Right to Payment and SAR Price. |
A SAR shall confer on the Grantee to whom it is granted a right to receive, upon exercise thereof, the excess of (a) the Fair Market Value of one (1) share of Stock on the date of exercise, over (b) the SAR Price as determined by the Committee. The Award Agreement for a SAR
2025 PROXY STATEMENT A-11
ANNEX A
shall specify the SAR Price, which shall be no less than the Fair Market Value of one (1) share of Stock on the Grant Date of such SAR. SARs may be granted in tandem with all or part of an Option granted under the Plan or at any subsequent time during the term of such Option, in combination with all or any part of any other Award, or without regard to any Option or other Award; provided that a SAR that is granted in tandem with all or part of an Option shall have the same term, and expire at the same time, as the related Option.
| 9.2 | Other Terms. |
(a) The Committee shall determine, on the Grant Date or thereafter, the time or times at which, and the circumstances under which, a SAR may be exercised in whole or in part (including based on achievement of performance goals and/or future Service requirements); the time or times at which SARs shall cease to be or become exercisable following termination of Service or upon other conditions; the method of exercise, method of settlement, form of consideration payable in settlement, method by or forms in which shares of Stock shall be delivered or deemed to be delivered to Grantees, whether or not a SAR shall be granted in tandem or in combination with any other Award; and any and all other terms and conditions of any SAR; provided that no SARs shall be granted to Grantees who are entitled to overtime under Applicable Laws that will vest or be exercisable within a six (6)-month period starting on the Grant Date.
(b) Notwithstanding Section 9.2(a), other than in the case of SARs granted as Substitute Awards, (i) the grant, issuance, retention, vesting, and/or exercise, of a SAR that is based solely upon performance criteria and level of achievement versus such criteria shall be subject to a performance period of not less than twelve (12) months, and (ii) the grant, issuance, retention, vesting, and/or exercise, of a SAR that is based solely upon continued Service and/or the passage of time may not vest or be exercised in full or in part prior to the satisfaction of a one (1) year minimum vesting period. Notwithstanding the foregoing, the Committee may provide for the earlier vesting and/or exercisability under any such SAR (i) in the event of the Grantee’s death or Disability, or (ii) in connection with a Change in Control.
(c) Notwithstanding the limitations in Section 8.2(b) and Section 9.2(b), up to five percent (5%) of the Share Limit may be granted pursuant to the Plan without being subject to the limitations in Section 8.2(b) and Section 9.2(b). The foregoing five percent (5%) share issuance limit shall be subject to adjustment consistent with the adjustment provisions of Section 16 and the share usage rules of Section 4.3.
| 9.3 | Term. |
Each SAR granted under the Plan shall terminate, and all rights thereunder shall cease, on the day before the tenth (10th) anniversary of the Grant Date of such SAR or under such circumstances and on such date prior thereto as is set forth in the Plan or as may be fixed by the Committee and stated in the Award Agreement relating to such SAR.
| 9.4 | Rights of Holders of SARs. |
Unless otherwise stated in the applicable Award Agreement, a Grantee or other Person holding or exercising a SAR shall have none of the rights of a shareholder of the Company (for example, the right to receive cash or dividend payments or distributions attributable to the shares of Stock underlying such SAR, to direct the voting of the shares of Stock underlying such SAR, or to receive notice of any meeting of the Company’s shareholders) until the shares of Stock underlying such SAR, if any, are issued to such Grantee or other Person. Except as provided in Article 16, no adjustment shall be made for dividends, distributions, or other rights with respect to any shares of Stock underlying a SAR for which the record date is prior to the date of issuance of such shares of Stock, if any.
| 9.5 | Transferability of SARs. |
Except as provided in Section 9.6, during the lifetime of a Grantee of a SAR, only the Grantee (or, in the event of such Grantee’s legal incapacity or incompetency, such Grantee’s guardian or legal representative) may exercise such SAR. Except as provided in Section 9.6, no SAR shall be assignable or transferable by the Grantee to whom it is granted, other than by will or the laws of descent and distribution.
| 9.6 | Family Transfers. |
If authorized in the applicable Award Agreement or by the Committee, in its sole discretion, a Grantee may transfer, not for value, all or part of a SAR to any Family Member. For the purpose of this Section 9.6, a transfer “not for value” is a transfer which is (a) a gift, (b) a transfer under a domestic relations order in settlement of marital property rights, or (c) unless Applicable Laws do not permit such transfer, a transfer to an entity in which more than fifty percent (50%) of the voting interests are owned by Family Members (and/or the Grantee) in exchange for an interest in such entity. Following a transfer under this Section 9.6, any such SAR shall continue to be subject to the same
A-12 LABCORP HOLDINGS INC.
ANNEX A
terms and conditions as were in effect immediately prior to such transfer. Subsequent transfers of transferred SARs shall be prohibited except to Family Members of the original Grantee in accordance with this Section 9.6 or by will or the laws of descent and distribution.
| 10. | TERMS AND CONDITIONS OF RESTRICTED STOCK, RESTRICTED STOCK UNITS, AND DEFERRED STOCK UNITS |
| 10.1 | Grant of Restricted Stock, Restricted Stock Units, and Deferred Stock Units. |
Awards of Restricted Stock, Restricted Stock Units, and Deferred Stock Units may be made for consideration or for no consideration, other than the par value of the shares of Stock, which shall be deemed paid by past Service or, if so provided in the related Award Agreement or a separate agreement, the promise by the Grantee to perform future Service to the Company or an Affiliate.
| 10.2 | Restrictions. |
At the time a grant of Restricted Stock, Restricted Stock Units, or Deferred Stock Units is made, the Committee may, in its sole discretion, (a) establish a Restricted Period applicable to such Restricted Stock, Restricted Stock Units, or Deferred Stock Units and (b) prescribe restrictions in addition to or other than the expiration of the Restricted Period, including the achievement of corporate or individual performance goals, which may be applicable to all or any portion of such Restricted Stock, Restricted Stock Units, or Deferred Stock Units as provided in Article 13. Awards of Restricted Stock, Restricted Stock Units, and Deferred Stock Units may not be sold, transferred, assigned, pledged, or otherwise encumbered or disposed of during the Restricted Period or prior to the satisfaction of any other restrictions prescribed by the Committee with respect to such Awards.
| 10.3 | Registration; Restricted Stock Certificates. |
Pursuant to Section 3.6, to the extent that ownership of Restricted Stock is evidenced by a book-entry registration or direct registration (including transaction advices), such registration shall be notated to evidence the restrictions imposed on such Award of Restricted Stock under the Plan and the applicable Award Agreement. Subject to Section 3.6 and the immediately following sentence, the Company may issue, in the name of each Grantee to whom Restricted Stock has been granted, certificates representing the total number of shares of Restricted Stock granted to the Grantee, as soon as reasonably practicable after the Grant Date of such Restricted Stock. The Committee may provide in an Award Agreement with respect to an Award of Restricted Stock that either (a) the Secretary of the Company shall hold such certificates for such Grantee’s benefit until such time as such shares of Restricted Stock are forfeited to the Company or the restrictions applicable thereto lapse and such Grantee shall deliver a stock power to the Company with respect to each certificate, or (b) such certificates shall be delivered to such Grantee, provided that such certificates shall bear legends that comply with Applicable Laws and make appropriate reference to the restrictions imposed on such Award of Restricted Stock under the Plan and such Award Agreement.
| 10.4 | Rights of Holders of Restricted Stock. |
Unless the Committee provides otherwise in an Award Agreement and subject to the restrictions set forth in the Plan, any applicable Company program, and the applicable Award Agreement, holders of Restricted Stock shall have the right to vote such shares of Restricted Stock and, to the extent the shares of Restricted Stock become vested, the right to receive any dividend payments or distributions declared or paid with respect to such shares of Restricted Stock. The Committee shall provide in an Award Agreement evidencing a grant of Restricted Stock that either (a) any cash dividend payments or distributions paid on Restricted Stock shall be reinvested in shares of Stock, which shall be subject to the same vesting conditions and restrictions as applicable to such underlying shares of Restricted Stock or (b) any dividend payments or distributions declared or paid on shares of Restricted Stock shall be paid in cash upon satisfaction of the vesting conditions and restrictions applicable to such shares of Restricted Stock. For the avoidance of doubt, dividend payments or distributions declared or paid on shares of Restricted Stock which vest or are earned based upon the achievement of performance goals shall not vest unless such performance goals for such shares of Restricted Stock are achieved, and if such performance goals are not achieved, the Grantee of such shares of Restricted Stock shall promptly forfeit and, to the extent already paid or distributed, repay to the Company such dividend payments or distributions. All stock dividend payments or distributions, if any, received by a Grantee with respect to shares of Restricted Stock as a result of any stock split, stock dividend, combination of stock, or other similar transaction shall be subject to the same vesting conditions and restrictions as applicable to such underlying shares of Restricted Stock.
2025 PROXY STATEMENT A-13
ANNEX A
| 10.5 | Rights of Holders of Restricted Stock Units and Deferred Stock Units. |
| 10.5.1 | Voting and Dividend Rights. |
Holders of Restricted Stock Units and Deferred Stock Units shall have no rights as shareholders of the Company (for example, the right to receive dividend payments or distributions attributable to the shares of Stock underlying such Restricted Stock Units and Deferred Stock Units, to direct the voting of the shares of Stock underlying such Restricted Stock Units and Deferred Stock Units, or to receive notice of any meeting of the Company’s shareholders). The Committee may provide in an Award Agreement evidencing an Award of Restricted Stock Units or Deferred Stock Units that the holder thereof shall be entitled to receive Dividend Equivalent Rights with respect to each Restricted Stock Unit or Deferred Stock Unit.
| 10.5.2 | Creditor’s Rights. |
A holder of Restricted Stock Units or Deferred Stock Units shall have no rights other than those of a general unsecured creditor of the Company. Restricted Stock Units and Deferred Stock Units represent unfunded and unsecured obligations of the Company, subject to the terms and conditions of the applicable Award Agreement.
| 10.6 | Termination of Service. |
Unless the Committee provides otherwise in an Award Agreement, in another agreement with the Grantee, or otherwise in writing after such Award Agreement is issued, but prior to termination of Grantee’s Service, upon the termination of such Grantee’s Service, any Restricted Stock, Restricted Stock Units, or Deferred Stock Units held by such Grantee that have not vested, or with respect to which all applicable restrictions and conditions have not lapsed, shall immediately be deemed forfeited. Upon forfeiture of such Restricted Stock, Restricted Stock Units, or Deferred Stock Units, the Grantee thereof shall have no further rights with respect thereto, including any right to vote such Restricted Stock or any right to receive dividends or Dividend Equivalent Rights, as applicable, with respect to such Restricted Stock, Restricted Stock Units, or Deferred Stock Units.
| 10.7 | Purchase of Restricted Stock and Shares of Stock Subject to Restricted Stock Units and Deferred Stock Units. |
The Grantee of an Award of Restricted Stock, vested Restricted Stock Units, or vested Deferred Stock Units shall be required, to the extent required by Applicable Laws, to purchase such Restricted Stock or the shares of Stock subject to such vested Restricted Stock Units or Deferred Stock Units from the Company at a purchase price equal to the greater of (x) the aggregate par value of the shares of Stock represented by such Restricted Stock or such vested Restricted Stock Units or Deferred Stock Units or (y) the purchase price, if any, specified in the Award Agreement relating to such Restricted Stock or such vested Restricted Stock Units or Deferred Stock Units. Such purchase price shall be payable in a form provided in Article 14 or, in the sole discretion of the Committee, in consideration for Service rendered or to be rendered by the Grantee to the Company or an Affiliate.
| 10.8 | Delivery of Shares of Stock. |
Upon the expiration or termination of any Restricted Period and the satisfaction of any other conditions prescribed by the Committee, including, without limitation, any performance goals or delayed delivery period, the restrictions applicable to Restricted Stock, Restricted Stock Units, or Deferred Stock Units settled in shares of Stock shall lapse, and, unless otherwise provided in the applicable Award Agreement, a book-entry or direct registration (including transaction advices) or a certificate evidencing ownership of such shares of Stock shall, consistent with Section 3.6, be issued, free of all such restrictions, to the Grantee thereof or such Grantee’s beneficiary or estate, as the case may be. Neither the Grantee, nor the Grantee’s beneficiary or estate, shall have any further rights with regard to a Restricted Stock Unit or Deferred Stock Unit once the shares of Stock represented by such Restricted Stock Unit or Deferred Stock Unit have been delivered in accordance with this Section 10.8.
| 11. | TERMS AND CONDITIONS OF UNRESTRICTED STOCK AWARDS AND OTHER EQUITY-BASED AWARDS |
| 11.1 | Unrestricted Stock Awards. |
The Committee may, in its sole discretion, grant (or sell at the par value of a share of Stock or at such other higher purchase price as shall be determined by the Committee) an Award to any Grantee pursuant to which such Grantee may receive shares of Unrestricted Stock under the Plan. Awards of Unrestricted Stock may be granted or sold to any Grantee as provided in the immediately preceding sentence in respect of Service rendered or, if so provided in the related Award Agreement or a separate agreement, to be rendered by the Grantee to the Company or an Affiliate or other valid consideration, in lieu of or in addition to any cash compensation due to such Grantee.
A-14 LABCORP HOLDINGS INC.
ANNEX A
| 11.2 | Other Equity-Based Awards. |
The Committee may, in its sole discretion, grant Awards in the form of Other Equity-Based Awards, as deemed by the Committee to be consistent with the purposes of the Plan. Awards granted pursuant to this Section 11.2 may be granted with vesting, value, and/or payment contingent upon the achievement of one or more performance goals. The Committee shall determine the terms and conditions of Other Equity-Based Awards on the Grant Date or thereafter. Unless the Committee provides otherwise in an Award Agreement, in another agreement with the Grantee, or otherwise in writing after such Award Agreement is issued, but prior to termination of Grantee’s Service, upon the termination of a Grantee’s Service, any Other Equity-Based Awards held by such Grantee that have not vested, or with respect to which all applicable restrictions and conditions have not lapsed, shall immediately be deemed forfeited. Upon forfeiture of any Other Equity-Based Award, the Grantee thereof shall have no further rights with respect to such Other Equity-Based Award.
| 12. | TERMS AND CONDITIONS OF DIVIDEND EQUIVALENT RIGHTS |
| 12.1 | Dividend Equivalent Rights. |
A Dividend Equivalent Right may be granted hereunder, provided that no Dividend Equivalent Rights may be granted in connection with, or related to, an Award of Options or SARs. The terms and conditions of Dividend Equivalent Rights shall be specified in the Award Agreement therefor. Dividend Equivalent Rights may be settled in cash, shares of Stock, or a combination thereof, in a single installment or in multiple installments, all as determined in the sole discretion of the Committee. A Dividend Equivalent Right granted as a component of another Award shall provide that such Dividend Equivalent Right shall be settled no earlier than the settlement, or payment of, or lapse of restrictions on, such other Award and that such Dividend Equivalent Right shall expire or be forfeited or annulled under the same conditions as such other Award. For the avoidance of doubt, Dividend Equivalent Rights granted as a component of another Award which vests or is earned based upon the achievement of performance goals shall not vest unless such performance goals for such underlying Award are achieved, and if such performance goals are not achieved, the Grantee of such Dividend Equivalent Rights shall promptly forfeit such Dividend Equivalent Rights.
| 12.2 | Termination of Service. |
Unless the Committee provides otherwise in an Award Agreement, in another agreement with the Grantee, or otherwise in writing after such Award Agreement is issued, a Grantee’s rights in all Dividend Equivalent Rights shall automatically terminate upon such Grantee’s termination of Service for any reason.
| 13. | TERMS AND CONDITIONS OF PERFORMANCE-BASED AWARDS |
| 13.1 | Grant of Performance-Based Awards. |
Subject to the terms and provisions of the Plan, the Committee, at any time and from time to time, may grant Performance-Based Awards in such amounts and upon such terms as the Committee shall determine.
| 13.2 | Value of Performance-Based Awards. |
Each grant of a Performance-Based Award shall have an initial cash value or an actual or target number of shares of Stock that is established by the Committee as of the Grant Date. The Committee shall set performance goals in its discretion which, depending on the extent to which they are achieved, shall determine the value and/or number of shares of Stock subject to a Performance-Based Award that shall be paid out to the Grantee thereof.
| 13.3 | Earning of Performance-Based Awards. |
Subject to the terms of the Plan, after the applicable Performance Period has ended, the Grantee of a Performance-Based Award shall be entitled to receive a payout of the value earned under such Performance-Based Award by such Grantee over such Performance Period.
| 13.4 | Form and Timing of Payment of Performance-Based Awards. |
Payment of the value earned under Performance-Based Awards shall be made, as determined by the Committee, in the form, at the time, and in the manner described in the applicable Award Agreement. Subject to the terms of the Plan, the Committee, in its sole discretion, (i) may pay the value earned under Performance-Based Awards in the form of cash, shares of Stock, other Awards, or a combination thereof, including shares of Stock and/or Awards that are subject to any restrictions deemed appropriate by the Committee,
2025 PROXY STATEMENT A-15
ANNEX A
and (ii) shall pay the value earned under Performance-Based Awards at the close of the applicable Performance Period, or as soon as reasonably practicable after the Committee has determined that the performance goal or goals relating thereto have been achieved; provided that, unless specifically provided in the Award Agreement for such Performance-Based Awards, such payment shall occur no later than the last day of the calendar year that follows the end of the calendar year in which such Performance Period ends. The determination of the Committee with respect to the form of payout of such Performance-Based Awards shall be set forth in the Award Agreement therefor. The Committee may, in its sole discretion, reduce the amount of a payment otherwise to be made in connection with Performance-Based Awards.
| 13.5 | Performance Conditions. |
The right of a Grantee to exercise or to receive a grant or settlement of any Performance-Based Award, and the timing thereof, may be subject to the achievement of such performance goals and conditions as may be specified by the Committee. The Committee may use such business criteria and other measures of performance as it may deem appropriate in establishing any performance conditions. The performance goals and conditions upon which the vesting or payment of a Performance-Based Award may be conditioned may include, but not be limited to the following, with or without adjustment:
(a) earnings before interest, taxes, depreciation, and/or amortization;
(b) earnings before interest, taxes, depreciation, and/or amortization as adjusted to exclude any one or more of the following: (i) stock-based compensation expense, (ii) income from discontinued operations, (iii) gain on cancellation of debt, (iv) debt extinguishment and related costs, (v) restructuring, separation, and/or integration charges and costs, (vi) reorganization and/or recapitalization charges and costs, (vii) impairment charges, (viii) merger-related events, (ix) gain or loss related to investments, (x) sales and use tax settlements, and (xi) gain on non-monetary transactions;
(c) operating income, earnings, or profits;
(d) return measures, including return on equity, assets, revenue, capital, capital employed, or investment;
(e) pre-tax or after-tax operating income, earnings, or profits;
(f) net income;
(g) earnings or book value per share;
(h) cash flow(s), including (i) operating cash flow, (ii) free cash flow, (iii) levered cash flow, (iv) cash flow return on equity, and (v) cash flow return on investment;
(i) total sales or revenues growth or targets or sales or revenues per employee, product, service, or customer;
(j) Stock price, including growth measures and total shareholder return;
(k) dividends;
(l) strategic business objectives, consisting of one or more objectives based on meeting specified cost targets, business expansion goals, and goals relating to acquisitions or divestitures or any combination thereof. Each goal may be expressed on an absolute and/or relative basis, may be based on or otherwise employ comparisons based on internal targets, the past performance of the Company and/or the past or current performance of other companies, and in the case of earnings-based measures, may use or employ comparisons relating to capital, shareholders’ equity and/or shares outstanding, or to assets or net assets;
(m) gross or operating margins;
(n) productivity ratios;
(o) costs, reductions in cost, and cost control measures;
(p) expense targets;
(q) market or market segment share or penetration;
(r) financial ratios as provided in credit agreements of the Company and its subsidiaries;
(s) working capital targets;
A-16 LABCORP HOLDINGS INC.
ANNEX A
(t) regulatory achievements or compliance;
(u) customer satisfaction measurements;
(v) execution of contractual arrangements or satisfaction of contractual requirements or milestones;
(w) product development achievements; and
(x) any combination of the foregoing business criteria.
Performance under any of the foregoing performance goals or conditions (a) may be used to measure the performance of (i) the Company, its Subsidiaries, and other Affiliates as a whole, (ii) the Company, any Subsidiary, any other Affiliate, or any combination thereof, or (iii) any one or more business units or operating segments of the Company, any Subsidiary, and/or any other Affiliate, in each case as the Committee, in its sole discretion, deems appropriate and (b) may be compared to the performance of one or more other companies or one or more published or special indices designated or approved by the Committee for such comparison, as the Committee, in its sole discretion, deems appropriate. In addition, the Committee, in its sole discretion, may select performance under the performance goal specified in clause (j) above for comparison to performance under one or more stock market indices designated or approved by the Committee.
| 13.6 | Evaluation of Performance. |
The Committee may provide in any Performance-Based Award that any evaluation of performance may include or exclude the impact of events that occur during a Performance Period, including without limitation: (a) asset write-downs; (b) litigation or claims, judgments, or settlements; (c) the effect of changes in tax laws, accounting principles, or other laws or provisions affecting reported results; (d) any reorganization or restructuring events or programs; (e) extraordinary, non-core, non-operating, or non-recurring items and items that are either of an unusual nature or of a type that indicates infrequency of occurrence as a separate component of income from continuing operations; (f) acquisitions or divestitures; (g) foreign exchange gains and losses; (h) impact of shares of Stock purchased through share repurchase programs; (i) tax valuation allowance reversals; (j) impairment expense; and (k) environmental expense.
| 14. | FORMS OF PAYMENT |
| 14.1 | General Rule. |
Payment of the Option Price for the shares of Stock purchased pursuant to the exercise of an Option or the purchase price, if any, for Restricted Stock, vested Restricted Stock Units, and/or vested Deferred Stock Units shall be made in cash or in cash equivalents acceptable to the Company.
| 14.2 | Surrender of Shares of Stock. |
To the extent that the applicable Award Agreement so provides, payment of the Option Price for shares of Stock purchased pursuant to the exercise of an Option or the purchase price, if any, for Restricted Stock, vested Restricted Stock Units, and/or vested Deferred Stock Units may be made all or in part through the tender or attestation to the Company of shares of Stock, which shall be valued, for purposes of determining the extent to which such Option Price or purchase price has been paid thereby, at their Fair Market Value on the date of such tender or attestation.
| 14.3 | Cashless Exercise. |
To the extent permitted by Applicable Laws and to the extent the Award Agreement so provides, payment of the Option Price for shares of Stock purchased pursuant to the exercise of an Option may be made all or in part by delivery (on a form acceptable to the Committee) of an irrevocable direction to a licensed securities broker acceptable to the Company to sell shares of Stock and to deliver all or part of the proceeds of such sale to the Company in payment of such Option Price and/or any withholding taxes described in Section 18.3.
| 14.4 | Other Forms of Payment. |
To the extent that the applicable Award Agreement so provides and/or unless otherwise specified in an Award Agreement, payment of the Option Price for shares of Stock purchased pursuant to exercise of an Option or the purchase price, if any, for Restricted Stock, vested Restricted Stock Units, and/or vested Deferred Stock Units may be made in any other form that is consistent with Applicable Laws, including (a) with respect to Restricted Stock, vested Restricted Stock Units, and/or vested Deferred Stock Units only, Service rendered or to
2025 PROXY STATEMENT A-17
ANNEX A
be rendered by the Grantee thereof to the Company or an Affiliate and (b) with the consent of the Company, by withholding the number of shares of Stock that would otherwise vest or be issuable in an amount equal in value to the Option Price or purchase price and/or the required tax withholding amount.
| 15. | REQUIREMENTS OF LAW |
| 15.1 | General. |
The Company shall not be required to offer, sell, or issue any shares of Stock under any Award, whether pursuant to the exercise of an Option, a SAR, or otherwise, if the offer, sale, or issuance of such shares of Stock would constitute a violation by the Grantee, the Company, an Affiliate, or any other Person of any provision of the Company’s certificate of incorporation or bylaws or of Applicable Laws, including any federal or state securities laws or regulations. If at any time the Company shall determine, in its discretion, that the listing, registration, or qualification of any shares of Stock subject to an Award upon any Stock Exchange or Securities Market or under any governmental regulatory body is necessary or desirable as a condition of, or in connection with, the offering, sale, issuance, or purchase of shares of Stock in connection with any Award, no shares of Stock may be offered, sold, or issued to the Grantee or any other Person under such Award, whether pursuant to the exercise of an Option, a SAR, or otherwise, unless such listing, registration, or qualification shall have been effected or obtained free of any conditions not acceptable to the Company, and any delay caused thereby shall in no way affect the date of termination of such Award. Without limiting the generality of the foregoing, upon the exercise of any Option or any SAR that may be settled in shares of Stock or the delivery of any shares of Stock underlying an Award, unless a registration statement under the Securities Act is in effect with respect to the shares of Stock subject to such Award, the Company shall not be required to offer, sell, or issue such shares of Stock unless the Committee shall have received evidence satisfactory to it that the Grantee or any other Person exercising such Option or SAR or accepting delivery of such shares may acquire such shares of Stock pursuant to an exemption from registration under the Securities Act. Any determination by the Committee in connection with the foregoing shall be final, binding, and conclusive. The Company may register, but shall in no event be obligated to register, any shares of Stock or other securities issuable pursuant to the Plan pursuant to the Securities Act. The Company shall not be obligated to take any affirmative action in order to cause the exercise of an Option or a SAR or the issuance of shares of Stock or other securities issuable pursuant to the Plan or any Award to comply with any Applicable Laws. As to any jurisdiction that expressly imposes the requirement that an Option or SAR that may be settled in shares of Stock shall not be exercisable until the shares of Stock subject to such Option or SAR are registered under the securities laws thereof or are exempt from such registration, the exercise of such Option or SAR under circumstances in which the laws of such jurisdiction apply shall be deemed conditioned upon the effectiveness of such registration or the availability of such an exemption.
| 15.2 | Rule 16b-3. |
During any time when the Company has any class of common equity securities registered under Section 12 of the Exchange Act, it is the intention of the Company that Awards pursuant to the Plan and the exercise of Options and SARs granted hereunder that would otherwise be subject to Section 16(b) of the Exchange Act shall qualify for the exemption provided by Rule 16b-3 under the Exchange Act. To the extent that any provision of the Plan or action by the Committee does not comply with the requirements of such Rule 16b-3, such provision or action shall be deemed inoperative with respect to such Awards to the extent permitted by Applicable Laws and deemed advisable by the Committee and shall not affect the validity of the Plan. In the event that such Rule 16b-3 is revised or replaced, the Committee may exercise its discretion to modify the Plan in any respect necessary or advisable in its judgment to satisfy the requirements of, or to permit the Company to avail itself of the benefits of, the revised exemption or its replacement.
| 16. | EFFECT OF CHANGES IN CAPITALIZATION |
| 16.1 | Changes in Stock. |
If the number of outstanding shares of Stock is increased or decreased or the shares of Stock are changed into or exchanged for a different number of shares or kind of Capital Stock or other securities of the Company on account of any merger, reorganization, recapitalization, reclassification, stock split, reverse stock split, spin-off, combination of stock, exchange of stock, stock dividend or other distribution payable in capital stock, or other increase or decrease in shares of Stock effected without receipt of consideration by the Company occurring after the Effective Date, the number and kinds of shares of Capital Stock for which grants of Options and other Awards may be made under the Plan, including the Share Limit set forth in Section 4.1 and the share limitations in Section 8.2(c), shall be adjusted proportionately and accordingly by the Committee. In addition, (i) the number and kind of shares of Capital Stock for which Awards are outstanding shall be adjusted proportionately and accordingly by the Committee so that the proportionate interest of the Grantee therein immediately following such event shall, to the extent practicable, be the same as immediately before such event, and (ii) the performance conditions of any outstanding Performance-Based Awards shall be adjusted appropriately if necessary so that a Grantee of an outstanding Performance-Based Award is neither advantaged or disadvantaged by such event. Any such adjustment in outstanding Options or SARs
A-18 LABCORP HOLDINGS INC.
ANNEX A
shall not change the aggregate Option Price or SAR Price payable with respect to shares that are subject to the unexercised portion of such outstanding Options or SARs, as applicable, but shall include a corresponding proportionate adjustment in the per share Option Price or SAR Price, as the case may be. The conversion of any convertible securities of the Company shall not be treated as an increase in shares effected without receipt of consideration. Notwithstanding the foregoing, in the event of any distribution to the Company’s shareholders of securities of any other entity or other assets (including an extraordinary dividend, but excluding a non-extraordinary dividend, declared and paid by the Company) without receipt of consideration by the Company, the Board or the Committee constituted pursuant to Section 3.1.2 shall, in such manner as the Board or the Committee deems appropriate, adjust (a) the Share limit set forth in Section 4.1 and the share limitations in Section 8.2(c), (b) the number and kind of shares of Capital Stock subject to outstanding Awards and/or (c) the aggregate and per share Option Price of outstanding Options and the aggregate and per share SAR Price of outstanding SARs as required to reflect such distribution.
| 16.2 | Reorganization in Which the Company Is the Surviving Entity Which Does Not Constitute a Change in Control. |
Subject to Section 16.3, if the Company shall undergo any reorganization, merger, or consolidation of the Company with one or more other entities which does not constitute a Change in Control, any Award theretofore granted pursuant to the Plan shall pertain to and apply to the Capital Stock to which a holder of the number of shares of Stock subject to such Award would have been entitled immediately following such reorganization, merger, or consolidation, with a corresponding proportionate adjustment of the per share Option Price or SAR Price of any outstanding Option or SAR so that the aggregate Option Price or SAR Price thereafter shall be the same as the aggregate Option Price or SAR Price of the shares of Stock remaining subject to the Option or SAR as in effect immediately prior to such reorganization, merger, or consolidation. Subject to any contrary language in an Award Agreement, in another agreement with the Grantee, or as otherwise set forth in writing, any restrictions applicable to such Award shall apply as well to any replacement shares of Capital Stock subject to such Award, or received by the Grantee, as a result of such reorganization, merger, or consolidation. In the event of any reorganization, merger, or consolidation of the Company referred to in this Section 16.2, Performance-Based Awards shall be adjusted (including any adjustment to the Performance Measures applicable to such Awards deemed appropriate by the Committee) so as to apply to the Capital Stock that a holder of the number of shares of Stock subject to the Performance-Based Awards would have been entitled to receive immediately following such reorganization, merger, or consolidation.
| 16.3 | Change in Control in Which Awards Are Not Assumed. |
Except as otherwise provided in the applicable Award Agreement, in another agreement with the Grantee, or as otherwise set forth in writing, upon the occurrence of a Change in Control in which outstanding Awards are not being assumed or continued, the following provisions shall apply to such Award, to the extent not assumed or continued:
(a) Immediately prior to the occurrence of such Change in Control, in each case with the exception of Performance-Based Awards, all outstanding shares of Restricted Stock, and all Restricted Stock Units, Deferred Stock Units, and Dividend Equivalent Rights shall be deemed to have vested, and all shares of Stock and/or cash subject to such Awards shall be delivered; and either or both of the following two (2) actions shall be taken:
(i) At least fifteen (15) days prior to the scheduled consummation of such Change in Control, all Options and SARs outstanding hereunder shall become immediately exercisable and shall remain exercisable for a period of fifteen (15) days. Any exercise of an Option or SAR during this fifteen (15)-day period shall be conditioned upon the consummation of the applicable Change in Control and shall be effective only immediately before the consummation thereof, and upon consummation of such Change in Control, the Plan and all outstanding but unexercised Options and SARs shall terminate, with or without consideration (including, without limitation, consideration in accordance with clause (ii) below) as determined by the Committee in its sole discretion. The Committee shall send notice of an event that shall result in such a termination to all Persons who hold Options and SARs not later than the time at which the Company gives notice thereof to its shareholders.
and/or
(ii) The Committee may elect, in its sole discretion, to cancel any outstanding Awards of Options, SARs, Restricted Stock, Restricted Stock Units, Deferred Stock Units, and/or Dividend Equivalent Rights and pay or deliver, or cause to be paid or delivered, to the holder thereof an amount in cash or Capital Stock having a value (as determined by the Committee acting in good faith), in the case of Restricted Stock, Restricted Stock Units, Deferred Stock Units, and Dividend Equivalent Rights (for shares of Stock subject thereto), equal to the formula or fixed price per share paid to holders of shares of Stock pursuant to such Change in Control and, in the case of Options or SARs, equal to the product of the number of shares of Stock subject to such Options or SARs multiplied by the amount, if any, by which (x) the formula or fixed price per share paid to holders of shares of Stock pursuant to such transaction exceeds (y) the Option Price or SAR Price applicable to such Options or SARs.
2025 PROXY STATEMENT A-19
ANNEX A
(b) For Performance-Based Awards, if less than half of the Performance Period has lapsed, such Performance-Based Awards shall be treated as though target performance has been achieved. If at least half of the Performance Period has lapsed, actual performance to date shall be determined as of a date reasonably proximal to the date of consummation of the Change in Control as determined by the Committee, in its sole discretion, and that level of performance thus determined shall be treated as achieved immediately prior to occurrence of the Change in Control. For purposes of the preceding sentence, if, based on the discretion of the Committee, actual performance is not determinable, the Performance-Based Awards shall be treated as though target performance has been achieved. After application of this Section 16.3(b), if any Awards arise from application of this Article 16, such Awards shall be settled under the applicable provision of Section 16.3(a).
(c) Other Equity-Based Awards shall be governed by the terms of the applicable Award Agreement.
| 16.4 | Change in Control in Which Awards Are Assumed. |
Except as otherwise provided in the applicable Award Agreement, in another agreement with the Grantee, or as otherwise set forth in writing, upon the occurrence of a Change in Control in which outstanding Awards are being assumed or continued, the following provisions shall apply to such Award, to the extent assumed or continued:
The Plan and the Options, SARs, Restricted Stock, Restricted Stock Units, Deferred Stock Units, Dividend Equivalent Rights, and Other Equity-Based Awards granted under the Plan shall continue in the manner and under the terms so provided in the event of any Change in Control to the extent that provision is made in writing in connection with such Change in Control for the assumption or continuation of such Options, SARs, Restricted Stock, Restricted Stock Units, Performance-Based Awards, Deferred Stock Units, Dividend Equivalent Rights, and Other Equity-Based Awards, or for the substitution for such Options, SARs, Restricted Stock, Restricted Stock Units, Performance-Based Awards, Deferred Stock Units, Dividend Equivalent Rights, and Other Equity-Based Awards of new stock options, stock appreciation rights, restricted stock, restricted stock units, deferred stock units, dividend equivalent rights, and other equity-based awards relating to the Capital Stock of a successor entity, or a parent or subsidiary thereof, with appropriate adjustments as to the number of shares (disregarding any consideration that is not common stock), performance conditions applicable to Performance-Based Awards, and exercise prices of options and stock appreciation rights.
In the event an Award other than a Performance-Based Award is assumed, continued, or substituted upon the consummation of any Change in Control and the Service of such Grantee with the Company or an Affiliate is terminated without Cause within one (1) year (or such longer or shorter period as may be determined by the Committee) following the consummation of such Change in Control, such Award shall be fully vested and may be exercised in full, to the extent applicable, beginning on the date of such termination and for the one (1)-year period (or such longer or shorter period as may be determined by the Committee) immediately following such termination or for such longer period as the Committee shall determine.
| 16.5 | Adjustments. |
Adjustments under this Article 16 related to shares of Stock or other Capital Stock of the Company shall be made by the Committee, whose determination in that respect shall be final, binding, and conclusive. No fractional shares or other securities shall be issued pursuant to any such adjustment, and any fractions resulting from any such adjustment shall be eliminated in each case by rounding downward to the nearest whole share. The Committee may provide in the applicable Award Agreement as of the Grant Date, in another agreement with the Grantee, or otherwise in writing at any time thereafter with the consent of the Grantee, for different provisions to apply to an Award in place of those provided in Sections 16.1, 16.2, 16.3, and 16.4. This Article 16 shall not limit the Committee’s ability to provide for alternative treatment of Awards outstanding under the Plan in the event of an internal reorganization change in control event involving the Company that is not a Change in Control.
| 16.6 | No Limitations on Company. |
The making of Awards pursuant to the Plan shall not affect or limit in any way the right or power of the Company to make adjustments, reclassifications, reorganizations, or changes of its capital or business structure or to merge, consolidate, dissolve, or liquidate, or to sell or transfer all or any part of its business or assets (including all or any part of the business or assets of any Subsidiary or other Affiliate) or to engage in any other transaction or activity.
| 17. | PARACHUTE LIMITATIONS |
If any Grantee is a Disqualified Individual, then, notwithstanding any other provision of the Plan or of any Other Agreement to the contrary and notwithstanding any Benefit Arrangement, any right of the Grantee to any exercise, vesting, payment, or benefit under the Plan shall be reduced or eliminated:
(a) to the extent that such right to exercise, vesting, payment, or benefit, taking into account all other rights, payments, or benefits to
A-20 LABCORP HOLDINGS INC.
ANNEX A
or for the Grantee under the Plan, all Other Agreements, and all Benefit Arrangements, would cause any exercise, vesting, payment, or benefit to the Grantee under the Plan to be considered a Parachute Payment; and
(b) if, as a result of receiving such Parachute Payment, the aggregate after-tax amounts received by the Grantee from the Company under the Plan, all Other Agreements, and all Benefit Arrangements would be less than the maximum after-tax amount that could be received by the Grantee without causing any such payment or benefit to be considered a Parachute Payment.
Except as required by Code Section 409A or to the extent that Code Section 409A permits discretion, the Committee shall have the right, in the Committee’s sole discretion, to designate those rights, payments, or benefits under the Plan, all Other Agreements, and all Benefit Arrangements that should be reduced or eliminated so as to avoid having such rights, payments, or benefits be considered a Parachute Payment; provided, however, to the extent any payment or benefit constitutes deferred compensation under Code Section 409A, in order to comply with Code Section 409A, the Company shall instead accomplish such reduction by first reducing or eliminating any cash payments (with the payments to be made furthest in the future being reduced first), then by reducing or eliminating any accelerated vesting of Performance-Based Awards, then by reducing or eliminating any accelerated vesting of Options or SARs, then by reducing or eliminating any accelerated vesting of Restricted Stock, Restricted Stock Units, or Deferred Stock Units, then by reducing or eliminating any other remaining Parachute Payments.
| 18. | GENERAL PROVISIONS |
| 18.1 | Disclaimer of Rights. |
No provision in the Plan, any Award, or any Award Agreement shall be construed (a) to confer upon any individual the right to remain in the Service of the Company or an Affiliate, (b) to interfere in any way with any contractual or other right or authority of the Company or an Affiliate either to increase or decrease the compensation or other payments to any Person at any time, or (c) to terminate any Service or other relationship between any Person and the Company or an Affiliate. In addition, notwithstanding any provision of the Plan to the contrary, unless otherwise stated in the applicable Award Agreement, in another agreement with the Grantee, or otherwise in writing, no Award granted under the Plan shall be affected by any change of duties or position of the Grantee thereof, so long as such Grantee continues to provide Service. The obligation of the Company to pay any benefits pursuant to the Plan shall be interpreted as a contractual obligation to pay only those amounts provided herein, in the manner and under the conditions prescribed herein. The Plan and Awards shall in no way be interpreted to require the Company to transfer any amounts to a third-party trustee or otherwise hold any amounts in trust or escrow for payment to any Grantee or beneficiary under the terms of the Plan.
| 18.2 | Nonexclusivity of the Plan. |
Neither the adoption of the Plan nor the submission of the Plan to the shareholders of the Company for approval shall be construed as creating any limitations upon the right and authority of the Board or the Committee to adopt such other incentive compensation arrangements (which arrangements may be applicable either generally to a class or classes of individuals or specifically to a particular individual or particular individuals) as the Board or the Committee in their discretion determine desirable.
| 18.3 | Withholding Taxes. |
The Company or an Affiliate, as the case may be, shall have the right to deduct from payments of any kind otherwise due to a Grantee any federal, state, or local taxes of any kind required by Applicable Laws to be withheld with respect to the vesting of or other lapse of restrictions applicable to an Award or upon the issuance of any shares of Stock upon the exercise of an Option or pursuant to any other Award. At the time of such vesting, lapse, or exercise, the Grantee shall pay in cash to the Company or an Affiliate, as the case may be, any amount that the Company or such Affiliate may reasonably determine to be necessary to satisfy such withholding obligation; provided that if there is a same-day sale of shares of Stock subject to an Award, the Grantee shall pay such withholding obligation on the day on which such same-day sale is completed. Subject to the prior approval of the Company or an Affiliate, which may be withheld by the Company or such Affiliate, as the case may be, in its sole discretion, the Grantee may elect to satisfy such withholding obligation, in whole or in part, (a) by causing the Company or such Affiliate to withhold shares of Stock otherwise issuable to the Grantee or (b) by delivering to the Company or such Affiliate shares of Stock already owned by the Grantee. The shares of Stock so withheld or delivered shall have an aggregate Fair Market Value equal to such withholding obligation. The Fair Market Value of the shares of Stock used to satisfy such withholding obligation shall be determined by the Company or such Affiliate as of the date on which the amount of tax to be withheld is to be determined. A Grantee who has made an election pursuant to this Section 18.3 may satisfy such Grantee’s withholding obligation only with shares of Stock that are not subject to any repurchase, forfeiture, unfulfilled vesting, or other similar requirements. The maximum number of shares of Stock that may be withheld from any Award to satisfy any federal, state, or local tax withholding requirements upon the exercise, vesting, or lapse of restrictions applicable to any Award or payment of shares of Stock pursuant to such Award, as applicable,
2025 PROXY STATEMENT A-21
ANNEX A
may not exceed such number of shares of Stock having a Fair Market Value equal to the minimum statutory amount (or, if permitted by the Company, such other rate as will not cause adverse accounting consequences and is permitted under applicable IRS withholding rules) required by the Company or the applicable Affiliate to be withheld and paid to any such federal, state, or local taxing authority with respect to such exercise, vesting, lapse of restrictions, or payment of shares of Stock.
| 18.4 | Captions. |
The use of captions in the Plan or any Award Agreement is for convenience of reference only and shall not affect the meaning of any provision of the Plan or such Award Agreement.
| 18.5 | Construction. |
Unless the context otherwise requires, all references in the Plan to “including” shall mean “including without limitation.”
| 18.6 | Other Provisions. |
Each Award granted under the Plan may contain such other terms and conditions not inconsistent with the Plan as may be determined by the Committee, in its sole discretion.
| 18.7 | Number and Gender. |
With respect to words used in the Plan, the singular form shall include the plural form, and the masculine gender shall include the feminine gender, as the context requires.
| 18.8 | Severability. |
If any provision of the Plan or any Award Agreement shall be determined to be illegal or unenforceable by any court of law in any jurisdiction, the remaining provisions hereof and thereof shall be severable and enforceable in accordance with their terms, and all provisions shall remain enforceable in any other jurisdiction.
| 18.9 | Governing Law. |
The validity and construction of the Plan and the instruments evidencing the Awards hereunder shall be governed by, and construed and interpreted in accordance with, the laws of the State of Delaware, other than any conflicts or choice of law rule or principle that might otherwise refer construction or interpretation of the Plan and the instruments evidencing the Awards granted hereunder to the substantive laws of any other jurisdiction.
| 18.10 | Foreign Jurisdictions. |
To the extent the Committee determines that the material terms set by the Committee imposed by the Plan preclude the achievement of the material purposes of the Plan in jurisdictions outside the United States, the Committee shall have the authority and discretion to modify those terms and provide for such additional terms and conditions as the Committee determines to be necessary, appropriate, or desirable to accommodate differences in local law, policy, or custom or to facilitate administration of the Plan. The Committee may adopt or approve sub-plans, appendices, or supplements to, or amendments, restatements, or alternative versions of the Plan as in effect for any other purposes. The special terms and any appendices, supplements, amendments, restatements, or alternative versions, however, shall not include any provisions that are inconsistent with the terms of the Plan as in effect, unless the Plan could have been amended to eliminate such inconsistency without further approval by the Company’s shareholders.
| 18.11 | Section 409A of the Code. |
The Plan is intended to comply with Code Section 409A to the extent subject thereto, and, accordingly, to the maximum extent permitted, the Plan shall be interpreted and administered to be in compliance with Code Section 409A. Any payments described in the Plan that are due within the Short-Term Deferral Period shall not be treated as deferred compensation unless Applicable Laws require otherwise. Notwithstanding any provision of the Plan to the contrary, to the extent required to avoid accelerated taxation and tax penalties under Code Section 409A, amounts that would otherwise be payable and benefits that would otherwise be provided pursuant to the Plan during the six (6)-month period immediately following the Grantee’s Separation from Service shall instead be paid on the first payroll date after the six (6)-month anniversary of the Grantee’s Separation from Service (or the Grantee’s death, if earlier).
A-22 LABCORP HOLDINGS INC.
ANNEX A
Furthermore, notwithstanding anything in the Plan to the contrary, in the case of an Award that is characterized as deferred compensation under Code Section 409A, and pursuant to which settlement and delivery of the cash or shares of Stock subject to the Award is triggered based on a Change in Control, in no event shall a Change in Control be deemed to have occurred for purposes of such settlement and delivery of cash or shares of Stock if the transaction is not also a “change in the ownership or effective control of” the Company or “a change in the ownership of a substantial portion of the assets of” the Company as determined under Treasury Regulation Section 1.409A-3(i)(5) (without regard to any alternative definition thereunder). If an Award characterized as deferred compensation under Code Section 409A is not settled and delivered on account of the provision of the preceding sentence, the settlement and delivery shall occur on the next succeeding settlement and delivery triggering event that is a permissible triggering event under Code Section 409A. No provision of this paragraph shall in any way affect the determination of a Change in Control for purposes of vesting in an Award that is characterized as deferred compensation under Code Section 409A.
Notwithstanding the foregoing, neither the Company nor the Committee shall have any obligation to take any action to prevent the assessment of any excise tax or penalty on any Grantee under Code Section 409A, and neither the Company or an Affiliate nor the Board or the Committee shall have any liability to any Grantee for such tax or penalty.
| 18.12 | Limitation on Liability. |
To the extent permitted by Applicable Law, no member of the Board or the Committee shall be liable for any action or determination made in good faith with respect to the Plan, any Award, or any Award Agreement. Notwithstanding any provision of the Plan to the contrary, neither the Company, an Affiliate, the Board, the Committee, nor any person acting on behalf of the Company, an Affiliate, the Board, or the Committee shall be liable to any Grantee or to the estate or beneficiary of any Grantee or to any other holder of an Award under the Plan by reason of any acceleration of income, or any additional tax (including any interest and penalties), asserted by reason of the failure of an Award to satisfy the requirements of Code Section 422 or Code Section 409A or by reason of Code Section 4999, or otherwise asserted with respect to the Award; provided, that this Section 18.12 shall not affect any of the rights or obligations set forth in an applicable agreement between the Grantee and the Company or an Affiliate.
To record adoption of the Plan by the Board as of March 27, 2025, the Company has caused its authorized officer to execute the Plan.
| LABCORP HOLDINGS INC. |
| By: |
| Name: |
| Title: |
Signature Page to the
Labcorp Holdings Inc. 2025 Omnibus Incentive Plan
2025 PROXY STATEMENT A-23
ANNEX B
LABCORP HOLDINGS INC.
2025 EMPLOYEE STOCK PURCHASE PLAN
Effective May 15, 2025
1. PURPOSE AND INTERPRETATION
(a) The purpose of the Plan is to encourage and to enable Eligible Employees of the Company and its Participating Affiliates, through after-tax payroll deductions or periodic cash contributions, to acquire proprietary interests in the Company through the purchase and ownership of shares of Stock. The Plan is intended to benefit the Company and its shareholders (a) by incentivizing Participants to contribute to the success of the Company and to operate and manage the Company’s business in a manner that will provide for the Company’s long-term growth and profitability and that will benefit its shareholders and other important stakeholders and (b) by encouraging Participants to remain in the employ of the Company or its Participating Affiliates.
(b) The Plan and the Options granted under the Plan are intended to satisfy the requirements for an “employee stock purchase plan” under Code Section 423. Notwithstanding the foregoing, the Company makes no undertaking to, nor representation that it will, maintain the qualified status of the Plan or any Options granted under the Plan. In addition, Options that do not satisfy the requirements for an “employee stock purchase plan” under Code Section 423 may be granted under the Plan pursuant to the rules, procedures, or sub-plans adopted by the Administrator, in its sole discretion, for certain Eligible Employees.
2. DEFINITIONS
(a) “Account” shall mean a bookkeeping account established and maintained to record the amount of funds accumulated pursuant to the Plan with respect to a Participant for the purpose of purchasing shares of Stock under the Plan.
(b) “Administrator” shall mean the Board, the compensation committee of the Board, or any other committee of the Board designated by the Board.
(c) “Board” shall mean the Board of Directors of the Company.
(d) “Code” shall mean the Internal Revenue Code of 1986, as amended, as now in effect or as hereafter amended, and any successor thereto. References in the Plan to any Code Section shall be deemed to include, as applicable, regulations and guidance promulgated under such Code Section.
(e) “Company” shall mean Labcorp Holdings Inc., a Delaware corporation, and any successor thereto.
(f) “Custodian” shall mean the third-party administrator designated by the Administrator from time to time.
(g) “Effective Date” shall mean May 15, 2025.
(h) “Eligible Compensation” shall mean, unless otherwise established by the Administrator prior to the start of an Offering Period, regular base pay (including any shift differentials) but excludes any bonus, overtime payment, sales commission, contribution to any Code Section 125 or 401(k) plan or to the extent applicable, its equivalence under the laws of a foreign jurisdiction, or other form of extra compensation.
(i) “Eligible Employee” shall mean a natural person who has been an employee (including an officer) of the Company or a Participating Affiliate for at least six (6) months as of an Offering Date, except the following, who shall not be eligible to participate under the Plan: (i) an employee whose customary employment is twenty (20) hours or less per week, (ii) an employee whose customary employment is for not more than five (5) months in any calendar year, (iii) an employee who, after exercising his or her rights to purchase shares of Stock under the Plan, would own (directly or by attribution pursuant to Code Section 424(d)) shares of Stock (including shares that may be acquired under any outstanding Options) representing five percent (5%) or more of the total combined voting power of all classes of stock of the Company, (iv) an employee who is a citizen or resident of a foreign jurisdiction (without regard to whether such employee is also a U.S. citizen or resident alien), if the grant of an Option under the Plan or an Offering Period to such employee is prohibited under the laws of such foreign jurisdiction or compliance with the laws of such foreign jurisdiction would cause the Plan or an Offering Period to violate the requirements of Code Section 423 and (v) any other natural person whom the Administrator determine to exclude from an offering designed to satisfy the requirements of Code Section 423 provided such exclusion is permitted by Code Section 423 and the guidance issued thereunder as well as, to the extent applicable, the laws of a foreign jurisdiction. Notwithstanding the foregoing, for purposes of a Non-423(b) Offering under the Plan, if any, the Administrator shall have the authority, in its sole discretion, to establish a different definition of Eligible Employee as it may deem advisable or necessary.
2025 PROXY STATEMENT B-1
ANNEX B
(j) “Enrollment Form” shall mean the agreement(s) between the Company and an Eligible Employee, in such written, electronic, or other format and/or pursuant to such written, electronic, or other process as may be established by the Administrator from time to time, pursuant to which an Eligible Employee elects to participate in the Plan or to which a Participant elects to make changes with respect to the Participant’s participation as permitted by the Plan.
(k) “Enrollment Period” shall mean that period of time prescribed by the Administrator, which period shall conclude prior to the Offering Date, during which Eligible Employees may elect to participate in an Offering Period. The duration and timing of Enrollment Periods may be changed or modified by the Administrator from time to time.
(l) “Fair Market Value” shall mean the value of each share of Stock subject to the Plan on a given date determined as follows: (i) if on such date the shares of Stock are listed on an established national or regional stock exchange or are publicly traded on an established securities market, the Fair Market Value of a share of Stock shall be the closing price of the Stock on such exchange or in such market (the exchange or market selected by the Administrator if there is more than one such exchange or market) on such date or, if such date is not a Trading Day, on the Trading Day immediately preceding such date, or, if no sale of the shares of Stock is reported for such trading day, on the next preceding day on which any sale shall have been reported; or (ii) if the shares of Stock are not listed on such an exchange or traded on such a market, the Fair Market Value of the shares of Stock shall be determined by the Board in good faith.
(m) “Holding Period” shall have the meaning set forth in Section 10(c)(i).
(n) “Non-423(b) Offering” shall mean the rules, procedures, or sub-plans, if any, adopted by the Administrator, in its sole discretion, as a part of the Plan, pursuant to which Options that do not satisfy the requirements for “employee stock purchase plans” that are set forth under Code Section 423 may be granted to Eligible Employees as a separate offering under the Plan.
(o) “Offering Date” shall mean the first day of any Offering Period under the Plan.
(p) “Offering Period” shall mean the period determined by the Administrator pursuant to Section 7, which period shall not exceed twenty-seven (27) months, during which payroll deductions or periodic cash contributions are accumulated for the purpose of purchasing Stock under the Plan.
(q) “Option” shall mean the right granted to Participants to purchase shares of Stock pursuant to an offering under the Plan.
(r) “Outstanding Election” shall mean a Participant’s then-current election to purchase shares of Stock in an Offering Period, or that part of such an election which has not been cancelled (including any voluntary cancellation under Section 5 and deemed cancellation under Section 11) prior to the close of business on the last Trading Day of the Offering Period (or if an Offering Period has multiple Purchase Periods, the last Trading Day of the Purchase Period) or such other date as determined by the Administrator.
(s) “Participating Affiliate” shall mean any Subsidiary designated by the Administrator from time to time, in its sole discretion, whose employees may participate in the Plan or in a specific Offering Period under the Plan, if such employees otherwise qualify as Eligible Employees.
(t) “Participant” shall mean an Eligible Employee who has elected to participate in the Plan pursuant to Section 5.
(u) “Plan” shall mean this Labcorp Holdings Inc. 2025 Employee Stock Purchase Plan, as it may be further amended from time to time.
(v) “Prior Plan” shall mean the Labcorp Holdings Inc. Amended and Restated 2016 Employee Stock Purchase Plan.
(w) “Purchase Period” shall mean the period during an Offering Period designated by the Administrator on the last Trading Day of which purchases of Stock are made under the Plan. An Offering Period may have one or more Purchase Periods.
(x) “Purchase Price” shall mean the purchase price of each share of Stock purchased under the Plan; provided, however, that the Purchase Price shall not be less than the lesser of eighty-five percent (85%) of the closing price of the Common Stock on the New York Stock Exchange on the Offering Date (or if such date is not a Trading Day, the next Trading Day thereafter) or the last Trading Day of the Offering Period (or if an Offering Period has multiple Purchase Periods, on the last Trading Day of the Purchase Period).
(y) “Stock” shall mean the common stock, par value $0.10 per share, of the Company, or any security into which shares of Stock may be changed or for which shares of Stock may be exchanged as provided in Section 12.
(z) “Subsidiary” shall mean any corporation (other than the Company) in an unbroken chain of corporations beginning with the Company if each of the corporations other than the last corporation in the unbroken chain owns stock possessing fifty percent (50%) or more of the total combined voting power of all classes of stock in one of the other corporations in such chain.
B-2 LABCORP HOLDINGS INC.
ANNEX B
(aa) “Termination of Employment” shall mean, with respect to a Participant, a cessation of the employee-employer relationship between the Participant and the Company or a Participating Affiliate for any reason as well as the occurrences included below that would constitute termination of employment at law,
(i) including, without limitation, (A) a voluntary or involuntary termination of employment by resignation, discharge, dismissal, redundancy, expiry of fixed-term contract, death, disability, retirement, (B) or the disaffiliation of a Subsidiary, (C) unless otherwise determined or provided by the Administrator, a transfer of employment to a Subsidiary that is not a Participating Affiliate as of the first day immediately following the three (3)-month period following such transfer, and (D) a termination of employment where the individual continues to provide certain services to the Company or a Subsidiary in a non-employee role, but
(ii) excluding (A) such termination of employment where there is a simultaneous reemployment of the Participant by the Company or a Participating Affiliate, and (B) any bona fide and Company-approved or Participating Affiliate-approved leave of absence, such as family leave, medical leave, personal leave, and military leave, or such other leave that meets the requirements of Treasury Regulations section 1.421-1(h)(2) or, to the extent applicable, its equivalence under the laws of a foreign jurisdiction; provided, however, where the period of leave exceeds three (3) months and the employee’s right to reemployment is not guaranteed either by statute or by contract, the employee-employer relationship will be deemed to have terminated on the first day immediately following such three (3)-month period.
(bb) “Trading Day” shall mean a day on which the New York Stock Exchange is open for trading.
3. SHARES SUBJECT TO THE PLAN
(a) Share Reserve. Subject to adjustment as provided in Section 12, the maximum number of shares of Stock that may be issued pursuant to Options granted under the Plan (including any Non-423(b) Offering established hereunder) is two million five hundred thousand (2,500,000) shares. The shares of Stock reserved for issuance under the Plan may be authorized but unissued shares, treasury shares, or shares purchased on the open market.
(b) Participation Adjustment as a Result of the Share Reserve. If the Administrator determines that the total number of shares of Stock remaining available under the Plan is insufficient to permit the number of shares of Stock to be purchased by all Participants on the last Trading Day of an Offering Period (or if an Offering Period has multiple Purchase Periods, on the last Trading Day of the Purchase Period) pursuant to Section 9, the Administrator shall make a participation adjustment, where the number of shares of Stock purchasable by all Participants shall be reduced proportionately in as uniform and equitable a manner as is reasonably practicable, as determined in the Administrator’s sole discretion. After such adjustment, the Administrator shall refund in cash all affected Participants’ Account balances for such Offering Period as soon as practicable thereafter.
(c) Applicable Law Limitations on the Share Reserve. If the Administrator determines that some or all of the shares of Stock to be purchased by Participants on the last Trading Day of an Offering Period (or if an Offering Period has multiple Purchase Periods, the last Trading Day of the Purchase Period) would not be issued in accordance with applicable laws or any approval by any regulatory body as may be required or the shares of Stock would not be issued pursuant to an effective Form S-8 registration statement or that the issuance of some or all of such shares of Stock pursuant to a Form S-8 registration statement is not advisable due to the risk that such issuance will violate applicable laws, the Administrator may, without Participants’ consent, terminate any outstanding Offering Period and the Options granted thereunder and refund in cash all affected Participants’ Account balances for such Offering Period as soon as practicable thereafter.
4. ADMINISTRATION
(a) Generally. The Plan shall be administered under the direction of the Administrator. Subject to the express provisions of the Plan, the Administrator shall have full authority, in its sole discretion, to take any actions it deems necessary or advisable for the administration of the Plan, including, without limitation:
(i) Interpreting and construing the Plan and Options granted under the Plan; prescribing, adopting, amending, waiving, and rescinding rules and regulations it deems appropriate to implement the Plan, including amending any outstanding Option, as it may deem advisable or necessary to comply with applicable laws; correcting any defect or supplying any omission or reconciling any inconsistency in the Plan or Options granted under the Plan; and making all other decisions relating to the operation of the Plan;
(ii) Establishing the timing and length of Offering Periods and Purchase Periods;
(iii) Establishing minimum and maximum contribution rates;
(iv) Establishing new or changing existing limits on the number of shares of Stock a Participant may elect to purchase with respect to any Offering Period, if such limits are announced prior to the first Offering Period to be affected;
2025 PROXY STATEMENT B-3
ANNEX B
(v) Adopting such rules, procedures, or sub-plans as may be deemed advisable or necessary to comply with the laws of countries other than the United States, to allow for tax-preferred treatment of the Options or otherwise to provide for the participation by Eligible Employees who reside outside of the United States, including determining which Eligible Employees are eligible to participate in the Non-423(b) Offering or other sub-plans established by the Administrator;
(vi) Establishing the exchange ratio applicable to amounts withheld in a currency other than U.S. dollars and permitting payroll withholding in excess of the amount designated by a Participant in order to adjust for delays or mistakes in the processing of properly completed Enrollment Forms; and
(vii) Furnishing to the Custodian such information as the Custodian may require.
The Administrator’s determinations under the Plan shall be final, binding, and conclusive upon all persons.
(b) Custodian. If the Administrator designates a Custodian for the Plan, the Custodian shall act as custodian under the Plan and shall perform such duties as requested by the Administrator in accordance with any agreement between the Company and the Custodian. The Custodian shall establish and maintain, as agent for each Participant, an Account and any subaccounts as may be necessary or desirable for the administration of the Plan.
(c) No Liability. Neither the Board, the Compensation Committee of the Board, any other committee of the Board, or the Custodian, nor any of their agents or designees, shall be liable to any person, to the extent permitted by applicable law, (i) for any act, failure to act, or determination made in good faith with respect to the Plan or Options granted under the Plan or (ii) for any tax (including any interest and penalties) by reason of the failure of the Plan, an Option, or an Offering Period to satisfy the requirements of Code Section 423, the failure of the Participant to satisfy the requirements of Code Section 423, or otherwise asserted with respect to the Plan, Options granted under the Plan, or shares of Stock purchased or deemed purchased under the Plan.
5. PARTICIPATION IN THE PLAN AND IN AN OFFERING PERIOD
(a) Generally. An Eligible Employee may become a Participant for an Offering Period under the Plan by completing the prescribed Enrollment Form and submitting such Enrollment Form to the Company (or the Company’s designee), in the format and pursuant to the process as prescribed by the Administrator, during the Enrollment Period prior to the commencement of the Offering Period to which it relates. If properly completed and timely submitted, the Enrollment Form will become effective for the first Offering Period following submission of the Enrollment Form and all subsequent Offering Periods as provided by Section 5(b) until (i) it is terminated in accordance with Section 11, (ii) it is modified by filing another Enrollment Form in accordance with this Section 5(a) (including an election is made to cease payroll deductions or periodic cash contributions in accordance with Section 6(c)), or (iii) the Participant is otherwise ineligible to participate in the Plan or in a subsequent Offering Period.
(b) Automatic Re-Enrollment. Following the end of each Offering Period, each Participant shall automatically be re-enrolled in the next Offering Period at the applicable rate of payroll deductions or periodic cash contributions in effect on the last Trading Day of the prior Offering Period or otherwise as provided under Section 6, unless (i) the Participant has experienced a Termination of Employment, or (ii) the Participant is otherwise ineligible to participate in the Plan or in the next Offering Period. Notwithstanding the foregoing, the Administrator may require current Participants to complete and submit a new Enrollment Form at any time it deems necessary or desirable to facilitate Plan administration or for any other reason.
6. PAYROLL DEDUCTIONS OR PERIODIC CASH CONTRIBUTIONS
(a) Generally. Each Participant’s Enrollment Form shall contain a payroll deduction authorization pursuant to which he or she shall elect to have a designated whole percentage of Eligible Compensation between one percent (1%) and ten percent (10%) deducted, on an after-tax basis, on each payday during the Offering Period and credited to the Participant’s Account for the purchase of shares of Stock pursuant to the offering. Notwithstanding anything herein to the contrary, the Administrator shall also have the authority, but not the obligation, to permit a Participant to elect to make periodic cash contributions, in lieu of payroll deductions, for the purchase of shares of Stock pursuant to the offering. Notwithstanding the foregoing, if local law prohibits payroll deductions, a Participant may elect to participate in an Offering Period through contributions to his or her Account in a format and pursuant to a process acceptable to the Administrator. In such event, any such Participant shall be deemed to participate in a separate offering under the Plan, unless the Administrator otherwise expressly provides.
(b) Insufficiency of Contributions. Subject to Section 6(e), if in any payroll period a Participant has no pay or his or her pay is insufficient (after other authorized deductions) to permit deduction of the full amount of his or her payroll deduction election, then (i) the payroll deduction election for such payroll period shall be reduced to the amount of pay remaining, if any, after all other authorized deductions,
B-4 LABCORP HOLDINGS INC.
ANNEX B
and (ii) the percentage or dollar amount of Eligible Compensation shall be deemed to have been reduced by the amount of the reduction in the payroll deduction election for such payroll period. Deductions of the full amount originally elected by the Participant will recommence as soon as his or her pay is sufficient to permit such payroll deductions; provided, however, no additional amounts shall be deducted to satisfy the Outstanding Election. If the Administrator authorizes a Participant to elect to make periodic cash contributions in lieu of payroll deductions, the failure of a Participant to make any such contributions shall reduce, to the extent of the deficiency in such payments, the number of shares purchasable under the Plan by the Participant.
(c) Cessation after Offering Date. A Participant may cease his or her payroll deductions or periodic cash contributions during an Offering Period by properly completing and timely submitting a new Enrollment Form to the Company (or the Company’s designee), in the format and pursuant to the process as prescribed by the Administrator, at any time prior to the last day of such Offering Period (or if an Offering Period has multiple Purchase Periods, the last day of such Purchase Period). Any such cessation in payroll deductions or periodic cash contributions shall be effective as soon as administratively practicable thereafter and shall remain in effect for successive Offering Periods as provided in Section 5(b) unless the Participant submits a new Enrollment Form for a later Offering Period in accordance with Section 5(a). A Participant may only increase his or her rate of payroll deductions or periodic cash contributions in accordance with Section 6(d).
(d) Modification Prior to Offering Date. A Participant may increase or decrease his or her rate of payroll deductions or periodic cash contributions, to take effect on the Offering Date of the Offering Period following submission of the Enrollment Form, by properly completing and timely submitting a new Enrollment Form in accordance with Section 5(a).
(e) Authorized Leave or Disability after Offering Date. Subject to Section 11, if a Participant is absent from work due to an authorized leave of absence or disability (and has not experienced a Termination of Employment), such Participant shall have the right to elect (i) to remain a Participant in the Plan for the then-current Offering Period (or if an Offering Period has multiple Purchase Periods, the then-current Purchase Period) but to cease his or her payroll deductions or periodic cash contributions in accordance with Section 6(c), or (ii) to remain a Participant in the Plan for the then-current Offering Period (or if an Offering Period has multiple Purchase Periods, the then-current Purchase Period) but to authorize payroll deductions to be made from payments made by the Company or a Participating Affiliate to the Participant during such leave of absence or disability. Neither the Company nor a Participating Affiliate shall advance funds to a Participant if the Participant’s payroll deductions during the Participant’s leave of absence or disability are insufficient to fund the Participant’s Account at his or her Outstanding Election.
7. OFFERING PERIODS AND PURCHASE PERIODS; PURCHASE PRICE
(a) The Administrator shall determine from time to time, in its sole discretion, the Offering Periods and Purchase Periods under the Plan. Each Offering Period shall consist of one or more Purchase Periods, as determined by the Administrator. Unless otherwise established by the Administrator prior to the start of an Offering Period, the Plan shall have two (2) Offering Periods (with concurrent Purchase Periods) that commence each calendar year, and each Offering Period shall be of approximately six (6) months’ duration, with the first such Offering Period beginning on the first Trading Day of January and ending on the last Trading Day of the immediately following June, and the second such Offering Period beginning on the first Trading Day of July and ending on the last Trading Day of the immediately following December; provided, however, that the first Offering Period under the Plan shall commence on the first Trading Day of July following the Effective Date and shall end on the last Trading Day of the immediately following December.
(b) The Administrator shall determine from time to time, in its sole discretion, the Purchase Price of each share of Stock for an Offering Period. Unless otherwise established by the Administrator prior to the start of an Offering Period, the Purchase Price shall be the lesser of eighty-five percent (85%) of the closing price of the Common Stock on the New York Stock Exchange on the first Trading Day of the Offering Period or the last Trading Day of the Offering Period (or if an Offering Period has multiple Purchase Periods, on the last Trading Day of the Purchase Period).
8. GRANT OF OPTION
(a) Grant of Option. On each Offering Date, each Participant in such Offering Period shall automatically be granted an Option to purchase as many whole or fractional shares of Stock as the Participant will be able to purchase with the payroll deductions or periodic cash contributions credited to the Participant’s Account during the applicable Offering Period.
(b) 5% Owner Limit. Notwithstanding any provisions of the Plan to the contrary, no Participant shall be granted an Option to purchase shares of Stock under the Plan if such Participant (or any other person whose Stock would be attributed to such Participant pursuant to Code Section 424(d)), immediately after such Option is granted, would own or hold Options to purchase shares of Stock possessing five percent (5%) or more of the total combined voting power or value of all classes of stock of the Company or any of its Subsidiaries.
2025 PROXY STATEMENT B-5
ANNEX B
(c) Other Limitation. The Administrator may determine, as to any Offering Period, that the offering shall not be extended to “highly compensated employees” within the meaning of Code Section 414(q).
9. PURCHASE OF SHARES OF STOCK; PURCHASE LIMITATIONS
(a) Purchase. Unless the Participant’s participation in the Plan has otherwise been terminated as provided in Section 11, such Participant will be deemed to have automatically exercised his or her Option to purchase Stock on the last Trading Day of the Offering Period (or if an Offering Period has multiple Purchase Periods, the last Trading Day of the Purchase Period) for the maximum number of shares of Stock that may be purchased at the Purchase Price with the Participant’s Account balance at that time; provided, however, the number of shares of Stock purchased is subject to adjustment by Section 3, this Section 9, and Section 12. The Administrator shall cause the amount credited to each Participant’s Account to be applied to such purchase, and the amount applied to purchase shares of Stock pursuant to an Option shall be deducted from the applicable Participant’s Account.
(b) Limit on Number of Shares Purchased. Notwithstanding Section 8(a) or Section 9(a), in no event may a Participant purchase more than fifty thousand (50,000) shares of Stock in any one Offering Period; provided, however, that the Administrator may, in its sole discretion, prior to the start of an Offering Period, set a different limit on the number of shares of Stock a Participant may purchase during such Offering Period.
(c) Limit on Value of Shares Purchased. Notwithstanding any provisions of the Plan to the contrary, excluding Options granted pursuant to any Non-423(b) Offering, no Participant shall be granted an Option to purchase shares of Stock under the Plan which permits the Participant’s rights to purchase shares under all “employee stock purchase plans” (described in Code Section 423) of the Company and its Subsidiaries to accrue at a rate which exceeds twenty-five thousand dollars ($25,000) of the Fair Market Value of such shares of Stock (determined on the first Trading Day of each applicable Offering Period) for each calendar year in which such Options are outstanding at any time.
10. STOCK ISSUANCE; SHAREHOLDER RIGHTS; AND SALES OF PLAN SHARES
(a) Stock Issuance and Account Statements. Shares of Stock purchased under the Plan will be held by the Custodian. The Custodian may hold the shares of Stock purchased under the Plan by book entry or in the form of stock certificates in nominee names and may commingle shares held in its custody in a single account without identification as to individual Participants. The Company shall cause the Custodian to deliver to each Participant a statement for each Offering Period during which the Participant purchases Stock under the Plan, which statement shall reflect, for each such Participant, (i) the amount of payroll deductions withheld or periodic cash contributions made during the Offering Period, (ii) the number of shares of Stock purchased, (iii) the Purchase Price of the shares of Stock purchased, and (iv) the total number of shares of Stock held by the Custodian for the Participant as of the end of the Offering Period.
(b) Shareholder Rights. A Participant shall not be a shareholder or have any rights as a shareholder with respect to shares of Stock subject to the Participant’s Options under the Plan until the shares of Stock are purchased pursuant to the Options and such shares of Stock are transferred into the Participant’s name on the Company’s books and records. No adjustment will be made for dividends or other rights for which the record date is prior to such time. Following purchase of shares of Stock under the Plan and transfer of such shares of Stock into the Participant’s name on the Company’s books and records, a Participant shall become a shareholder with respect to the shares of Stock purchased during such Offering Period (or, if applicable, Purchase Period) and, except as otherwise provided in Section 10(c), shall thereupon have all dividend, voting, and other ownership rights incident thereto.
(c) Sales of Plan Shares. The Administrator shall have the right to require any or all of the following with respect to shares of Stock purchased under the Plan:
(i) that a Participant may not request that all or part of the shares of Stock be reissued in the Participant’s own name and shares be delivered to the Participant until two (2) years (or such shorter period of time as the Administrator may designate) have elapsed since the Offering Date of the Offering Period in which the shares were purchased and one (1) year has elapsed since the day the shares were purchased (the “Holding Period”);
(ii) that all sales of shares of Stock during the Holding Period applicable to such purchased shares be performed through a licensed broker acceptable to the Company; and
(iii) that Participants abstain from selling or otherwise transferring shares of Stock purchased pursuant to the Plan for a period lasting up to two (2) years from the date the shares of Stock were purchased pursuant to the Plan.
B-6 LABCORP HOLDINGS INC.
ANNEX B
11. DEEMED CANCELLATION OR TERMINATION OF PARTICIPATION
(a) Termination of Employment Other than Death. In the event a Participant who holds outstanding Options to purchase shares of Stock under the Plan experiences a Termination of Employment for any reason other than death prior to the last Trading Day of the Offering Period, the Participant’s outstanding Options to purchase shares of Stock under the Plan shall automatically terminate, and the Administrator shall refund in cash the Participant’s Account balance as soon as practicable thereafter.
(b) Death. In the event of the death of a Participant while the Participant holds outstanding Options to purchase shares of Stock under the Plan, the legal representatives of such Participant’s estate (or, if the Administrator permits a beneficiary designation, the beneficiary or beneficiaries most recently designated by the Participant prior to his or her death) may, within three (3) months after the Participant’s death (but no later than the last Trading Day of the Offering Period (or if an Offering Period has multiple Purchase Periods, the last Trading Day of the then-current Purchase Period)) by written notice to the Company (or the Company’s designee), elect one of the following alternatives. In the event the Participant’s legal representatives (or, if applicable, beneficiary or beneficiaries) fail to deliver such written notice to the Company (or the Company’s designee) within the prescribed period, the alternative in Section 11(b)(ii) shall apply.
(i) The Participant’s outstanding Options shall be reduced to the number of shares of Stock that may be purchased, as of the last day of the Offering Period (or if an Offering Period has multiple Purchase Periods, the last Trading Day of the then-current Purchase Period), with the amount then credited to the Participant’s Account; or
(ii) The Participant’s Options to purchase shares of Stock under the Plan shall automatically terminate, and the Administrator shall refund in cash, to the Participant’s legal representatives, the Participant’s Account balance as soon as practicable thereafter.
(c) Other Termination of Participation. If a Participant ceases to be eligible to participate in the Plan for any reason, the Administrator shall refund in cash the affected Participant’s Account balance as soon as practicable thereafter. Once terminated, participation may not be reinstated for the then-current Offering Period, but, if otherwise eligible, the Eligible Employee may elect to participate in a subsequent Offering Period in accordance with Section 5.
12. CHANGES IN CAPITALIZATION
(a) Changes in Stock. If the number of outstanding shares of Stock is increased or decreased or the shares of Stock are changed into or exchanged for a different number or kind of shares or other securities of the Company by reason of any recapitalization, reclassification, stock split, reverse stock split, spin-off, combination of shares, exchange of shares, stock dividend, or other distribution payable in capital stock, or other increase or decrease in such shares effected without receipt of consideration by the Company occurring after the Effective Date, the number and kinds of shares that may be purchased under the Plan shall be adjusted proportionately and accordingly by the Company. In addition, the number and kind of shares for which Options are outstanding shall be similarly adjusted so that the proportionate interest of a Participant immediately following such event shall, to the extent practicable, be the same as immediately prior to such event. Any such adjustment in outstanding Options shall not change the aggregate Purchase Price payable by a Participant with respect to shares subject to such Options but shall include a corresponding proportionate adjustment in the Purchase Price per share. Notwithstanding the foregoing, in the event of a spin-off that results in no change in the number of outstanding shares of Stock, the Company may, in such manner as the Company deems appropriate, adjust (i) the number and kind of shares for which Options are outstanding under the Plan and (ii) the Purchase Price per share.
(b) Reorganization in Which the Company Is the Surviving Corporation. Subject to Section 12(c), if the Company shall be the surviving corporation in any reorganization, merger, or consolidation of the Company with one or more other corporations, all outstanding Options under the Plan shall pertain to and apply to the securities to which a holder of the number of shares of Stock subject to such Options would have been entitled immediately following such reorganization, merger, or consolidation, with a corresponding proportionate adjustment of the Purchase Price per share so that the aggregate Purchase Price thereafter shall be the same as the aggregate Purchase Price of the shares subject to such Options immediately prior to such reorganization, merger, or consolidation.
(c) Reorganization in Which the Company Is Not the Surviving Corporation, Sale of Assets or Stock, and Other Corporate Transactions. Upon any dissolution or liquidation of the Company, or upon a merger, consolidation, or reorganization of the Company with one or more other corporations in which the Company is not the surviving corporation, or upon a sale of all or substantially all of the assets of the Company to another corporation, or upon any transaction (including, without limitation, a merger, consolidation, or reorganization in which the Company is the surviving corporation) approved by the Board that results in any person or entity owning more than fifty percent (50%) of the combined voting power of all classes of stock of the Company, the Plan and all Options outstanding hereunder shall terminate, except to the extent provision is made in writing in connection with such transaction for the continuation of the Plan and/or the assumption of the Options theretofore granted, or for the substitution for such Option of new rights covering the stock of a successor corporation, or a parent or subsidiary thereof, with appropriate adjustments as to the number and kinds of shares and purchase prices, in which event the
2025 PROXY STATEMENT B-7
ANNEX B
Plan and rights theretofore granted shall continue in the manner and under the terms so provided. In the event of any such termination of the Plan, the Offering Period shall be deemed to have ended on the last Trading Day prior to such termination, and in accordance with Section 9, the Options of each Participant then outstanding shall be deemed to be automatically exercised on such last Trading Day. The Administrator shall send written notice of an event that will result in such a termination to all Participants at least five (5) days prior to the date upon which the Plan will be terminated.
(d) Adjustments. Adjustments under this Section 12 related to stock or securities of the Company shall be made by the Administrator, whose determination in that respect shall be final, binding, and conclusive.
(e) No Limitations on Company. The grant of an Option pursuant to the Plan shall not affect or limit in any way the right or power of the Company to make adjustments, reclassifications, reorganizations, or changes of its capital or business structure or to merge, consolidate, dissolve or liquidate, or to sell or transfer all or any part of its business or assets.
13. TERM; AMENDMENT, SUSPENSION, AND TERMINATION OF THE PLAN
(a) Term. The Plan shall be effective as of the Effective Date. The outstanding offering period under the Prior Plan shall be the last offering period under the Prior Plan which ends on June 30, 2025. The Plan shall terminate on the first to occur of (i) the day before the tenth (10th) anniversary of the Effective Date, (ii) the date on which all shares of Stock reserved for issuance under the Plan pursuant to Section 3 have been issued, (iii) the date determined in accordance with Section 12, and (iv) the date determined in accordance with Section 13(b).
(b) Amendment, Suspension, and Termination of the Plan. The Administrator may, at any time and from time to time, amend, suspend, or terminate the Plan or an Offering Period under the Plan; provided, however, that no amendment, suspension, or termination shall, without the consent of the Participant, impair any rights of a Participant that have vested at the time of such amendment, suspension, or termination. Without approval of the shareholders of the Company, no amendment shall be made (i) increasing the number of shares reserved for issuance under the Plan pursuant to Section 3 (except as provided in Section 12) or (ii) changing the eligibility requirements for participating in the Plan.
14. GENERAL PROVISIONS
(a) Withholding of Taxes. To the extent that a Participant recognizes ordinary income in connection with a sale or other transfer of any shares of Stock purchased under the Plan, the Company may withhold amounts needed to cover such taxes from any payments otherwise due and owing to the Participant or from shares that would otherwise be issued to the Participant under the Plan.
(b) Options Not Transferable or Assignable. A Participant’s Options under the Plan may not be sold, pledged, assigned, or transferred in any manner, whether voluntarily, by operation of law, or otherwise. If a Participant sells, pledges, assigns, or transfers his or her Options in violation of this Section 14(b), such Options shall immediately terminate, and the Participant shall immediately receive a refund of the amount then credited to the Participant’s Account. Any payment of cash or issuance of shares of Stock under the Plan may be made only to the Participant (or, in the event of the Participant’s death, to the Participant’s estate or, if the Administrator permits a beneficiary designation, the beneficiary or beneficiaries most recently designated by the Participant prior to his or her death). During a Participant’s lifetime, only such Participant may exercise his or her Options under the Plan.
(c) No Right to Continued Employment. Neither the Plan nor any Option to purchase Stock under the Plan confers upon any Eligible Employee or Participant any right to continued employment with the Company or any of its Subsidiaries, nor will a Participant’s participation in the Plan restrict or interfere in any way with the right of the Company or any of its Subsidiaries to terminate the Participant’s employment at any time.
(d) No Interest on Payments. No interest shall be paid on sums withheld from a Participant’s pay or otherwise contributed for the purchase of shares of Stock under the Plan unless otherwise determined necessary by the Administrator.
(e) Governmental Regulation. The Company’s obligation to issue, sell, and deliver shares of Stock pursuant to the Plan is subject to such approval of any governmental authority and any national securities exchange or other market quotation system as may be required in connection with the authorization, issuance, or sale of such shares.
(f) Rule 16b-3. Transactions under this Plan are intended to comply with all applicable conditions of Rule 16b-3 or any successor provision under the Securities Exchange Act of 1934, as amended. If any provision of the Plan or action by the Administrator fails to so comply, it shall be deemed null and void to the extent permitted by applicable law and deemed advisable by the Board. Moreover, in the event the Plan does not include a provision required by Rule 16b-3 to be stated in the Plan, such provision (other than one relating to eligibility requirements or the price and amount of awards) shall be deemed automatically to be incorporated by reference into the Plan.
B-8 LABCORP HOLDINGS INC.
ANNEX B
(g) Payment of Plan Expenses. The Company shall bear all costs of administering and carrying out the Plan.
(h) Application of Funds. All funds received or held by the Company under the Plan may be used for any corporate purpose until applied to the purchase of Stock and/or refunded to Participants.
(i) Governing Law. The validity and construction of the Plan and the Options granted hereunder shall be governed by, and construed and interpreted in accordance with, the laws of the State of Delaware (other than any conflicts or choice of law rule or principle that might otherwise refer construction or interpretation of the Plan and the Options granted under the Plan to the substantive laws of any other jurisdiction), except to the extent superseded by applicable U.S. federal laws.
* * *
2025 PROXY STATEMENT B-9
ANNEX B
Labcorp Employee Stock Purchase Plan
Canadian sub-plan
SUB-PLAN FOR CANADIAN PARTICIPANTS
| 1. | APPLICATION |
This Sub-Plan sets forth additional terms and conditions applicable to the rights granted to, and the shares of Stock purchased by, Eligible Employees under the Plan who are, or are deemed to be, resident in Canada for the purpose of payment of income taxes or are otherwise liable to tax under the Income Tax Act (Canada) in respect their participation in the Plan (a “Canadian Participant”).
The Plan and this Sub-Plan are complimentary to each other and shall be deemed as one. In any case of contradiction between the provisions of this Sub-Plan and the Plan, the provisions set out in the Sub-Plan shall prevail. Any capitalized terms used in this Sub-Plan but not defined shall have the meaning given to those terms in the Plan.
| 2. | GLOBAL PROVISIONS |
(a) English Language. By participating in the Plan, each Canadian Participant acknowledges that such Canadian Participant is proficient in the English language, or has consulted with an advisor who is sufficiently proficient in English, so as to allow the Canadian Participant to understand the terms and conditions of the Plan, this Sub-Plan and any other related document under the Plan. If a Canadian Participant has received the Plan, the Sub-Plan or any other document related to the Plan translated into a language other than English and if the meaning of the translated version is different than the English version, the English version will control.
(c) Currency. Each Canadian Participant understands that, if the Canadian Participant’s payroll deductions under the Plan are made in any currency other than U.S. dollars, such contributions will be converted to U.S. dollars on or prior to the date shares of Stock are purchased under the Plan using a prevailing exchange rate in effect at the time such conversion is performed, as determined by the Company. Each Canadian Participant understands and agrees that neither the Company or its Participating Affiliates shall be liable for any foreign exchange rate fluctuation between the Canadian Participant’s Canadian dollar and the U.S. dollar that may affect the value of the purchase rights granted to the Canadian Participant under the Plan, or of any amounts due to the Canadian Participant under the Plan or as a result of the subsequent sale of any shares of Stock acquired under the Plan.
(d) Acknowledgment of Nature of Plan and Rights. In participating in the Plan and this Sub-Plan, each Canadian Participant acknowledges that:
(i) for employment and labor law purposes, except if required by the applicable employment standards legislation, the rights granted and the shares of Stock purchased under the Plan are an extraordinary item that do not constitute wages or salary of any kind for services of any kind rendered to the Company or its Participating Affiliates, and the award of rights is outside the scope of the Canadian Participant’s employment or service contract, if any;
(ii) for employment and labor law purposes, except if required by the applicable employment standards legislation, the rights granted and the shares of Stock purchased under the Plan are not part of integral, normal or expected wages or salary for any purposes, including, but not limited to, calculation of any notice of termination of employment, payment in lieu of any notice of termination of employment, severance, resignation, termination (with or without Cause, as defined below), redundancy, expiry of fixed-term contract, dismissal, end of service payments, bonuses, holiday pay, paid time off, long-service awards, pension or retirement benefits or similar payments and in no event should be considered as compensation for, or relating in any way to, past services for the Company or its Participating Affiliates;
(iii) the rights and the shares of Stock purchased under the Plan are not intended to be an integral component of compensation or to replace any pension rights or compensation;
(iv) neither the rights nor any provision of Plan or the policies adopted pursuant to the Plan confer upon any Canadian Participant any right with respect to service or continuation of current service and shall not be interpreted to form an employment or a service contract or relationship with the Company or its Participating Affiliates;
(v) the future value of the underlying shares of Stock is unknown and cannot be predicted with certainty;
(vi) if the underlying shares of Stock do not increase in value, the right may have no value;
(vii) if a Canadian Participant acquires shares of Stock, the value of such shares acquired upon purchase may increase or decrease in value, even below the original price paid; and
B-1A LABCORP HOLDINGS INC.
ANNEX B
(viii) participation in the Plan by a Canadian Participant is purely voluntary and the Canadian Participant has not been induced to participate by expectation of engagement, appointment, employment or continued engagement, appointment or employment, as applicable.
(e) Applicable Withholding Taxes. To the extent that a Canadian Participant realizes employment income in connection with the purchase of shares of Stock under the Plan, the Company or its Participating Affiliates may withhold all taxes and other source deductions or other amounts which the Company or its Participating Affiliates are required by law to withhold from any payments otherwise due and owing to the Canadian Participant or from shares that would otherwise be issued to the Canadian Participant under the Plan.
| 3. | LANGUAGE CONSENT |
The parties acknowledge that it is their express wish that the Plan, as well as all documents, notices and legal proceedings entered into, given or instituted pursuant hereto or relating directly or indirectly hereto, be drawn up in English.
Consentement relatif à la langue utilisée. Les parties reconnaissent avoir exigé la rédaction en anglais de cette convention, ainsi que de tous documents, avis et procédures judiciaires, exécutés, donnés ou intentés en vertu de, ou liés directement ou indirectement à, la présente convention.
| 4. | TERMINATION OF EMPLOYMENT |
In the event of termination of a Canadian Participant’s employment, the Canadian Participant’s right to purchase shares of Stock under the Plan, if any, will terminate, and he or she shall be deemed to have elected to withdraw from the Plan, effective as of the Canadian Participant’s Termination Date.
“Cause” shall mean, in respect of a Canadian Participant: (i) in respect of the termination of an employee employed in Ontario, wilful misconduct, disobedience or wilful neglect of duty by the employee that is not trivial and is not condoned by the employee’s employer; and (ii) in respect of an employee employed in another jurisdiction outside of Ontario, such conduct by the employee which permits the employee’s employer to terminate the employee without notice, payment in lieu of notice or severance pay, whether arising under statute, contract or at law.
“Termination Date” shall mean in respect of a Canadian Participant whose employment or term of office with a Participating Affiliate terminates for any reason, including by reason of retirement, expiry of fixed-term contract, resignation, death, disability, termination without Cause, termination for Cause, the last day of the Canadian Participant’s actual and active employment or term of office with a Participating Affiliate, which in the event of a termination without Cause or termination due to disability shall include any minimum statutory period of individual notice of termination or pay in lieu to the extent required by the applicable employment standards legislation, but shall exclude any other period of deemed employment as well as additional notice or severance periods or pay in lieu in respect of which the Canadian Participant is in receipt of or may be eligible to receive at statute, common law or civil law, pursuant to a contract, or otherwise. For greater certainty, (a) a Termination Date shall be determined without reference to any statutory severance, notice of mass lay-offs or any contractual or common law or civil law notice of termination or pay in lieu that the Canadian Participant is entitled to or in receipt of; and (b) in no event will the Canadian Participant receive less than that the entitlements required by applicable minimum employment standards legislation.
For absolutely certainty, each Canadian Participant represents, warrants and acknowledges that such Canadian Participant has read and understood the terms and conditions of the Plan which: (i) state that the Canadian Participant shall have no entitlement to damages or other compensation whatsoever arising from, in lieu of, or related to not receiving any compensation, Options or shares of Stock which would have been granted or payable after the Canadian Participant’s Termination Date, including but not limited to damages in lieu of notice at common law or civil law; and (ii) have the effect that no period of common law or civil law reasonable notice that exceeds the Canadian Participant’s minimum statutory individual notice period under applicable employment standards legislation (if any), shall be used for the purposes of calculating the Canadian Participant’s entitlement under this Plan. By participating in this Plan, each Canadian Participant expressly waives any eligibility or entitlement to receive damages or payment in lieu of any forfeited amounts under this Plan that would have vested, accrued or been paid during any common law or civil law reasonable notice period that exceeds such Canadian Participant’s minimum statutory individual notice period under the applicable employment standards legislation (if any).
The payroll deductions credited to such Canadian Participant’s account during the Offering Period shall be paid to such Canadian Participant or, in the case of his or her death, to the executor, administrator or liquidator of the estate of the Canadian Participant, as soon as reasonably practicable and such Canadian Participant’s rights for the Offering Period shall be automatically terminated on the Termination Date.
2025 PROXY STATEMENT B-2A
ANNEX B
| 5. | AUTHORIZED LEAVE |
“An Authorized Leave of Absence and Disability” in respect of a Canadian Participant shall mean : (i) a paid leave of absence, approved by the Company or its Participating Affiliates and paid through the Company or a Participating Affiliate’s payroll, including, for greater certainty, a leave during which the Canadian Participant is in receipt of short-term disability benefits; or (ii) an unpaid leave of absence taken in accordance with applicable employment standards legislation during which the applicable legislation requires that the Canadian Participant be permitted to elect to continue participation in the Plan during the leave.
| 6. | PURCHASE OF SHARES |
Notwithstanding anything in the Plan to the contrary, the purchase of Shares for any Canadian Participant shall occur on the first Trading Day following the end of the Offering Period, and the Purchase Price shall be calculated by reference to the sales price of the Common Stock on the New York Stock Exchange on such date.
| 7. | DATA PROTECTION |
The Company collects and processes various types of information that is used to administer or support the Plan. “Personal Information” means information that can be used to identify or authenticate an individual but does not include business contact information and publicly available information.
In addition to the global provisions of the Sub-Plan, each Canadian Participant hereby authorizes the Company and the Company’s representatives to discuss with and obtain all relevant Personal Information from all personnel, professional or not, involved in the administration and operation of the Plan, where necessary or inadvertent, including personal biographical information (including an Eligible Employee’s name, address, gender and date of birth), tax reporting information (including a Social Insurance Number and citizenship information), as well as contact information. Each Canadian Participant further authorizes the Company to disclose and discuss the Plan and this Sub-Plan with their advisors, to the extent reasonably necessary to administer the Plan and this Sub-Plan, including in relation to audits and communication of the Plan. Each Canadian Participant further authorizes the Company to record Personal Information and Plan information, and to keep such information in the Eligible Employee’s employee file.
The Company affirms its commitment to ensure that all Personal Information of Canadian Participants collected, maintained and used, is kept confidential and used only for the purposes for which it is intended, and assumes responsibility for safeguarding such Personal Information in accordance with the Plan and Sub-Plan requirements and all applicable laws.
In the event of a security breach, the Company will take reasonable steps to comply with all applicable breach notification processes in accordance with applicable law. A security breach occurs when the security or confidentiality of Personal Information is comprised, and includes the unauthorized collection, use, or disclosure of Personal Information.
The measures that the Company will undertake to safeguard the security of Personal Information collected include, but are not necessarily limited to, taking the following steps commensurate with industry standards, as applicable: (i) limiting employee and contractor access to Personal Information; (ii) securing business facilities, data centers, paper files, services back-up systems and computing equipment; (iii) implementing network, device, database, and platform security in accordance with industry standards; (iv) securing information transmission, storage and disposal; (v) implementing appropriate personnel security and integrity procedures sand practices; and (vi) providing appropriate privacy and information security training to employees.
The administration of the Plan might entail storage of Personal Information outside of Canada, including, without limitation, in the following countries: United States of America. Canadian Participants will be clearly informed of such storage outside Canada and any changes thereto, and be provided with the contact information of an individual who can answer questions regarding the collection and use of Personal Information.
| 7. | NOTIFICATIONS |
(a) Securities Law Information. There may be securities law implications to a Canadian Participant who sells shares of Stock acquired through the Plan through a broker other than a broker appointed under the Plan or if the sale does not take place through the facilities of a stock exchange outside of Canada on which the shares of Stock are listed and the Canadian Participant shall be solely responsible for complying with any such securities laws, if applicable.
(b) Foreign Asset/Account Reporting Information. If a Canadian Participant is a Canadian resident, such Canadian Participant may be required to report his or her foreign property on form T1135 (Foreign Income Verification Statement) if the total cost of the foreign property
B-3A LABCORP HOLDINGS INC.
ANNEX B
exceeds a certain threshold at any time during the year. Shares of Stock and rights to receive shares of Stock (e.g., Options) under the Plan are property which are included in foreign property that must be reported. Such Options must be reported — generally at a nil cost — if the threshold is exceeded because of other foreign property. When shares of Stock are acquired, their cost generally is the adjusted cost base (“ACB”) of the shares. The ACB would ordinarily equal the fair market value of the shares of Stock at the time of purchase, but if other shares of Stock are also owned, this ACB may have to be averaged with the ACB of the other shares of Stock. The form must be filed by April 30th of the following year.
2025 PROXY STATEMENT B-4A
LABCORP EMPLOYEE STOCK PURCHASE PLAN
UK sub-plan
SUB-PLAN FOR UNITED KINGDOM PARTICIPANTS
| 1. | APPLICATION AND INTERPRETATION |
| 1.1 | This Sub-Plan sets forth additional terms and conditions applicable to the rights granted to, and the shares of Stock purchased by, Eligible Employees (as such term shall apply for potential participants in the United Kingdom for the purposes of this Sub-Plan) under the Plan: |
| (a) | who are, or are deemed to be, resident in the United Kingdom for the purpose of payment of income taxes; |
| (b) | who are otherwise liable to tax in the United Kingdom in respect of their participation in the Plan; and/or |
| (c) | to whom the Administrator (in its absolute discretion) designates this Sub-Plan shall apply (including, without limitation, as a result of their employment being subject to the laws of the United Kingdom), |
each, a “UK Participant”.
| 1.2 | The Plan and this Sub-Plan are complimentary to each other and the terms of the Plan shall apply to this Sub-Plan unless otherwise stated. In any case of contradiction between the provisions of this Sub-Plan and the Plan, the provisions set out in the Sub-Plan shall prevail. Any capitalized terms used in this Sub-Plan but not otherwise defined in this Sub-Plan shall have the meaning given to those terms in the Plan. |
| 1.3 | In this Sub-Plan: |
| (a) | “Employee Tax” means income tax, employee’s National Insurance contributions and any other employee’s social security contributions (whether or not in force at the date of the UK Participant becoming a participant in the Plan and this Sub-Plan), together with any similar or equivalent taxes, contributions, withholdings or levies in the UK or any other jurisdiction, or any other sums for which the relevant employer is required to account to HM Revenue & Customs or any other tax or social security authority on behalf of the relevant UK Participant, and any interest or penalties relating to any of them; |
| (b) | “ITEPA 2003” means the Income Tax (Earnings and Pensions) Act 2003; |
| (c) | “Pounds Sterling” shall mean the lawful currency of the United Kingdom. |
| (d) | “shares of Stock” or “Stock” shall include, for the avoidance of doubt and without limitation, any fractional shares of Stock or any other interest in Stock or shares of Stock acquired by a UK Participant pursuant to the Plan and this Sub-Plan. |
| 2. | ELIGIBLE EMPLOYEES |
For the purposes of this Sub-Plan, and noting that an offer to a UK Participant would be a Non-423(b) Offering, the definition of “Eligible Employee” in paragraph 2(i) of the Plan shall be amended by way of the deletion of sub-paragraphs 2(i)(i) and 2(i)(ii).
| 3. | IMPORTANT RISK AND CURRENCY INFORMATION |
| 3.1 | Each UK Participant understands and acknowledges that the value of any Shares acquired pursuant to the Plan and this Sub-Plan can go up or down, and that a UK Participant could get back less than the original amount of their payroll deductions (or any other amount invested in shares of Stock) and be exposed to a capital loss; and |
| 3.2 | Each UK Participant understands and acknowledges that, if the UK Participant’s payroll deductions under the Plan and this Sub-Plan are made in any currency other than U.S. dollars, such contributions will be converted to U.S. dollars on or prior to the date shares of Stock are purchased under the Plan and this Sub-Plan using a prevailing exchange rate in effect at the time such conversion is performed, as determined by the Company. Each UK Participant understands and agrees that neither the Company or its Participating Affiliates shall be liable for any foreign exchange rate fluctuation between Pounds Sterling (or any other relevant currency) and the U.S. dollar that may affect the value of the purchase rights granted to the UK Participant under the Plan and this Sub-Plan, or of any amounts due to the UK Participant under the Plan and this Sub-Plan or as a result of the subsequent sale of any shares of Stock acquired under the Plan and this Sub-Plan. |
B-1B LABCORP HOLDINGS INC.
| 4. | RELATIONSHIP TO EMPLOYMENT |
| 4.1 | The rights and obligations of an UK Participant in relation to his or her office or employment with the Company or any Participating Affiliate (including but not limited to under any employment contract or service contract) shall not be affected by this Sub-Plan, the Plan, or any Enrollment Form or other documentation or agreements in relation to this Sub-Plan or the Plan. If on termination of employment or engagement (lawfully or otherwise) any UK Participant loses any rights or benefits under this Sub-Plan or the Plan (including rights or benefits that he would not have lost had the employment or engagement not been terminated), the UK Participant is not entitled to any compensation for such loss of rights.” |
| 4.2 | Rule 14(c) of the Plan shall be amended as follows in relation to this Sub-Plan and UK Participants: |
None of the Plan, this Sub-Plan or any Option to purchase Stock under the Plan or this Sub-Plan confers upon any Eligible Employee or UK Participant any right to continued employment with the Company, any Subsidiary or any Participating Affiliate, and a UK Participant’s participation in the Plan or this Sub-Plan shall not restrict or interfere in any way with the right of the Company, any Subsidiary or any Participating Affiliate to terminate the UK Participant’s employment in accordance with applicable law.
| 5. | TAX |
| 5.1 | As a condition of participation in the Plan and this Sub-Plan, the Administrator may require a UK Participant to enter into any election for tax purposes that the Administrator (in its absolute discretion) deems necessary and/or desirable, including (without limitation) an election under section 431(1) of ITEPA 2003 in circumstances where a Holding Period applies under Section 10(c)(i) of the Plan. |
| 5.2 | Notwithstanding any other provision of the Plan, a UK Participant’s participation in the Plan and this Sub-Plan (including the purchase of Stock under the Plan and this Sub-Plan) shall be conditional upon such UK Participant making adequate provision for payment of an amount equal to any Employee Tax for which the Company, any Subsidiary or any Participating Affiliate is liable to account or pay in connection with the UK Participant’s participation in the Plan and this Sub-Plan (including the purchase of Stock under the Plan and this Sub-Plan) (all such liabilities, together, the “Relevant Tax Liabilities”). |
| 5.3 | Each UK Participant shall indemnify (on an after-tax basis) the Company, each Subsidiary and each Participating Affiliate (each, an “Indemnified Party”) for any Employee Tax which the Indemnified Party may be liable to deduct, withhold, account for or pay by reason of the UK Participant’s participation in the Plan and this Sub-Plan (including the UK Participant’s purchase of Stock). |
| 5.4 | Notwithstanding any other provision of the Plan, the Administrator may determine, and each UK Participant agrees that the Administrator may determine, that the UK Participant shall satisfy the Relevant Tax Liabilities in any way determined by the Administrator in the Administrator’s absolute discretion (but subject at all times to the requirements of applicable law), including (without limitation) the Company, any Subsidiary or any Participating Affiliate: |
| (a) | withholding a number of Stock having an aggregate fair market value equal to such Relevant Tax Liabilities; |
| (b) | withholding cash from the UK Participant’s aggregate payroll deductions under the Plan and this Sub-Plan equal to such Relevant Tax Liabilities (and, for the avoidance of doubt, such cash need not be applied to the purchase of Stock and the UK Participant shall have no right to receive or be paid such cash); |
| (c) | withholding an amount equal to such Relevant Tax Liabilities from the UK Participant’s salary and/or any other amounts payable to the UK Participant (including in their capacity as an employee) by the Company, any Subsidiary or any Participating Affiliate; and/or |
| (d) | requiring the UK Participant to account directly to the Company, any Subsidiary or any Participating Affiliate for an amount equal to the Relevant Tax Liabilities on a timely basis. |
| 6. | DATA PROTECTION |
The Company will process each UK Participant’s personal data in connection with the Plan and this Sub-Plan in accordance with the terms of the privacy notice previously provided to the UK Participant.
2025 PROXY STATEMENT B-2B
To record adoption of the Plan by the Board as of March 27, 2025, the Company has caused its authorized officer to execute the Plan.
| LABCORP HOLDINGS INC. |
| By: |
| Name: |
| Title: |
Signature Page to the
Labcorp Holdings Inc. 2025 Employee Stock Purchase Plan
B-3B LABCORP HOLDINGS INC.

labcorp 2025 Labcorp Holdings, Inc. All rights reserved.

LABCORP HOLDINGS INC. 358 SOUTH MAIN STREET BURLINGTON, NC 27215 SCAN TO VIEW MATERIALS & VOTE VOTE BY INTERNET Before The Meeting - Go to www.proxyvote.com or scan the QR Barcode above Use the Internet to transmit your voting instructions and for electronic delivery of information up until 11:59 P.M. Eastern Daylight Time the day before the cut-off date or meeting date. Have your proxy card in hand when you access the web site and follow the instructions to obtain your records and to create an electronic voting instruction form. During The Meeting - Go to www.virtualshareholdermeeting.com/LH2025 You may attend the Meeting via the Internet and vote during the Meeting. Have the information that is printed in the box marked by the arrow available and follow the instructions. VOTE BY PHONE - 1-800-690-6903 Use any touch-tone telephone to transmit your voting instructions up until 11:59 P.M. Eastern Daylight Time the day before the cut-off date or meeting date. Have your proxy card in hand when you call and then follow the instructions. VOTE BY MAIL Mark, sign and date your proxy card and return it in the postage-paid envelope we have provided or return it to Vote Processing, c/o Broadridge, 51 Mercedes Way, Edgewood, NY 11717. TO VOTE, MARK BLOCKS BELOW IN BLUE OR BLACK INK AS FOLLOWS: V66409-P30532 KEEP THIS PORTION FOR YOUR RECORDS DETACH AND RETURN THIS PORTION ONLY THIS PROXY CARD IS VALID ONLY WHEN SIGNED AND DATED. LABCORP HOLDINGS INC. The Board of Directors recommends you vote FOR each of the Nominees listed in the following proposal: 1. Election of the members of the Company's Board of Directors. Nominees: For Against Abstain 1a. Kerrii B. Anderson 1b. Jeffrey A. Davis 1c. D. Gary Gilliland, M.D., Ph.D. 1d. Kirsten M. Kliphouse 1e. Garheng Kong, M.D., Ph.D. 1f. Peter M. Neupert 1g. Richelle P. Parham 1h. Paul B. Rothman, M.D. 1i. Adam H. Schechter 1j. Kathryn E. Wengel The Board of Directors recommends you vote FOR the following proposals: For Against Abstain 2. To approve, by non-binding vote, the compensation ofthe Company's Named Executive Officers. 3. To approve the Company's 2025 Omnibus Incentive Plan. 4. To approve the Company's 2025 Employee StockPurchase Plan. 5. Ratification of the appointment of Deloitte and Touche LLP as Labcorp Holdings Inc.'s independent registered public accounting firm for the year ending December 31, 2025. NOTE: Such other business as may properly come before the meeting or any adjournment thereof. Note: Please sign exactly as your name(s) appear(s) above. When signing as an executor, administrator, or other fiduciary, please give full title as such. Joint owners should each sign personally.All holders must sign. If a corporation or partnership, please sign in full corporate or partnership name by authorized officer. Date and promptly return the card in the envelope provided. Signature [PLEASE SIGN WITHIN BOX] Date Signature (Joint Owners) Date

Important Notice Regarding the Availability of Proxy Materials for the Annual Meeting:The Notice of Proxy Statement, the Proxy Statement, and Annual Report are available at www.proxyvote.com. V66410-P30532 SHAREHOLDERS' PROXY SOLICITED BY THE BOARD OF DIRECTORS OF LABCORP HOLDINGS INC. To: LABCORP HOLDINGS INC. I appoint Sandra D. van der Vaart and Julia A. Wang, individually and together, as my proxies, with power of substitution, to vote all of my LABCORP HOLDINGS INC. common stock at the Annual Meeting of Shareholders of LABCORP HOLDINGS INC. to be held online at www.virtualshareholdermeeting.com/LH2025 on Thursday, May 15, 2025 at 9:00 a.m., Eastern Daylight Time, and at any adjournment or postponement of the meeting. My proxies will vote the shares represented by this proxy as directed on the other side of this card, but in the absence of any instructions from me, my proxies will vote "FOR" the election of all the nominees listed under Item 1, and "FOR" Items 2, 3, 4 and 5. My proxies may vote according to their discretion on any other matter which may properly come before the meeting. I may revoke this proxy prior to its exercise. Please sign and date the other side of the card. (Please fill in the appropriate boxes on the other side.)